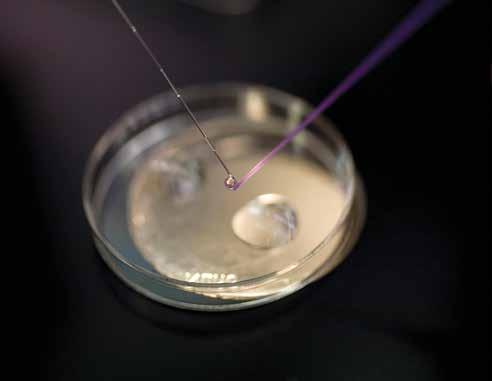

Hereford BREED JOURNAL 2023





 by Paul Sneyd
by Paul Sneyd
After the last few years being so disruptive with Covid it has been nice to get back to some form of normality and that has certainly been the case for the UK Hereford Cattle Society in 2022. While there is lots of good news to report from last year we must not become complacent as there will be significant challenges ahead in the future, such as a reduction of the suckler herd across the UK and challenges from other breeds.
At our spring show and sale in April at Shrewsbury Auction centre, bids reached £11,550 for bull Rempstone 1 Virus N598 from M Ludgate, while a new record bull average was set for 27 bulls sold to average £4,404 clearing at 79 percent. In the heifer section, a selective trade saw some impressive prices. Topping this section at £8,400 was the day’s grand female champion, Normanton 1 Blue Leg 13th V555 from TD and WT Livesey, Normanton-le-Heath, Leicestershire.
The Balmoral Show returned to its normal May fixture following disruption over the Covid period, making it the first major show in 2022 for the society. Northern Irish breeders put forward a strong entry of 46 cattle from 13 different exhibitors and were pleased to welcome South African judge PJ Budler
to the show to sort the line-ups. Taking the supreme champion title on the day was Dorepoll 1 Sally 679 from JE and RI and W Haire, Dundrod Co Antrim. Taking the reserve supreme was Richmount 1 Treadstone from James Graham, Portadown, Co Armagh.
Over the summer the country celebrated the Queen’s jubilee which was a great occasion and one we all relished and look back on fondly especially after the sad passing of Queen Elizabeth II.
The Royal Three Counties was where Sky High 1 Miss Allure from Boomer Birch, Graham Brindley and Nick Griffiths Staffordshire stood supreme, grand female and junior female champion. It was a quick turnaround for the society and then off up to the Royal Highland Show where Spartan 1 Typhoon from SC and GL Hartwight stood supreme and performance recorded interbreed champion, having already had a fruitful show season.
It is always difficult to highlight everything that is achieved at the shows but considering the last few challenging years the number of cattle on show have been down it has still been encouraging and credit must go to our members for their continued support and efforts.
The Lewis Bicentenary sale saw a number of breed records smashed by the Haven and Havenfield herds of EL Lewis and son and JW Lewis’ Boycefield herd on celebrating 200 years of the Lewis family continuously breeding pedigree Hereford cattle.
To mark 200 years of the Lewis family breeding Hereford cattle, HRH The Princess Royall visited the home farm of The Haven, Dilwyn, Herefordshire which was an honour for the family to host her at their farm. A picture has been donated to the family in recognition
of their achievements and is hung in Hereford House.
With the society’s official auctioneer Jonny Dymond in the rostrum, a fastpaced exchange around the ring saw bids fly to 20,000gns for Haven Thrush 74th, a September 2020-born heifer. In doing so a new female price record was set at public auction. This powerful and correct female can be traced back 22 generations to one of the foundation cows purchased in 1850 under the Lewis ownership.
At the society and under the guidance of council we continue with our programme of modernising and trying to improve the breed. This year has been about putting the building blocks in place to move forward on several fronts in 2023. Below you can see some of the areas that we have been working on: Genomics – council took the decision to move forward on this and make it available to our members.
Linear scoring – this is an assessment of an animal’s traits carried out by a panel of professional independent assessors who travel to holdings over the UK and are employed by Holstein UK
Work being carried out on updating our articles of association
Updating our registration software ILR2
Initiatives to help improve the breed which are based on the work which Dr Liz Genever has done through the sustainability project.


Looking to run some PR days to further develop our beef brand and retail/ consumer awareness
We have continued to market Hereford beef under the guidance of the Seed Group, with new material and a different look and feel which has been received really well.
Hereford Youth again has had an incredible year and it is great to see
our numbers so strong, and it remains an integral part of our society under the leadership of Emma Edwards. It is so important we give focus, time and energy to the next generation and it was so pleasing to see Emma and the team put on a great Charity Ball in November.

Laura Bowyer (marketing and breed development manager), Carolyn Fletcher (president) and I were lucky enough to attend the European Hereford Conference in France in October and to meet all our European friends. The French were impeccable hosts and had organised a great conference. We ended the year with the Christmas calf show where our entries were really
strong and what a great way to round off 2022. HCBA put on a fantastic show and should be congratulated for their continued support and commitment to the event.
Although we all face difficult challenges over the next few years, I truly believe that the Hereford is well -placed and suited to the new environment with their strong characteristics really coming to the fore.
Many thanks go to all the team at Hereford House, the continued support of council and members in making this role such a privilege to do.

I wish you all well for 2023.
laura.bowyer@
This year I have become somewhat over familiar with the M6 having travelled the length and breadth of the country to areas and shows, but it’s been well worth it having met so many people with a shared passion of Hereford cattle and the warm welcome and hospitality I’ve received. It was at times exhausting, but always enjoyable.
With shows and sales being almost back to normal, the number of entries were sometimes low, but what we lost in quantity was almost always compensated for in quality with some fantastic cattle on show.

Although shows are an important, enjoyable and social way of promoting our cattle and indeed morale boosting when a Hereford wins an interbreed which happens pleasingly often, they are only a small part of the function of the Hereford Cattle Society. The society must first and foremost promote the breed and its beef and oversee the day to day running of the society, which is both complex and time consuming, so we should empower our staff to apply their skills, energy and time as fits this criteria, which may mean we see a little less of them at shows.
It has also been hugely rewarding to meet breeders not only focused on showing, but with experience and focus on breeding pedigree Herefords on a commercial basis. These breeders have much to offer and should be brought to the fore and given a voice in the society.
The Haven sale commemorating 200 years of breeding Herefords was a tremendous and well-deserved success, a high spot in the year and a hugely enjoyable gathering bringing good publicity for the breed. During HRH Princess Anne’s visit to The Haven we were given the clear challenge when she asked ‘you have a great breed, why are you letting the Aberdeen Angus hold
the top spot?’. This is a good challenge and one we need to address. What are we lacking? Is it simply that we need to improve our promotion and marketing to bring Hereford Beef to public attention, or do we need to do something fundamentally different? With commodity prices painfully high, we must also make commercial breeders aware of the advantages of Herefords as a terminal sire. We breeders should take every opportunity to raise the profile of Herefords, selling our top cattle at official sales and getting headline grabbing prices. Private sales, however big, simply don’t make news.
Sommet de l'Élevage was an impressive showcase for French livestock with many international visitors, with such an event sadly lacking in this country since the demise of the Royal Show. The European Hereford Conference, which ran in conjunction with the show, was a good opportunity to meet and discuss Herefords with other nationalities
and to learn how they are tackling breed development. There is plenty of knowledge which can be shared.
The sustainability project reminds us that we need to ensure that we are breeding fertile, functional cattle with emphasis on maternal and beef traits. The introduction this year of geonomics and linear scoring will give us added knowledge to achieve this but let’s never lose sight of breed characteristics, without which cattle are just cattle, not a recognisable breed.
As we work on our cattle’s sustainability our next move should be to demonstrate the superior eating quality of grass-fed Hereford Beef. To this end, as breeders, we need to put more emphasis on beef traits such as inter muscular fat to aid tenderness and flavour.
The Hereford breed is a family, whether the cattle are Traditional, horned, poll or British Polled. All have their place and there should be no reason why they and their breeders cannot thrive in harmony and friendship jointly promoting this
great breed with pride. We know that grass fed Hereford Beef is best – let’s make sure the public gets this message.
As a breed we have a phenomenal foundation built over some 300 years, and as breeders we have the undeniable duty to do this justice by relentlessly
and unapologetically focussing on getting superior Hereford genetics on every plate in the country. This will be achieved through an obsession with quality, progressive collaboration with academia, embracing change, be it driven by commodity prices, net zero targets
or health benefits, and marketing our beef not only as the consumer’s beef of choice, but the commercial producer’s terminal sire of choice as well.
Finally my thanks to the staff at Hereford House for their help and friendship throughout the year.
David Smyth of the Co Down-based Magheraknock herd has been elected as president of the Hereford Cattle Society for the year 2023.

A society member for the past 20 years, David is best known among breeders of the horned strain, keeping 30 cows.
Now semi-retired, David has run a successful financial planning business for the last 40 years but now has more time to concentrate on his cattle.
David regularly shows at both Balmoral and the Northern Irish National Show. Furthermore, he spent eight years as secretary of the Northern Ireland Hereford Breeders’ Association, was association president last year and has also carried out the role of treasurer.
Looking at the national picture, David is now in his twelfth year on the council of the Hereford Cattle Society and is also a previous host of the National Hereford Club AGM and farm tour.
On his election, David commented: “I am elated to have been elected president of the Hereford Cattle Society. I am now the sixth president to come from Northern Ireland, and I am looking forward to being the ambassador of the breed at the various events across the UK during 2023. I have been encouraged by many emails, texts, etc. from well wishing breeders throughout the country.”
He continued: “I think we are moving into an opportune time for the breed. With increasing costs for feed and fertiliser, our breed has to be a serious consideration being low maintenance. I look forward to meeting with many
breeders during the year ahead to discuss our shared passion.”























1. Solpoll 1 Perfection - SC and GL Hartwright
2. Moralee 1 Rebel Kicks KS R12 - T and D Harrison
3. Normanton 1 Laertes - TD and WT Livesey



1. Spartan 1 Typhoon - SC and GL Hartwright
2. Buckenhill 1 Trans Am - M Gray and L Crowther
3. Harveybros 1 Va-Va-Voom - G and S Harvey
1. Pulham Pansy 26th - E and J Lake
2. Free Town Gift - RA Bradstock and partners
3. High Hedges Diadem 9-21 - Mrs S Cowle

1. Spartan 1 Duchess T95 - SC and GL Hartwright
2. Coley 1 Duchess 609 - Miss H Whittaker

3. Sky High 1 Miss Allure - B Birch and G Brindley and N Griffiths

1. Free Town - RA Bradstock and partners
2. Pulham - PRJ and LR Vincent
3. Borovere - E and J Lake
1. Free Town Versatile - RA Bradstock and partners
2. Free Town Vaughan - RA Bradstock and partners
3. Haven Silvester - G Davies
At the society’s annual awards dinner, SC and GL Hartwright snapped up the majority of the evening’s awards.
After a very active and successful summer show circuit, visiting shows from the Royal Highland to the Royal Norfolk, Simon and Gemma Hartwright’s Spartan herd was a volume award winner at the Hereford Cattle Society’s annual awards dinner, taking an assortment of silverware back home to Oxfordshire.


Bull of the year was among the herd’s victories, with Spartan 1 Typhoon named as the winner, with points accumulated throughout the year’s show calendar.
The Hartwrights’ triumph in the show ring have increased in recent times, having won a string of breed championships last summer with Typhoon the most successful animal to come from the Spartan stable to date. Born in February 2020, Typhoon is a son of Solpoll 1 Perfection, and out of Panmure 1 Plum K19.
Spartan 1 Typhoon was also named poll bull of the year on the night. This bull’s successes include supreme champion at the National Poll Show, the Great Yorkshire, the Royal Highland, Bucks County, Shropshire County, Burwarton and Royal Norfolk.
It was Typhoon’s sire, Solpoll 1 Perfection, which took the much anticipated sire of the year title. Bred by Northern Irish breeders John and William McMordie, the Hartwrights made its purchase at
the 2019 society spring show and sale for 8,000gns. It is a son of the renowned Panmure 1 Henry which has really produced for the Northern Irish breeders.
From the same stable, Spartan 1 Duchess T95 was announced as female of the year. This February 2020-born heifer is out of Ruckmans 1 Orange 1332 and
by the now current UK sire of the year, Solpoll 1 Perfection.
The trophy for poll female of the year was also presented to the Hartwrights for Spartan 1 Duchess. Duchess has had an active show season, and was tapped out as female champion at the Great Yorkshire, reserve supreme and female champion at the Royal Norfolk and won its class at the Highland and reserve female champion at Shropshire County. It therefore came as no surprise that SC and GL Hartwright also headed to the front of the room to receive the show herd of the year accolade. With stockman Luke Murphy at the helm, the
Spartan herd has enjoyed one success after the other this year, making it its most fruitful year to date.
In the horned Hereford awards, the horned bull of the year was received by Tony Bradstock of RA Bradstock and partners, Tarrington, Herefordshire for their success with November 2020born Free Town Versatile. A Moyclare Quinlan son, this bull is out of Free Town Penchant, which carries generations of Bradstock breeding on its dam side and stood reserve grand male champion at the National Hereford Show, Shropshire County and the Royal Three Counties.
Horned female of the year was named as
September 2020-born Pulham Pansy 26th from first time exhibitors James and Ellen Lake, Froxfield, Hampshire, a firsttime exhibitor at the National Hereford Show, where it stood reserve supreme and grand female champion. Hereford Cattle Society members since 2019, Pansy was purchased from Philip and Laura Vincent from their Norfolk-based herd as a calf atfoot to its mother Clipston Pansy T3.
Returning to RA Bradstock and partners was the horned herd of the year title which was also won by the breeders in 2019 when the awards were last held, having had success at the National Hereford Show, Shropshire County and Royal Three Counties.




















































 by Neil Shand
by Neil Shand
A year on, what has changed? Well, three prime ministers, four chancellors and three DEFRA secretaries later, there is a sense of change to come, but its detail is far from transparent, and pathetically slow in its roll out.
I have consistently and persistently challenged DEFRA with the accusation that the Environmental Land Management (ELM) scheme is not fit for purpose, and I’ve seen nothing yet to change my mind. However, there are strong rumours that change is on its way, driven by fear of food shortages and supply problems; a fear that has certainly been fuelled by the war in Ukraine.
It is incredibly sad and more than a little worrying that government couldn’t see it for themselves - that it needed a war in Europe to make them wake up and smell the coffee. I hope that my optimism that real change is coming is not misplaced.
It’s six and a half years since the Brexit vote, two years since we left the EU, and still we have an industry desperately crying out for substance on future agricultural support. Cows are disappearing fast, input costs are escalating exponentially, and our producers are feeling the pressure. However, there does appear to be a slow but definite change in mindset. Producers are saying no to lower prices, no to being bullied within the supply chain, and no to continuing to lose money.
As an organisation, we will continue to beat the drum loudly in the corridors of Westminster and strive for the right type
Neil Shandof industry support. Our members own the land and the ruminants. Collectively we can deliver environmental gain and food production which are the two things Government want, but somehow seem unable to link. They need to provide incentives to allow the industry to deliver what they need, not beat us with a metaphorical stick.
The fact we have made so little progress in a year can justifiably be laid firmly at the door of the government, and can –and should – be used as a catalyst to ensure we are not sitting in the same position beating the same drum this time next year.
At the time of writing, every major public service is talking about strike action. It seems there are many with short memories. Business upon business received government support during Covid and they, in turn, appear to have poured the goodwill down the proverbial drain. I’m not taking sides, but neither can we bust the country, nor do we want to end up with food shortages.
The reality is that we are facing massive
contraction from the industry across all sectors. In ours, it’s likely the suckler herd will decrease by a double-digit figure. This is happening alongside a dramatic increase in beef-bred dairy calves being slaughtered at a young age due to the cost of feed. This is not a good combination, and will lead to a major shortage of British produced beef in two years’ time.
Beef Expo 2022 was a tremendous success, undoubtedly contributed to by the lack of the event during the pandemic. The board has considered this and believe that to keep the event fresh and thriving, it should be held biannually. Therefore, we will not host an event in 2023 but we will return again in 2024 with a venue and date being announced very soon.
Amidst all the challenges, we have to remain positive. Demand for beef for Christmas was good. We need to further embrace the support we get from the consumer, build on it, and ensure the demand for home-grown remains strong, securing a vibrant trade for British beef.
In 2022, three society members won awards at the prestigious Farmers Weekly awards held at the Grosvenor House Hotel, London in October
Taking the Beef Farmer of the year was Simon Cutter of Coldwell Herefords based near Ross-on-Wye, Herefordshire. Simon farms the last remaining county council holding in Herefordshire. At Model Farm, he has developed a lowcost suckler beef enterprise as part of a diverse, fertility-building crop rotation. He runs a split-block calving system for his herd of pedigree poll Hereford cows. Year-round finishing ensures a consistent supply of beef for the farm’s butchery and shop.
Two animals are slaughtered each week at 24 months, with a target weight of 620kg liveweight off forage only.
A founder member of the Pasture-Fed Livestock Association (PFLA), Simon farms to organic and PFLA standards.
In the early days of the farm’s Higher Level Stewardship scheme, now 20 years old, he got a derogation to outwinter and bale-graze his cows to reduce cow maintenance costs.

“Everyone thought I was totally loopy, but starting from nothing it was the only way I could do it,” he says.
While he is a great supporter of the British Polled, his focus is on New Zealand genetics, which have been ‘a revelation’ in terms of improved performance off grass.
Simon uses estimated breeding values (EBVs) to drive improvements in the herd. Having successfully selected for maternal placidity, calving ease and longevity – cows have at least eight calves – the focus now is improving marbling and eye muscle from foragetype bulls.
As well as grass, grazed rotationally, and clover-rich herbal leys, lucerne is grown for protein and to counter drought.
Simon takes three to four cuts a year, which are clamped in alternating layers with an arable silage of oats, barley, peas and vetch.
Woodchip, supplied free from local landscape gardeners, is spread in the finishing shed at the start of winter.
Simon buys in straw for bedding, which is then composted with the woodchip before spreading in the first year of the crop rotation.
Annual beef costings are £202 a cow, including 120 days of winter feeding on hay and deferred grazing with young calves, at 40p/day. Producing a 300kg weaned calf is costed at £243.
Once this is added to second-year costs, a finished autumn-born calf costs £404 to produce, and a spring-born one, £492, plus Simon’s time.
The business employs two full-time butchers and specialises in supplying beef for customers following ‘stone-age’ and ‘keto’ diets, which favour grass-fed meat, as well as those interested more generally in a high-quality product.
Beef is sold online through Primal Meats and Back to Nature, via a local box delivery scheme, or at the farm’s shop attached to the butchery cutting room.
Bones for broth are sold at £5/kg, while fillet steak costs £35/kg.
Simon’s two sons, George and Jonty, look after marketing and delivery runs.
Ian Boyd of Whittington Lodge Farm, Gloucestershire is Farmers Weekly’s Grassland Manager of the Year.
Ian Boyd is hugely passionate about improving on-farm habitats for wildlife, and what makes his system so impressive is that he is managing to do that without compromising on profitability.
He is cleverly using grassland to both provide for his 45-head Whittington Hereford herd, with all meat sold directly, and drive production on arable land.

The farm’s total grassland is made up of 65 hectares (161 acres) of wildflower meadows, 35ha (86ac) of permanent pasture and 70ha (173 ac) of herbal leys, all split into paddocks.
His low-cost, organic system sees cattle mob-grazing the various types of grassland on the farm, with long rest periods in between to allow for flowering and seed setting.
Swathes of the farm which used to be conventionally managed cereal fields are now established wildflower meadows, the oldest of which contains 43 different species and features a sea of orchids.
With more than 2,000 individual homes ordering beef from the farm on a regular basis, year-round supply from the late spring-calving herd requires strategic grazing plans and daily moves.
Grazing management is the same across all grassland and follows the principle of holistic grazing animal days a hectare, alongside a ‘gut feel’ based on years of experience.
Good resource use sees the cattle predominantly based on the older pastures, while multispecies leys are grown on arable land and cut to drive soil improvement and crop production. All paddocks are surrounded with mains electric-powered fencing. This can be remotely controlled, which has been a huge time-saver.
The herbal ley mixes contain no less than 15 species, under-sown in barley crops for successful establishment.
Ian now also increases the level of sainfoin in the mixes because the cattle like it and it helps control bloat issues. Despite having a successful, profitable system already, Ian is constantly researching new ideas.
Keen to reduce the need for conserved fodder, he is exploring ways to minimise hay and silage-making and keep youngstock outside over winter.
Ian believes the 100 per cent grassfed production system is what gives the farm’s beef its unique flavour and has created its popularity with repeat customers.
• Low-cost, pasture-fed beef system, using nature-friendly methods to add value
• Excellent herbal ley establishment and management, achieving strong regrowth
• Evolution of species-rich wildflower meadows
• Drive to continue to improve through different grazing management methods
• Passion to share experience and skills with others in and out of agriculture
The grassland system is also protecting both the beef and arable enterprises from rising input costs, while improving soils and on-farm biodiversity.
Ian’s passion, which is shared by his daughter and business partner, Steph Ackrill, has driven them to develop a multipurpose centre in the farmyard called the Sainfoin Centre, building on the farm visits they already host.
Not only will this provide another income for the farm, but their hope is to host the public, students and established farmers to share their story, knowledge and ideas around regenerative farming.
Ben Chilman of Kinsham Herefords, Presteigne, Powys won Farmers Weekly’s Awards 2022 Ag Student of the Year. Farming will always need passionate, knowledgeable and diligent supporters to fight its corner and remind people that a prosperous agriculture industry is vital to society.
One such ambassador is Ben Chilman, an ambitious Harper Adams graduate having studied Farm Business Management who impressed the judges with his achievements at university and his work to improve mental health awareness within farming.
Whether he is behind the microphone, out in the fields, or attending industry events, his enthusiasm for UK agriculture is evident in everything he does.
Ben’s podcast, EweTurn, has been praised for its light-hearted but candid conversations about agriculture and important industry issues such as mental health. Ben is a keen football commentator, covering his local club Hereford FC, and travelled to Wembley Stadium in May last year to cover the FA Trophy final.
The 22 year old wants to one day run the mixed family farm, but has his sights set on a career in the farming media, having shown himself to be a talented broadcaster.

A successful placement year with the Co-op saw Ben lead on several projects to promote British produce, as well as organise training for supermarket colleagues and chair meetings with farmers. He says this boosted his confidence and increased his industry knowledge.
He says “It pushed me to see a completely different side of the food chain, which is what I wanted to do, and as a result I’ve learned to produce
what people want on the supermarket shelves.”
A meeting with the DPJ Foundation for Co-op farmers to talk about mental health awareness inspired Ben to create the EweTurn podcast with his friends, Ted and Nog.
“It was the best-attended farming group meeting we had in the 12 months I was there, and that was a complete eyeopener to the issues that are out there
and how people want to learn more,” he says.
“I came away thinking surely there is more I can do.
“The podcast is a way to get people talking in a light-hearted way – we wanted it to be quite funny so that it wasn’t just talking about mental health, it was keeping it upbeat as well.”
Ben says he has been taken aback by the support for the podcast. The fortnightly episodes are averaging 1,000 listeners and the podcasters hope to hit 50,000 downloads by Christmas.
The judges were impressed with Ben’s ability to juggle his commitments without letting standards slip.
He takes an active role on the 405ha (1,000ac) family farm and has helped introduce better yield monitoring for the cereal enterprise.
He has also been a member of Presteigne Young Farmers’ Club for the past 10 years and is set to become its next chairman.



“This has led to further changes on how shoppers buy their groceries. Primarily, this change is made in the form of the store they shop in, or by moving away from branded products.
The World Steak Challenge held in late September 2022 in Dublin for the third year, saw the Waitrose No.1 Dry Aged Hereford Sirloin Steak gain the accolade of gold medal winner.

Karen Howarth, category and marketing manager at Dovecote Park, says: “We are thrilled to have another award-winning product in our range.
"We have been applying a gold medal winning sticker to all packs, and with over 200 five-star reviews on their website, Waitrose customers also agree this is a fantastic steak.”
The long-awaited competition put the planet’s finest cuts to the test and gave steak producers and suppliers the opportunity to showcase product quality on a global stage. Categories for 2022 were fillet, ribeye and sirloin.
The World Steak Challenge prides itself on a completely robust and independent judging process. Every steak is judged on its own merits against the internationally agreed judging criteria. Firstly, steaks are scored blind on raw and cooked criteria by the expert panel of judges. Then, top scoring steaks are tasted and tested by consumers drawn from a wide range of nationalities and expertise.
Commenting on the current state of the wider industry, Karen says: “Following the
challenges reported in previous years, there was hope that 2022 would prove to be a little easier to navigate.
“Instead, labour shortages and increased ingredient and packaging lead times have become the norm, and now customers are experiencing significant inflation across all categories of the grocery industry.
She continues: “For those who attended our 25 year celebration back in September, you will have heard from Simon Moore, Waitrose fresh food trading director, about how Waitrose expect their shoppers to switch their spend to both the retailer’s Essentials and No.1 brands.”
As households manage their budgets, and as seen during the pandemic, Waitrose expects sales of their premium products to increase as their shoppers reduce the number of trips to restaurants and re-create that experience in their own homes instead.
"Dovecote Park continued to offer the same fantastic range of Hereford products in Waitrose stores throughout 2022, the majority of which are branded in their premium No.1 tier."
Hereford Beef has again been recognised for its quality and this time wins gold at the World Steak Challenge.
The passing of Queen Elizabeth II in September 2022 saw the end of an unbroken run of some 170 years of association by the British monarchy with the Hereford breed.
Although never a breeder of registered Herefords herself, The Queen, during her childhood would have recalled the work of the Windsor herd founded by her great-great-grandfather, Prince Albert, Queen’s Consort and on many occasions during her long reign this celebrated monarch came face-to-face with the presence of the Welsh border breed.
It was reported that following his visit to the Royal Show of England, held during 1851 and in Windsor Great Park, Prince Albert was so impressed with the magnificent turnout of the white-faced breed, led by Walford, the celebrated bull of Lord Berwick, that he pursued the establishment of a Hereford herd on the Windsor Estate. The farms had kept Hereford cattle and indeed had bred winners at Smithfield Show, notably in 1848 when an ox bred there was awarded first prize.
By 1855 a registered herd was maintained at Flemish Farm within Windsor Park with the foundation females being obtained from Lord Hereford, Tregoyd, near Hay-on-Wye; Lord Radnor, Coleshill, Berkshire and Walter Maybery of Brecon. The herd developed well and at the 1862 Royal Show held as the ‘international show’ at Battersea, Maximus, bred and exhibited from Fleming Farm won the senior bull class. This being the last time that a bull registered as being without a white face won any major accolade.
The male champion that day was Milton, exhibited by Richard Hill of Golding Hall, south of Shrewsbury. It was the first time a male champion had been selected from the exhibits and was to celebrate the specially arranged English Royal. Unfortunately, Prince Albert did not witness the occasion - he had died the previous December. The victory, however, was of some solace to the mourning Queen so much so she decided to retain the Hereford herd her
husband had founded. This relationship again developed in 1865, honouring breeders by becoming the patron of the Herd Book of Hereford Cattle, following on from the Prince Consort who was the first to take that office in 1858. Queen Victoria then became patron to the Hereford Herd Book Society when it was formed on 5 March 1878.
Queen Victoria enjoyed success as a Hereford breeder. At the English Royal of 1870 held at Oxford, she bred and exhibited Prince Albert Edward to win the two year old bull class and was sold for export to W Robinson of Lake Colac, Victoria, Australia. The Queen’s herd won this class again in 1889 at the Royal held at Windsor, this time with Favourite bred by John Price of The Court House, Pembridge. Then, great success in 1898 when again the monarch won the two year old bull class at the Birmingham Royal, this time with the home-bred Robin. Her Majesty’s exhibits also won the cow class with Truthful, an eight year old, another bred by John Price. At

The Royal family has a long affiliation with the Hereford breed, going back to 1855. During the many decades on the throne The Queen came into contact with a number of society members over a period which saw great change in the breed.Maximus, bred and exhibited from Fleming Farm won the senior bull class at the 1862 Royal Show
Smithfield Show in 1900, Queen Victoria won the supreme championship with her highly acclaimed ox. This beast had been awarded over £800 in prize money over three winter seasons before being sold at its final London event for £150. This long-lived monarch had achieved much: top winners and exports that led to overseas’ successes. She had made her mark in cattle breeding.
Her roles as a breeder and patron to the breed society were taken on by her heir to the throne, King Edward VII. The new monarch was a keen supporter of the breed and indeed had increased the number of cows kept. His investment was paying off. In 1903 the Windsor herd bred and exhibited Fire King, sired by Earlsfield, the massive portrait of which currently hangs in the board room of Hereford House, and was champion at The Royal held at Park Royal, London. This venue was the first attempt by the English Royal Society to develop a permanent site but by 1906 this project had failed. Fire King repeated his win at the 1904 Royal at the same venue and another son of Earlsfield, the yearling bull Diplomatist, won his class. The 1906 Royal was held at Derby and there was another class winner for the Windsor herd with Admiral, another Earlsfield son, winning the senior bulls. Admiral was to be the sire of the 1917 Royal Champion, Avondale, bred by Edward VII but exhibited by his heir, George V. In 1920 the new monarch was out buying.
The Royal herd purchased Carnation, a double Starlight-bred cow, for 1,000gns at William Griffiths’ record breaking Aldersend dispersal sale when the 104 head averaged £474.16s.
At Smithfield Show in 1921 King George V was an enthused visitor witnessing his heifer, Laurel, taking the Hereford championship and at the Royal in 1922 held at Cambridge. He took the two year old heifer class with Radiance 2nd, described as a ‘sweet heifer’ sired by Twyford Triumph. In 1923 at the principal February sale at Hereford, Windsor Star sold at 310gns and Windsor Gambler

at 270gns were champion and reserve and the two highest sellers. Both were by Lulsley Statesman bred by Thomas Powell of Worcester. This just illustrates the work and research carried out by the managers of the Royal herd. Time and time again they achieved top results with genetic mixes which were far from fashionable, in-fact breeding that was obscure. The herd achieved much by using animals that hardly anyone else had heard of or followed but one of the most consistent features was that often their origins appeared to have been in Wales.

At the Royal Show of 1924 Lulsley Statesman was doing it again and sired two female class winners, Peerless and Lavender Lass. At the March sale in 1926, the King sold Windsor Equerry at 250gns to P and G Hughes for export to South America.
On to February 1935 and the Windsor herd was on the lookout for a new sire. The one selected was a non-prize winner at the Hereford show and sale, Sultan, and at the equal second highest price of 300gns from CD Jones of Erwood, Breconshire. Again, not a household name but from Wales. Sadly, King George V passed in January 1936. He had been a devoted Hereford breed enthusiast and a successful breeder. He was, of course succeeded by Edward VIII. The new King’s Hereford breeding activities had an impressive start by taking first prize at the Royal with Sultan, the bull picked
out for his father at Hereford. By the end of the year the King had abdicated and the Windsor herd passed to his brother, King George VI.
By now the Windsor herd numbered just a handful of breeding females but in 1939 they still involved themselves with exporting two heifers as part of a large shipment to Russia. In April that year, the last calf was registered, Carnation 5th bred up from that purchase at Aldersend. Nearly 85 years of Hereford cattle breeding had been accomplished and an even longer interest of the breed and in this time every monarch and Prince Albert was patron, initially of the herd book but to be followed by the society responsible for producing it. George VI continued to be patron until his death. Three days before Windsor Carnation 5th was born, Princess Elizabeth celebrated her 13th birthday and although the Royal herd no longer continued, following the time that she became Queen in 1952, there would be many regular engagements with the breed that had flourished at Flemish Farm.
Of all of the agricultural organisations around, the Breconshire Agricultural Society is the oldest that still exists in UK if not the world. Founded in 1755 it celebrated its bi-centenary show on 6 August 1955 when the Queen and the Duke of Edinburgh made a visit. It was The Duke who tapped-out the breed champion in the form of the 18 month old, Baysham Kismet from Charles Rudge and family from near Ross-on-Wye along with Noble Sam
from the same home to the position of reserve male champion. The female championship went to the breed’s oldest herd, then as it still is now, with Leen Splendour taking the honours. The Queen presented the trophies to the successful exhibitors. Later both of the bulls were exported. Kismet to the famed Sypherpan herd of the Moorcroft family in South Africa and Noble Sam to a partnership of breeders in Texas and New Mexico, USA.
It wasn’t long before Charlie Rudge met up with the Royal couple again where Noble Sam won breed champion at the Norwich Royal of 1957 and became bull of the year. A special parade of champions was arranged for The Monarch to inspect the breed leaders.

On Wednesday 24 April 1957, The Queen and Prince Philip visited Hereford. Part of their trip was to view the improvements made to the livestock market. This phase of development was centred around the new cattle lairage facility and the Langford sale ring. This latter feature was developed with the Hereford cattle sales in mind. Few sale rings would have the capacity of this one for the number of people that it could comfortably accommodate. The Hereford breed was also on display in the form of three ‘family’ groups with the previous three Royal champions at their head.
The first group was from Owen Hellyer’s Eaton herd. Here The Queen reacquainted herself with the Hereford and Queen’s Cup champion of the Windsor Royal of 1954. With Eaton Eastern Venture was Eaton Countess and bull calf by this celebrated champion, Eaton Invergordon. The second trio to inspect came from the Jones family of Penatok Herefords. The unbeaten Penatok Crusader led this group and with him were the heifer Penatok Countess and a bull calf Penatok Fiesta. The third group came from EL Lewis and son of The Haven, Dilwyn. This group featured the 1956 Royal champion Vron Gaffer along with Haven Gertrude 8th and a bull calf, Haven Nobility.
The Queen very much appreciated the display and showed much interest in the exhibits. She also commented on the presentation of the cattle before her and praised the concise nature of

the arrangements. Hosting the Royal party during the visit was the society’s vice-president, Jack Weyman-Jones. Unfortunately, president Bill Milner was not too well but was present to greet the visitors upon their arrival to this memorable gathering and sadly died at the time of the 1957 Royal Show held at Norwich where his Wenlock herd took awards.
The Royal Smithfield Show in London of 1965 saw The Queen hand over the supreme championship trophy and The King’s Perpetual Challenge Cup for the best exhibitor-bred beast to Barnoldby Orange Miss from Roy Osmond and family.
The Three Counties Show of 1968 was a right Royal occasion. The Queen visited the show on the permanent showground at Malvern and viewed the judging of the Hereford classes carried out by Major Geoffrey North of Tiverton, Devon. There were 183 entries catalogued and the champion was Penatok Nobel from AE and DO Jones of Penyrwrlodd, near Hayon-Wye, Breconshire. Queen Elizabeth was accompanied in the judging ring by breed president and stalwart of Herefordshire, Frank Smith.
On 21 May 1975 The Queen visited another Welsh Border show, this time the Three Counties Show, which was celebrating its centenary. Her Majesty visited the Hereford judging ring and watched Herefordshire-born Australian, Richard Morgan Jones select the winners of the senior heifer class then proceeded


to present awards. The winner was Shraden Pansy 6th, sired by Bwlchllyn Carlos, and paraded by Hazel Everall. As ring steward, her father Roger looked on escorting, The Queen, together with the judge, along the line of winners. Pansy 6th was tapped out as reserve female champion behind the junior section winner, Sherlowe Model 139th, sired by Wenlock Surprise, bred and exhibited by Jim Everall, uncle to Roger.
Following the disaster of the 2001 foot and mouth tragedy, spirits were on the way up as exhibitions were reintroduced during 2002. None more so than at Stoneleigh when Queen Elizabeth II
attended Burke Trophy day at the Royal. The Hereford classes had been judged by Australian Ian Watson. His male and breed champion was Onondaga Pure Gold exhibited by Jack Henry of West Yorkshire. Jack had bought this prospect at four months of age from breeders, Gil and Molly Henderson of St George, Ontario, Canada, who visited the show to witness proceedings. The female winner came from famed Scottish duo, John and Margaret Cameron of Balbuthie, Fife. Their cow, Baldinnie 1 Oakland 4th presented by John Brown was impressive and the two were well paired for entry into the Burke Trophy competition.
The judge for the event, who had had to wait because of the 2001 cancellation was Thomas B Turner of The Ohio State University, Columbus, Ohio, USA. Thomas worked in the Animal Sciences Department, travelled widely and regularly took up judging appointments. Thomas was looking for animals that were sound and correct in their skeletal design and functional from a reproductive standpoint. He also looked for width of skeleton, muscle mass and fleshing ability, in addition to a number of other qualities. He stated that, ‘the Hereford pair had a superior combination of all the above’, and were awarded the Burke Trophy. To present the trophy to breed president Richard Bradstock was The Queen and Prince Philip. It was the breed’s first overall
win in the Burke since 1979. The Queen informed Thomas that she was pleased he had selected a native British breed. A sincere comment as The Queen knew about these things.
She was a breeder herself, not only of cattle but of many species. She firmly understood the challenges of farming livestock and feelings of success in this task of getting things right. These are just a few examples of Queen Elizabeth II’s involvement with the Hereford, at Windsor up to her teenage years, at many events on her travels around the UK, throughout the Commonwealth and beyond. She will have always been pleased to have seen that familiar stamp of the white faced Hereford. Her face, her sincerity and her presence will be greatly missed.
As a monarch, Queen Elizabeth II was well in-touch with rural life and farming. In fact the Royal farms are very well run, successful and at the cutting edge of production and marketing. Their livestock are high performers: the Jersey


dairy herd the largest in the UK and of top genetics; the Sussex beef herd, well respected and productive.

The Queen was knowledgeable and interested in farming topics and had many other enterprises on other Royal estates. An image that will last long in the memories of livestock people is connected with the June 2022 Trooping of the Colour when the Queen came out onto the balcony of Buckingham Palace to inspect the spectacle armed with a shepherd’s crook. Like any seasoned professional at a show, event or livestock market she leant on it concentrating on the activities.
On her passing a few months later the world said farewell to one of the greatest humans that had ever lived. Her like will probably not be seen again. But everything moves on and now the assets and responsibilities of the Royal farms are in the hands of King Charles III and many of his previous commitments being handled by the new Prince and Princess of Wales.
The incoming monarch has long been associated with extensive agriculture and environmental matters. The credentials of the Hereford that can fit into livestock farming of the future could well be considered under the incoming management. The heritage, achievement and interest of his family over many generations may well pave the way for the Hereford breed to once again have a future with the British Royal Family.
over the last five years and plan to replace all f-gas systems with net zero refrigeration systems by 2030. To heat water on our sites we are upgrading equipment to burn lower carbon fuels and switching to renewable sources of thermal energy generation such as electricity and renewable sources of heat recovery such as heat pumps.”
At Dunbia, we recognise that our future relies upon the health of our natural world and the wellbeing of our communities, says Matthew Rollason, agricultural manager at Dunbia.

Sustainability has been at the centre of Dunbia’s business plan for over 20 years, and this means taking responsibility for business impact by making a positive contribution to the environment and society.
Matthew says: “In December 2022, we were proud to launch our landmark blueprint for building a more sustainable food system – Plan Four Zero. We have four ambitions focused on the environment, farming, food and society, which outlines how Dunbia will reduce emissions within our operations and supply chains, protect and restore biodiversity, inspire more sustainable farming and support communities on the journey to net zero.
“We have a target to reach net zero emissions across our sites by 2040, and align our supply chain target with 1.5 degrees, placing us on a net zero trajectory by 2050.”
Across Dunbia’s sites, they will continue to procure 100 per cent renewable electricity and aim to install solar panels to progress towards on-site renewable energy generation.
Matthew continues: “We have progressively reduced fugitive emissions
Dunbia plans to switch 100 per cent of the company fleet to electric vehicles by 2030. They are also supporting biodiversity at our sites and in our communities, installing beehives, planting trees and permitting areas to go wild.
“In order to meet our supply chain target of 1.5 degrees, we understand the important role that our 18,000 farmers across Great Britain and Northern Ireland play,” says Matthew.
“Each year, we invest over £2m to demonstrate best practice, fund knowledge sharing initiatives and invest in research and development projects which is delivered through our dedicated, in-house agriculture and procurement teams. We work closely with industry groups, customers and farming organisations to enhance the performance of the sector, while supporting the traditional family farms of our beef and lamb supply chains.”
Through Dunbia’s farming ambition, Farm Green, they are actively working to inspire more sustainable farming. Every month, they upload videos and webinars which focus on sharing knowledge in areas such as animal health and welfare, genetics, biodiversity, climate, soil, meat quality, water and nutrition.
“Farm Green allows us to showcase best practice in sustainable livestock production, while giving farmers the opportunity to stay connected with the rapidly changing industry requirements we are seeing, in real time,” continues Matthew.
“In 2022 we established a UK supplier carbon footprinting project to set a new baseline from which to accelerate action and reduce emissions. We are investing £1m in this project, which is part funded by Innovate UK, to measure the carbon footprint of 500 farms and establishing farm specific plans and roadmaps to help them reduce emissions, with progress monitored every 18-24 months.”
The Conception to Consumption (C2C) project, is an Innovate UK funded project which sits at the forefront of the group’s strategy and vision for sustainable beef. In collaboration with Dunbia’s partners Breedr and SRUC, the objective is to produce better beef by understanding and improving the efficiency and quality of the beef supply chain.
“We have worked with over 50 suppliers throughout England, Scotland and Wales who have enrolled in the supply of 12,000 cattle from six breeds, including Hereford, and their lifetime performance data to the project. In addition, DNA, abattoir and eating quality data was also collected and analysed to support the project’s outcomes, which Dunbia plan to publish in early 2023.”
Dunbia has launched a new plan to become net zero across all of its sites by 2040 while also promoting sustainable farming systems.Matthew Rollason

Having worked to promote Hereford Beef on behalf of the society since 2021, specialist food and drink digital marketing agency Seed explains how their work progressed in 2022.
As a Herefordshire-based specialist food and drink digital marketing agency, Seed Group is pleased to have recently renewed its contract with Hereford Cattle Society, working on the promotion of Hereford Beef.
Initially engaged in late 2021, Seed Group has been working to drive brand awareness and differentiation, increase consumer understanding around the breed and beef, and establish a more cohesive and engaging on-brand experience for all of Hereford Beef’s social media channels.
With strong Herefordshire roots, Seed has an end-to-end understanding of farming and the food and drink industry. Combined with their insights and experience, this has meant Hereford Beef has seen a significant increase in brand awareness.
Phia Folkes, managing director at Seed Group, says: “We have focused on Hereford Beef’s key messages around welfare, sustainability, taste, and quality, using social media to increase consumers’ understanding and trust of Hereford Beef as the better beef option at the critical buying moment.”
The plethora of in-house agency talent has allowed the Hereford Beef social media campaigns to span as far as
consumer recipe creation. Using a variety of Hereford Beef cuts, Seed’s in-house chef has developed a range of campaign recipes for key occasions, including valentine’s day, barbecue season and Christmas.
Simultaneously, it has been vital for these recipes to respond to consumer demands for simple, budget-friendly and crowd-pleasing meals and showcase the best of complementary seasonal British produce, explains Phia.
Working with like-minded brands such as Beefy Boys, Savernake Knives, and Sublime Butter has enabled the Hereford Beef social channels to experience a significant uplift in engaged audience and follower growth.
Phia says: “In addition, as part of our social media strategy, we have focussed on relationship building and raising the profile of Hereford Beef through working with well-known foodie social media influencers and chefs whose audience is likely to purchase Hereford Beef, enabling us to target the right audience and increase the credibility of Hereford Beef through social proofing.
“Through partnering with relevant, well-vetted influencers, we have created a community of ambassadors celebrating and showcasing Hereford Beef across social media. This influencer activity allows us to reach much larger audiences, extending our reach and driving credibility into the brand.”
Seed Group has also used a family-run butcher, Heggies of Hereford, to dispatch selected cuts of Hereford Beef to
competition winners or influencers and provide the meat for our recipe creation. Since the partnership began, the agency has established a portfolio of highquality photography created in-house focusing on seasonal recipes, the variety of Hereford Beef cuts, food pairings and cooking methods and techniques.
Key messaging has been enhanced with strategic paid support.
Phia explains: “Alongside our organic activity, we have employed hypertargeted paid social strategies during key campaign periods to increase reach, awareness, traffic, and engagement.”
Some of this paid activity has driven traffic towards key retailers such as Waitrose, Lidl and Coop whereas other activity has been focused on the Hereford Beef website.




“As an agency, we have generated over 4.5 million impressions in the past year on Hereford Beef’s social media channels and increased the channel’s followers by over 107 per cent.
“We continue to create engaging

content and grow the social channels to ensure the attraction of new Hereford Beef customers and drive further loyalty with existing customers, offering new ways to enjoy Hereford Beef, the health benefits of the meat and details on where to buy.”

Looking forward, Seed Group has a number of exciting seasonal campaigns in 2023 to align with key events which will educate and encourage consumers to choose Hereford Beef whenever relevant or possible. In addition to this, their campaigns have been developed in response to current consumer needs and relevant global topics, for example the cost of living crisis and sustainability.
Phia says: “We are delighted with the success that Seed’s fresh approach to Hereford Beef’s social media channels is generating and the increased brand loyalty and awareness. We are very much looking forward to continuing this successful partnership with Hereford Beef.”

Dr Liz Genever has been heading up the society’s sustainability project. She explains why the Hereford plays a key role in the future of sustainable beef production.
It is not the cow; it is the how
There is a growing movement towards the idea of ‘it is not the cow; it is the how’, which encourages consumers to move away from thinking all cattle production is bad, towards them having a positive impact on the environment, explains Dr Liz Genever.
Grass and forage-based systems can have the most positive impact on bolstering a herd’s environmental sustainability.
Liz says: “Grass and forage-based systems tend to use lower inputs, such as fuel and electricity for processing and transporting feed. If the focus has been on clover and other legumes, we can move away from using artificial fertiliser, which can also have massive impacts on profitability.”
Hereford cattle thrive in grass and forage-based systems, as that is what they were initially developed to do, Liz explains. There is a very high representation of Hereford cattle on pasture-fed farms, due to their easy fleshing abilities, including those within the Pasture-Fed Livestock Association.
“An advantage of grass and foragebased systems is that the land that is being used for grazing and making
conserved feed is capturing carbon, if being managed appropriately,” says Liz. When the plants are photosynthesising, they use carbon dioxide from the atmosphere and water to produce sugar (glucose C6H12O6) and pump out oxygen as a by-product.
She continues: “The sugar is used as a food source by the plant, and some of it is released by the roots. This mechanism is how most carbon is being captured into soils. This means that plants need to be healthy and growing well to be capturing carbon.
“Through the Hereford Cattle Society sustainability project, it has been identified members need to be encouraged to maximise grass and forage in the diets, as it is a key part of farming for the future. Importantly, it is what commercial buyers are doing and wanting to do more of, especially as input prices increase.”
Suckler cow efficiency is a measure of how many kilos of calf is weaned per kilo of cow weight.
Liz comments: “The industry target is 45 per cent, meaning a group of cows averaging 650kg has an average weaning weight (adjusted to 200 days of age) of
293kg. It is combination of mature size, fertility and calf growth rate. It is welldocumented that bigger cows produce more methane as they eat more, so we need to make sure they are performing well.”
Suckler cow efficiency is used as a group measure to compare the performance of different groups or families of cows on a farm. Maternal traits, available through Breedplan, should be used to identify underperforming cows to be removed from the herd.
“Identifying these females is as important as finding the stars within your herd. The sustainability project also identified that they need to support members to improve their suckler cow efficiency,” says Liz.
As feed intake is driven by bodyweight, more commercial farmers are becoming interested in lowering mature size as costs increase. If a producer is looking to extend the grazing period to reduce housing costs, lighter cows make it more possible.
More farmers are aiming to outwinter to make suckler cows more viable, says Liz. She says: “Hereford cattle are renowned for their ability to gain and hold onto condition, which makes them very suitable for these systems.
“More farmers are moving towards rotational grazing systems to boost per hectare performance, or using mob grazing systems to boost soil health, and will be looking for herds selecting bull and heifer genetics under similar production systems. There will be massive opportunities for breeders who engage with more sustainable production systems.”
Sustainable farming is a combination of environmental factors, economics and ethics.
Liz says: “It could be called organic, agroecology, pasture-fed, naturefriendly, regenerative or holistic, but the principle of the balance of these three areas are always present. Most of the approaches are not new, with some of them being rediscovered from previous generations of farmers.
“Within these movements, there is a recognition that some genetics work, and some don’t as different traits, such

as grazing behaviour, rumen capacity or maintaining body condition, are needed.




“Part of it is selecting animals for future breeding programmes from these systems, and more commercial farmers are seeing the benefit of buying their breeding stock from systems who match their aspirations.

“An important start is to recognise what you are already doing, it could be
environmental schemes, reducing feed and fertiliser use, reducing cultivations, or increasing clover levels. This is not necessary about radical change, it is making conscious decisions that will enhance your environmental, economical and ethical position. It is great to go and see farmers who are doing different things, as it can challenge your current thinking and help establish your plan.”

At the spring show and sale at Shrewsbury Auction Centre, bids reached 11,000gns for bull Rempstone 1 Virus N598, while a new record bull average was set as 27 bulls sold to average £4,404, clearing at 79 per cent.
A buoyant trade spread through Shrewsbury Auction Centre as Rempstone 1 Virus N598 from M Ludgate reached a top call of 11,000gns, paid for by Robert Allcock to join his Shrewsbury-based Burmill herd.
January 2021-born, this Solpoll 1 Nobility son also stood grand male champion in the pre-sale show, which saw silverware return to the fixture for the first time since the pandemic and was ably judged by Alistair Smith, Newark. Nobility, a Panmure 1 Henry son, has worked within the Rempstone herd as a stock bull, having also bred the 2021 Agri Expo supreme champion Rempstone 1 Curly N604. Out of Blakesley 1 Myrtle, a Dendor 1 Krypton daughter, it is from an easy calving line at Rempstone, with this dam’s first three calves having averaged 34kg at birth.
With official auctioneer Jonny Dymond in the box, next in the money at 8,500gns was Classic 1 Theodore from R Edwards and E Smith, Swindon, Wiltshire,

purchased by Pete Cobley, Stoney Stanton, Leicestershire. With Costhorpe breeding in both sides of its pedigree, it is by Kinglee 1 Nimrod and out of homebred dam Classic 1 Showgirl, which is by Frys Cross 1 Oberon. April 2020-born, this bull was also tapped out as reserve senior male in the pre-sale show.
The only horned bull in the sale, senior male champion Pulham Victory from PRJ and LR Vincent, Pulham Market, Norfolk sold for 6,500gns to W Shaw, Kirkbymoorside, North Yorkshire.
September 2020-born, it is by the Irish import Shiloh-Farm Elite which stood breed champion at Ireland’s Longford Show 2018. It is out of Pulham Blossom 16th, which is a Haven Hotspur daughter and bred from the famous Badlingham Blossom line. Not a stranger to the Shrewsbury ring, it also stood male champion at the Christmas Calf Show in December 2021.



Another Ludgate-bred bull, this time Rempstone 1 Vicenzo N600, changed hands at 6,000gns to RA Bradstock and partners, Tarrington, Herefordshire. Another Solpoll 1 Nobility son, it is out of Rempstone 1 Dowager V424, a Hawkesbury 1 Vespa daughter. This bull stood third in its class to two other Rempstone males and in all the three averaged an impressive £7,665.
Hoghton View 1 Jackpot from S and E Walker, Preston, Lancashire, realised 5,600gns, selling to EL Lewis and son, Dilwyn, Herefordshire who celebrated their 200th year of breeding Herefords last year. Homozygous polled and January 2020-born, it is by the 2021 National Poll Show senior male champion, Hoghton View 1 Jackaroo. Having made the trip south from Co Durham, W and R Kemp and sons achieved 5,500gns for Auckvale 1 Trafford 1991T, with a top bid made by Powys-based Steven O’Kane and Helen Morgan to take on the role as herd sire at Keadyview Herefords. By two home-bred parents, it is by Auckvale 1 Ramesses 1711R, a Laertes son. Its dam is Auckvale 1 Janet 1649P, a daughter of Dendor 1 Muttley which is the first stock bull the Kemps have bought in the last 20 years. At 5,000gns, Normanton 1 Van Gough from TD and WT Livesey sold to Anthony Whitfield, Derrington, Staffordshire. By Dendor 1 Rosco P. Coltrane, a son of the
Royal Welsh champion Bakgard 1 Keno 1178, its dam is by Days Calibre G74.
Rempstone 1 Venom N597 from M Ludgate sold for 4,900gns to GE and SE Jackson, Hilderlsley, Herefordshire. Selling for use on British Blue cows, Taymar 1 Valentino from S Taylor and D Marsh, Leyland, Lancashire sold at 4,800gns.
In the heifer section, a selective trade saw some impressive prices. Topping this section at 8,000gns was the day’s grand female champion, Normanton 1 Blue Leg 13th V555 from TD and WT Livesey, Normanton-le-Heath, Leicestershire. A Panmure 1 Pudding daughter, it is out of a Laertes sired dam. It was purchased by Anthony Whitfield.
Barwise 1 Anise MU 127T, a class winner from Mrs CS Fletcher, Appleby-inWestmorland, Cumbria sold for 6,400gns and joined Anthony Whitfield’s purchases of the day. Sold as having run with bull Barwise 1 Tortuga, a son of Square-D Tortuga 953T, it has been scanned in-calf. This dark heifer carries HF 4L
36N, Dendor 1 Goblin and Barwise 1 Wellington in its pedigree.
Having travelled across the Irish Sea, Solpoll 1 Pansy T17 from John and William McMordie, Ballygowan, Co Down found a new home at 6,000gns, selling to the Allwood herd of FJ Wood and sons, Moreleigh Totnes, Devon. Having placed second in its heifer class, it by Moeskaer Mentos and out of the Panmure 1 Henry sired Solpoll 1 Pansy M16, this heifer is full sister to Solpoll 1 Powerhouse which holds the Northern Irish public auction records.


At 4,800gns, Normanton 1 Fistulina 35th V569, again from TD and WT Livesey sold to N Hooper, Leigh Sinton, Worcestershire. This class winner is another by previous stock bull Panmure 1 Pudding and out of a Dorepoll 1 579 Knighthood daughter.
Two heifers sold for 4,000gns. The first was Pepperstock 1 Orchid V707 from Speirs Farms, Luton, Bedfordshire which was another purchase made by FJ Wood
and sons. Having run with Rockafella 1 Trevor, this heifer is the first to be offered by Pepperstock 1 Rebellious which was supreme champion at Bucks Show 2019.
At the same money was Spartan 1 Oyster’s Vienna from SC and GL Hartwright, Abingdon, Oxfordshire, selling to P Pimlott, Market Drayton, Shropshire. By the 8,000gns Solpoll 1 Perfection which the Hartwrights purchased at the 2019 spring show and sale, it is out of Cleland 1 Oyster Gem 50th.


There was a 100 per cent clearance in the for sale only female section, which was led by Alderoak 1 Lilac 7th from P and E Williams, Montford Bridge, Shropshire and Fellowhills 1 FR Julia from J Hodge, Horndean, Berwickshire, both selling for 1,500gns.
Averages: 30 show females, £2,973; 27 bulls, £4,404; 6 for sale only females, £1,330
Auctioneers: Halls
The year 2022 saw the 16th European Hereford Conference held by the French Hereford Association in central France.
The 16th European Hereford Conference descended on the Massif Central of France in October 2022 with the proceedings centred around Sommet de l’Élevage, a large agricultural show which attracts 93,000 visitors.

In a country famed for producing some of the world’s most popular livestock breeds, the show welcomes 70 different breeds of sheep, cattle and horses annually, with 22 cattle breeds present.
With 2,400 international visitors from 65 countries attending the show, many interesting and useful conversations were had in the international lounge, with interest shown for the breed from countries around the world.

The conference was opened on Tuesday 4 October by Pascal Bastien, the president of the French association. Following his welcome, Pascal took delegates on a tour of the show, finishing at the Hereford stand with a welcome drink and a selection of local cheeses and meats. French breeders then displayed their Hereford cattle in the ring. What was striking was the difference between the French breeds in their native country and the type of UK breeders are used to seeing on home soil, making it clear why many continental breeds in the UK have changed their names to British Blonde, British Blue, etc. At the same time, the Simmentals could be found in the dairy lines.
The difference in stockmanship was also noticeable. Cattle had not been obviously prepped for the show ring, and with no soap in sight, cattle entered in the National Charolais Show were very yellow compared to those seen on the UK show scene. Similarly, exhibitors did not carry show sticks and did not adjust their animals’ legs.
The Hereford judging took place the next day and was executed by familiar face, PJ Budler, having travelled from Texas. There were 18 animals forward across three classes of bulls, heifers and cows with calves at-foot. PJ found his male champion in six year old Romany 1 Popcorn BL P15 from Pascal Bastien. Bred by Scotland’s Robert Wilson, society president Carolyn Fletcher was present to witness the success of her breeding, being sired by Barwise 1 Lancer, the two times UK sire of the year.
That afternoon, country reports were given from across Europe as well as from the American Hereford Association with Stacy Sanders, head of records, present throughout the conference.

Thursday saw a visit to the farm of Olivier Avignon where some quality cattle were seen, with Charolais inside and the Hereford grazing outside.

That afternoon delegates returned to the conference room to listen to the keynote speakers where firstly Didier Deleau emphasised the benefits of grass-fed livestock, focusing on the Hereford breed.

Next to speak was Jean Denaux, a butcher in the north of Burgundy who was particularly interesting to Irish and UK delegates, being the first customer of Ireland’s Hereford Prime scheme.
Jean praised the group’s 5,000 Irish farmers for their carcase uniformity and marbling.
Next to speak was author Sylvie Brunel, via her daughter who acted as a translator, known for her book entitled
‘Why farmers will save the world’.
Sylvie said: “Ukraine has put food sovereignty back on the agenda and Covid showed a fear of food shortages while the alarm is also being sounded on climate change. It’s not easy being a farmer, having to feed the world and save the planet.
“Beef cattle are a key part of sustainable food production. It is forecast that there will be 10 billion people on the planet in 2050. People require 500g meat each week for a healthy diet, but half of the world’s population do not have access to this.”
Sylvie continued to state grassland would play a key role in sustainable meat production as grassland can hold 80 tonne carbon per hectare, the same capacity as woodland.
The final evening of the conference involved a train ride up volcano, Puy de Dome. Although delegates were expecting to see views of the vast landscape below, the train went above the clouds and instead, a spectacular sunset was enjoyed.
As per tradition, attending countries presented gifts to the French Association. Following this, world secretary general Larry Feeney addressed the delegation. Before the closing of the conference, Pascal Bastian handed over the European Conference baton to the Irish Hereford Breed Society, who will host the next conference in August 2026, centred around Tullamore Show.

As part of the European Hereford Conference, delegates visited the farm of Olivier Avignon who runs Charolais and Hereford cattle alongside each other, with two different markets for the breeds.

In 2019, beef producer Olivier Avignon kept a Charolais herd on his 220 hectare (544 acre) holding in the Auvergne area of France, which on approach looks remarkably like many stock areas of the UK, with its green hedgerows and rolling hills.
Having been on their family farm since 1912, the Avignons started with 40 Charolais cows. Nowadays the farm is home to 120 cows including 80 Charolais and 40 Hereford females.
In 2016, the opportunity arose to manage the next door farm of 80ha (198ac). At this point, Olivier did not wish to increase his Charolais herd, saying it
would complicate calving, so instead the family’s first Herefords were purchased. Olivier explains: “I was looking for a breed with good maternal qualities and meat. I noticed the breed at Sommet de l’Élevage and contacted Hereford France for more details. The Hereford is docile, easy calving and can finish off grass. I have no regrets in choosing Hereford.”
Olivier has now bred Herefords for the last four years and having started with crossbreds, he is now working towards a purer type.
For time management reasons, no AI is used but instead natural service is favoured. Two bulls are being used on the Herefords, which had been purchased from the Burgundy region of France and are sired by Fisher 1 Jaguar bred by Reg Hutchings, West Sussex.
Unlike the UK consumer, the French market demands an older animal at the point of slaughter, with the cow herd used as the primary source of meat.
In France, Limousins and Charolais are generally sent to be finished overseas and in Olivier’s case, his progeny head to Italy, leaving the farm at 420kg.
Unlike the Charolais, Olivier finishes the Herefords himself and castrates steers at eight to 10 days old. An abattoir buys the cattle at 18 months of age and they go on to kill out at 330kg to 360kg.
Olivier says: “There is no traditional market for the breed in France – you need to build your own market to add value. It is a niche market.”
Cull cows are also purchased to feed for €2,000 per head at 800 to 900kg., and Olivier says they are looking for a profit of €500 per head, which is difficult but not impossible following three to four months on-farm.
Weaning takes place at eight months. Young cattle are fed a diet of lucerne, haylage and wheat, consisting of 10kg lucerne and 5kg ground wheat. Olivier has also worked towards utilising 100 per cent home grown feed, as well as working with a nutritionist. He also makes use of a clover and grass silage. Hereford sires are used for the first calving on Charolais cows and the resulting progeny grow at 1 to 1.2kg per day though Olivier notes his Charolais eat 30 per cent more than the Herefords.
Hereford heifers calve at two year old while Charolais calve at three years. Charolais calve inside in November and December while the Hereford calve in two groups outside, in spring and autumn.

Beef price at the time of visiting was €5. 40/kg with Olivier receiving €3.20/ kg for cattle going to Italy on live weight for a market which demands bull beef. However the Herefords are generating €6/kg and he says when selling directly, the grade is not relevant.
Olivier tells a familiar tale of the EUROP grid.
He says: “Meat quality is not taken into account when using the EUROP grid. Instead, it is the sort of system which lends itself to making burgers.”
In France, the burger industry is
growing and now more than 50 per cent of the market is mince. Beef in the supermarkets is heifer or cow and could be anything from a once-calved heifer to an old cull cow.
“The quality of genetics in France needs improving, to produce animals with better growth,” notes Olivier.
“Cow beef is just part of French culture,” he explains. “Our traditional cooking methods are all based around old beef. The market has been organised in this way for years and it also means the buyers don’t need to pay lots for beef.”
The French beef mince trade is propped up by dairy-bred beef and is often sold significantly cheaper than that from the suckler herd.
The French customer opts for cow beef, with carcases averaging 520kg. The Herefords are 350 to 400kg carcase cows and are finished at 30 months.

Olivier says: “I haven’t sat down and
worked out which of my systems is more profitable but the inputs are so low, it is likely the Herefords are.”
Along with the farm and countryside, the challenges faced by farmers in France are all strangely familiar, with Olivier noting that succession, climate change and vegans were all threats to the French agricultural industry. Although they are not faced with animal health challenges quite like in the UK, French farmers are subject to animal welfare inspections which is, in part, the reason Olivier has opted for the poll strain. He adds: “We don’t breed cattle to treat them badly. Greening regulations and EU policy can also be a nuisance. We can’t plough permanent pasture so we need to keep turning leys over every five years to ensure they are not classified as permanent. The policies are not related to what we need to do in order to do a good job.”
The 2022 National Poll Show at Moretonin-Marsh concluded with yet another championship for Spartan 1 Typhoon from SC and GL Hartwright.
Following on from a successful summer show circuit, Spartan 1 Typhoon from SC and GL Hartwright, Abingdon, Oxfordshire was tapped out as supreme, grand male and senior male champion by judge Ian Shaw at the National Poll Show, once again staged at Moreton-inMarsh Show.

The Hartwrights’ triumph in the show ring have increased in recent times, having won a string of breed championships this summer with Typhoon the most successful animal to come from the Spartan stable to date. Born in February 2020, Typhoon is a son of Solpoll 1 Perfection, bred by Northern Irish breeders John and William McMordie and is a son of the renowned Panmure 1 Henry. Purchased at the 2019 society spring show and sale for 8,000gns, it is out of Panmure 1 Plum K19, a line which has consistently delivered for Scottish breeders JM Cant and partners.
Taking the reserve supreme, grand female and senior female titles was Rempstone 1 Anna Mary N506 from FJ Wood and sons having travelled up from Moreleigh, Devon. March 2018-born, it is by Solpoll 1 Nobility, another McMordie bred bull. Out of Dendor 1 Anna Mary 14th, a daughter of Hawkesbury 1 Prosper, the female line goes back to the wellknown Jennefer line at Dendor.

Reserve grand male and intermediate male champion was Kinglee 1 Verlou, bred and exhibited by Pete Cobley, Stoney Stanton, Leicestershire on its first show outing. By Cleland 1 Nelson which Pete purchased for 3,100gns at the 2018 autumn sale from breeders Nesbitt Farms, it is out of Kinglee 1 Nicole 462.
Coley 1 Duchess 609 from Heather Whittaker, Halifax, Yorkshire was selected as reserve grand female and overall junior champion and was shown at the foot of its mother Gouldingpoll 1 Duchess 916 as it took the reserve supreme title at this summer’s Royal Highland Show. By Danish-bred sire Solbakkens Patrik, it then went on to win its junior heifer class at the Great Yorkshire.
The junior male championship was selected as Studdolph 1 Goldfinger from TG, EI and EN Thorne, Milford Haven, Pembrokeshire. By stock bull Vexour 1 Palmer which is having a big impact across the poll herds of the Thornes, it is out of Studdolph 1 Precious 501, which was bred from the Greta line at Dendor.
Ian Shaw found his reserve junior male champion in the form of Moralee 1 Wynne SO270. Born in February 2022, it is by Auckvale 1 Standout 1891S and out of Moralee 1 Pippa KS S11 which has had its own share of show success over time.

Another from the Hartwrights was Spartan 1 Voyager SP V138, which was chosen as reserve intermediate male champion. Born in March 2021, it is



another by Solpoll 1 Perfection which has done so well for the breeders, it is out of Panmure 1 Plum K19, a daughter of Hawkesbury 1 Volcano.
The reserve senior male championship went to Buckenhill 1 Trans Am from Matthew Gray and Louise Crowther, Bromyard, Herefordshire. Having had an active summer of showing, this senior bull was also reserve champion at the Royal Bath and West, senior male champion at the Royal Three Counties and male champion at the Royal Welsh. Having stood supreme champion at Agri Expo in 2021, Rempstone 1 Curly N604 from M Ludgate, Thame, Oxfordshire took the intermediate female championship. It also won its
class at the 2021 Christmas Calf Show at Shrewsbury. Another by Solpoll 1 Nobility, the Curly line at Rempstone goes back to Badlingham breeding.
Success continued for Matthew and Louise who saw success in the intermediate female championship, taking the reserve title with Buckenhill 1 Brownie V329 which stood reserve female champion at the Royal Bath and West earlier this year. Born in November 2020, it is out of Bosa 1 Brownie 1034 and by Buckenhil 1 Samsonite, a Greenyards 1 Nostradamus son.
The reserve senior female championship was another won by FJ Wood and sons, this time with Pepperstock 1 Leslie V706 which stood third in its class at the show the previous year and second in its class at the 2021 Midlands and East Anglia Hereford Breeders Association herds





competition while still under ownership of Jim Speirs.





One year old heifer Porton House 1 Amethyst 2nd from Paul and Vicky Moyle, Newport, Gwent went home with the reserve junior female championship. By Panmure 1 Nugget, a full brother to Panmure 1 Henry and the 2019 reserve grand male champion at the 2019 Royal Welsh Show, it is out of Ashley Moor 1 Amethyst 33rd.
Both group of three classes were led by a trio from SC and GL Hartwright, with the progeny group all sired by Solpoll 1 Nobility. Meanwhile, the pairs class saw M Ludgate move to the fore.

For the second consecutive year Luke Murphy of Spartan Herefords received the Ted Hewitson Trophy for the stockman in charge of the most successful herd and follows an extremely successful year for both Luke and the herd.
Friday night’s young handlers competition was judged by Richard Edwards who presented the Dendor show stick to Grace Denning who after

winning the 13-17 year old class, won the championship. The junior class was led by Tia Moyle of Porton House Herefords and the senior class by Isla Soutter.


The complete young handler competition held alongside the main show on Saturday was judged by
Andrew Owen and Sharon MorganJones. The junior class was won by Mia Shaw and follows her recent success at the National Hereford Show, while the intermediate class was led by Robbie Dickin and the senior class saw Isla Soutter once again be successful.


Meurig James, head classifier at National Bovine Data Centre (NBDC).
According to Meurig, type classification plays an important role in ensuring cows have the right balance between strength and femininity along with good legs, feet and functional udders.

Meurig describes it as giving an actual picture of the cow, being a fresh pair of eyes on your cows and completely independent.
Classification is a useful management aid for all pedigree beef producers, says
He explains: “Classification identifies which traits need improving on cows, therefore giving the farmer the opportunity to use certain bulls to rectify these faults. Classification is not aimed at the elite pedigree breeder but is a useful management tool for farmers and breeders across all 20 breeds which NBDC scores.”
Classification of dairy animals started about 50 years ago in order to identify strengths and weaknesses in these animals both nationally and globally. The system allows faults to be seen in the herd, aiding bull choice to rectify these problems.
Beef Shorthorns were the first beef breed to adopt linear classification via the NBDC and have been doing so for nearly a decade. This adoption came as a result of the beef strain seeing the advantages
Type classification can be an effective tool for all pedigree beef breeders. As Hereford Cattle Society moves to adopt the system, Meurig James explains the benefits of classifying a herd.Meurig James
of classifying the Dairy Shorthorn when the two operated as one society. As a result of the Beef Shorthorn’s success, another 10 beef breeds have since taken on type classification.
At the request of the breeder, a NBDC classifier will visit a farm to assess the cattle on different linear traits, entering the relevant scores into a handheld computer. A team of 14 classifiers visits herds all over the UK every seven to eight months. The information will then be fed back to the relevant breed society, where it can also feed into performance recording data, and to the respective breeder.
When classifying for the first time, Meurig advises the breeder scores the whole herd, for the best breeding decisions to be made.

Meurig says there will be a slight difference between a show cow and a herd cow, but there is less difference now than in past decades.
He says: “A heifers and second calvers can be scored a maximum of VG89 to allow it time to get better with age.
Heifers scoring high on legs, feet and mammary system will last longer in the herd and be more profitable.


Cows have to calve three times before they can be scored excellent as they need to prove they can last.
He says: “Too many people are of the opinion excellent cows are ‘show cows’. This is certainly not the case because show cows need style and ring presence and have a tendency of having superior management throughout the year, however a cow can be scored excellent because she is balanced, feeds her calf very well and is a trouble-free cow.”
Linear traits include chest width, body width, angularity, width of rump and, in beef cattle, length to withers.
Meurig says: “In 2022, 140,000 dairy and beef animals were classified. We had a record year in 2015 in terms of numbers classified and scored 149,500 cattle.
“Money spent on registration and classification is well spent as they will often be worth more, even when there is


a slump in cattle prices.”

There are several beef breeds which now classify stock bulls using the same scoring system as that used for cows. Linear scores readily used as a marketing tool for selling pedigree cattle and generations of a pedigree’s scores can be listed to show the value of an animal. Knowing an animal’s score, or indeed the score of a close relative, can save wasted trips if a breeder is looking to buy stock from around the country.
Meurig adds: “As your society moves forward and looks to adopt genomics, I believe type classification will work well as it records the actual phenotype of the animal while genomics predicts its potential.

“We are very much looking forward to working with the Hereford Cattle Society as the breed continues to improve inline with its popularity.”

If you would like to start classifying your herd, contact the society for more information.


A lso G e n ot yp in g fo r : M yos t atin • Poll e d • T H • T h re e Tra it s • A1 & A 2 B et a C a se in B L A D • B re e d A s sig n m e nt A n d m a ny m o re - p l e a se co nt a c t th e la b o rato r y fo r a f ull lis t .
Fo r f u r th e r d etails co nta c t o u r la b o rato r y at : We ath e r bys S ci e nti fi c , U n it F 1 , M7 B u si n e s s P a r k , N ewh a ll , N a a s , C o . K il d a re , I re l a n d . W9 1



X8


Telep hone: +353 (0) 45 875521 | m ail @weat herbysscienti fi c .com | w w w.weat herbysscienti fi c .com

In-vitro embryo production can be utilised in breeding programmes to safeguard bloodlines while allowing the overall merit of the herd to advance more quickly and permit the introduction of completely new genetics on both the dam and sire side through the trade of embryos.
Cattle breeders seeking to improve their herd’s genetic potential are introducing in-vitro embryo production (IVP), says AB Europe’s vet Gavin Tate.

Globally, IVP is a widely used method for producing embryos where it outcompetes MOET (multiple ovulation embryo transfer) for its flexibility and multiple benefits to breeders and their donor animals.
AB Europe currently offers two distinct IVP donor programmes, non-stimulated and stimulated for take up, depending on the individual animal requirement and/or farmers preference.
IVP features some of the most technically advanced procedures to produce embryos from collected oocytes which are fertilised within a petri dish by selected semen and subsequently cultured for seven days until the fully developed embryos can be transferred or frozen. Gavin Tait provides answers to some of the most Frequently asked questions.
Do cattle have to be taken to a special collection centre for IVP?
No, AB Europe can collect the oocytes
(unfertilised eggs) both on farm and at our own livery collection centre based in the Scottish Borders. To make the process more cost effective we would recommend those with smaller numbers (one to two donors) to take advantage of the livery facilities. For larger numbers, we can collect on farm, so long as there is an adequate set up.
Our programme involves six hormone injections prior to collection which boost oocyte quality and often oocyte numbers. Stimulated collections can be carried out on a fortnightly basis. We find that a mild stimulation programme tends to produce better results that non-stimulated collections.
On average, if they are well grown and cycling, we can start collecting from beef
heifers at around 10 to 11 months of age and dairy heifers around eight months. There will be variation between breeds and individual animals.
Can you collect from pregnant donors?
Yes. We can collect from in-calf donors up to around 12 weeks gestation. After this point it becomes very donor dependant as to whether her ovaries can still be accessed by the vet.
How many donors can you use a straw of semen over?
One straw of semen can be used over an average of four to five donors depending on semen quality, concentration, and oocyte numbers.
Can you use fresh semen?
Yes. This requires careful planning prior to collection. Bulls must be licenced, and the semen must arrive at the AB IVP laboratory in Edinburgh on the same day as the donor collection.
Can IVP embryos be transferred fresh?
Yes. In our IVP lab, 50 per cent of the embryos produced are transferred fresh. Embryos are produced eight days after the initial oocyte collection, consequently careful planning and early booking is vital to ensure availability.
What is vitrification?
Vitrification is a process whereby the embryos are first dehydrated to remove all liquid within the embryo and then rapidly frozen on specially designed hooks. This prevents ice crystals forming within the embryo which could be detrimental to the embryo when thawed. It is also the preferred method of freezing used in human IVF.
Does vitrification result in better hold rates compared to conventional freezing methods?
Grade 1 embryos tend to hold equally as well with either method. However, we find there is a marked improved hold rate when grade 2 embryos are vitrified.
How long can embryos be stored for?
Indefinitely, as long as they are stored in liquid nitrogen.
What do your embryo grades mean?
Our grades consist of two parts – the embryo’s developmental stage and the embryo’s overall appearance.
Grade 1 Picture perfect embryo. Inner cell mass (ICM) is neat and tidy with even cell size, shape and colour. No evidence of fragmentation
Grade 2 ICM cellular distribution less compact with minor fragmentation
Grade 3 No clear cellular boundaries with >50% fragmentation. Not viable for freezing or transferring

The gavel went down at 7,000gns after a fast-paced exchange of bids for 21 month old Fisher 1 Valentino at the Hereford Cattle Society’s autumn show and sale at Shrewsbury Auction Centre, which saw bulls average £3,720.


Purchased by DJ and JM Blaxell, Antingham, Norfolk, it is a son of Fisher 1 Prospect P464 which was breed champion at the 2019 Royal Three Counties Show, and out of Fisher 1 Eva N433, a female line which does so well for breeder Reg Hutchings, Chichester, W Sussex.
Next in the money was March 2021born Harveybros 1 Va-Va-Voom which made the trip south from Glasgow with breeders George and Sophie Harvey and sold to a call of 5,500gns from DN and LF Williams, Llanidloes, Powys. Reserve senior male in the pre-sale show, as judged by New Zealand breeder Gray Pannett, it was named reserve bull of the year at the society’s annual awards dinner the night before. It is by the memorable Normanton 1 Laertes and out of Harveybros 1 Crocus E2.
The day’s reserve grand male champion Hollybush 1 Viscount from G and R Watkins, Little Hereford, Shropshire went through the ring at 5,000gns, and joins the Barbern herd of Bernard and Barbara Rimmer, Scorton, Lancashire. Noted as being a ‘deep, very good bull’ during the judging, it is a son of Romany 1 Redemption BL R21 and out of a home-bred daughter of Australian sire Wirruna Daffy D1.
Rempstone 1 Vegan N621 from M Ludgate, Thame changed hands at 4,800gns going to Peter Eccles of Rockness Herefords, Tranent, East Lothian. Reserve native interbreed champion at Herts County Show this summer it is by the Ludgates’ herd sire Solpoll 1 Nobility and out of a home-bred female, by Solpoll 1 Hollywood.
At 3,600gns was Glenvale 1 Fanfare from Pembrokeshire breeders TG, EI and EN Thorne which made its way across the Irish Sea to join Matthew and Rita Goulding’s Co Kerry-based Gouldingpoll herd at 3,600gns. By stock bull Vexour 1 Palmer, it is out of the Polly line, one of the breeders’ best cow families.


A robust average just shy of £3,000 was seen in the show heifer section and continues the buoyant female trade the breed has enjoyed in recent times, although buyers’ selectiveness throughout reflected the winter of high costs and forage shortages ahead.

Leading the female trade was Normanton 1 Chanterelle 17th V779 from TD and WT Livesey, Ashby-de-laZouch, Leicestershire selling at 4,600gns to Anthony Whitfield, Derrington, Staffordshire. A class winner at this summer’s National Poll Show, it also stood at the head of its class in the presale show. It is a daughter of Dendor 1 Rosco P. Coltrane, which stood reserve male champion at Shropshire County Show in 2019.
At 4,300gns was Kinglee 1 Oyster Girl 665 from P Cobley, Stoney Stanton, Leicestershire, secured by MJ Sharlot, Weston under Wetherley, Warwickshire. Having produced many successful cattle in recent times, this heifer is by Cleland 1 Nelson and out of a home-bred female.
From Paul and Vicky Moyle, Newport, Gwent, Porton House 1 Jane 2nd, the winner of the junior heifer class at the Royal Welsh this year, sold at 4,000gns to C Codd and R Lewis Trefgarne,

Haverfordwest, remaining in southern Wales. It is by Dendor 1 Sherlock and out of a Panmure 1 Nugget daughter.
Another at 4,000gns was Panmure 1 Plum V5 from JM Cant and partners, Arbirlot, Tayside, purchased by the same buyer. By Fisher 1 Rancher R483, it is out of a Romany 1 Distiller A84 D53 daughter, with the Plum line consistently performing for these Scottish breeders.
At the same money was Auckvale 1 Pansy 2041V from W and R Kemp and sons, Bishops Auckland, Co Durham, and headed home with WD and SB Roberts, Capel Coch, Anglesey. It is by Auckvale 1 Resolution which was imported as an embryo and has been running with Dendor 1 Muttley.
Hoghton View 1 Emmal 1st from S and E Walker, Preston, Lancashire made 3,200gns on their first time consigning a female to public auction and was also purchased by WD and SB Roberts, Capel Coch, Anglesey. By Danish sire Moeskaer Magnetic 1579, it is out of Whitehill 1 Emmal.
Another heifer from W and R Kemp and sons, this time Auckvale 1 Liveley 2043V, realised 3,000gns, selling to Daniel Fowler, Scorton, Lancashire.

The section leader within the for sale only female section was Holmefold 1 Domino from Maddy Scott, Belthorn, Lancashire selling at 2,400gns to Anthony Whitfield.


Averages: 19 show heifers, £2,923; 14 bulls, £3,720; 3 for sale only females, £1,890.
Auctioneers: Halls

Several significant enhancements have been scheduled for implementation in the January 2023 Breedplan evaluation provided to the Hereford Cattle Society, including new genetic parameters, single-step Breedplan evaluations and more robust accuracies.
One of the highest priorities in providing the commercial Breedplan genetic evaluation service to the Hereford Cattle Society (HCS) is to ensure the model makes best use of the quantity and quality of performance records collected by Hereford breeders, explains Dr Brad Crook, genetics research and development manager.

As both populations and performance recording practices change over time it is necessary to regularly update the genetic parameters used in the calculation of estimated breeding values (EBVs), he says. This is especially important for traits which are either less common in their levels of recording, because of cost for example, or newlyintroduced traits which are still gaining uptake among beef cattle breeders. Brad says: “Whether we a talking about beef evaluations (such as Breedplan) or evaluations provided for other livestock species, a consistent feature of all genetic evaluations is the routine updating of genetic parameters which
best describe the current recorded population and using these in the calculation of EBVs.”
In the case of the Breedplan evaluation for HCS, the number of records available has increased considerably since the first Breedplan evaluation was introduced. The re-estimation of genetic parameters was completed in 2022, with the changes in the heritability to be used for a range of traits shown in figure 1. Test evaluations were completed to understand the impact of the new parameters on Breedplan EBVs and accuracy reported for HCS.
“The implementation of updated genetic parameters is scheduled for January 2023, and the Breedplan evaluation for HCS will ensure these new parameters reflect the on-going investment in data collection by its members,” comments Brad.
There are approximately 13,500 Hereford animals recorded on the HCS database with a genotype, with each representing at least 50,000 single nucleotide polymorphisms (SNPs).
“While SNP data can provide valuable information about pedigree accuracy and the presence of genetic defects, there is so much more that can be achieved with the density of genotypes being collected by Hereford breeders. For instance, having a considerable population of Hereford animals with high density genotypes and performance information can provide opportunity to deepen our knowledge of the biology underlying the traits expressed in the Hereford breed.

“A very practical application of genomic information is to make use of it in the genetic evaluation, along with pedigree and performance records. In other words, using SNP data as an additional source of information in the calculation of EBVs and accuracy. This will take place in the January 2023 Breedplan evaluation for HCS,” says Brad.
When genomic data is included in a Breedplan evaluation, it is referred to as a single-step Breedplan evaluation because the model makes use of pedigree, performance, and genomic data in one step to calculate EBVs.
The availability of genomic data provides two types of additional information useful in EBV calculations, explains Brad. The first concerns true genetic relationships among the genotyped population.
He says: “In the absence of genomics, we assume the animal will receive 50 per cent of its genetic material from each parent and this equates to 25 per cent of its genetic material from each grandparent.
“While the former part remains true with genomic data, the latter is not necessarily so. In the case of the sire, he might contribute more genetic material from one or the other of his parents to his progeny, depending on how the genes from his parents get mixed and swapped when semen cells are being formed.”
Brad explains: “Likewise for the dam, she might pass an egg that has more genetic material from one or the other of her parents. When an animal is genotyped, we can determine more accurately the relationship between the individual and its grandparents. In other words, genomics allows us to identify which side of the sire’s family and the dam’s family is present in which proportions. This has the potential to impact both EBVs and accuracy.
“The second concerns the relationship between certain areas of certain chromosomes and the traits recorded among the genotyped population. What we have started seeing in breeds
where genomics is being used, is that some animals show larger changes in their EBVs than we might expect as a direct result of having their genotype included. These animals seem to have a specific combination of SNPs of certain patterns at certain points on certain chromosomes which somehow relate to greater or lesser genetic potential for a trait than might be assumed.
“We can therefore see certain traits being impacted more than expected when genomics are included. By way of their genotype, they pick up far more information from the genotyped population as to how genomics relates to genetic potential for growth.”
There are advantages that come with genomics and the single-step Breedplan model, explains Brad.
For breeders with small herds, accuracy levels are often limited by small contemporary group sizes even when pedigree and performance records are available. If calves are genotyped, however, they can accumulate additional information and accuracy via their relationship to the wider genotyped and performance recorded population.
Furthermore, when young animals are genotyped at an early stage in life, they can achieve higher levels of EBV accuracy earlier in life, especially for traits expressed later in life, than is possible with a conventional Breedplan model.
“Genotyping young animals equates to greater accuracy of selection decisions, at an earlier stage in the growth of animals,” says Brad.
“It is also worth noting that the benefit of improved accuracy arising from genomics is most evident for animals with EBVs of low accuracy prior to genotyping. The gains in accuracy for carcase EMA, for example, are evident at the lower pre-genotyping end of the accuracy range.

“In other words, high accuracy animals are unlikely to show much change in accuracy once genotyped, even if changes in their EBVs are observed.”
The continual growth in volume and density of genomic information used in Breedplan evaluations has highlighted the need for a more efficient way to better account for SNP effects in the calculation of EBV accuracy. An advanced algorithm for accuracy calculations has now been developed and implemented for all clients using the single-step Breedplan model.
Brad adds: “This represents a worldfirst approach to modelling SNP effects in accuracy calculations and will be implemented with the single-step Breedplan evaluation provided to the Hereford Cattle Society in January 2023.
“While it may result in small reductions in the accuracy reported for certain traits and for certain individual animals, the bottom line is that the EBV accuracy will be calculated more
Spartan 1 Typhoon from SC and GL Hartwright, Abingdon, Oxfordshire graced the ring at the annual Designer Genes sale to realise a new UK breed record for a poll Hereford bull of 16,000gns. Having recently been named champion of Europe, as well as UK bull of the year, this well admired bull sold to Speirs Farms to join their Pepperstock herd.
The sale cleared at 91 per cent and over 10 females and 1 bull, averaged £6,846, setting a new UK and European sale average.
Born in February 2020, Typhoon is a son of UK sire of the year Solpoll 1 Perfection, and out of Panmure 1 Plum K19. The bull was well shown this year having won supreme at the National Poll Show, Great Yorkshire, Royal Norfolk, Royal Highland and Shropshire County.

Female trade topped at 8,000gns for Pulham 1 Starlet 11th from PRJ and LR Vincent, Pulham Market Norfolk and sold to Emma Hodge, Berwickshire with Pulham Herefords retaining embryo interest. Sired by renowned breeding bull Appel 1 KaBoom and out of a Romany 1 Machine daughter.
A single entry from seasoned consignors
W and R Kemp and sons, St Helens, Durham came in the form of cow and calf outfit Auckvale 1 Beauty 1767R and heifer
calf Auckvale 1 Beauty 2233A. Beauty 1767R was sired by Dendor 1 Muttley which has bred females to 7,300gns and they sold as a pair to Anthony Whitfield, Shropshire for 7,500gns.
First time consignors Steven and Lizzie Walker Hoghton, Lancashire reached 7,000gns for Hoghton View 1 Emma Jane 1st. Its dam, the Irish-bred Intelagri 1 Emma Jane was purchased in the 2019 Goulding Opportunity sale. A February 2021-born in-calf heifer by semen sire Hoghton View 1 Jackaroo, it sold incalf to outcross sire Hoghton View 1 Endure and joined Anthony Whitfield’s purchases of the day at 7,000gns.
Next in the money was Rempstone 1 Anna Mary D594 from M Ludgate,
Thame, Oxfordshire being September 2020-born in-calf heifer. Sired by Gouldingpoll 1 Double Decker, it is out the 2022 National Poll Show grand female champion and sold for 6,000gns to E Williams, Denbighshire.
M Ludgate sold a further two heifers which were the two youngest females in the sale. January 2022-born heifer, Rempstone 1 Myrtle N639, a daughter of renowned bull Dendor 1 Nairobi, sold for 5,000gns to C Codd and R Lewis, Pembrokeshire. Rempstone 1 Bubbles D647, a March 2022-born heifer calf sired by Gouldingpoll 1 Double Decker reached 3,200gns and sold to M Voss, Somerset. The only horned female entry of the day came in the form of Pulham 1 Tiara 7th from
A new record for a poll bull was set at Designer Genes 2022 as Spartan 1 Typhoon went through the ring.Spartan 1 Typhoon sold for 16,000gns
PRJ and LR Vincent sold for 4,800gns to B McCreath, Staffordshire. Sired by Shiloh-Farm Elite, it is a paternal sister to the 20,000gns record priced female and was reserve junior female champion at the National Hereford Show 2022.

Dendor 1 Jano 22nd from DE, ED and AL Jones, Caersws, Powys and at 4,200gns, was another to travel to Somerset with M Voss. The last daughter of Dendor 1 Nairobi to ever sell from the Dendor herd, this heifer stemmed from one of the most popular female lines at Dendor and also carries both the SMH Euro and Bakgard Keno bulls in its lineage.
A single entry from NJ Griffiths, Bickford, Staffordshire came in the form of Grifford 1 Star at a call of 3,500gns from R Williamson, Cheshire. The October 2021-born heifer is a daughter of Fabb 1 Northern Star and out of Coley 1 Clara 315.
Averages: 1 bull, £16,800; nine heifers, £5,740

Auctioneers: Halls
Sales management: Dowbiggin Marketing
Stirling
Sunday 5 – Monday 6 February
Dungannon Farmers Mart
Tuesday 14 February
Shrewsbury Auction Centre
Saturday 15 April
Dungannon Farmers Mart
Tuesday 18 April
Borderway Mart
Saturday 20 May
Shrewsbury Auction Centre
Saturday 30 September
Stirling
Sunday 16 – Tuesday 18 October

The National Hereford Club has returned to a normal programme of events following the disruption caused by the pandemic and once again members descended on Tenbury Show for the National Hereford Show.
Despite 2022 being an interesting year for farming generally, it was pleasing to see our club competitions and events
back in the calendar, and it has been good to meet up with members at the shows and events once again. As mentioned below, the annual general meeting, lunch and herd visit at the Whitlow’s HighHouse herd was no exception, with over 40 attendees enjoying an excellent and memorable day.
As with many shows across the country this year it has been a difficult season, with entries down following the pandemic. A slightly smaller, but very strong line up, with quality throughout and a busy ringside, meant that the resumption of classes at Tenbury Show proved to be a successful day, under the very proficient eye of our judge, Robert Wilson, from Romany Herefords. Both the overall champions, and indeed all of the section champions, showcased the
horned side of the breed very well, with animals of all ages showing what horned genetics can produce for the breed, as well as for the wider cattle industry.
Whether it be for crossing with other breeds, or back on to poll lines needing to restore breed attributes, the use of horned genetics for their consistency of breeding, maternal traits, longevity, correctness and bone structure must be considered. As horned breeders, we will continue to promote our offering of often overlooked quality outcross genetics.
The National Hereford Club was delighted to be able to hold its AGM and herd visit in person once again on Saturday 4 June 2022. It was a welcome
occasion following two years of online meetings. Members were treated to a day of exceptional hospitality courtesy of the Whitlow family, Abbots Morton, Worcestershire, who put in months of hard work to provide the club with a truly superb venue, meal and tour of their HighHouse herd of pedigree Hereford cattle.
At the AGM, the elections of officers of the club took place, with the reelections of Nick Hewer as president Tony Bradstock as chairman, David Makin as vice-chairman, Sarah Cook as secretary, and Sarah Cowle as treasurer and entries secretary. After many years in the role, Michael Church retired as show organiser following the 2022 National Hereford Show, and members were keen to show their appreciation for the hard work and dedication he had given to making the event such a success. For the 2023 show, these duties will be allocated to other members accordingly with guidance from Michael, while Edward Lewis, Richard Mann and David Makin would also continue to provide their help with the organisation and running of the National Hereford Show.


Following the meeting, members enjoyed a two-course lunch with roast beef provided by Risbury Court Farm, before moving on to view the HighHouse herd of John and Helen Whitlow and family. The cattle looked tremendous at grass with some impressive and consistent youngstock coming through and were a true testament to the keen eye and dedication to the breeding programme that the family have worked on since establishing their herd just over a decade ago. The farm walk was also peppered with some spectacular aerial visits from the nearby air show. Afternoon tea was served while members joined in with a ‘guess the weight of the bull’ competition, raising over £200 for the British Heart Foundation. Edward Righton won the competition, winning a HighHouse Christmas turkey which he sold and added the money to the pot.
On behalf of the membership, the club would like to sincerely thank the Whitlow family and all who helped bring together such a wonderful day, as well as the many members who attended.

Normality resumed as the National Hereford Show returned after a Covid-induced hiatus to Tenbury Countryside Show.


Sorting the line-ups was Romany Herefords’ Robert Wilson who had travelled south from Kelso and found his supreme champion in the form of Haven Silvester from Gwyndaf and Helen Davies of the Creuddyn herd, based in Templebar, Ceredigion. On what was the exhibitors’ Tenbury debut, the bull stood grand male and senior male champion with Steven O’Kane on the halter.
Bred by EL Lewis and son and purchased as a two year old, this April 2019-born bull is by a succession of National Hereford Show victors, being a son of Haven Lamborghini which stood senior male champion in the same ring three years ago which itself is by Haven Cavalier, another Tenbury champion. Its dam, Haven Thrush 64th, is also responsible for producing Haven Thrush 74th, the recent price record breaker which sold at 20,000gns.
Robert described this bull as having ‘great scale and width’ while still moving well for an animal with ‘so much muscle and length’.
The reserve supreme champion title went to Pulham Pansy 26th from James and Ellen Lake, Froxfield, Hampshire, another first-time exhibitor at this show, having already gained the grand female and intermediate female titles. Hereford Cattle Society members since 2019, Pansy was purchased from Philip and Laura Vincent from their Norfolk-based
herd as a calf at-foot to its mother Clipston Pansy T3. Born in September 2020 and by Pulham Powerhouse it is due to calve for the first time in January to Pulham Va Va Voom, the Lakes’ stock bull.
Pansy is a ‘great upstanding heifer’, commented Robert, ‘with femininity and power and a lot of potential for the future’.
HighHedges Diadem 9-21 from Sarah Cowle, Quainton, Buckinghamshire secured the junior female championship before standing reserve grand female champion. By HighHedges Synergist, the 2019 National Hereford Show reserve supreme champion, it is out of a homebred female, sired by Border Burlington J35.



Reserve grand male, intermediate male and exhibitor-bred champion was Free Town Versatile from RA Bradstock and partners, Tarrington, Herefordshire. Reserve grand male at the Royal Three Counties this year to its male champion stable mate, this November 2020-born bull is out of Free Town Penchant and is a son of Moyclare Quinlan, bred by Ireland’s Michael Molloy and jointly owned with Anthony Spooner.
James Lewis and family, Dilwyn, Herefordshire returned to exhibiting at Tenbury with Boycefield Wrangler, a 10 month old bull calf by Haven Stanely, and out of Boycefield Pinky 28th.
Following Wrangler through from its class and into the reserve junior male champion position was Pulham

Wedding Crasher from Philip and Laura Vincent, Pulham Market, Norfolk which is by Pulham Ranger, the 2017 National Hereford Show junior male champion since exported to Ireland to join the herds of JJ Farrell and Podraig McGrath. Another from the Pansy line, it is out of Pulham Pansy 15th, the 2020 National Hereford Club virtual show champion.




Also coming across from West Wales to Tenbury for the first time was Paul and Will Griffiths, Ferryside, Carmarthenshire who had previously not shown beyond the Welsh Winter Fair. Their April 2020born Penrhiwgoch BM Progress 483T stood second to Haven Silvester in its class and reserve in the senior male championship. By Border Mortlake M8 which sired the 2019 champion and 2020 reserve champion steers at the Welsh Winter Fair, it is out of Penrhiwgoch Binks Dowager 130.
Reserve to the intermediate champion was Haven Voltage from EL Lewis and son. September 2020-born, it is by Mawarra Aftershock which together with Messrs Spooner, the breeders own the EU semen rights. It is out of Haven Dowager 183rd, a daughter of Haven Kingpin, a bull enrolled to the Irish Hereford Breed Society’s breed improvement scheme.
Free Town Gift from RA Bradstock and partners was selected as intermediate female champion. Its dam, Free Town Gigi, a daughter of Mara Humorous, was placed second in the 2021 virtual show and is another by Moyclare Quinlan.
Five year old Oldwest Carol Singer R1 from Karen Froud, Ely, Cambridgeshire was tapped out by Robert as senior female champion. By Oldwest Nightwork, a SNS Generator 28X grandson, it is
out of Oldwest Carol Singer 1st, a daughter of Haven Wizard. A previous intermediate female champion at Tenbury, this female goes back to the Hermitage Carol Singer line.
Taking the reserve spot in the senior female championship was Rockland Tiara T7 from Clive and Paula Bidmead, Rockland St Peter, Norfolk. By Dieulacresse Kingdom, it is out of Clipston Tiara L19, both of which have many championships to their names.
Pulham Tiara 7th from Philip and Laura Vincent took the reserve female champion title. September 2021-born, it is by Shiloh-Farm Elite, which also sired the 20,000gns heifer record holder Haven Thrush 74th. The Vincents purchased the Irish-bred bull after judging it champion at County Longford Show.
Elsewhere in the classes, the March 2021 to August 2021 class was led by HighHouse Voltage from JR Whitlow, Abotts Morton, Worcestershire. By Drumatee Rocket, the 2021 virtual show male champion, it is out of Nanscient Gaylass 74th, a daughter of Hustyn Superior, both from the home of the Hawke family, Burlawn, Cornwall.




The youngest bull class was won by
Beckhall Welton from Beth Vincent, Pulham Market, Norfolk. Out of Pulham Tiara 3rd, it is another by Shiloh-Farm Elite, which Philip and Laura Vincent purchased after placing it champion at County Longford Show, Ireland.
In the group of three class, RA Bradstock and partners came out on top, while PRJ and LR Vincent won the pairs.
The young handlers competition was hotly contested for with good entries in all age groups. Nine year old Mia Shaw of Thornysure Herefords, Ilmington, Warwickshire took the overall champion title and can frequently be seen in these classes. Ollie Garnett-Smith of Classic Herefords near Swindon took the intermediate class while Pulham stock lady Hannah Murrell won the senior class.
BOSA
G Blandford & Son – 01531640209 / 07817707745

FREE TOWN
R A Bradstock & Partners – 01432890238 / 07734200508
PARKAPELLA
S Coates & I Coates – 07525426190
ASHLEY MOOR
EC & MM Everall 01568780266
HONEYBROOK
APG Goodwin – 01568720331
ROUGHMOOR TJ & BM Goodwin (C Powell) – 01544327434 / 07867800788
BOSBURY
S Hawkins – 01531640405 / 07813796053
ELDERSFIELD
L Hobson – 01452840169
ROSEMOOR
GCE Holborow – 01886821226 / 07966130853
BOYCEFIELD
JW Lewis – 01544318946 / 07767863377
HAVEN
EL Lewis & Son – 01544318255 / 079747446
ADZOR
DJ Makin – 01432830241 / 07961033283
BLACKHALL
J Pudge – 01432830361 / 07985078581
BORDER
SW Quan & CO – 01981570231 / 07714291362
BROMLEY
M & M Roberts – 01981540717 / 07980834266
Pigeon House
MR Barnett & Son - 07875525563
HOLME LACY DC Seabourne – 01432870808 / 07967208818
RISBURY RG & MD Thomas – 01568760443
HOLLYBUSH
G & R Watkin – 01584711323
PARLIAMENT
WD Wiggin – 02072198175
BUCKENHILL
MF Gray & Miss L Crowther - 01885483459 / 07909793455
LONGMOOR
S Greve-Jones - 07768714569
THAMES
A & S Timbrell - 01285 770112
Mob:07889044070
KINGSLAND
Vaughans Farms Ltd – 07977586140

DOCKLOW/HYDE
J Walker 01886 821892 / 07974307566
HIGH HOUSE
JR Whitlow –– 01386793880
ELDERSFIELD Mrs. LR Hobson - 07876 490194
PEBWORTH Mr N & Mrs. L Holdsworth - 01789721972 / 07894074041
HEATH HOUSE RCG & EC Lywood – 01547530149
ALDEROAK
P & E Williams – 01743741755 / 07843238039
CALLAUGHTON W Milner Ltd - 07816531845
LONGRIDGE
C McCreath 01785715050 / 07866540127
Members of Hereford Cattle Breeders’ Association have enjoyed a busy year of socials, farm walks and a restructured herds competition.

Hereford Cattle Breeders’ Association (HCBA) started 2022 on a high from an extremely successful Christmas Calf show in December 2021, the first the association had held in two years, since the pandemic.
Thankfully, most of the running of the club has returned to normal and members began the year with the AGM. David Makin announced the end of his tenure as chairman with Andrew Whitlow succeeding to the role and Colin Powell of Roughmoor Herefords elected as vice. Andrew Whitlow says: “I would like to thank David for all his advice and dedication to the club over the last couple of years.”
Emma Davies and Jenny Pudge were re-elected as secretary and treasurer with Gerald Blandford succeeding Richard Bradstock as president, who was thanked for all his time spent as HCBA president.
As soon as the clocks changed and daylight could be enjoyed, members held their first farm walk of the year. This was kindly hosted by Robert and Richard Thomas of Risbury Court. It was an eye-opening experience with the farm now running as a regenerative farming system. Richard’s passion and enthusiasm for how modern farming practices can work hand-in-hand with
nature was clear to see. It was a pleasure to see how the Hereford breed was working at the centre of such a holistic system. A sociable evening was had by all with members now starting to focus their attention on the herd competition in July.
At the beginning of July, the Lewis family held their Bicentenary Sale of Haven and Boycefield cattle. The association congratulates Edward, James and all the Lewis family on their successful sale to commemorate 200 years of breeding Hereford cattle. It was a great spectacle to witness and was the culmination of generations of hard work and excellent breeding. The association wishes the family all the best for the next 200 years.
The association was extremely lucky to welcome Clive Roads of McCartney’s Auctioneers as master judge for the 2022 herd competition. Clive’s knowledge and experience of cattle shone throughout, when giving his reasons to our members after judging
over 20 herds from across the West Midlands. Responding to feedback from last year’s judge, the association decided to add extra classes, which added depth to the competition and is something that will now continue. A huge thanks goes to Free Town Herefords and the Bradstock family for hosting the awards evening and providing an insight to what goes on at their farm. A fun, sociable evening was had by all and even some stock judging was thrown in for good measure.
Heading into the autumn months, a social was held at Boycefield Herefords, kindly hosted by James Lewis and family. Here, members received an excellent herd tour of the Boycefield herd which is paddock grazing cattle on a regenerative system. The HCBA also welcomed guest speaker Nick Gibbons, partner of Belmont Vets who gave members a fascinating insight into the new animal pathway legislation that is being brought in as part of the new government
support scheme. Thanks go to James and Cin Lewis for such a warm reception and to Jenny and Colin Powell who did a sterling job of the catering.
Approaching the winter months, attention then turned to the HCBA Christmas Calf Show. Building on last year’s success, prize money was increased for each class which was supported by generous sponsors. New championship rounds were added for senior and junior male and females. The association must also thank member herds who sponsored new competition trophies; Adzor, Bosa, Haven and HighHouse Herefords. Focus to improve and expand on the young handler’s competition also took place with competitors across all age groups challenged and encouraged to approach public speaking; skill which will be needed in all elements of life but particularly as their career in the breed grows as future judges. The calf show was also used as a chance to market the newly designed HCBA 2023 calendars which includes photos from members’ herds for each month. There was an outstanding display of cattle from all exhibitors with over 120 entries. The committee thank all those who exhibited, spectated, and helped run the show and look forward to seeing exhibitors again next year.
Looking ahead to 2023, the HCBA is keen to see how it can grow and develop
the association and provide all our members from Staffordshire, Shropshire, Worcestershire and Herefordshire a quality club experience which can work for all.

Overall herd, Haven, EL Lewis and son
Small herd, Heath House, R and E Lywood; 2nd, Buckenhill, M Gray and L Crowther; 3rd, Bramley, SG and HPJ Bowen
Medium herd, 1st, HighHouse, JR and HM Whitlow; 2nd, Bosbury, S Hawkins; 3rd, Thames, A and S Timbrell
Large herd, 1st, Haven, EL Lewis and son; 2nd, Free Town, RA Bradstock and partners; 3rd, Hyde/Docklow, J Walker
Stock bull and progeny, 1st, Boycefield Stormzy, RA Bradstock and partners; 2nd, Solpoll 1 Lawman, EL Lewis and son, 3rd, Drumatee Rocket, JR and HM Whitlow
Best bull calf, 1st, Free Town Wealth, RA Bradstock and partners; 2nd, Border Vancouver V3, SW Quan and co; 3rd, Haven Wellington, EL Lewis and son
Best heifer calf, 1st, Haven Dowager, EL Lewis and son; 2nd, Thames 1 Ruby, A and S Timbrell; 3rd, T and M Goodwin, Roughmoor Dawn 320T
Best bulling heifer, 1st, Free Town 1 Victoria, RA Bradstock and partners; 2nd, Buckenhill Brownie V329, M Gray and L Crowther; 3rd, HighHouse Roulette W39, JR and HM Whitlow
Best yearling bull, 1st, Free Town Vaughan, RA Bradstock and partners; 2nd, Heath House Voldermort, R and E Lywood; 3rd, HighHouse Roulette Voltage, JR and HM Whitlow
Best cow and calf, 1st Bosa 1 Brownie and Bosa 1 Brownie 74, G Blandford; 2nd, Roughmoor Dawn 208 and Roughmoor Dawn 320, T and M Goodwin; 3rd, Blackhall 1 Cleopatra and Blackhall 1 Katie 26, J Pudge
Best stockman, 1st, Daniel Seabourne; 2nd, Mark Chandler; 3rd, Daniel Goodman
















































To celebrate 200 years of the Lewis family’s time breeding Hereford cattle, the Haven and Boycefield herds held a sale which saw records tumble.

Staged on-farm at The Haven, Dilwyn, Herefordshire, the Lewis Family Bicentenary Sale saw a number of breed records smashed by the Haven and Havenfield herds of EL Lewis and son and JW Lewis’ Boycefield herd, on celebrating 200 years of the Lewis family continuously breeding pedigree Hereford cattle.
The sale saw a new female and poll female record set by EL Lewis and son, who still also hold the breed’s male price record set in 1980. A new official sale record average was set and across the offerings from the two breeders, the sale broke the European female record sale average at £6,252, with the Boycefield females averaging £5,394 while Haven and Havenfield heifers averaged £6,592. With the society’s official auctioneer Jonny Dymond in the rostrum, a fast-paced exchange around the ring saw bids fly to 20,000gns for Haven Thrush 74th, a September 2020-born heifer. Paying the money was New House Herefords, Hampton Bishop, Herefordshire and in doing so a new female price record was set at public auction. This powerful and correct female can be traced back 22
generations to one of the foundation cows purchased in 1850 under the Lewis ownership.
By Irish-bredsire Shiloh-Farm Elite, it is a maternal sister to Haven Kermit which won the 2014 National Hereford Show as well as a maternal granddaughter of Haven Wizard, the horned Hereford bull of the year 2005. Haven Thrush 74th was sold in-calf to Mawarra Influential Q162 which EL Lewis and son purchased shares in at Australia’s National Hereford Show and Sale for AUS$42,000 in 2021. Also beating the previous female record although later on in the sale was Boycefield Acorn 45th sold to a top call of 14,000gns to A Whitfield, Derrington, Staffordshire. The Lewis’ Acorn line descends from the famous LL Moore’s Brampton herd and is a full sister to Boycefield Stormzy which stood reserve champion at the 2019 Kington Show. This September 2020-born heifer was sold in-calf to Boycefield Congo, reserve male champion at the 2007 Royal Show.


Generating another piece of history on the day was Havenfield 1 Lady Lynda 3rd, which after selling to A Whitfield for 12,000gns, now stands as the breed’s new poll female record price made at public auction. In 2021, this October 2020-born heifer was judged best heifer calf in the West Midlands by Dinmore Limousins’ Richard Bartle. Sired by stock bull Solpoll 1 Lawman which stood supreme champion at Tullamore Show in both 2016 and 2017, its dam is by Haven Lamborghini, the 2019 National Hereford Show senior male champion. Another from the run of in-calf heifers, it sold incalf to Dendor 1 Kohinoor.
Next in the money was Haven Curly 144th which sold to FC Jones and co, Kington, Herefordshire where it will join Upper House Herefords having realised 10,500gns. September 2020-born, it was another in-calf to Australian bull Mawarra Influential.
At 7,800gns was Havenfield 1 Ruby 4th, a March 2021-born heifer, selling to H Davies, Amlwch, Anglesey to join the Llynon herd. Another from EL Lewis’ poll herd, it is out Dendor 1 Ruby 20th which was Kington Show champion in 2015 and also produced Havenfield 1 Robinhood, the 2018 National Calf Show male champion.

Another poll animal, this time Havenfield 1 Mary Irene sold to a call of 7,200gns, at just 13 months of age, it added to A Whitfield’s purchases of the day, and will join his Butterbank herd. This young maiden was a heifer’s first calf and is out of Greenyards 1 Mary-Irene S485
which was purchased from the Allmans’ dispersal sale in 2020 and goes back to Dendor breeding.
Not far behind at 7,000gns was Havenfield 1 Lucy 8th, a December 2020-born heifer carrying a Dendor 1
Kohinoor calf which sold to Newport Farms, Almeley, Herefordshire. By Solpoll 1 Lawman it is out of Romany 1 Lucy D1 M16 which was purchased privately from Robert Wilson’s herd in the Scottish Borders.






In-calf heifer Haven Queen 2nd saw bids climb to 6,500gns, and was another bought by Newport Farms. By ShilohFarm Elite, it is out of Dovemount Gipsy L5, bred by Thorley Bros.
At 6,200gns was Haven Lady Lynda 60th which sold jointly to Bob Borwick, Northampton and Buckinghamshirebased Paul Snell, with half of the sale price to be donated to My Name’5 Doddie Foundation in memory of Leslie Lewis, Edward and James’ father who was responsible for putting both the Lewis’ cattle and the wider breed in the spotlight in the 1950s and 60s.
The gavel went down at the same money for Havenfield 1 Lady Lynda 4th going to I Hurley, Claines, Worcestershire. By the AUS$95,000 Minlacowie Jubilant J123, it was sold as in-calf to Dendor 1 Kohinoor.
Also selling at 6,200gns was Haven Curly 145th, going to Anthony Spooner, Staffordshire. Sired by Haven Snowdon, its dam Haven Curly 109th also produced Haven Nugget, the 2017 horned Hereford bull of the year.




Other sale highlights for JW Lewis’ Boycefield herd included Boycefield Pinky 33rd which changed hands at 5,500gns to JR Whitlow, Abbots Morton, Herefordshire and joins the HighHouse herd. By stock bull Lisrace Lumberjack 18th bred by Northern Ireland’s David Wilson, it is from a long line of Haven Pinky females.
Boycefield Lady Lynda 26th also travels to HighHouse Herefords who had come back for more after previously buying a full sister. It is again by Lisrace Lumberjack 18th and was the only Lady
Lynda on offer from the Boycefield herd, selling for 5,200gns.
Just one bull went through the ring at this special sale and came in the form of Havenfield 1 Tyson which went on to sell at 8,500gns to Nigel Hooper, Leigh Sinton, Worcestershire. Not far off three year old and sitting in the top 1 per cent of the breed for terminal and selfreplacing indices, it is another from the famed Lady Lynda family.
Auctioneers: Halls
Averages: 36 total head, £6,326; 14 Haven and Havenfield in-calf heifers, £7,387.50; 3 Boycefield in-calf heifers, £7,945; 13 Haven and Havenfield maiden heifers, £6,243.46; 5 Boycefield maiden heifers, £3,864; 1 bull, £8,500
mark 200
Hereford cattle, the society gifted them a framed photograph to be hung in Hereford House.
At the November council meeting, the Lewis family, consisting of EL Lewis and son of the Haven and Havenfield
herds and JW Lewis of the Boycefield herd, visited Hereford House for a presentation to mark their 200th year of breeding Hereford cattle.

The family were presented with a framed photograph of an image chosen by the family – Haven Wizard, the 2005 Three Counties Show champion. The photograph is now hung at the entrance of the boardroom in Hereford House and is a nod to the family’s long history within the breed. With many historical images lining the walls of the society’s premises, the image of Wizard shows
how history is still being made in the modern day and will now be an up-todate part of a tour of Hereford House when showing visitors around the building.
On presenting the photograph, society president Carolyn Fletcher said: “As a society, we owe you a debt of gratitude for your long history in the breed, the record-breaking sale in July and in doing so, promoting the Hereford breed. It shows what dedication we have in our breeders and long may it continue.”
Bicentenary Sale - 28 Pedigree Cattle averaged £6592.50 (Halls Auctioneers)





























We would like to thank everyone who helped us celebrate our Bicentenary Sale. We thank the purchasers and underbidders who showed such con dence in our cattle. It was a day to truly remember for us as a family.
We were honoured to host HRH Princess Royal who visited us to mark the Lewis Family’s contribution to the Hereford breed over the last 200 years.

Stock & Semen for sale - give us a call!

One of the earliest shows of the year, Shropshire County Show saw Spartan 1 Typhoon from SC and GL Hartwright stand champion.
At Shropshire County Show, SC and GL Hartwright, Abingdon, Oxfordshire led the judging with Spartan 1 Typhoon tapped out by judge Andrew Owen as supreme and male champion. This two year old bull also had a successful lap around the show circuit last summer, winning its class at the Great Yorkshire and Shropshire County, and placed reserve male champion at Royal Lancs and reserve champion at Stafford.
It is sired by Solpoll 1 Perfection, purchased at the 2019 society spring show and sale for 8,000gns which went on to win the 2019 Devon County and Royal Bath and West breed championships that year with stockman Luke Murphy on the halter.


Taking the reserve spot and leading the female section was Hallwood 1 Lady Jewel from R and RI Shaw, Ledsham, Cheshire. January 2021-born and sired by Fabb 1 Northern Star, it is out of a homebred dam.
Standing reserve in the female championship was Spartan 1 Duchess T95 from SC and GL Hartwright, a daughter of Solpoll 1 Perfection which has bred so many of the breeders’ show ring successes. Out of Ruckmans 1 Orange 1332, it was born in February 2020 and also won the senior female class.
was chosen as Andrew Owen’s reserve male champion. By stock bull Moyclare Quinlan, it is out of Free Town Penchant, which is a daughter of Hustyn Scotty, bred by Cornwall’s Fred Hawke.
The January to March 2021-born bull class was led by another Bradstockbred bull; this time Free Town Vaughan. Also by Quinlan, it is bred from their long established Plum family.
Dendor 1 Vivian from DE, ED and AL Jones, Caersws, Powys won the red
ticket in the junior bull class at just shy of 14 months of age. By AI sire Gouldingpoll 1 Moonshine, it is out of Dendor 1 Holly 10th, a daughter of Bakgard 1 Keno 1178.

It was back to Hartwrights’ stable to find the winner of the July to December 2020born heifer class in the form of Spartan 1 Victoria’s Secret. Another Perfection sired member of the Spartan show team, it is out of Cleland 1 Glissade 26th.
In the junior heifer class, Moorside 1 Violet from G and MC Shepherd, Preston,
Lancashire stood at the top-end of the line out. By the 13,000gns Coley 1 Pilot, the female line goes back to Bernard and Barbara Rimmer’s Jackie family.
In the pairs, Emma Jackson’s home-bred duo came to the fore with Eveter 1 Gin 3rd V27 and Eveter 1 Gin 4th V28 while the group of three came from A and P Massey’s Hollyvale herd.



Katherine Shaw of Hallwood Herefords took the top honours in the young handlers’ class.



peak at 4,000gns for a cow and calf outfit.
Eldersfield 1 Necktie P1228 topped the reduction sale of the Eldersfield herd held on behalf of Lorraine Hobson at Hereford market at 4,000gns, setting a trend for females with heifer calves at-foot. By Bosa 1 Hereward and out of a home-bred dam, it sold to Michael Clark, Malmesbury, Wiltshire with its fifth calf at-foot, a Buckenhill 1 Pirlo daughter. It was in-calf to Free Town 1 Thunder.
Next in the money was another fifth calver, Eldersfield 1 Lilac P1282 with its Solpoll 1 Landmark sired heifer calf. By Rough Moor 1 Lorenzo, it sold at
3,600gns to GB Essex-Potter and co, Bringsty, Worcestershire.
Eldersfield 1 Bobbie R1410 saw bids to 3,200gns, adding to J Barrington’s purchases from the day and was another senior cow with a Free Town 1 Thunder heifer calf at-foot. It sold in-calf to Bosbury 1 Thomas.
Selling at 3,100gns to T and M Goodwin and C Powell, Upcott Alemely, Herefordshire was Eldersfield 1 Sara R1377, another by Rough Moor 1 Lorenzo. Born in March 2018 and in-calf to Free Town 1 Thunder, its March-2022 heifer calf is by Buckenhill 1 Pirlo.
Eldersfield 1 Beauty L007 saw the hammer go down at 2,800gns selling to MJ Sharlot, Weston-under-Wetherley, Warwickshire. Sired by New Zealand bull Kairuru Xavier 02 0011, it is out of Llancillo Hall Beauty 12th. This time this fifth calver was sold with a bull calf, sired by Buckenhill 1 Pirlo and was another to
sell in-calf to Free Town 1 Thunder.
Selling at 2,750gns was Eldersfield 1 Oyster R1399. Going home with TJ Van Rees, Llanwrtyd Wells, Powys, it is a four year old with its Landmark sired heifer calf at-foot. It sold in-calf to Free Town 1 Thunder.
The hammer went down at 2,700gns for Eldersfield 1 Emma Jane L973 which was another purchased by J Barrington, with a Buckenhill 1 Pirlo daughter at-foot and in-calf to Free Town 1 Thunder.
Also at 2,700gns was Eldersfield 1 Sara L1016, an eight year old, having had six calves, including Eldersfield 1 Rhodium, its Buckenhill 1 Pirlo bull calf which sold at-foot. It sold in-calf to Bosbury 1 Thomas to TG, EI and EN Thorne, Milford Haven, Pembrokeshire.
Auctioneers: Hereford Market Auctioneers

Following the presentation of awards at Groundswell, Billy Lewis has been announced as the Mixed Soil Farmer of the Year. The competition, now in its seventh year, is organised by the Farm Carbon Toolkit in conjunction with Innovation for Agriculture (IFA).
The competition aims to find farmers and growers who are engaged with, and passionate about managing their soils to create a highly sustainable, resilient and productive agricultural system.
Billy farms 145 hectares (358 acres) in Herefordshire, producing a variety of arable crops alongside sheep and the Boycefield
herd of pedigree Hereford cattle.
Billy’s focus on the farm has been to regenerate tired soils which have previously been in a high-intensity arable system and implementing a rotational grazing system to create high quality forage for the livestock.
Billy says: “We have introduced herbal leys which are managed through predominately mob grazing with additional cutting if needed. We started with a select group of animals and now graze everything in a mob system.”
The arable rotation on the farm is fully integrated with herbal leys and diverse swards to ensure livestock are able to graze and improve soil health.
He says: “The arable rotation is no more than three years before going back into a ley and seeing the hooves of an animal once more”.
In addition to the livestock, Billy also uses composted FYM to benefit soil health and plant nutrition.
“Spreading compost as soon as the bales are cleared from the field means
we can generate really productive catch crops before the following cereal, benefiting our soil health and nutrient capture,” says Billy.
This has led to vast reductions in nitrogen use, with the farm’s main goal being to drive down fossil fuel use and inputs.
“We have halved the amount of nitrogen we use in three years and would look to half this quantity again over the next three,” he says.
Billy has been selected as the winner in the mixed farm category this year due to his passion and attention to detail for integrating livestock into the arable system and maximising his pasture productivity through diverse leys and a mob-grazing approach.
He says: “Our farm is coming to life and now functioning as a whole and healthy ecosystem.”
Speaking on his motivation, Billy says: “If you don’t make mistakes you’re not learning, you’ve got to have faith and stick to your guns.”

Having never shown at the Shrewsbury event before, Maddy Scott of Holmefold Herefords won supreme champion with a junior bull.

Holmefold 1 Rocco from Maddy Scott, Tower View, Lancashire strode into the supreme champion position at the Hereford Cattle Breeders’ Association Christmas Calf Show held at Shrewsbury Auction Centre.
At 25 years of age, Maddy has just six cows including Rocco’s dam Hoghton View 1 Chico 1st bred by S and E Walker from the Chico line at Baldinnie Herefords. Born in March 2022, it is by Hoghton View 1 Kid Rock, which is a Dendor 1 Kohinoor son.
Judging the line-ups was Limousin and commercial cattle man, Colin Phillips, Sarnesfield, Herefordshire. Colin praised his champion saying it had ‘serious power’ and a ‘lovely front’.
Occupying the reserve position was Spartan 1 Woodsman from SC and GL Hartwright, Abingdon, Oxfordshire.
September 2021-born it is by current UK sire of the year Solpoll 1 Perfection, which itself is a son of the renowned Panmure 1 Henry. Also winning senior male champion, it is out of Bounds 1 Madalaine, a daughter of Romany 1 Juggernaut.
Reserve to the supreme champion in the junior male championship was nine month old Rempstone 1 Worldwide N649 from M Ludgate, Thame, Oxfordshire. Out
of Danish-bred Rosenkaer Miss World, it is another by a Dendor bull, this time the 2018 National Poll Show champion, Nairobi.

Taking the reserve senior male title was October 2021-born Kinglee 1 Wizzbang from Pete Cobley, Stoney Stanton, Leicestershire. By Cleland 1 Nelson which was purchased by the breeder at the 2018 autumn show and sale for 3,100gns, it is out of Kinglee 1 Star 371, a Leos Pride 1 Ellis daughter.



Adding another title to its name was Coley 1 Duchess 609 from Heather Whittaker, Halifax with Maddie Clark once again on the steering end and tapped out as senior female champion. Standing supreme at Agri Expo in October and reserve grand female at the National Poll Show, this September 2021-born Solbakkens Patrik daughter is out of the 5,900gns Gouldingopll 1 Duchess 916.
Next to Duchess as reserve senior female champion was Studdolph 1 Vogue
839 from Non Thorne, Milford Haven, Pembrokeshire. At 12 months old, this female is by AI sire Fabb 1 Northern Star while the Vogue line at Studdolph goes back to Dendor’s Greta family.

Junior female champion was selected as January 2022-born Bowendu 1 Ruby 2nd from L and L Bowen, Nelson, Glamorgan. By Solpoll 1 Trailblazer which was purchased for £10,000, it is out of Dendor 1 Ruby 23rd, one of the Bowen’s original female purchases.

Moralee 1 Pippa BS265 from Tom and Di Harrison, Mickley, Northumberland was named as reserve junior female champion. A daughter of the Canadianbred Auckvale Barnstormer, its dam was one of the breeders’ foundation females and 2017 Royal Highland Show supreme champion, Coley 1 Pippa 356.






Elsewhere in the classes, Hoghton View 1 Jack Hammer from S and E Walker, Hoghton, Lancashire took the red ticket in the January/February 2022 bull class. A son of the 2021 National Poll Show senior male champion, Hoghton View 1 Jackaroo, it is out Gouldingpoll 1 Pebbles 846 which the breeders purchased for
3,400gns from the 2019 Goulding Opportunity sale.
Glenvale 1 Galway Guy from TG, El and EN Thorne, Milford Haven, Pembrokeshire won the most junior bull class at just eight months old. It is by Gouldingpoll 1 Stockman semen and out of the
Glenvale Polly line which consistently produces for this herd.
Leading the line-up of March 2022-born heifers was Dendor 1 Anna Mary 44th from DE, ED and AL Jones, Caersws, Powys. By Romany 1 Distiller son Dendor 1 Trigger, its female line is layered with generations of Dendor breeding.
Rempstone 1 Bonny N655 from M Ludgate headed up the April 2022 heifer class. Another by Dendor 1 Nairobi, its home-bred dam is by Solpoll 1 Hollywood which also bred the mother of Rempstone 1 Vegan N621 which sold for 4,800gns at the 2022 autumn show and sale.
The pair of bull calves was won by the Kingsland herd of Vaughan Farms, Kingsland, Herefordshire.
The pair of heifers class was won by FJ Wood and sons, Moreleigh, Devon and consisted of Allwood 1 Faith by Pepperstock 1 Tremendous and Allwood 1 Greta, a Kilvrough 1 Thomas daughter.
Finlay Soutter, 17, won the champion young handler title having already led the intermediate class on the day and follows winning the interbreed championship at the English Winter Fair in November. From Bowendu Herefords,

21 year old, Ethan Brook won the senior class and the reserve champion award. First time exhibitor Ashley Hughes won the junior class at 11 years old and was also named as winning the future champion award.

 L-R Mike Chandler, Mark Hooper, Edward Lewis and Princess Anne
L-R Mike Chandler, Mark Hooper, Edward Lewis and Princess Anne
On arrival at The Haven, HRH Princess Royal was received by The Lord Lieutenant of Herefordshire who introduced local civic dignitaries.
She was then introduced to Edward Lewis who presented the Lewis family and escorted her to `The Loft`, a visitor’s room which has recently been renovated with the help of a Herefordshire Leader Council grant. Here, the Lewis family’s involvement in the breed was explained through a timeline and numerous historic photographs, many of which included other Royal Family members.
After signing the visitors’ book The Princess Royal viewed cattle destined for the National Hereford Show before meeting the next generation of custodians of the family’s cattle breeding, Ben and Billy Lewis in the paddocks. Here, they discussed the future of Hereford breeding, including embryo work and the benefits of utilising paddock grazing and herbal leys in their systems.
The next stop for Her Royal Highness was to meet Philip Alman, chairman of the Hereford Cattle Society’s council, society president Carolyn Fletcher and director of operations Paul Sneyd. They outlined how the society works and is adapting to new trends in the beef market.
Finally, Her Royal Highness was invited to present long service awards to Mike Chandler, Mark Hooper and Andrew Baugh who accumulatively have worked for the Lewis family for over 146 years.
Edward Lewis said: “As a family, we were delighted to be able to welcome HRH The Princess Royal to The Haven and share our history and passion of Hereford cattle with her.”
Before leaving the farm, 91 year old Nancy Wellings, who previously worked for the family, presented a posy to Her Royal Highness and Carol Lewis presented a hamper of local Hereford produce.






There was great success for Midlands and East Anglia Hereford Breeders’ Association at the National Stockjudging Competition.
The National Stockjudging Competition returned in 2022 to its normal venue of the Royal Three Counties Show. Midlands and East Anglia Hereford Breeders’ Association’s members made a clean sweep in the team competition with Ryan Coates.


Second placed team was another from Midlands and East Anglia, this time consisting of Tommy Smith, Steve Edwards and Pete Cobley.
Placing third was another Midlands and East Anglia trio, in the form of Mike Shaw, Richard Mann and Rob Dickin.
Congratulations must also go to first time competitor Llewelyn Rosser of Lowesmoor Herefords who won the cup for the most individual points achieved by an under 25.
As per tradition, master judge was society president Carolyn Fletcher. She said: “Despite there being a two year break from the competition, I was glad to see such enthusiasm in the number of entrants. The competition is useful in giving members the opportunity to practice their own stockjudging and learn the points a judge may look for in the ring. The friendly rivalry between teams gives it an extra buzz.”


Having already won some notable titles, Sky High 1 Miss Allure continued its success at the Royal Three Counties, winning supreme champion.
Sky High 1 Miss Allure from Boomer Birch, Graham Brindley and Nick Griffiths, Staffordshire stood supreme, grand female and junior female champion at the Royal Three Counties Show, with the line ups sorted by experienced judge Steve Edwards, Leicestershire.
Born in February 2021, Miss Allure won supreme champion in the National Pedigree Calf Show held at the English Winter Fair and was also junior champion at Stars of the Future. Also having travelled south on the summer show scene, this heifer won female champion and interbreed native heifer at the Royal Bath and West. By Dendor 1 Kohinoor, it is a son of Danish-imported SMH Euro 30E and out of Dendor 1 Jennefer 15th, the two times Hereford female of the year which is a daughter of Solpoll 1 Gilbert, the three times UK sire of the year.
Taking a clean sweep in the male championship was RA Bradstock and partners, Tarrington, Herefordshire who took the reserve supreme position and male championships with Free Town Vaughan. Another February 2021 born animal, it is by Moyclare Quinlan and out of Free Town Plum 109th.
Standing next to its stable mate in the male championship and having won the September to November 2020 bull class was Free Town Versatile. Another Quinlan son, this bull was out of Free Town
Perkin, which again carries generations of Bradstock breeding.
In the reserve female spot was Thornysure 1 Vixen from M and C Shaw, Ilmington, Warwickshire. A daughter of Kinglee 1 Pure Gold, it is out of a home-
bred dam, by Fisher 1 Monarch. Born in December 2020, its female line goes back to Hermitage breeding.
Senior female champion was picked out as Newtoncroft 1 Dora 416 from Newtoncroft Farms, Newton Harcourt,
Leicestershire. Born in March 2020, it is by Solpoll 1 Hollywood and out of Hawkesbury 1 Dora, which goes back to Costhorpe breeding.
The reserve senior female champion rosette went in the direction of Rempstone 1 Fashion N584 from M Ludgate, Thame, Oxfordshire. By Solpoll 1 Nobility, it is out of Kinglee 1 Fashion 304, which again goes back to Costhorpe breeding.
Buckenhill 1 Trans Am from M Gray and L Crowther, Bromyard, Herefordshire was judged senior male champion. January 2020-born and a Cornriggs 1 Knightrider son, it is out of the Anxiety line at Buckenhill.



Reserve senior male champion, Porton House 1 Meridian from L and L Powell, Hengoed, Glamorgan. The first bull to sell from the Porton House herd in 2022, it is a Gouldingpoll 1 Moonshine son and out of one of the best cows at Porton House, Dendor 1 Lilac Wine 28th.
Away from the championships, Bosbury 1 Vanderpool BN from Sarah Hawkins, Bosbury, Herefordshire won the March to April 2021 born bull class. Out of Bosa 1 Elke, it is by Barwise 1 Nabucco, which is a grandson of Remittal Online 122L. The junior heifer class was won by Porton House 1 Jane 2nd from P and V Moyle. May 2021 born, it is by Dendor 1 Sherlock.
In the pairs class, Rempstone 1 Fashion N584 and Agri Expo 2021 supreme champion Rempstone 1 Curly N604 teamed up to take the red ticket.

On their first time entering, TG and FM Hart, Monmouth, won the champion carcase accolade at the English Winter Fair, as judged by D Morland, Tebay, Cumbria.
Scott Coates, a familiar face within the society who is associated with the Monmouthshire-based business, decided to enter the carcase competition after being shut down with TB and therefore unable to show the March 2021-born animal in the live classes.
By Danish-bred sire Moeskaer Upgrade, the steer weighed 630kg at home before making its way to HP Westwoods of Cannock, the designated slaughterhouse for the show, before hanging up at 347kg on the hook, grading at an R4H. During Sunday afternoon sale, the carcase sold back to the slaughterhouse at £4.70/kg.

In the Hereford classes of the pedigree primestock section, Tom and Di Harrison, Mickley, Northumberland led the judging with steer, Moralee 1 Venture RK V23. A Rebel Kicks son, weighing in at 625kg, the March 2021-born steer won its class before being promoted to Hereford champion, by judge Tecwyn Jones, Llantrisant, Anglesey. The steer was led through the sale ring at £2.85/kg.
Leading the heifer class was Normanton 1 Jurana 22nd V398 from TD and
WT Livesey, Ashby-de-la-Zouch, Leicestershire. April 2021-born, it is a Laertes daughter, and out of a homebred Alvian 1 Emperor daughter. It sold for £3.30p/kg and weighed 525kg.
There was also more success for the Herefords at the show when the Moralee and Normanton herds teamed up to win
reserve champions in the Duke of Norfolk group of three interbreed competition. The team consisted of Normanton 1 Jurana 22nd V398, Normanton 1 Victor and Moralee 1 Venture RK V23.
In the non-pedigree section, Porkie, a home-bred Vexour 1 Phantom sired steer from Dorset’s RA and VA Mitchell
It was a great day for the breed at the English Winter Fair as a Hereford carcase beat all other entries.Champion carcase from TG and FM Hart
won the Tim Bickford Trophy for the champion Hereford cross animal sired by a Hereford bull.
Reserve in the cross-bred Hereford championship was Ruby from Steven and Helen O’Kane, Adfa, Powys. Sired by Moralee 1 Rebel Kicks, the heifer weighed 605kg and sold at £3/kg.



Within the National Pedigree Calf Show which is hosted at the Winter Fair, Normanton 1 Winter Wonderland W372 stood second place in the any other native senior calf class, having already stood reserve senior male champion at Agri Expo. By the 4,000gns Panmure 1 Pudding it was purchased at the 2018 autumn show and sired Normanton 1 Fistulina 35th V569 which sold for 4,800gns.
Staying within the any other native breed classes, judge Charlie MacLean, Eastleigh, Hampshire of Mortimers Charolais directed Newtoncroft 1 Whole Lot-of-Fun into the first place position, ahead of other competing breeds. Born in January 2022, it is by Hawkesbury 1 Swift and out of Dendor 1 Honeysuckle.
SC and GL Hartwright, Abingdon, Oxfordshire led the senior heifer class with Spartan 1 Oyster Gem SP166. Born in October 2021, it is by sire of the year Solpoll 1 Perfection and won its class at Agri Expo.
An all-Hereford junior heifer class saw Tom and Di Harrison come to the
fore with Moralee 1 Kylie OR263. By Scottish-bred Baldinnie 1 Orient, it is out of a home-bred Spurstow 1 Recruit 1st daughter.
Finlay Soutter of Normanton Herefords took the young handlers championship, following on from his class win at last year’s event.





President: Mr Bernard Rimmer Chairman: Mr Richard Jackson
Honorary Secretary: Mrs Jackie Cooper, Pollards Farm, Howick Cross Lane, Penwortham, PR1 0NS
Tel: 07960 994 376 Email: nehbasecretary@gmail.com Facebook: North of England Hereford Breeders
Durham
CORNRIGGS HEREFORDS: Mr Harry Elliott, Low Cornriggs Farm, Cowshill, Weardale, Co. Durham DL13 1AQ
Tel: 01388 537600 Mobile: 07760 766794 Email: cornriggsfarm@btconnect.com www.cornriggsfarm.co.uk Facebook: https://www.facebook.com/henry.elliott
STARLIGHT POLL HEREFORDS: Mr. Stuart Hall, Plough Farm, Haswell County Durham DH6 2AZ Tel: 01915 208158 Email: ploughfarm@icloud.com
BETHANFIELD HEREFORDS: Bethan Hutchinson, Field House Farm, Greatham, Billingham TS23 3TQ Mobile: 07903 415044
Email: bethan3012@hotmail.co.uk
Facebook: facebook.com/bethanfieldherefords
AUCKVALE HEREFORDS: W & R Kemp & Sons, Wigdon Walls Farm, Bishop Auckland, Co. Durham DL14 0LN Tel: 01388 603395 Mobile: 07803 692545
Email: wigdonwalls@talktalk.net Facebook: www.facebook.com/auckvaleherefords
Northumberland
CHOLLERTON HEREFORDS: Jessica Anderson, Chollerton Farm, Chollerton, Hexham NE46 4TQ Mobile: 07954 164050
Email: jess.pazzi@hotmail.com
FOURSTONES HORNED HEREFORDS:
Fourstones, Fourstones, Hexham, Northumberland NE47 5DX Tel: 01434 674242 Email: ra-armstrong@outlook.com
WANSBECK HEREFORDS: Ailsa Dickinson, Three Farms, Harle, Newcastle upon Tyne NE19 2PS Tel: 01830 540278
Email: a.ilsa@hotmail.co.uk
MALLOWBURN HEREFORDS: Davie and Kate
Dickinson, Chattlehope House, Catcleugh, Newcastle upon Tyne NE191TY
Tel: 07881 379 809
Email: chattlehope@gmail.com
MORALEE HERERFORDS: Tom & Di Harrison, The Old Potato House, Eltringham Farm, Mickley, Stocksfield, Northumberland NE43 7DF
Di Mobile: 07962 076853
Tom Mobile: 07962 076 854
Email: moraleeherefords@gmail.com
www.moraleeherefords.co.uk
North Yorkshire
BLACKWOOD HEREFORDS: Stephen Tate, White Lodge
Farm, Green Lane, Easingwold, York YO61 3ER
Tel: 01347 823 190 Mobile: 07964 753079
Email: Stephen@thetates.me.uk www.blackwoodherefords.co.uk
WHITEHILL HEREFORDS: Mark and Gemma Dobson
Raikes Farm, Hartlington, Burnsall, Skipton, North Yorkshire
BD23 6BX
Tel: 01756 720210 Mobile: 0777 992 0202
Email: whitehillherefords@hotmail.co.uk www.whitehillherefords.co.uk
HANSON HEREFORDS: DK & DK Hanson, Bay View Farming Co, Bay View Farm, North Street, Flixton, Nr. Scarborough, North Yorkshire
YO11 3UA
Mobile: 07852334503
Email: david@hansonherefords.co.uk Web: www.hansonherefords.co.uk
CASTLE PARK HEREFORDS: Hazel Thompson, Woodview, 4 Station Road, Helmsley, York YO62 5BZ Mobile: 07881 581072
Email: hazelmorrison11@btinternet.com Facebook/hazelmorrison
KIPLINGCOTES HEREFORDS: AM & SV Soanes, Wallis Grange, Kiplingcotes, Market Weighton, YORK YO43 3LX Sarah Soanes, Tel: 07970416334 or 01430810664
Email: sarahvsoanes@gmail.com Web: kiplingcotesherefords.co.uk
Cumbria
CARLETON HEREFORDS: N & L Cummings, Hall Carleton farm, Saltcoats, Holmrook, Cumbria CA191YZ Mob 07581488378 Email neil.cummings@btinternet.com
BARWISE HEREFORDS: Mrs Carolyn Fletcher, Barwise Hall, Appleby in Westmorland, Cumbria CA16 6TD
Tel: 01768 353430 Mobile: 07711 415694 Email: info@barwisepedigreecattle.com
NETHERHALL HEREFORDS: Nether Hall Farm Ltd, Nether Hall, Mansergh, Kirkby Lonsdale, Cumbria LA6 2EW
Tel: 015242 73927 Mobile: 07808 050030 Email: netherhall@hotmail.co.uk
POPPLEMIRE HEREFORDS: T K Robinson, Greaves Farm, Popplemire Lane, Old Hutton, Kendal, Cumbria LA8 0NA
Tel: 01539 722444 Mobile: 07711 967932 Email: gbbears@hotmail.co.uk
Cheshire
BRADMORE HEREFORDS: Mr. John Morris, 1b Wrenshot Lane, High Legh, Knutsford, Cheshire WA16 6NQ
Mobile: 07711 506020 Email: bakersfield2@hotmail.co.uk

BARWICK POLL HEREFORDS: Mr E Warner & Mrs C Burnell, 12 Abbott Close, Aberford, Leeds LS25 3AZ
Tel: 07977 317 506 / 0777 399 4625 Email: christine.burnell@googlemail.com
STONER POLL HEREFORDS: Mr Brian J Boulton, Stones Farm, Wainstalls, Halifax, HX2 7UJ
Tel: 01422 240573 Mobile: 07399 178888 (Brian) Mobile: 07903 325341 (Lauren)
Email: stoner1lauren@hotmail.com
HALL GREEN HEREFORDS: James Siddall, Lower Hall Green Farm, Hall Green Lane, Rishworth, Sowerby Bridge, West Yorkshire
Tel: 07517562280 Email: hallgreenherefords@btinternet.com
COLEY HEREFORDS: Miss Heather Whittaker, Coley Walks Farm, Norwood Green, Halifax, West Yorkshire, HX3 8RD
Tel: Andrew Hughes 07861 899 646 Mobile: 07811 207 244 (Heather)
Email: coleywalks@tiscali.co.uk
Mr Alan Crooks, Well Hill Farm, Well Hill Road, Greenmoor, Sheffield S35 7DP Tel: 07957 543 646 Email: alancrooks1@live.co.uk
Northumberland
HOLLYVALE POLL HEREFORDS: A & P Massey, Hollins Mount Farm, Bury, Lancashire
Tel: Phil Massey 07878 Allen Massey 07917 324 471
Email: phil_massey@hotmail.co.uk
NEW DAWN HEREFORDS: Mr Matthew Rollason, Hill Top Farm, Mill Lane, Great Harwood, Lancashire, BB6 7UQ Mobile: 07794 458798
Email: matthew_rollason96@outlook.
Facebook: www.facebook.com/ newdawnherefords
Instagram: newdawnherefords
RIMINI POLL HEREFORDS: Mrs Jackie Cooper, Pollards Farm, Howick Cross Lane, Penwortham, PR1 0NS
Mobile: 07960 994 376
Email: mootoyoutoo77@gmail. com
PINMOOR POLL HEREFORDS: Mr Gary Hall, Sedbury Home Farm, Gilling West, Richmond, DL105LF
Tel: 07710 193 013
Email: gary_hall@ntlworld.com
EVETER HEREFORDS: Mrs E Jackson Bradley Hall Farm, Parr Lane, Eccleston, PR7 5RL Mobile: 07815 790880 Email: eveter@outlook.com
BARBERN POLL HEREFORDS: Mr & Mrs B & B A Rimmer, Holmefields Farm, Off Long Lane, Scorton, Preston, Lancashire PR3 1DB Mobile 0771 425 4564 Email: barbara.rimmer@hotmail.co.uk
HOLMEFOLD HEREFORDS: Maddy Scott
Holmefold Farm, Tower View, Belthorn, Blackburn BB1 2PD Tel: 07462 950 206 Email: maddyscott1997@gmail.com Facebook.com/HolmefoldHerefords
TAYMAR HEREFORDS: S R Taylor & D Marsh, 6 Jane lane, Hesketh Farm, Midge hall, Leyland, Lancashire PR26 6TQ Tel : 07740193866 & 07860636605 or Matt Taylor 07832480355 Email: moocowdebs@yahoo.co.uk Facebook:Taymar livestock
HOGHTON VIEW HEREFORDS: S & E Walker, Lane Side Farm, Blackburn Old Road, Hoghton, Preston, Lancashire, PR5 0SG Tel: 01254 852187 Mob: 07814 056943 Email: steven@hoghtonviewherefords.co.uk Website: www.hoghtonviewherefords.co.uk facebook.com/hoghtonviewherefords / instagram: hoghtonviewherefords

CRAWFORD HEREFORDS: Rebecca and Chris Abbott, Moorside Farm, Hobson Moor Road, Mottram, Cheshire SK14 6SG Tel: 07388 034502 Email becabbott@outlook.com www.crawfordherefords.co.uk
LEO’S PRIDE POLL HEREFORDS: B & J Ellis, Bores Farm, Chorley Road, Worthington, Wigan, WN1 2XJ Mobile: 07967 741 492 Email: bettyhereford@outlook.com
HALLWOOD POLL HEREFORDS: R & R I Shaw, Hallwood Farm, Badgers Rake Lane, Ledsham, South Wirral, Cheshire CH66 8PF
Mobile: 07885 438 993 (Ian) Mobile: 07774 469 896 (Robert) Email: robertshaw1102@gmail.com
WALROSE HEREFORDS: Mr Sam Walton, Weaver Dairyhouse Farm, Stocks Hill, Winsford, Cheshire, CW7 4EE
Tel: 07840 638877 Email: farmersam_123@hotmail.com
WYTHEN POLL HEREFORDS: Wythenshawe Community Farm, c/o Allen Massey, Wythenshawe Park, Wythenshawe Road, Wythenshawe, M23 0AB Tel: 0161 946 0726 Mobile: Allen 07917 324 471
Richard Jackson of Eveter Herefords took over the reigns of chairman from Phil Massey, in what he says seems a more settled period than what his predecessor endured during Covid, but the challenges now are rising costs of fuel, feed and energy.
Richard says: “I think as a breed we are well positioned and equipped to tackle these challenges head on, not losing site of the main aim to breed functional and commercially viable cattle.”
Richard started his role as chairman after the North of England Hereford Breeders’ Association (NEHBA) AGM in February 2022 having served as vice to Phil, and thanks his predecessor for his commitment to NEHBA over the last three years.
Richard adds: “It has been a huge honour to be voted in by the NEHBA members, I would like to thank them for their support and faith in me to become chairman.”
The association’s year started in February with their AGM. Much was discussed and debated with lots of interesting ideas including looking into marketing ideas for the association to push forward at a more local level.
“We have a great secretary in Jackie Cooper, who prepares the agenda for our AGM. Without Jackie’s commitment
over the years, NEHBA would not have run as smoothly. Thanks Jackie,” says Richard.
One the biggest discussions at the AGM is always generally in relation to the Great Yorkshire Show which is without doubt the pinnacle of the showing season in the northern area and quite possibly the whole country. The association plans many social events around the few days at the show including a stockman’s supper and stockjudging event for a bit of fun, to include members of the public. I would like to congratulate the Hartwright family and Luke Murphy on their success with the breed champion, Spartan 1 Typhoon.
During the summer Richard and his wife Emma spent a lot of time out at summer shows, including both one day shows and some national events. Richard says the reduced numbers of cattle at many of these shows was very noticeable, purely down to ever rising costs involved in production and transportation.
Richard comments: “Seeing this reduction does fill me with a little concern. We must not forget the importance of our shop window and engagement with the public who are in an indirect way our customer. Be the face behind our brand - it’s good to talk.”
The summer shows came and went with quite a pace, followed by winter fairs and calf shows in no time. NEHBA and the Scottish Hereford Breeders’ Association jointly planned the Hereford calf show held at Agri Expo in Carlisle. Both associations formed sub-committees to discuss plans and many phone calls took place between the Scottish chairman George Harvey and I but I would like to personally thank Margaret Galbraith, the Scottish Association’s secretary for the majority of the work in the background.
“It was an impressive show of cattle on the day, on behalf of both associations I’d like to thank all the exhibitors for their effort and commitment in making

With a change of chairman for the North of England Hereford Breeders’ Association, members in the area have had another busy year.Male and female champions at Royal Lancs Show
the event a great success not forgetting our judge for the day William McMordie of Solpoll Herefords. Congratulations to Heather and Andrew of Coley Herefords with their supreme champion,” says Richard.

The year ended for NEHBA with a herd visit to Lower Hurst Herefords, Hartington, Derbyshire. Hosted by the Sebire family and farm manager Sam Walton, members had a very informative talk by Sam as they walked around the cattle and the farm. It was great to see honest, functional cows doing exactly as they should. Members broke off for lunch and the NEHBA presentation followed promptly afterwards. Congratulations to all winners in their respective categories, thank you to Lesley Sebire and Sam Walton for their time and effort on the day.


Going up a gear from its 2021 class win, Spartan 1 Typhoon from Oxfordshirebased SC and GL Hartwright strode into the supreme champion position, at the Great Yorkshire under the direction of judge Robert Thomas, Herefordshire.
Typhoon is the most successful homebred animal to come out of the Spartan stable, the Hartwrights have been consistently performing in the ring in recent times. This February 2020-born bull is a son of Solpoll 1 Perfection, bred by Northern Irish breeders John and William McMordie, and purchased at the 2019 society spring show and sale for 8,000gns, before winning multiple show prizes. It is out of Panmure 1 Plum K19, a line which has consistently delivered for Scottish breeders JM Cant and partners.


As well as 2021’s success at the Great Yorkshire, Typhoon also won its class at Shropshire County while this year it placed reserve male champion at Royal Lancs, reserve champion at Stafford and supreme at Royal Norfolk and Shropshire County.
Following through from the male championship and into the reserve supreme spot was Harveybros 1 Va-VaVoom, also standing junior champion. Born in March 2021, it is by Normanton 1 Laertes and out of Harveybros 1 Crocus E2 from the only female line at the Harvey’s stable, which goes back to Panmure’s Crocus family.
Spartan 1 Duchess T95, another from
on from success at the Highland, the Great Yorkshire was another successful show for Spartan 1 Typhoon.Spartan 1 Typhoon from SC and GL Hartright Harveybros 1 Va-Va-Voom from G and S Harvey
the Hartwright’s programme, took the female championship, mirroring its position at the Royal Norfolk just the week previous. This February 2020born heifer is out of Ruckmans 1 Orange 1332 and again by Panmure 1 Henry son Solpoll 1 Perfection.
Reserve female and reserve junior champion was Sky High 1 Miss Allure from B Birch and G Brindley and N Griffiths, Staffordshire, having also been tapped out as supreme champion at the Royal Three Counties in June. Miss Allure won supreme champion in the National Pedigree Calf Show held at the English Winter Fair in 2021 and was also junior champion at Stars of the Future 2021 and female champion and interbreed native heifer at the Royal Bath and West this summer. It is out of Dendor 1 Jennefer 15th, the two times Hereford female of the year which is a daughter of Solpoll 1 Gilbert, the three times UK sire of the year.
In the bull born after April 2021 class, Dendor 1 Vodka from Bethan Hutchinson, Billingham, Co Durham stood at the top end of the line-up. Bred by DE, ED and AL Jones, Powys, it is by 2018 Royal Welsh champion Gouldingpoll 1 Moonshine and out of Dendor 1 Wattle 9th, a daughter of Bakgard 1 Keno, the 2017 champion.


Also having travelled from Co Durham, Auckvale 1 Beth 1791R from W and R Kemp and sons led the cow class. Brought into the country as an embryo from Canada, its donor dam is CBB 4R Iggy 511C which the Kemps own a share of in Canada.


Coley 1 Duchess 609 from Heather Whittaker, Halifax saw victory in the junior heifer class. By Danish bull Solbakkens Patrik, it is out of Gouldingpoll 1 Duchess 916 bred



by Ireland’s Matthew Goulding, and purchased for 6,000gns at the Goulding Opportunity sale in 2019. This young female was shown on its mother at the Royal Highland where the unit placed

reserve champion.
The Wirral’s R and RI Shaw saw success in the group of three while it was back to the Spartan stable to find the winning pair.









North Yorkshire farmer Doug Dear has built his contract finishing unit virtually from scratch.
Doug’s business model could be seen as unusual to some, not owning a single head of beef in his extensive yard. The same could be thought of those who send the animals there, owning cattle which they do not keep themselves. But with numbers comes efficiencies, and Doug is able to feed cattle in this way more efficiently and in turn can pass this on to his customers.
Situated in the heart of the food manufacturing area of the country, co-products are readily available to someone who can handle bulk and flex to accommodate different loads and feed types.
It was the beef price of 10 years ago which pushed Doug down this avenue.
He explains: “About a decade ago the price of beef was on the floor and we had yards full of cattle. We either had to stop or do something differently.
“We looked at bed and breakfast pigs, and I decided to replicate the same model but with cattle.
“We are providing a turnkey feeding operation. We don’t specialise in calf rearing or growing cattle, but are good at feeding them and so in this way we can pass on the benefit of our expertise to other people’s operations.”

Initially Doug was sending cattle to one processor but after four or five years, Doug decided on a ‘farmer retained’ strategy, and says these days he could have cattle from 28 different customers in his yard, sending anything from 20 to 1,000 every year from each owner.
At any one time there are 1,000 cattle on the yard, with 3,300 cattle finished every
Doug Dear finishes 3,300 cattle annually, and says among the breeds which enter his North Yorkshire yard, the Hereford performs particularly well.
year but Doug says with the demand he receives he could easily expand further. He says: “Some of my customers come and regularly look at their stock, and others I have never met,” he adds.
“We don’t take anything out of Scotland but we will receive cattle from Northern Ireland, Southern Ireland, Wales and the whole of England.”
Life is also made easier for Doug from being a licensed finishing unit in a TB4 area meaning he doesn’t need to worry about TB tracer testing.
Buying forward and in bulk is key to keeping the family’s costs down, which the likes of waste Yorkshire puddings and brewers’ grains play an important part in.

Doug comments: “We can buy much more than a standard person can. We buy 40 tonne of Yorkshire puds and 60 tonnes of brewers’ grains every week.”
Despite Doug’s innovative approach to running a beef unit, the Dear family are certainly not newcomers to farming, having been at their family farm since 1919. Now run with Doug and wife Pam at the helm, parents Alan and Elizabeth had kept suckler cows while Doug was growing up. At this point, the farm was 223 hectares (550 acres), but since purchases have been secured to expand the farmed area to 567ha (1,400ac).
With this scale of available land, the farm is able to produce 75-80 per cent of its own feed and is self-sufficient when it
comes to straw. All muck then goes back onto the ground.
Doug comments: “Year-on-year we need more straw and more feed so hence our gradual expansion.”
When it comes to stock Doug does not want to receive cattle at 450kg or less but instead favours those at 500kg, to take on to 620kg, to be ‘just nicely in spec’.

He comments: “I like to work for 300kg dead but anything from 270kg to 350kg is OK.”
Nothing has grazed on the farm for 20 years. The pens which are semi covered are where cattle do the best.
Increasing numbers of native breeds, of which the Hereford makes up a good proportion, are entering Doug’s yard.
He also comments that less and less of these cattle are suckler-bred and are now increasingly coming from the dairy herd which he says makes a good cross.
“The Herefords don’t take a lot of feeding and are of a good nature. They can do 2kg per day with no worries.”
Doug says the Hereford is sometimes thought to go over fat, but he says it all comes down to management.
He adds: “They don’t go too fat, you just have to be on you’re A-game. Hereford heifers come and go, they are really easy to feed.
“The Hereford is an easy feeder and very docile while producing good-eating meat with a good fat content. Herefords eat less and grow more quickly than continentals, and what’s more, they are good on their feet. We never have lame Herefords.
“The Herefords in our yard are averaging a gain of 1.6kg per day, with the best hitting 2kg. Some of these continentals are doing nowhere near that. We increase our feeding by 2 per cent every day until they plateau out.”
Doug comments: “We don’t seem to get any health problems with the Herefords. If the cattle haven’t achieved the required weight and finish at 120 days, they go anyway.”
Cattle are weighed in on arrival and again on exit and 100 to 150 could easily pass out and be replaced every week.
Doug says he is aiming for 90 days finishing, saying 80 to 90 days is optimum. If it gets to 120 days, it will go anyway, he says.

Top 1% for Low birth weights & calving ease. 120 bull calves averaged 38.2 kg & 115 heifer calves averaged 36.4 kg (2022)


Top 1% for eye muscle area and Retail beef yield. Heifers & Bulls
Carcase Scanned at 14 months old.
Bulls in Top 1% for Scrotal Size. Naturally reared- super fertile. Vet Checked
HIGH HERD HEALTH

Johnes & BVD accredited, BVD & LEPTO vaccinated,TB 4 year testing. No Risk


MILK
Top 1% of the breed for Milk. All Cows udder scored. No Creep Feed
Great feet and Mobility
No feed- Just Grass
“Customers receive entry and exit weights and are informed exactly what they have been fed,” Doug explains. This continual flow of cattle allows for regular kill sheets and figures and therefore information to respond to if required.

It could be easy to over complicate a system such as Doug’s but that is not in his mind set and Farmplan and Tru Test systems are utilised.
He says: “We will use data if it is simple to use and if it is relevant. Really, we just need to know what is in the yard and if it is growing or not. Keep it simple. You can really complicate stuff.”
On arrival everything is IBR and pneumonia vaccinated as well as wormed and fluked, which is charged to the customer at cost.
Every animal is given the farm’s own management tag with an initial and a number, and with savings key to the success of Doug’s business, once their system gets to 1,000, they start again at 0, to save the time writing unnecessary numbers of digits.
Doug has his own gripes with the industry, saying the small to medium store producers do not value farm assurance schemes and as such a two-tier beef system has been born. This also brings time required for Doug as if cattle are to be killed after being on the holding for less than 90 days, their farm assurance status has to be checked.
Working with nine processors, Doug says whatever an abattoir wants in terms of cattle, he can provide from his yard. Some buyers visit the yard to view cattle. When it comes to Herefords, those from his yard could end up at Dovecote Park, Dunbia or Hartshead Meats.
Doug comments: “I am not tied to an abattoir. If they want cattle they will have to bid against each other.
“We are trying to place cattle to suit the processor. Some customers do however favour selling live and so we do put cattle through the ring for them such as at Selby and Thirsk markets. I don’t like sending too many nice cattle to one market just to keep the trade up.”
Doug says he favours sending dairy crosses on the dead, adding ‘it is what it is and it is all agreed’.
“Everything was suckler bred when we started out but now the whole job is swinging towards dairy cross. The whole industry will swing that way, he says. Every processor requests the cattle are clipped and at Osgodby Grange three clippers are run at once to get the job done as quickly as possible.
With Doug and two staff members, Steven Dodds and James Wiles, on the farm, he says two people can bed and feed the 1,000 cattle within two hours. He says he would expand if he could get additional reliable staff, but this comes with its own challenges.
Time is put into drawing cattle correctly but Doug says these days it takes longer to do the paperwork than process the cattle.
As the farm’s arable production increases, the farm looks to become more and more self-sufficient, and Doug generates his own electric and uses the farm’s own well.
The beef operation is totally unsubsidised along with three quarters of the arable operation. The rotation follows a pattern of maize, wheat, barley, oilseed rape, wheat and then maize.
“A massive saving is made by using home grown spring barley in diets, which we mill every day here,” says Doug.

Integrated into the system are 2,500 store lambs, which are kept again on stubble turnips used as a cover crop before the maize and potatoes and are also run on a bed and breakfast arrangement with a set fee per hectare. Doug comments: “The war in Ukraine has helped the government see the need for sustainability of food supply. I am also worried that the notion of net zero and so called sustainability will come at the cost of food production.
“There is absolutely no point in net zero when India, China and the USA have not adopted it. All we will end up doing is putting our own agricultural industry out of business to end up buying produce from our competitors who are not working to the same goal.”
• 567ha (1,400ac) farmed area
• Finishing 3,300 cattle each year



• 1,000 on-farm at one time
• 2,500 store lambs

Cornriggs 1 Vancouver from Mr and Mrs H Elliot, Cowshill, Durham led a small entry of Herefords at Harrison and Hetherington’s native sale at Carlisle at 3,600gns. Born in October 2020, it is by Minlacowie Jubliant J123 and out of a home-bred Cornriggs 1 Valerie 3rd daughter. This October 2020-born bull was bought by R and I Watson, Kirkcudbrightshire.
Making 3,000gns and selling to TE Stephenson, Whitley Chapel, Northumberland was Barwise 1 Viking MU 1175 from the home of society president Carolyn Fletcher, Applebyin-Westmorland, Cumbria. By
MoeskaerUltra 1582, it is out of a Moeskaer Patriarch 1458 daughter from Barwise’s Rose line.
Having travelled west from Forest-inTeesdale, Durham, TW Hutchinson’s Kingshaugh 1 Upgrade sold at 2,800gns to J and A Currie, Carluke, Lanarkshire. This April 2021-born bull is by Solpoll 1 Dynamite and out of Kingshaugh 1 Lady, a cow bred from semen of the Canadian sire Axa Golden-Oak Xceed 704X.
In the female section, the top call was made at 2,200gns for March 2021born heifer Kingshaugh 1 Una from TW Hutchinson, selling to JG Smith and RJ Staveley, Gisburn, North Yorkshire.
Another by Solpoll 1 Dynamite it is out of a home-bred JSF 271 Dice ET 10M daughter.
Carolyn Fletcher’s Barwise 1 Wild Rose MU T1163 changed hands at 2,000gns to BPF Norwood, Heads Nook, Cumbria. Another Moeskaer Ultra 1582 son, it’s dam, Barwise 1 Wild Rose is a daughter of Dendor 1 Goblin. This May 2020-born heifer had been running with Barwise 1 Tortuga in the autumn.
Auctioneers: Harrison and Hetherington
Averages: 3 bulls, £3,290; 2 females, £2,205


Steven and Lizzie Walker
Lane Side Farm | Blackburn Old Road | Hoghton Preston | Lancashire | PR5 0SG 07814056943 01254 852187
www.hoghtonviewherefords.co.uk


Tom and Di Harrison, Mickley, Northumberland. Born in April 2018, it was also the joint poll bull of the year in 2019 and many commercial producers stopped to examine this bull.
Local breeder, Bethan Hutchinson of Bethanfield Herefords, brought 2017-born cow Bethanfield Lisette and bull calf Bethanfield 1 Wolverine. This female was reserve supreme at National Hereford Show 2018 and horned female of the year in the same year.

Beef Expo 2022 was held in Darlington Mart in May and following a Covid-induced hiatus, the event saw a great attendance.
Hereford Cattle Society's stand saw a great deal of visitors and interest, mainly due to the cattle kindly provided by members.
One of the main attractions was champion of Europe and multiple interbreed winner Moralee 1 Rebel Kicks KS R12 from

Bernard & Barbara Rimmer
Bulls & heifers for sale and all enquiries welcome
Senior Bull - Barwise 1 Plutarch
Newly purchased junior bull - Hollybush 1 Viscount
W and R Kemp and sons, Bishops Auckland provided 2014-born Dendor 1 Muttley. Sired by three time UK sire of the year, Solpoll 1 Gilbert, it is out of Dendor 1 Honeysuckle 6th.
The Kemp family also provided a Hereford-cross steer, sired by Auckvale 1 Resolution 1780R and out of a British Blue cross Holstein, weighing 590kg.
Steers were jointly provided by Tom and Di Harrison and Steven and Helen O’Kane with both sired by Moralee 1 Rebel Kicks KS R12 and went to take second and third in the native classes.
Spot was out of Limousin-cross and weighed 520kg at home 6 May 2022 while Freckle Kicks was born February 2021 out of a Shorthorn-cross British Blue and weighed 560kg at home on 6 May 2022.
Contact Barbara on 07936 515794
Email: barbara.rimmer@hotmail.co.uk or Bernard on 07714 254564
Email: bernardrimmer48@gmail.com
Holmefields Farm, Off Long Lane, Scorton, Preston, Lancashire, PR3 1DB
TB4 & BVD accredited
Visitors made most welcome
The Hereford Cattle Society stand attracted many visitors at Beef Expo, with particular interest in the cattle on display.Typical Barbern female L-R Di Harrison and Helen O'Kane


Visitors always welcome Visits and transport arranged

www.herefordni.co.uk
Date for 2023 National Show
Weds 26th July 2023 at Clogher Valley Show
SHOW AND SALE DATES 2023 (Dungannon Farmers Mart)
Native breed sale Tuesday 14 February
Native breed sale Tuesday 18 April
Native breed sale Tuesday 5 December
Secretary: Mark Moore, 51 Glassdrummond Road, Aughnacloy, Co. Tyrone, BT69 6DE Mob:07966876575 Email: mark-moore@hotmail.co.uk
Chairman
William McMordie - 07891903243
CO.ANTRIM
MOUNTVIEW
T Andrews, 02893344376, 07801448939 trevorandrews67@btinternet.com
18 Ballyfore Road, Raloo, Larne, BT40 3NF
AUGHNAMULLAN
P & N Beatty, 07835111360 nicky.martin7@hotmail.co.uk
22 Belfast Road, Nutts Corner, Crumlin, BT29 4TQ
BALLYPALLADY
S Cherry, 07779036556 steviecherry_69@yahoo.co.uk
77 Ballymartin Road, Templepatrick, BT39 0BS
POLLDONA
SH Coleman, 02825 685796, 02825 685396
Hardona 160 Dunminning Road, Glarryford, Ballymena, BT44 9ET
DOREPOLL
JE & RI & W Haire, 02890 825215, 02890 825215 haire.dorepoll@btopenworld.com
Loughanhill 41 Divis Road, Dundrod, Crumlin, BT29 4UB
BOGHILL
FA & E Kerridge, 02894433780
9 Connor Road, Parkgate, Templepatrick, BT39 0DY
BALLYMAVE
I Martin, 07783193323 i-martin@hotmail.co.uk
94 Ballinderry Road, Upper Ballinderry, Lisburn, BT28 2NW
ROSELODGE
E McCorry, 02894454104 eamon.mccorry@hotmail.co.uk
50B Crumlin Road, Ballinderry, Lisburn, BT28 2JZ
DRUMSHANBO
J & G Small, 07836701782 - G, 07725914391 - J ethancareysmall@yahoo.co.uk
Hilltop Farm, 23 Creeve Road, Randalstown, BT41 3LW
President Treasurer
William McMordie - 07891903243
CO.ARMAGH
UMGOLA
S Baxter, 02837 524606, 07752392229 stephen.baxter20@yahoo.co.uk
Tarascon House, 22 Monaghan Road, Armagh, BT60 4DA
DRUMATEE
J Conlon, 2837551488, 07753471873 drumateelivestock@hotmail.co.uk
27 Gosford Road, Markethill, BT60 1QD
BROUGHAN
S Curry, 02837 511200 sg.curry650@btinternet.com
86, Ennislare Road, BT60 2PU
RICHMOUNT
J Graham, 02838336570, 07984458007 espritni@btconnect.com
Carrick Hill, 42 Richmount Road, Portadown, BT62 4JQ
HILLTOP
Mrs K Greenaway & Mr WG Conn, 07801844723 kathryngreenaway@live.co.uk
Ithiel House, 23 Derryvinny Road, Birches, Portadown, BT62 1SX
DERRYGAVAD
C Halliday, 02838852684, 07598135648 lhalliday100@gmail.com
21 Derrgavad Road, Annaghmore, Portadown, BT62 1ND
GLENMOUNT
J & A Henning, 0784301681 jimbohenning@gmail.com
17 Keadymore Road, Mountnorris, BT60 2UH
SWEET BRIAR
Miss J Hunter, 02837507259, 07706873733 jennahunter643@hotmail.co.uk
20 Derrycughan Road, Markethill, BT60 1RW
GRACELAND
R & J Irvine, 02837507005, 02837507005 robin.irvine@nigta.co.uk
115 Ballymoyer Road, Whitecross, BT60 2JN
Stephen Baxter - 07752392229
KINNEGO
C Kerr, 07956656588
ciarankerr_86@hotmail.co.uk
67 Annesborough Road, Kinnego, Lurgan Craigavon, BT67 9JD
FARNALOY
R Milliken, 07821728584
beckymilliken90@hotmail.co.uk
76 Farnaloy Road, Madden, BT60 3LR GROVEHILL
W Morrow & Son, 02838 330777, 07855 829420 morrowportadown@btinternet.com
Grove Hill Farm, Drumnakelly, Portadown, BT62 3SG
NANCY
G Morton, 07761979806 glennmorton@hotmail.co.uk
11a Madden Road, Armagh, BT60 3LN
MULLANTINE
N Patterson, 02838335615, 07860356727
64 Mullantine Road, Portadown, Craigavon, BT62 4EJ
CLUSTER D Toner, 07845050751 declantoner87@gmail.com
200 Coolmillish Road, Cashel Tassagh, BT60 2QY
LESSANS
P Auret, 02897 510141, 07808923894
126 Monlough Road, Saintfield, Ballynahinch, BT24 7EU
BALLYNAHINCH
J Coulter
j.coulter700@btinternet.com
58 Dromara Road, Ballynahinch, BT24 8JW
DRUMADONNELL
R Fee, 07833744016 robinfee@hotmail.co.uk
41 Drumgooland Road, Ballyroney, Banbridge, BT32 5HB
LUSKY
WJ Gill, 02897542757, 07968754976
57 Saintfield Road, Killinchy, Newtownards, BT23 6RL
BOLEY
J Henning, 02840632020, 07739611220
180 Castlewellan Road, Cabra, Newry, BT34 5EX
CLONROOT
WI Hewitt, 02838 333866 bertiehewitt007@gmail.co
Tree Tops, 48 Drumard Road, Portadown, Craigavon, BT62 4HP
LISOLA
Mrs J Martin, 02890 817292, 07745080388 - D Martin jackie.martin@live.co.uk
34 Lisdoonan Road, Saintfield, BT24 7HH
BROOKFIELD
Roy & Pat McClenaghan, 02890427945 r_mcclenaghan@hotmail.com
Brook Cottage, 72 Ballymiscaw Road, Holywood, BT18 9RW
BALLYCRUNE
C McCord, 07709390346, 01159451000
271 Ballynahinch Road, Anahilt, Hillsborough, BT26 6BP
MAYTOWN
D McMinn Johnston, 07835696101 dianemcminn05@hotmail.co.uk
22 Main Street, Bessbrook, Newry, BT35 7DJ
SOLITUDE
A McMordie, 02897528222, 07890042168 andymcm8@hotmail.co.uk
Solitude, Ballygowan, Newtownards, BT23 6NA
RIVER-DALE
McMordie Family, 028 97511181, 07836362029 norman.mcmordie@gmail.com
3 Riverdale Lane, Saintfield, BT24 7JG
SOLPOLL
J & W McMordie, 02897 528222, 0786 6125959 johnmcm@hotmail.co.uk
Solitude, Ballygowan, BT23 6NA
RINGDUFFERIN
MH Farms Ltd, 028 91878316, 07836668719 louise@mashdirect.com
81 Ballyrainey Rd, Comber, Newtownards, BT23 5JU
LISNAREE
M Murdock, 02840631301 murdockr25@yahoo.co.uk
25 Shinn Road, Newry, BT34 1PB
GLASSDRUMMOND
A Rea, 02897561084, 07828489414
62 Glassdrumman Road, Ballynahinch, BT24 8TW
MAGHERAKNOCK
D Smyth, 02892 639322, 02892639322 m5wds@hotmail.com
Magheraknock House, 65 Creevytennant Road, Ballynahinch, BT24 8UJ
CARNEY HILL
J & K Taggart, 07715906009, 02891 862345 johngtaggart@hotmail.com
34 New Road, Carrowdore, Newtownards, BT22 2HB
BARNBURN
B & G Watson, 07990517766 Greer Watson watson595@btinternet.com
64 Templeburn Road, Crossgar, Downpatrick, BT30 9NG
CASSAN
G Buchanan, 028 66387580, 07923838822 Cassan House, Innishmore, Lisbellaw, BT94 5NN
GLEBE
M & J Doonan, 028 677 51844, 07809835427 Drummonds Glebe, Roslea, BT92 7NU
KILLYVILLY
N Elliott, 02866328077
niallelliott@aol.com
16 - 18 Cloghtate Road, Hilltop, Killyvilly, Enniskillen, BT74 4AJ
CORCREEVY
N Hudson, 07780912961
niallhudson@hotmail.com
8 Raw Road, Brookeborough, BT94 4GE
CORRABACK
RM Richmond, 02867748382 corrabackherefords@hotmail.co.uk
Killynick, Aghalane Enniskillen, BT92 9HJ
LISRACE
DR Wilson, 02867751666
Lisrace, Magheraveely, BT92 6PP
BALLYMENAGH
J A Nevin
129 Cashel Rd, Ringsend, Coleraine, BT51 4HW
MAGHARACASTLE
T Nevin
j.nevin129@btinternet.com
130 Cashel Rd, Ringsend, Coleraine, BT51 4HW
CASTLEPOLL
C & M Beatty & Son, 028855 57349
49 Leany Road, Castletown, Cabra, Dungannon, BT70 1SL
CANDLEFORD
R Black, 02882 252695, 02882 841746 robertblack@live.co.uk
10 Rogers Road, Tattykeel, Omagh, BT78 5DD
CLOGHER VALLEY
I & G Browne, 07901856063 beechcroftnursery@btinternet.com
47 Screeby Road, Fivemiletown, BT75 0LF
DRUMGOLD
P Collins
peter.colins@btinternet.com
105 Moy Road, Dungannon, BT71 7DX
BALLYMULLY
IR Elliott, 07419988454, 02886762012
pelliott_bob@hotmail.co.uk
24 Sessiagh Road, Cookstown, BT80 8SN
KILLYCURRAGHPOLL
AJJ Glasgow, 02886751305
Springhill, Killycurragh, Cookstown, BT80 9LR
PALLAS
A & S Irvine, 02889561735, 07764204410 fingerpostherefords@hotmail.co.uk
Fingerpost, 4 Derryallen Road, Trillick, BT78 3RZ
MULLIN
D Kelly, 028 87752909, 028 87752990 des.kelly@cavanaghkelly.com
7 Dergenagh Road, Ballygawley, BT70 2JY
KILMORE
J Kirkland, 07771776747 jaykirk69@hotmail.com
29 Ballyvaddy Road, Brantry, Dungannon, BT70 1LW
HILLSIDE
RA Knipe, 07702 341681
5 Donnelly’s Hill Road, Benburb, Dungannon, BT71 7NL
TAMNABRADY
D McCrea, 02871343194 dereknmccrea@btinternet.com
22 Ballybeeny Road, Bready, Strabane, BT82 0DF
OSCAR
K McOscar, 07711342003 kevinmcoscar@gmail.com
Island Farm, 35 Derrygonigan Road, Cookstown, BT80 8SU
ANNAGHBEG
M Moore, 02885557317, 07966876575 mark-moore@hotmail.co.uk
51 Glassdrummond Road, Aughnacloy, BT69 6DE
CONDUFF
R Morrow, 028 855 57360
39 Rehaghey Road, Aughnacloy, BT69 6EU
ROUGHAN
AJ Patton, 02885567443, 07827444014 45 Annaghilla Road, Roughan, Augher, BT77 0BS
TULLYMORE
R Pogue, 0283754 9649, 07860402673 info@poguesoilsolutions.com
54-58 Milltown Road, Benburb, Dungannon, BT71 7ND
BENBURB
A Shaw, 07711227782
alanshaw17@gmail.com
17 Lisgobbin Road, Dungannon, BT71 7PT
SESSIAGH
N Shaw, 07966795243 - Dad n4uelshaw@hotmail.co.uk
16a Lisgobban Road, Dungannon, BT71 7PT
THORNBANK
SH Stewart
22 Cavandarragh Road, Castlederg, BT81 7NZ
Solpoll Herefords’ William McMordie was chair of the Northern Ireland Hereford Breeders’ Association in 2022 and looks back on a positive year.
Looking back on 2022, it must be seen that it was a successful year for the breed both at local in Northern Ireland and national level.
Locally, the Northern Ireland Hereford Breeders’ Association celebrated its 50th anniversary.

Chairman William McMordie says: “Although very few of the herds that were present at the founding meeting are still active now, I’d like to think they’d be happy with how the association has met the numerous challenges over the 50 years to keep the breed relevant and be a viable option for local commercial farmers.”
With the return of a full show season
Herefords were the most numerous breed at most of the shows, particularly at the National Show in Armagh where there was a fantastic turnout for society president Carolyn Fletcher to place. The calf show had a record turnout and was live streamed for the first time.
Of the three bull sales in Dungannon, the April sale was the standout with 10 bulls averaging £3,707 and a new Northern Irish record price of 5,600gns.
Williams says: “The only disappointment is that 10 bulls seems to be highest number to sell in any Dungannon sale lately. Hopefully this is something that will be pushed upwards in 2023.
“Nationally it was important to see
record prices being set at 16,000gns and 20,000gns, hopefully this is the beginning of five-figure prices becoming the normal, especially for bulls. For too long the breed has been poor relation among the natives and these headlines prices are important to help highlight all the positive attributes the Hereford is associated with to more commercial farmers especially as sustainability and more economical farming are becoming more important.”
Although geographically small, there are a lot of Herefords registered in Northern Ireland and the cattle produced in the province can hold their own. Of the six animals sold publicly at auction for fivefigures sums, four were sired by Northern Irish-bred sires alongside class winners at both the National Poll and National Hereford Shows.
William continues: “Looking forward to 2023 we have finally got our new website up and running after a series of delays, this should give better access to information and available cattle for sale from our local members. Having a better presence at our various events and shows will help keep the breed in the public’s mind, but this wouldn’t be possible without our members bringing cattle forward to our shows and sales with the level of numbers and quality seen this past year.
“The 2023 Balmoral Show is Wednesday 10 to Saturday 13 May and the National Show is at Clogher Valley on Wednesday 26 July. We openly invite all members and any area associations who wish to visit; they will be made most welcome to come and see what Northern Ireland Herefords have to offer.”
EST. 1953
For bulls that breed for others
Barnburn 1 Ulsterman, Champion & new N.I. record price of 5600gns at N.I. Spring Sale. Sired by Solpoll 1 Ringo, 2022 N.I. Sire of the Year.
Havenfield 1 Lady Lynda 3rd, 12,000gns at Lewis Family 200 year sale. Sired by Solpoll 1 Lawman, 7 progeny averaged £7995 in the sale.






JOHN & WILLIAM MCMORDIE


Balmoral Show returned to its normal May fixture in 2022, following disruption over the Covid period, making it the second show at the showground in eight months.
Northern Irish breeders put forward a strong entry of 46 cattle from 13 different exhibitors and were pleased to welcome judge PJ Budler to Balmoral Show to sort the line ups. These days, PJ is best known for his organisation of the Hereford Champion of the World competition which he runs from his Texas base and over time has enjoyed success within the Hereford, Angus, Red Angus, Braford and Brahman breeds.
Leading Wednesday’s judging and taking the supreme champion title was Dorepoll 1 Sally 679 from JE and RI and W Haire, Dundrod, Co Antrim. This heifer was born in February 2021 and led the youngest female class in the show, before winning the grand female and supreme titles. With a pedigree packed full of Dorepoll breeding, it is by Dorepoll 1 639 Perfection, while grand dam Dorepoll 1 262L Sally also stood champion at the show, back in 2013. It also won the breed’s junior and female championships.
Taking the reserve supreme was Richmount 1 Treadstone from James Graham, Portadown, Co Armagh. By Australian sire Mawarra Mustang, it is out of Richmount 1 Laura, a Barbern Gargantuan daughter. Born in September 2019, it was also the grand


male champion after standing at the top end of the most senior bull class. This bull’s maternal sister stood reserve champion at the 2019 Balmoral Show. The first calf born from Treadstone was exhibited at the foot of the first prize winning cow, Richmount 1 Mabel.
Co Antrim’s Stephen Cherry secured the reserve grand female position with Ballypallady 1 Top Notch. The winner of the senior heifer class, it is a daughter of one of the herd’s foundation females Hawkesbury 1 Veronica and was sired by Dorepoll 1 499 Heritage, a bull which twice won the senior bull class at Balmoral Show.
The Haire family also lifted the reserve male championship with the five year old stock bull Dorepoll 1 639 Perfection, the first calf of which is this year’s champion Sally 679. Its pedigree is full of home breeding being a son of Manhattan and out of Tessa 545E, which is also a previous Balmoral reserve female champion.
Another victor from the Graham stable, this time Richmount 1 Mabel led the senior female class. By Richmount 1 Kaiser which is a Greenyards 1 Dougie son this seven year old is a maternal sister to the 2011 Balmoral Show female champion.

Solpoll 1 Starlet V11 from J and W McMordie, Ballygowan, Co Down took the red ticket in the intermediate heifer class. This October 2020-born daughter of the 2018 Balmoral champion Starlet P2 was sired by Herberry 1 Herbert. The Solpoll team also won the group of three with Starlet V11, Duchess V23 and Herberry 1 Humberto.
Irish-bred Country Crest Jack from Peter and Ciaran Kerr took the bull, born on or after 1 April 2020, and on or before 31 December



2020 class. By Moyclare Phoenix, it is out of Ballyaville Isla and was senior male champion at last year’s calf show.


The youngest bull class was led by Kinnego 1 Valentino, again from Peter and Ciaran Kerr which went on to take the reserve junior champion title. January 2021-born, this junior bull is by Kinnego 1 Rocketman and out of Lusky 1 Hope, a Solpoll 1 Classic daughter. No stranger to success Valentino was placed best spring-born calf in last year’s herd competition.
The progeny pair was won by James Graham and his duo of Treadstone and Tabitha, both sired by Mawarra Mustang.
Judge PJ Budler congratulated exhibitors who had brought out cattle and commented he hoped the UK could again become a global source of
genetics for the Hereford breed. He gave comments on every animal present during their classes and before tapping out his supreme champions commented the champions had the ability to work in a variety of markets across the world and said he was impressed with the strong entry of quality cattle in front of him.
During the week’s interbreed classes, Solpoll 1 Starlet V11 was native and reserve interbreed beef performance champion, while Solpoll 1 Duchess V23 stood reserve native champion for J and W McMordie.
The last class of the week was the native team of five which was won by the Herefords. Representing the breed was by Richmount 1 Treadstone from J Graham, Ballypallady 1 Top Notch from
Stephen Cherry, Solitude 1 Helen T991 from A McMordie, Solpoll 1 Starlet V11 from J and W McMordie and Dorepoll 1 Sally 679 from JE, RI and W Haire and were chosen as winners for the second year in succession.
Judge William Smith, Meath said: “There’s a good bull dominating four exceptional females. The females are really well balanced. The group caught my eye from the minute they came in, they’re easy winners.”
Elsewhere, the Hereford team won the interbreed stockjudging competition, and consisted of William McMordie, Solpoll Herefords; Will Awan, Midford Herefords; Ciaran Kerr, Kinnego Herefords and Greer Watson, Barnburn Herefords.

The premier sale of Herefords at Dungannon Farmers’ Market saw a strong entry of 19 bulls from 10 exhibitors with Cathal Flynn of Rossmore Herefords from Co Monaghan tasked with judging the pre-sale show.
The three class winners took the top three prices in the sale, led by Graceland 1 Tom from Robin and James Irvine, Whitecross, Co Armagh selling to John McConville, Rathfriland for 3,500gns under auctioneer Stephen Redmond. A May 2020-born son of stock bull Blakesley 1 Nobility which was judged best stock bull in last years’ herds competition, it is out of the home-bred Fisher 1 Jubilee daughter, Graceland 1 Nino.
Taking the championship and the day’s second top price of 3,000gns was the McMordie family, Saintfield, Co Down with the July 2020-born River-Dale 1 Valiant. A superior carcase sire, it carried
top 15 per cent figures for eye muscle area, retail yield and terminal index. Sired by the 2021 Balmoral Show reserve male champion Solpoll 1 Real Good, its dam was the reserve junior female at 2019 Balmoral Show and headed to Rathfriland to the home of William Hanna.
The day’s third best price of 2,600gns
and the purchase of Colin Hunter was Broughan Ibis from Shane and Lauren Curry, Co Armagh on these breeders’ debut in the show ring. A March 2020born Gurteragh Aristocrat son, its dam was a home-bred Drumatee Manus daughter.


Average: £2,670

With a packed ring at Dungannon Farmers Mart, the spring show and sale laid host to a solid trade for bulls and a new centre record price set for the breed.
Leading the trade at the April Dungannon fixture and taking the championship for the first time was Bertie and Greer Watson, Raffrey with Barnburn 1 Ulsterman. After spirited bidding it was knocked down for 5,600gns to join the line-up at AI Services. Born in September 2020, it was the first son for sale by herd sire Solpoll 1 Ringo. Its dam, Barnburn 1 Priscilla, stood reserve female champion at the 2018 Balmoral Show and is a Pinmoor 1 Kingsley daughter, a former Northern Ireland bull of the year, bred by Gary Hall, Merseyside.
Taking the reserve championship, as judged by Ben Sinnamon, was Solpoll 1 Valencia, an 18 month old Solpoll 1 Promoter son from John and William McMordie, Ballygowan.
A heifer’s calf, its dam Solpoll 1 Amber S3 was sired by previous UK bull of the year, Costhorpe 1 Granite. Backed with good figures for calving ease and eye muscle, it sold for 5,000gns to William Crea and son, Strangford.

Next in the money at 4,700gns was the 20 month old Glenmount 1 Van-the-man from Jim and Ann Henning, Mountnorris. Sired by Blakesley 1 Nathan and with a Fisher-bred dam, it sold to William Adams, Glarryford.

The Watsons also sold the youngest bull forward, the 15 month old Barnburn 1 Ultimate at 3,900gns. Again sired by Ringo, its dam was the Panmure 1 Henry daughter Barburn 1 Nolana. Second prize winner in the last class of the day, it sold to Lawrence Heslip, Ballygawley.
From Co Fermanagh-based Mervyn and Henry Richmond, Corraback Tom, a May 2020-born bull sold for 3,100gns. The young bull has been used in the Corraback herd and won its pre-sale show class. It was one of two Kye Rodge sons sold, going home with O Mitchell, Omagh.
Black Water Unique, one of two sons of stock bull Clondrina 1110th offered by Nigel Heatrick from Middletown sold at 3,100gns to C and J McAleer, Omagh. August 2020born, it is out of Black Water Locket, which is a daughter of Kye Sting 595.
Another Promoter son from the McMordies, the 20 month old Solpoll 1 Vicon sold to G McAdoo, Cookstown at 3,000gns and stood second place to the champion in the presale show. It is out of a Starlet female, sired by Moeskaer Upgrade.

The small offering of females topped at 2,600gns for the female champion Lisnaree 1 Tina Turner. Bred by Marcus Murdock, Newry it was a May 2020-born daughter of the home-bred Lisnaree 1 Romeo and sold in-calf to Dendor 1 Kohinoor to join Derek McCrea in Strabane.
Marcus Murdock also sold the March 2021born Lisnaree 1 Velvet Red. By two homebred parents, it is by Lisnaree 1 Samson and out of Lisnaree 1 Millie, by Dorepoll 1 60G Chinook and sold for 1,800gns to L Young, Magherafelt.

Auctioneers: Dungannon Farmers Mart Averages: 10 bulls, £3,707




A small entry of Herefords was present at the December native breeds sale held at Dungannon Farmers’ Mart where the champion in both sections also commanded the top prices.
Leading the prices at Dungannon's December sale was the two year old in-calf heifer from Andrew McMordie, Ballygowan with Solitude 1 Duchess V547. A daughter of Herberry 1 Herbert, it is by Panmure 1 Henry daughter and full sister to the UK sire of the year, Solpoll 1 Perfection. Due to calve in March, it sold for 3,500gns to M and L Armstrong to start a new herd in Ballyclare.
Topping the bull section was Solpoll
1 Voodoo, a 20 month old Herberry 1 Herbert son again out of a Panmure 1 Henry daughter, with full brothers having already led two previous Dungannon sales. A superior carcase sire, it was bred by John and William McMordie, Ballygowan and sold to Michael O’Brien, Poyntzpass for 3,400gns.
Taking the second top price in the bull section was the 21 month old Benburb
1 Vinny from Alan Shaw, Dungannon. Having stood second to the champion in the class, it sold for 2,900gns to Derek McCrea, Strabane. Sired by the Panmure 1 Henry, it is out a first calving Normanton 1 Laertes daughter.
Average: 2 heifers, 2,300gns; 3 bulls, £2,870
Auctioneer: Dungannon Farmers’ Mart

When a County Antrim dairy farmer held an on-farm dispersal sale back in the early seventies, one of those in attendance was a young man called Ivan Haire. As the sale got underway and the auctioneer started talking about the pedigrees of this cow and that cow, it got Ivan thinking about starting a hobby. Whereas many young men of his age were out playing golf or following the football of a weekend, these leisure pursuits did not hold much interest for Ivan. At that particular sale which took place at Ligoneil around 50 years ago, Ivan decided his new hobby was going to involve pedigree cattle.
Ivan grew up on Loughanhill Farm in the townland of Budore, Dundrod, County Antrim. His father, Robert, kept a commercial dairy herd of cross-breds before starting into pedigree Ayrshires.
When the time came to enter the world of work, Ivan started off his career in the Nuffield Tractor and New Holland dealership firm Stevenson’s of Lisburn. He says: “I remember going to Balmoral Shows during these days and helping set up the machinery display on Stevenson’s stand. Part of what I did at the show involved removing anything that could have been pinched off the tractors during the week. Knobs and such like were taken off and lynch pins were wired in.”
After spending some time with Stevenson’s, Ivan moved on to work in the stores of David Brown Tractors based on Belfast’s Antrim Road. But in 1970 Ivan’s career path took a change of direction when he entered the insurance industry. A couple or so years later Ivan returned to Ligoneil where, having watched and listened to the auctioneer, he decided his new hobby was going to involve the breeding of pedigree cattle.
It wasn’t too long after on Saturday 24 November 1973, that Ivan went to the dispersal of the Riverdale Hereford herd in Newcastle, County Down owned by David Deboys. One of the animals put forward was a seven year old cow named Riverdale Avril which Ivan purchased for 170 gns.
“It was money well spent,” he recalls. “I sold a bull off that cow at Balmoral for 770 guineas called Dorepoll 1 Mizer.”
By the time this bull was born Ivan, who had originally registered his Herefords under the prefix Loughanhill had made the decision to switch from horned Herefords to the poll strain of the breed. Taking the last four letters from his town Budore and adding them to the word poll, the Dorepoll herd was born.
At the RUAS Spring Show in 1974 Ivan purchased his first two poll Hereford heifers. Following the lifting of a ban on importing females from Great Britian, Ivan was able to develop the Dorepoll herd by purchasing a succession of cattle. On one occasion two poll Hereford heifers were secured at a
production sale, held in Crosthwaite, Cumbria in November 1982.
Most of the cattle at this special sale were from the Cumbria herd but were joined by several lots from guest consignor Harry Coates of the Costhorpe herd from Leicestershire. The sale was conducted by the official auctioneers to the North British Hereford Breeders’ Association, Wm. Bosomworth and sons and by the close of business, Ivan had purchased a female from each of the two herds and as another outcome, made a lifelong friend in Steve Edwards who was stockman for the Costhorpe herd.
The first of these two purchases was Cumbria 1 Reva secured at 2,000gns and the second, Costhorpe 1 Sunlight, cost 900gns. Both animals came to Ivan’s farm, via the ministry’s quarantine station at Tolan’s Point on the shores of Lough Neagh.
These cattle had been well bought.
Dorepoll First Lady, a daughter of Cumbria 1 Reva, would play an important role in promoting the Dorepoll herd in the showring during these early days. This female took a championship at Balmoral in 1986 as a yearling heifer before going on to even greater things.
Speaking about Dorepoll First Lady, Ivan says: “The organisers of Limerick Show wanted to have an all-Ireland championship in 1987 so you had to qualify at various shows. We qualified at Balmoral with this heifer and then took her to Limerick where it won the allIreland two year old heifer championship and was actually overall champion on the day.”
This was one of the early show ring successes and in the years that followed. Ivan and his family have won a great many prizes with their cattle. Back at the start, however, there was much to learn.
He says: “We were new to the game and really hadn’t much of a clue. We were on a steep learning curve, but it didn’t put us off. I suppose we had to start some place. Actually, some of the older, more experienced Hereford exhibitors were a big help.”
One of these more experienced
Hereford exhibitors who stood out in this respect for Ivan was a rather flamboyant and interesting character called Harry
Petticrew, who ran a pedigree herd at Ballymenoch, County Down.

“I got my first stock bull from Harry Petticrew, its name was Ballymenoch Diamond. Harry was really quite eccentric. At one time he’d have been seen smartly attired in tweed plus fours and the next he could be getting the cattle ready for the show ring with a black welly on one foot and a green one on the other. I remember Harry had a cow that kicked so when the time came for him to wash her, he had to use a deck scrubber on a long pole,” he says.
When Ivan purchased two new stock bulls in England he was accompanied by Harry Petticrew. The bulls were Ridgeway 1 Pall Mall of Canadian breeding and Windycote I Ringer of Australian blood and through their purchase Ivan wanted to widen the genetics in his herd.
He says: “There was a year of difference in the age of these animals, and we showed them at Balmoral in 1982. Ridgway 1 Pall Mall was made champion and Windycote 1 Ringer stood next to him as reserve.”
Over the decades Herefords from Dorepoll have won numerous prizes at all our provincial shows and beyond. Ivan exhibited an imported female, Mistress Tessak at the Scottish National Show and then, a bull called Dorepoll 1 Jonathan was made junior champion at the Royal Show at Stoneleigh. Semen from this bull was exported to Denmark, Germany and the south of Ireland as were straws from Dorepoll 1 Nationwide and Dorepoll 1 Headliner.
“Jonathan did a really good job for us and stayed a long time. He was getting on a bit, and we had used him a lot and had semen off him too,” recalls Ivan. “ I wanted to give him a good retirement and as it turned out there was a lady in Norfolk who wanted to buy him. This she did and the condition was that he’d get his day on the farm.”
In regards to females, one of the most renowned families is that of Duchess.
“We sold a heifer calf to the Gouldingpoll herd and this was one of their foundation females. That heifer went on to have a great career in the showring and was flushed for ET purposes. The Duchess family would now be a household female line in the Hereford breed,” says Ivan.
In 1985, Ivan took cattle to the Royal Highland Show.
“That was an experience” he recalls. “There were a lot of things to organise in transporting the cattle. We had to get the lorry packed to live and sleep in. We had to bring beds, a cooker, food and all that kind of stuff. The hard work paid off because we got supreme championship with our cow Onondaga Vanity. We had bought her at a dispersal in Yorkshire and she’d been imported as a live animal from Canada.”
Remitall Sally, a heifer he purchased, took reserve female championship at the Canadian National Show.
“We bought her with no intention of bringing her home but just wanted her for flushing. The breeders at Remitall kept her and got a calf out of her each
year for her keep. We had her embryos sent over and one of her offspring took the championship at the first Balmoral Show to be held at the Maze.”
Remitall Sally was bred by the Latimer family from Olds in the Western Canadian province of Alberta. If you reverse the letters of the name ‘Latimer’ and add an L one gets the word Remitall. The herd was massive and described by Ivan as being, at that time the Hereford herd of the world.


“I was out in Canada and at the home of the Remitall herd when I saw Keynote. It was in the early 2000s and I guess he would be the best Hereford bull that I’ve set eyes on. He was in a paddock and just was my idea of a beef animal having great structure combined with length. He had traditional Hereford markings, and this is something I consider to be important,” he says.
Over the years Ivan has judged cattle at agricultural shows throughout Ireland and on the other side of the Irish Sea in England and Scotland. But the first time Ivan pinned the judge’s badge to his lapel was at Enniscorthy in County Wexford.
“My first time judging was a bit nervewracking, but I suppose over the years I have got more used to it. The biggest show I’ve judged was the Royal Highland. I enjoy looking at cattle from a different perspective. When you’re looking at your own cattle all the time, you’re sometimes looking at them through rose-tinted glasses.
Ivan has served several terms as president of the Northern Ireland Hereford Breeders’ Association and was secretary for around two decades. The Haire family has hosted the annual barbecue on various occasions.
He says: “I suppose there’s not so many characters in the breed as there was when I came in. The old breeders really came alongside the younger ones and
gave both encouragement and advice. There were people like Harry Petticrew, Dick Adams, Sandy Burnett, Frank Gittoes, Trevor Simpson, Derek Vaughan and others. I remember Jack Morrison had a very successful show bull back in the early seventies called Ardmulhcan Coiner. Another person who was a great help to me was Sam McCully from Groomsport.”
After a lifetime of working with pedigree Hereford cattle, Ivan continues to have much confidence in the breed. He will cite its docility, beef of high quality and especially in these economic times, the fact that one doesn’t need to be going to a Hereford with bags of feed.
It has been a long and interesting journey since Ivan Haire of the Dorepoll herd embarked and with a great wealth of experience, Ivan still gets enthused about those calves being born in the Dorepoll herd and how, after all these years.
For any young breeder looking to start their own herd, Ivan advises: “It’s good to start off with an old cow, because there’s a reason she’s an old cow.”
Dorepoll has kept many influential siresIvan still has great enthusiam for the breed
At the Northern Irish National, Richmount 1 Treadstone from James Graham was promoted to supreme champion.
Armagh Show played host for the 2022 NI National Show where Carolyn Fletcher, Hereford Cattle Society president, was tasked with judging the largest section forward on the day.
Richmount 1 Treadstone from James Graham, Portadown was chosen by the Cumbria-based breeder as her supreme male champion, which began the day by heading-up the senior bull class. A son of the Australian Mawarra Mustang, this September 2019-born bull had previously stood reserve champion at Balmoral Show.
Young breeder Marcus Murdock from Newry lifted the female and reserve supreme championship with 2016-born Cornriggs 1 Vanity 2nd, bred by Harry and Janet Elliott, Durham. A daughter of Cornriggs 1 Super Guy and out of Cornriggs 1 Vanity, it was shown with its January-born Fisher 1 Profile daughter at-foot.

Lurgan-based Ciaran Kerr was the winner of the reserve male championship with the Irish-bred stock bull, Country Crest Jack. Sired by Moyclare Phoenix and out of Ballyaville Isa, it stood senior male champion at last year’s Northern Ireland calf show and a first prize winner at Balmoral Show.

was second in the cow class and was elevated to reserve female champion. Seven years old, it is out of Hilton 1 Deliah and by Richmount 1 Kaiser.
Success continued for Ciaran and his Kinnego herd as January 2021-born
Kinnego 1 Valentino took the junior male championship. Sired by the home-bred Kinnego 1 Rocket Man, its dam was Lusky

1 Hope. These two bulls from the Kinnego stable combined with herd mate Kinnego
1 Verity to win the group of three.
The junior female championship was won by Glenn and Tracey Morton, Armagh with the home-bred May 2021-born heifer, Nancy Fancy. A daughter of Pulham Providence, it is out of dam Glaslough Royal, bred by Nigel Heatrick, Co Armagh.
The exhibitor-bred heifer championship was won by the July 2020-born Glassdrummond Vicky from Alan Rea, Ballynahinch. A daughter of stock bull Magheraknock Matador, it is out of Glassdrummond Porche.




Finishing as reserve heifer champion, Magheraknock Daffodil T7 from David Smyth, Ballynahinch was the class winner in the senior heifers. A daughter

of Free Town Mentor and Rathregan Daffodil, David’s success didn’t end there when his February 2022-born Border Sentinal son, Magheraknock Winston, took the red ticket in the junior bull calf class.


Greer Watson, Raffrey won the calf championship with his December 2021born Barbern 1 Victor. A son of the 2022 NI sire of the year, Solpoll 1 Ringo, its dam is the home-bred Barnburn 1 Nolana.
Richmount 1 Mabel W2, the first calf born from Treadstone and out of Richmount 1 Mabel, was the winner of the youngest heifer calf class. Born in January 2022
it went on to finish reserve in the calf championship.
The pairs class was won by two young bulls sired by the home-bred Tullymore 1 Nixon from Raymond and Stuart Pogue, Benburb.

The final class of the day was the ever competitive young handlers competition. Taking the top place of senior and overall young handler was Nathanial Shaw, Dungannon and his closest competition came from his sister Keziah Shaw who took junior young and overall young handler.

The Northern Ireland Hereford Breeders’ Association presentation evening was held in Armagh in October 2022 and saw many members pick up awards.


Members of the Northern Ireland Hereford Breeders’ Association (NIHBA) along with families and friends gathered at the Armagh City Hotel on Friday 28 October to celebrate their annual awards evening which recognises the individual and collective winners throughout the show season.
After a fantastic meal which included Hereford Beef, the speaker for the evening David Wright, northern editor of the Irish Farmers Journal, thanked the NIHBA for inviting him, then went on to
give a brief outlook for farming in 2023, highlighting the potential opportunities and threats that may be around the corner going forward.
The presentation was led off by James Graham, Portadown who scooped both bull and poll bull of the year with Richmount 1 Treadstone and female and poll female of the year with Richmount 1 Mabel.
Treadstone also picked up the News Letter Rose Bowl, the Robert Clarke Cup and the Robert Haire Cup throughout the year. James was also presented with crystal to recognise his championships at Lurgan, Armagh and Saintfield.
Ivan Haire from Dundrod was triumphant at Balmoral with his young heifer Dorepoll 1 Sally 679 and with that he took home the Sydney Mawhinney Cup and The F W McMordie Cup as well as crystal recognising his supreme championship at the show.
The TT Simpson Cup for horned bull of the year went to Ciaran Kerr Lurgan for his young bull Country Crest Jack. Jack
also took the championship crystal at Clogher Valley Show and the accolade of reserve bull of the year.
Glenn and Tracey Morton, Armagh were also winners on the night picking up the Cuddy Cup for overall herd of the year.


The AS O’Connor Cup for their horned female of the year, Kye Lady, and the Baron Cup for the junior female at the National Show with the home-bred Nancy Fancy.
Marcus Murdock, Newry took the trophy for reserve female of the year for his cow Cornriggs 1 Vanity 2nd. Vanity had
picked up the championship win at Castlewellan in the summer.
Greer Watson from Crossgar had a good night picking up firstly the sire of the year award for stock bull Sollpoll 1 Ringo. Ringo’s progeny had been well sought after in the sale ring with Barnburn 1 Ulsterman picking up the Omagh Cup for champion at the spring sale. Another Ringo calf Barnburn 1 Victor picked up the calf champion at the National Show in Armagh.
Taking the Wenlock Cup for the January sale champion was the McMordie family,
Saintfield, with their young bull Riverdale 1 Valient.
Picking up the trophies for the Calf Show was David Wilson from Magheraveely whose young bull Lisrace Loneranger 6th took male champion. The female championship went to Robin Irvine Whitecross for Graceland 1 Verity.
Nathaniel Shaw of Sessiagh Herefords picked up the shield for best young handler at the National Show and his herd also took the Clow Cup for exhibitor-bred group of three at the same show.
Philip Murdock, Loughgall thoroughly enjoyed his debut year on the show circuit and lifted the Novice Award for the best newcomer.

Alan Rea from Ballynahinch took the Ralston Cup at the National Show with his best exhibitor-bred heifer Glassdrummond Vicky.
The Ulster Bank Rose bowl for best progeny pair was won by John and Karen Taggart Carrowdore for their Dorepoll 1 Prairie sired animals.
Picking up the other summer show championships was Stephen Cherry, Templepatrick for both Ballymena and Antrim with Ballypallady 1 Top Notch. Mervyn and Henry Richmond took the title at Omagh Show with Highhedges Synergist.
The NIHBA would look to thank all who took part in the various shows and sales throughout the year and congratulate all on their great representation of the Hereford breed.
The special 50 year anniversary Northern Ireland Hereford Breeders' Association calf show saw success for Lisrace and Annaghbeg Herefords.


Winning the male championship at the NIHBA calf show and taking home a special gold rosette to commemorate 50 years of the Northern Ireland Hereford Breeders Association was David Wilson, Magheraveely with Lisrace Lackey Boy 22nd, among a record entry of 57 calves.
A January-born son of Glaslough Unique 2 and out of the home-bred Lisrace Bridge Girl 19th, this bull calf was the winner of the largest class of the day with nine forward and also took the junior male championship.
It was encouraging to have a good gallery of spectators at the event with a number travelling from across the border to watch judge Robert Jones of Keenagh Herefords, Co. Longford. The event was also live streamed for the first time thanks to the Shaw Family at Agri Images enabling breeders across the country to watch the day’s proceedings.
The reserve junior male champion came from the same class for John and William McMordie, Ballygowan with Solpoll 1 Wildfire. A son of Otapawa Dr Jekyl, its dam was Balmoral Show champion in 2018.
The senior and reserve male champion also came from the same home and was another son of Dr Jekyl, the December
2021-born Solpoll 1 Wolfman while its dam had stood junior female champion at the 2016 calf show. Wolfman was also part of the wining pair of calves alongside herd mate Warrior.




The reserve senior male championship was secured by Dundrod-based breeder Ivan Haire with the Dorepoll 1 Nationwide son, Dorepoll 1 Westminster. Born in September 2021 it is full brother to one of the leading cows in the Dorepoll herd. Not ending the success, the Haire family also took the junior and reserve female championship with the Januaryborn Dorepoll 1 Classic Kim 687. Sired by Dorepoll 1 Chinook, its dam is by Dorepoll 1 Patriot.
Annaghbeg Georgina 957 gave Mark and Lawrence Moore, Aughnacloy their first calf show championship win placing first, senior then overall female champion. Born in December 2021 this heifer has a pedigree stacked with home-bred genetics being sired by Annaghbeg Gladiator and out the first calving heifer Annaghbeg Georgina.
Not finished there, the Moore family also lifted the reserve junior female award with their April-born Annaghbeg Georgia 965, the first daughter of Cill Cormaic Nevada born into the herd. An April-born Nevada son also won the March/April bull calf class with Annaghbeg 1 Kingsman taking the red rosette.
Trevor Andrews, Larne took the reserve senior female championship with Mountview 1 Loyalty. A daughter of stock bull Dorepoll 1 579 Legacy, it had earlier won the September/October class.
The baby heifer class was won by the June-born Nancy Vicky, sired by Laxfield Victory it was part of the herds competitions winning herd from Glenn and Tracey Morton, Armagh.






The baby bull class was won again by David Wilson with the recently purchased Mullaghdoo Winston, a May-born son of Balleen Wayfair.
The always competitive young handlers classes saw wins for Holly Taggart, Keziah Shaw and Ciara Fitlzpatrick, with Ciara winning the overall followed by Keziah in reserve.
The Northern Ireland Hereford Breeders Association would like to thank United Feeds for the continued support in sponsoring the event, the Wylie Family at Dungannon Mart, judge Robert Jones and all exhibitors for ensuring that the event was a huge success.

2022 Northern Ireland Hereford
Breeders’ Association
herds competition was won by Glenn and Tracey Morton and their Nancy herd.
The annual Northern Ireland Hereford Breeders’ Association (NIHBA) herds competition took place in the first week of September. With 24 herds entered it was a busy week for judges Bernard and Barbara Rimmer from Barbern Herefords, Lancashire.


The results were announced at the farm of 2022 NIHBA president David Smyth, of the Magheraknock herd based in Ballynahinch, Co Down who hosted an open night to view his herd and a barbecue.
A wet evening did not deter attendees from having a good time with all enjoying the fantastic food and entertainment provided.
The highly competitive medium herds section produced both the overall and reserve best herds. Taking the winning
spot was the Armagh-based Nancy herd of Glenn and Tracey Morton. Established in 2014 this was their first win in the herds competition and the judges commented they had a well-balanced herd with some very impressive two year old heifers.
Taking the reserve spot was John and Karen Taggart’s Carney Hill herd from Co Down. The judges were impressed with the cows and calves with the herds home-bred stock bull Carney Hill 1 Sexton also picking up the best stock bull award.
The small herd was won by Ciaran Kerr for the second year in succession. Based in Lugan the Kinnego herd also produced the best spring born heifer calf class winner with the April 2022-born Kinnego 1 Winter, sired by Richmount 1 Skyfall.



The large herd was also a repeat of last year with the Solpoll herd of John and William McMordie taking first place.
Alan Shaw of the Benburb herd won two calf sections. First up was the December 2021-born Benburb 1 Winnie. Winning the autumn-born heifer calf section and sired by Wirruna Lennon with the February 2022-born Moeskaer Waterloo son Benburb 1 Waterloo winning the best spring born bull calf class.
Mountview 1 Leonardo bred by Trevor Andrews, Larne won the autumn-born bull calf class with a September 2021 son of his stock bull Dorepoll 1 Legacy.
The NIHBA would like to thank Flynn and Co Solicitors for their continued support of the herds competition and to Dunbia Meats for supplying the meat for the barbecue. They also wish to thank the Smyth family for all the hard work that went into hosting a very successful night with all proceeds raised being donated to Macmillan Cancer Support.
Overall, G and T Morton, Nancy; reserve, J and K Taggart, Carney Hill
Small herd, 1st, C Kerr, Kinnego; 2nd, JE, RI and W Haire, Dorepoll; 3rd, A Rea, Glassdrummond
Medium herd, 1st, G and T Morton, Nancy; 2nd, J and K Taggart; 3rd, R and J Irvine
Large herd, 1st, J and W McMordie, Solpoll; 2nd, D Wilson, Lisrace; 3rd, D Smyth, Magheraknock
Autumn bull calf, 1st, Mountview 1 Leonardo, T Andrews; 2nd, Dorepoll 1 Westminster, JE, RI and W Haire; 3rd, Solpoll 1 Wexford, J and W McMordie
Autumn heifer calf, 1st, Benburb 1 Winnie, A Shaw; 2nd, Glenmount 1 Willow, J Henning; 3rd, Mountview 1 Loyalty, T Andrews
Spring bull calf, 1st, Benburb 1 Waterloo, A Shaw; 2nd, Annaghbeg Koala, M and L Moore; 3rd, Carney Hill 1 Winter, J and K Taggart
Spring heifer calf, 1st, Kinnego 1 Winter,C Kerr; 2nd, Nancy Gina, G and T Morton; 3rd, Lisrace Bridge Girl, D Wilson
Stock bull, 1st, Carney Hill 1 Sexton, J and K Taggart; 2nd, Blakesley 1 Nobility, R and J Irvine; 3rd, Richmount 1 Skyfall, J Graham

Hereford cattle numbers in Northern Ireland continue to increase. This trend is reflected in the quantity of Hereford straws sold by the province’s cattle breeding businesses and the number of pedigree breeders now on the ground. Significantly, AI Hereford usage is in equal demand across both the dairy and suckler sectors. Moreover, breeding companies, including AI Services (Northern Ireland), are keen to source the Hereford genetics they need from local breeders.
Driving the demand for Hereford bloodlines in Northern Ireland is the growing recognition that the breed ticks every box when it comes to producing beef of the highest quality in the most efficient way possible.

Robbie Wilson farms at Magheraveely in Co Fermanagh at 21 years of age, with the farm extending to 67 hectares (165 acres). His fast developing business comprises a 40-strong herd of suckler cows, a dairy calf to beef enterprise and a 50-strong flock of breeding sheep, with lambs taken through to finishing. He also finishes 100 ‘feeding ewes’ over a 12-month period.
The farm is laid out entirely in grass. Optimal use is made of the available grazing and silage areas. Robbie has succeeded in making four cuts of silage in each of the past two years.
“The plan is to increase the suckler numbers up to 60 cows,” Robbie explains. “The development policy for the herd is centred on a three-way breed combination in equal measure: Limousin, Simmental and Hereford.
“The Limousin delivers excellent conformation, the Simmental has excellent milk production potential while the Hereford guarantees the best possible growth rates from grass and silage.”
Co Fermanagh’s Robbie Wilson uses a fusion of beef breeds to create his perfect suckler cow, with the Hereford playing a key role.
He continues: “The beef industry has been told that it must secure higher levels of efficiency in order to lower its overall carbon footprint. The Hereford will play a critical role in making this happen. And increasing numbers of commercial beef finishers are already recognising this fact.”

In his own case Robbie finishes all the male calves born on the farm as steers. He is currently bringing many of these animals through to 380kg plus finishing weights at around 27 months of age.
“The heifer calves make perfect suckler replacements,” Robbie comments. “Those which I don’t need for my own use will be sold bulling or as springers. Demand for this type of animal is already very strong. Their uniform, roan colour makes them stand out as an animal with real breeding quality.”
Further evidence of the growing recognition that Hereford-bred cattle are now receiving in Northern Ireland came courtesy of this year’s Fermanagh County Show.
A feature of the day was the success of the newly catalogued ‘non-pedigree suckler cow classic’ and ‘breeding heifer derby’ classes.
Robbie secured a very praise worthy second place in the heifer class with a Salers-cross heifer, bred from a pedigree Hereford cow.
He says: “The heifer was 16 months-old on the day of the show. She is due to calve next February and is a tremendous
example of the quality that Hereford genetics can offer the beef sector as a whole.”
For the record, Robbie’s father David of Lisrace Herefords was placed third in the non-pedigree suckler cow class. A pedigree Hereford breeder of note in his own right, he is also committed to working with a mix of Hereford, Simmental and Limousin bloodlines, in order to breed a very sustainable suckler cow.
Robbie is quick to confirm the availability of the Hereford price bonus by all the meat plants in Northern Ireland
is helping to boost the interest in the cattle at farm levels.
He explains: “The current bonus is allowing finishers with Hereford cattle to secure competitive returns, but the bottom line is that the scope to put more Herefords through the various bonus schemes is significant.”
Meanwhile, the rate of change within Northern Ireland’s pedigree Hereford sector continues apace. Back in 1996, the province was home to 30 active breeders. Today, that figure has grown to approximately 200.

Moreover, the prices paid for pedigree Hereford stock has also increased significantly. The top prices paid for Hereford bulls 30 years ago averaged 1,200gns. Today that figure has risen to some 5,000gns.
Meanwhile, Northern Ireland’s farm minister Edwin Poots has made it very clear he wants to see a ‘genetic revolution’ taking place within the beef sector.
He put breeding the right type of animal at the base of a pyramid that will allow farmers to drive sustainability within their businesses. This means calving suckler heifers down at 24 months of age, ensuring that a suckler animal will calve every 12 months and that finished cattle will be brought to slaughter weights at 24 months of age.
And all of this improvement will be secured on the back of improved grassland management practices. Robbie is in no doubt that Hereford breeding stock will help make all of this happen.
He explains: “Key to the breed is the tremendous selection of bloodlines within it. As a result, there are breeding bulls available that can meet the needs of dairy and suckler farmers in equal measure.
“But the over-riding advantage of the breed is the ability of cattle to finish off grass at an early age plus the superb quality of the beef they produce.”
Robbie’s priority right now is to build a sustainable future for himself from a career in farming.
He says: “Making best use of grass, both from a grazing and silage perspective will be critical in this regard.
“The availability of good housing facilities for stock is also important. And, in this regard, I am well resourced. The farm has an excellent cubicle house for the cows and good quality additional housing for the young stock and finishing animals. The two silos available to me are also in excellent condition.”
Robbie makes four cuts of silage each year, mostly as bales, with all grass wilted for 24 hours after cutting.
The commitment to cut grass on such a regular basis is paying dividends in terms of the silage quality available throughout the winter months.
He comments: “We can do most of the work ourselves: a local contractor undertakes the baling and wrapping.”
The quality of Robbie’s bales silage speaks for itself. His cutting dates this year were: 14 May; 06 July; 24 August and 29 September. Last year he consistently produced silage with a D Value of 76; an ME of 12.16 and a DMD value of 21.7.
“The pay-off in cutting grass consistently at that optimal growth stage is the securing of improved growth rates from young stock and a lesser reliance on concentrates when it comes to
finishing cattle,” says Robbie.
While Robbie is always keen to look forward, sometimes there is a dividend to be gained from looking back in time. Possibly the best bull ever bred by David Wilson was the exceptional sire Lisrace Lifeliner. It was the Balmoral 2000 Hereford champion and semen from the bull has been used widely throughout the UK and Ireland over many years.
Robbie says: “We kept 400 straws from the bull for our own use here at home. I am using some of these on my own suckler cows at the present time.
“Lifeliner was a tremendous bull. And his quality is evident, even today. His progeny have tremendous scope and his daughters make excellent suckler cows.”
He concludes: “The Hereford breed has a lot to offer the beef industry in Northern Ireland. And the scope to increase numbers is significant.
“Years ago, Hereford-cross cattle were the backbone of the Irish beef industry. The cattle are unique in achieving very high daily growth rates while also producing beef of an exceptional quality.

“Adding to all of this is the fact that Northern Ireland is home to many excellent pedigree Hereford herds at the present time.”

1. W Andrew
ARRANVIEW (P&H)
Oaklea, Auchincruive, Ayr KA6 5HS
Tel: 01292 521067 Mob: 07785 721330
2. PM & NJ Brown
BOSOLOPOLL
Clachaig, Kilmory, Isle of Arran KA27 8PG
Mob 07703 323 526
Email:dbrown1820@aol.com
3. J A Cameron & Son
BALDINNIE (P)
Balbuthie, Kilconquhar, Leven, Fife KY9 1EX
Tel: 01333 730210
Email: j.cameron@farming.co.uk
Web: www.baldinnieherefords.co.uk
4. J M Cant & Partners
PANMURE (P)
Easter Knox, Arbirlot, Arbroath, Angus
DD11 2PZ
Tel: 01241 871660 Mob: 07974 705430
Email: easterknox@btinternet.com
5. G and M Dunbar
DRUMBOY (P)
Springholm, Drumclog, Strathaven, Lanarkshire
Tel: 01357 440544
Gavin Dunbar: 07892715465
6. Rockness Livestock
Peter Eccles - ROCKNESS (P)
Carlaverock Farm, Tranent, East Lothian
Tel: 01875 610266 Mob: 07503 925917
Email: rocknessherefords@icloud.com
7. M Galbraith
CRAIGDHU (P)
Millmoor Farm, Sandilands, Lanark ML11 9TW
Mob: 07706 237524
Email: margaret.stewart123@btinternet.com
8. G & S Harvey
HARVEYBROS (P)
100 Buchanan Street Balfron, Glasgow G63 0TQ
Tel: 01360 440504 George: 07810 807824
Sophie: 079 844 52306
Email: george-harveybros@outlook.com
9. J O Hodge
FELLOWHILLS (P)
Horndean, Berwick-Upon-Tweed TD15 1XN
Tel: 01289 3826678 Mob: 07967 643129
10. Janice Laird
ST. CLEMENTS WELLS (P)
St Clements Wells Farm, Wallyford ,East Lothian
EH21 8QN
Tel: 01316 692584 Mob: 07850 226994
11. Kenny Lang WELLHEAD
Wellhead Farm, Cleghorn, Lanark
ML11 7SW
Tel: 01555 870 223 Mob: 07843 605 861 Email: a-lang@btconnect.com
12. Mr James Logan GALAWATER
Pirntaton, Stow, Galashiels TD1 2TH Email: jim@pirntaton.co.uk Mobile: 07771 526936
13. David Morrison
North Falaknowe, Coldingham, Eyemouth
TD14 5TZ
Tel: 01361 840 257 Mob: 07766 406 042 Email: david@jamesbrownandco.com
14. F B Sangster
BADENKEP (H) & FS (P)
Badenkep Farm, Buchlyvie, Stirling FK8 3NT Tel: 01360 850531 Mob: 07979 093031
15. Ian Skea
BENNACHIE (P)
Glenbervie, Dalriach, Kemnay, Inverurie
Aberdeenshire AB51 5LP Mob: 07506 157 480
Anyone will always be welcome
16. D & S Smith & Son
MILOVAIG (P) & TOROVAIG (H)
Ballochneil Cottage, Turnberry, Ayrshire KA26 9NE
Tel: 01655 331796 Mob: 07710 570944 calum@arn-ltd.com
17. C Smith & A Wilson MILOVAIG (P)
The Workshop, Wester Cairnglass, Ardersier, Inverness IV2 7QS Calum: 07538083338 Anna: 07837199603 calum.smith0792@gmail.com
18. Andrew & Serena Sykes
KILEEKIE (Traditional Horned)
Kileekie, Crosshill, Maybole, Ayrshire KA19 7PY
Tel: 01655 740510 Mob: 07798 622879
Email: andrew_sykes@msn.com
Web: www.kileekie.co.uk
19. Molly Stuart GLENLIVET
Lettoch Farm, Braes of Glenlivet, Ballindalloch Banffshire AB37 9JQ
Tel: 01807 590 242 Email: kelly.lettoch@ gmail.com
20. J B Torrance
KNOWETOP (P)
Knowetop Farm, Quarter, Hamilton ML3 7XQ
Tel: 01698 284268 Mob: 07957 149943
21. W, P & K Wason SALTIRE (P)
Redwells Farm, Kinglassie, Lochgelly, Fife KY5 0UD
Tel: 01592 881740 Mob: 07779 591447
Email: saltireherefords@btinternet.com
22. Mr Iain Wilkinson REDSTROKE
Balgay Farm House, Inchture, Perth. PH14 9QH, Mobile:07740505374 iain.wilk10@gmail.com
23. J R B Wilson & Sons ROMANY (P)
Cowbog, Kelso, Borders TD5 8EH
Tel: 01573 440273 / 01573 440278
Mob: 07980 253496 Email: cowbog@aol.com
Web: www.romanyherefords.co.uk
24. Harrison & Hetherington Ltd
Auctioneers Borderway Mart
Rosehill, Carlisle, Cumbria CA1 2RS
Email: Heather.P@borderway.com
Tel: 01228 640924 Mob: 07714 761311
Web: www.harrisonandhetherington.co.uk
Give a Ring, send an Email, tell us which Airport, Station or Ferry -- we’ll be there!
CHAIRMAN: George Harvey, 100 Buchanan Street, Balfron, Glasgow, G63 0TQ Tel: 01360 440504 Mob: 07810 807824 Email: george-harveybros@outlook.com
SECRETARY: Margaret Galbraith, Millmoor Farm, Sandilands, Lanark ML11 9TW Mob: 07706 237524 Email: margaret.stewart123@btinternet.com
“HEALTHY CATTLE IN REAL CATTLE COUNTRY”
Stranraer. For many, it was the highlight of the year. The event was well attended and the association visited three very different farms.
Well, what a difference a year makes. This year the Scottish Hereford Breeders Association has certainly been out and about so much more. In Scotland it was a slow start for local agriculture shows with cattle numbers down but show attendances up. As the year progressed, cattle numbers rose, as did the standard of Herefords being shown around the country.
There are now two official Hereford sales at United Auctions in Stirling in autumn and spring.
June saw the Royal Highland Show return to Ingleston with the champion tapped out as Spartan 1 Typhoon. Many people visited the breed stand and it was great to catch up with Hereford breeders and encourage others to consider the Hereford when picking a stock bull for commercial or dairy herds.
This year the National Show was held at the Black Isle Show, which is a brilliantly run show and well worth a visit. Judging this year was Robert Grierson from Dalbeattie and he found his supreme winner in the form of Studdolph 1 Barbie 754 from Calum Smith and Anna Wilson with the reserve supreme going to Harveybros 1 Va Va Voom by George and Sophie Harvey.
This year the association arranged a west of Scotland farm visit weekend to
The first visit was to Robert Parker of Drumdow Farms. Robert gave a fantastic tour of his farm stopping to show visitors his stock and explaining his methods used to produce the most outstanding Black Baldies. His best bit of advice was to ‘keep it simple’. His rotational grazing, breeding regime, out-wintering of cows and feeding of young stock were explained thoroughly and executed to the highest of standards. All of his Hereford bulls were purchased from his neighbour John Douglas which he favoured for their growth and vigour. That night members stayed in Stranraer
and had tea and a good catch up with the odd dram to keep the banter going. The following morning the weather was again kind to the trip which headed off to John Douglas at Mains of Airies. Here, members were met by John and two of his daughters who again spent time with showing the association around their stock. The views were outstanding as he took members around his farm. John breeds Aberdeen Angus as well as his very large herd of Herefords. John splits his herd into tribes and rotates his bulls every year. He has worked with American line one genetics for many years now. His stock is sold on farm and online and are renowned for having very good growth rates and for being ‘unpampered’. The set-up is quite amazing and a visit at

Scottish Hereford Breeders’ Association continues to go from strength to strength and this year members enjoyed a weekend of herd visits in the Stranraer area.Robert Parker was visited on the association's weekend trip
sale time is recommended.
Lastly but by no means least members headed to Andrew and Serena Sykes at Kileekie. They have a herd of Traditional Herefords. The Traditional Hereford is smaller in height but do not be fooled by that as the depth and width of these animals are quite something. They are grass fed and extremely good natured. A big concern to Andrew and Serena is the gene pool getting smaller and lines becoming extinct.
The autumn show and sale went well for the Scottish contingency with March 2021-born Harveybros 1 Va-Va-Voom from breeders George and Sophie Harvey and selling to a call of 5,500gns and at 4,000gns was Panmure 1 Plum V5 from JM Cant and partners.
At Livescot 2022, held at Lanark Market, the champion Hereford was Craigdhu 1 Will-It-Do from Margaret Galbraith, Sandilands, Lanarkshire.

Lastly, SHBA would like to thank the Hereford Cattle Society for all its help throughout the year.
There were 17 entries for this year’s herd competition, well judged by Colin and Isla Soutter.
Overall winner, Jimmy and Fiona Hodge, Fellowhills
Large herd, Jimmy and Fiona Hodge, Fellowhills.
Small herd, JM Cant and partners, Panmure Herefords

Best heifer calf, Glenlivet 1 Heidi, Molly Stuart
Bull calf, Panmure 1 Wilbur, JM Cant and partners
Stock bull, Baldinnie 1 Romeo, JA Cameron and son







As the Royal Highland Show returned to Ingleston, Spartan 1 Typhoon impressed the judge and spectators.
Proving the long journey worthwhile from Oxfordshire to the Royal Highland was Spartan 1 Typhoon from SC and GL Hartwright which stood supreme and performance recorded interbreed champion, having already had a fruitful show season.
By the 8,000gns Solpoll 1 Perfection which had great success in the show ring, it is out of Panmure 1 Plum K19, a line which has consistently performed for Scottish breeders JM Cant and partners.

The most successful home-bred to come out of the Spartan stable, the Hartwrights have had some great achievements in recent times with stockman Luke Murphy on the halter, including winning the supreme championship at the Christmas calf show in 2021. This two year old bull had show wins last year, winning its class at the Great Yorkshire and Shropshire County, while this year it has placed reserve male champion at Royal Lancs, reserve champion at Stafford and supreme at Shropshire County.
Tasked with judging was AberdeenAngus breeder Willie McLaren who said Typhoon had a real presence in the ring, being ‘so correct, with great feet, body mass and spring of rib’. Willie said he

was just the type of animal the breed requires.
In the reserve position was Gouldingpoll 1 Duchess 916, owned by Heather Whittaker, Halifax, Yorkshire and bred by Ireland’s Matthew Goulding, having been purchased for 6,000gns at the Goulding Opportunity sale in 2019. Born in March 2018, its sire line goes back to Canada’s Remitall herd while its dam is another member of Gouldingpoll’s Duchess line. The female was shown with its second calf, Coley 1 Duchess 609, at-foot.
Willie commented he judged Duchess and calf as a unit, stating the female would wean the calf at 50 per cent of its body weight while carrying a ‘lovely udder’.
Taking the junior championship and the reserve grand female title was Milovaig
1 Lady Anna from Calum Smith and Anna Wilson, Inverness. By Shraden 1 Perestroika, a grand sire of SMH Euro 30E, it is out of a Fisher 1 Ensign E254 daughter. This March 2021 born female also stood best Scottish-bred exhibit within the Hereford section.



Reserve grand male and junior male champion was Moralee 1 Vermouth RK V22 from T and D Harrison, Mickley, Northumberland. A son of Moralee 1 Rebel Kicks KS R12, it is out of Richmount 1 Katie-Perry, bred by James Graham, Portadown, Co Armagh.
Standing reserve in the junior male championship was Dendor 1 Vodka from Bethan Hutchinson, Billingham,

Co Durham. Sired by Gouldingpoll 1 Moonshine, the 2018 Royal Welsh Show champion, it is out of Dendor 1 Wattle 9th which is a daughter of Bakgard 1 Keno daughter, the 2017 Royal Welsh champion.
The September 2020 to February 2021 class saw success for Spartan 1 Victoria’s Secret which had also travelled north with the Hartwrights. Another by Perfection, this September 2020 born female is out of Cleland 1 Glissade 26th.
Another from the Spartan herd, this time Spartan 1 Duchess T95 led the September 2019 to August 2020 born class. Also by Perfection, it is out of Ruckmans 1 Orange 1332.
Coley 1 Vincent came to the fore in
the September 2020 to February 2021 bull class. Now 21 months old, it stood reserve supreme at the 2021 Great Yorkshire Show. An embryo calf, it is by Fabb 1 Northern Star and out of Gouldingpoll 1 Duchess 591.
Moralee 1 Roland Rat KS R16, owned and shown by JA Cameron and son, Kilconquhar, Fife, took the red ticket in the senior bull class. Employed as stock bull at Baldinnie Herefords, it is a son of SMH King Size 87K, the 2019 UK sire of the year. Not a stranger to success at Ingleston, Roland Rat stood next to Moralee 1 Rebel Kicks KS R12 as reserve champion native pair in the Royal Highland Showcase in 2021.


Continuing last year’s success in the pairs class, Harrisons came to the fore once again, this time with Moralee 1 Pippa RK V21 and Moralee 1 Pippa RK V33, two full sisters by Rebel Kicks and out of Coley 1 Pippa 356.


On his debut into the sale ring with a Hereford, Dumfriesshire-based Ewan Burgess topped the trade at Stirling at 6,200gns in February.


Returning to the ring at Stirling in February after a number of years, the Hereford section saw six bulls selling to an average of £4,322.50, clearing at 86 per cent, with just one animal not finding a home.
The top call of the day at 6,200gns was made for Criffel 1 Thor from Ewan Burgess, New Abbey, Dumfriesshire which also stood champion in the presale show judged by Liam Muir, Orkney. May 2020-born, it is by Australian AI sire Wirruna Katnook K74 and out of Moorside 1 Jane 8th which was purchased at the 2018 Designer Genes sale for 4,000gns, being a Romany 1 Lawbreaker daughter. The first bull to be sold at public auction from the new breeder, it travels to Perthshire with a great set of figures to Iain Wilkinson of Redstroke Herefords to be used on both commercial and pedigree females. With bidders and the judge in agreement, the reserve champion was next in the money. Baldinnie 1 Digger from JA Cameron and son, Balbuthie, Fife realised 4,500gns, selling to E Innes and sons, Glenlivet, Moray. March 2020born, it is by stock bull Solpoll 1 National, a son of Solpoll 1 Dynamite and out of Baldinnie 1 Dom Lass 21st.
Saltire 1 Vinnie from Willie and Pauline Wason, Kinglassie, Fife realised 4,000gns, purchased by the Roberts family, Dunfermline, Fife. Having been
seen out on the calf show circuit last year, it stood reserve senior and senior male champion at Stars of the Future and reserve senior male champion at Agri Expo. A Normaton 1 Laertes son, it is out of Baldinnie 1 Cathy 40th and sold at 16 months of age.

Also changing hands at 4,000gns was Harveybros 1 Vuitton from Balfron-based father and daughter team, George and Sophie Harvey. Born in December 2020, it is by Wirruna Matty M288 and from the family’s renowned Crocus line. It sold to Dougie Hogarth, Saltcoats, Ayrshire to use on his herd of Montbeliardes.
Travelling with its stablemate to the same home and selling at 3,500gns was Harveybros 1 Valentino, another Matty son. Going through the ring at 16 months of age, its dam is a Laertes daughter.
First bull sold was another from JA Cameron and son, Baldinnie 1 Rebel, which was purchased by the Scottish Government for use in its Crofting Cattle Improvement Scheme as bull hire for 2,500gns. Born in March 2020, it is again a son of Solpoll 1 National.
Two heifers were forward in the female section, both from JA Cameron and son. Baldinnie 1 Dainty 8th by Wirruna Justin J13 sold at 1,800gns while herd mate Baldinnie 1 Ruth 60th, a Cornriggs 1 Knight Rider daughter sold for 2,400gns.
Both were purchased by JJ Patterson, Oxton, Scottish Borders.
Auctioneers: United Auctions
Averages: 6 bulls, £4,322.50; two females, £2,205

Harveybros 1 Versace from G and S Harvey, Balfron, Glasgow sold for a top call of 4,200gns at Stirling’s May bull sale, going home with commercial men, Robert Simpson and son, Crieff, Perth and Kinross.
Sold at 15 months of age, it is a son of the Australian sire Wirruna Matty M288 and out of Harveybros 1 Crocus S2 from the only female line the Harveys keep, which has performed so well for the breeders over the years. This female is sired by Normanton 1 Laertes, the 2016 Royal Highland and Royal Welsh interbreed champions.
Auctioneers: United Auctions
Average: 1 bull, £4,410
Black Isle Show hosted the Scottish National in 2022 where Calum Smith and Anna Wilson’s Studdolph 1 Barbie 754 strode into the supreme spot.


Staged at Black Isle Show, the Scottish National Show saw Studdolph 1 Barbie 754 from Calum Smith and Anna Wilson, Adersier, Inverness move to the fore, as directed by judge Robert Grierson, Dalbeattie, winning supreme, female and senior female champion. Having started its life in Pembrokeshire with breeders TG, EI and EN Thorne, this heifer was purchased privately by the young couple in October 2020 as a six month calf to join their 25 female Milovaig herd. By stock bull Lowesmoor 1 Nasser, it is out of a Studdolph-bred female, and stood reserve supreme champion at last year’s National Poll Show.
In reserve supreme, male and junior male champion was Harveybros 1 VaVa-Voom from Balfron’s George and Sophie Harvey, having also stood reserve supreme and junior champion at the Great Yorkshire and junior male and reserve male at the Royal Welsh. Born in March 2021, it is by Normanton 1 Laertes and out of Harveybros 1 Crocus E2 from the only female line at the Harvey’s stable, which goes back to Panmure’s Crocus family.
Joining its stablemate to stand reserve in the female championship was
Milovaig 1 Lady Anna, another from Calum Smith and Anna Wilson, also taking junior female champion and reserve female championships. By Shraden 1 Perestroika, a grand sire of SMH Euro 30E, it is out of a Fisher 1 Ensign E254 daughter and was reserve female and junior champion at the Royal Highland.
Reserve male and senior male champion was selected as Bennachie 1 Vinny from Ian Skea, Dalriach, Aberdeenshire. January 2021-born, it is by two homebred parents and also stood senior male champion.




Reserve junior male champion was Milovaig 1 Vindicator, again for Calum Smith and Anna Wilson. Born in May 2021, it is by Shraden 1 Perestroika and out of Milovaig 1 Bonnie Belle 9th.
Reserve junior female champion was Craigdhu 1 Morag Una from Scottish Hereford Breeders Association secretary Margaret Galbraith, Sandilands, Lanarkshire. A daughter of AI sire Kinglee 1 Hero, it is out of a home-bred Normaton 1 Laertes daughter, bred from the Jane family at Romany.
Harveybros 1 Crocus Tiara from George and Sophie Harvey took the reserve senior female championship. By Normanton 1 Laertes which has served the Harveybros herd well, its homebred dam is a Venture Night Time 7055 daughter.
Elsewhere in the classes, Jimmy Hodge, Berwickshire took the red ticket in the junior heifer class with September 2021born Fellowhills 1 FR Dawn. A son of AI sire Fabb 1 Royce, it is out of Romany 1
Dawn K956 P54, which itself is sired by Fardre 1 HI Hidalgo K956.
Fifth-calver Harveybros 1 Crocus N1 from George and Sophie Harvey led the senior cow class, with its Marchborn Wirruna Matty M288 sired bull

calf at-foot. With the Harveys out in force for the National Show, the family took the best group of three as well as the pair.
The bull born on or after August 2021 class was led by Ian Skea’s Bennachie


1 Wizard. August 2021-born, it is by Solpoll 1 Lawman and out of Bennachie 1 Pansy 4th, bred from the Pansy line at Auckvale.
Jimmy Hodge of Fellowhills Herefords won the progeny group of three.
travelled to Maines of Airies once again to secure Ervie bulls for both pedigree and commercial use.
C and D Auctions conducted the annual spring live and online bidding sale of Hereford and Aberdeen Angus bulls at Mains of Airies, Kirkcolm, Stranraer on behalf of John Douglas and family.
A grand crop of 38 rising two year old, naturally shown, unpampered bulls was presented to a large crowd of both local and distant buyers who travelled to the far south west of Scotland along with online bidders. With 11 bulls sold online and a 100 per cent clearance, the sale averaged £2,852.
Ervie Advance 202699 topped the Herefords at £5,000. Much admired from the Lisette family, and sired by imported herd sire, Ervie RL1 Achiever 151966N, it was purchased by longterm repeat customer, Robert Parker, Stranraer, Wigtownshire.


The sum of £4,600 was paid for Ervie Advance 202726. Another from the Lisette family, and again sired by 151966N, this young bull was purchased by another Wigtownshire-based Black Baldie breeder and repeat buyer, G McKie and co, Wigtown, Wigtownshire.
Ervie Advance 202776 from the Crocus family sold at £3,600 to yet another repeat buyer, DT Lang and son, Wellhead, Lanarkshire for commercial and pedigree breeding.
Ervie Advance 202868 was knocked down at £3,400 in a joint purchase to RT Davies and co of Westwood
Herefords and W Chase, both based in Herefordshire.
Volume buyer for bulls to use on their dairy herd was another repeat buyer, James and Becky Ward, Stranraer, buying five Hereford bulls for an average of £2,200. Scott Shearlaw, Maybole,
South Ayrshire bid online to a top price of £3,400 and secured four good Hereford bulls to average £2,825.
Auctioneer: C and D Auctions
Average: 33 Hereford bulls, £2,709
Making it a hat-trick of Agri Expo supreme championship wins for Halifax-based Heather Whittaker, Coley 1 Duchess 609 was selected by Northern Ireland’s William McMordie as champion at the Scottish and North of England Hereford Breeders Associations calf show.


The current reserve poll female of the year, this September 2021-born heifer has already stood reserve grand female and overall junior champion at the National Poll Show and won its junior heifer class at the Great Yorkshire this year. Having started the 2022 show season at the foot of its mother Gouldingpoll 1 Duchess 916, the outfit took the reserve supreme title at this summer’s Royal Highland Show.
Speaking of his champion, William described Duchess as a ‘big well grown’ heifer and said it was ‘good and wide all down her back through her rib and loin while still being very feminine’.
Having followed the champion all the way through from its heifer class and then the female and supreme championship was Porton House 1 Amethyst 2nd from Paul and Vicky Moyle, Newport, Gwent which stood reserve supreme champion. By former stock bull Panmure 1 Nugget, it is out of Ashley Moor 1 Amethyst 33rd, making it a maternal sister to the Moyles’ 2021 Designer Genes offering which sold for 3,600gns.
William explained this Porton House heifer stood ‘very close to the champion’, stating it was ‘probably more powerful but just not as sweet’.
There was further success for Heather Whittaker in the junior female championship as January 2022-born Coley 1 Mink 634 came out on top. A daughter of Gouldingpoll 1 Stockman, it
is out of Frenchstone P. 1 Eve which was sired by Solpoll 1 Dynamite.
Reserve to the Coley heifer was Dendor
1 Anna Mary 44th from DE, ED and AL Jones. March 2022 born, this heifer is out of a Maxstoke 1 Yeoman daughter and by Dendor 1 Trigger, a Romany 1 Distiller son.
In the bulls, the male championship was handed to March 2022-born Harveybros
1 Willy-The-Womanizer from Glasgowbased George and Sophie Harvey. By Australian-bred AI sire Wirruna Matty M288, it is out of a Venture Night Time 7055 daughter from the Harvey’s famed Crocus line. This young bull was also named junior male champion.




Having made the trip north from Caersws, Powys, DE, ED and AL Jones occupied the reserve male champion position with Dendor 1 Wilson, a September 2021-born bull. By 2018 Royal Welsh Show champion Gouldingpoll 1 Moonshine, it is out of Dendor 1 Wattle 6th which is by Solpoll 1 Gilbert, the three times UK sire of the year.
Reserve junior male champion went to first-time exhibitor and Scottish Hereford Breeders Association secretary, Margaret Galbraith, Sandilands, Lanarkshire with Craigdhu Will-It-Do. Another by Gouldingpoll 1 Stockman, it is out of home-bred female Craigdhu 1 Morag, a Laertes daughter, with Romany breeding on its female side which was selected as reserve female champion in the 2020 Scottish Hereford Breeders Association virtual show.
TD and WT Livesey, Ashby-de-la-Zouch, Leicestershire were responsible for the reserve senior male with Normanton 1 Winterwonderland W372. It is by Panmure 1 Pudding which was purchased at the 2018 autumn show and sale for 4,000gns and has performed well for the herd while employed as stock bull, including siring the 4,800gns Normanton 1 Fistulina 35th V569.


Elsewhere in the classes, Panmure 1 Plum W4 from JM Cant and partners, Arbirlot, Angus took the red ticket in the November to December 2021 heifer class. By Romany 1 Thor, a son of Fabb 1 Rocco, it is out of a Romany 1 Distiller sired home-bred female.

SC and GL Hartwright, Abingdon, Oxfordshire, the operators of the current show herd of the year, saw success continue in winning the October 2021 heifer class with Spartan 1 Oyster Gem SP166. By the UK sire of the year Solpoll 1 Perfection, it is out of Cleland 1 Oyster Gem 50th.
JM Cant and partners also led the November to December bull class with Panmure 1 Womble. Another by Romany 1 Thor, it is out of a home-bred Dendor 1 Leota sired female. Headed by Audrey Anderson, these breeders won both the pairs and the group of three classes. The young handlers classes were once again well supported. In the junior section, 14 year old Maisie Beresford, associated with Moralee Herefords, won the class. Will Awan, 21 year old owner of Midford Herefords near Bath, took the red ticket in the senior section.

At the annual Stars of the Future Calf Show JM Cant and partners’ Panmure herd took the honours in the senior section.
Panmure heifers commanded the senior section of the Stars of the Future Calf Show, hosted by United Auctions, Stirling. Senior champion was December 2021-born heifer Panmure 1 Plum W4 from JM Cant and partners, Arbirlot, Angus, following hot on the heels of its class win at Borderway’s Agri Expo. By Romany 1 Thor, a son of Fabb 1 Rocco, it is out of a Romany 1 Distiller sired homebred female.
Following its stable mate through into the reserve senior champion position was heifer Panmure 1 Plum W1, as chosen by judge Sophie Harvey, Balfron, Glasgow. December 2021 born, it is by Romany 1 Distiller A84 D53 and out of Panmure 1 Plum P10, a Dendor 1 Leota daughter.


Junior champion was Craigdhu 1 WillIt-Do from M Galbraith, Sandilands and was another animal which performed at Agri Expo where it was reserve junior male champion. Another by Gouldingpoll 1 Stockman, it is out of home-bred female Craigdhu 1 Morag, which was selected as reserve female champion in the 2020 Scottish Hereford Breeders Association virtual show.
Reserve in the junior section was Moralee 1 Pippa BS265 from T and D Harrison, Mickley, Northumberland.
January 2022-born, it is by Auckvale 1 Barnstormer, which was imported by its breeders as an embryo from Canada. It is out of Coley 1 Pippa 356 which stood breed champion at the Royal Highland in 2017, a daughter of Australian sire, Days Calibre G74 daughter.




These Northumberland-based breeders were also responsible for the reserve junior male champion, Moralee 1 Waxahachie KS269. By the 2019 UK sire of the year SMH King Size 87K, it is out of Moralee 1 Kylie, which was bred from the Romany Ishbel line.
Reserve junior female champion was Fellowhills 1 Talisman Echo from J Hodge, Berwick-upon-Tweed. Born in March 2022, it is by Gouldingpoll 1 Gold spice son Fellowhills 1 Talisman and out of Rockness 1 Echo, bred from Greenyards’ Echo family.
Some of the leading herds in the country are in our area and the undermentioned breeders would be delighted to see you. A prior appointment would be appreciated.
BERKSHIRE
1. R. Snelling, Sarabande Herefords, Long Meadow, Shurlock Row, Reading RG10 0PL. Tel: 01189 343323 Mobile: 07976 692543
BUCKINGHAMSHIRE
2. D. Briggs, Blackwell (P) Herd, Blackwell Farm, Latimer, Chesham, Bucks HP5 1TN. Tel: 01494 762190. Email: farm@davidbriggs.com
GLOUCESTER
3. M.L. & D.J. Jenkins, Appleridge (P) Herd, Appleridge Farm, Hystfield, Stone, Berkeley, Gloucestershire GL13 9LJ. Tel: 01453 511635. Mobile: 07785 388408 Email: martinljenkins@aol.com
HAMPSHIRE
4. M. Osmond, Broadgate Herd, Gastons Farm, Five Bells Lane, Nether Wallop, Stockbridge, Hampshire, SO20 8EN Tel: 07970 484 677 Email: contact@gastonsfarm.com
5. Julian Neagle & Sarah Taylor, Velmore Herd, 1 Velmore Farm Cottages, Bournemouth Road, Chandlers Ford, Hampshire, SO53 3HF. Tel: 07736 830536 Email: jneagle@tiscali.co.uk
6. T Yaldren, Banjos Poll Hereford: Long Park Farm, Long Park, Crawley, Winchester, Hampshire, SO21 2QE 07850024412
Email: longparkfarm@hotmail.com
7. James and Ellen Lake, Borovere, 1 Ragmore Farm Cottages, Froxfield, Petersfield, Hants, GU32 1DE. 07936 373996, Email: jameslake1988@gmail.com
8. Tom Hewitt, Potkiln Herd: Field House, Hursley, Winchester, Hampshire, SO21 2LE 01962 775203 07803165333
Email: hewitttom@hotmail.com
9. Harold Hatt, Jason & Priscilla Miller, Weybrook (P),Sherborne St John, Basingstoke, Hampshire, RG24 9LH Tel: 01256 850083
Email: jasonandcil@hotmail.co.uk
10. Mr & Mrs P Bradley, Crockers & Northwood Herds, Crockers Farm, Cowes Road, Newport, Isle of Wight, PO30 5TP. Tel: 01983 525878. Email: crockerslively@gmail.com
11. M & J Morris, Whitelane Herefords, Apesdown Farm, Rowridge Lane, Calbourne, Isle of Wight, PO30 4HS. Tel: 01983 531234/07791 537890
Email: mikedm.whitelane@gmail.com
12. David Thurman, Brambles Herefords: Brambles Farm, Brambles Lane, Freshwater, Isle of Wight, PO40 9SS 07887658816
Email: tthurmandavid@aol.com
13. H.B. Angel & Sons (John Angel), Locks Reds, Locks Farm, Locksgreen, Porchfield, Nr Newport, Isle of Wight PO30 4PF Tel: 07973 601634, 01983 522678 Email: locksgreengarage@gmail.com
14. S.I. Purchese, Lynsore (P) Herd, Court Lodge Farm, Manns Hill, Bossingham, Nr. Canterbury, Kent CT4 6EB. Tel: 01227 709330 Email: soniapurchese@yahoo.co.uk
15. Jan Boomaars, Vexour Herd: Hampkins Hill Road, Chiddingstone, Kent, TN8 7BB 01883 653064 07500706695 www.vexour.com
Email: mart1nsal@yahoo.co.uk
16. Charlie Basley, Phantom Herd, Landway Farm, Basted Lane, Crouch, Kent, TN15 8PY Tel: 01732 886002 Fax: 01732 887466
Email: enquiries@ghostmotors.co.uk
17. Wendy Howland, Tug Herd, Bramble Down, Sharnal Street, High Halstow, Rochester, Kent ME3 8QN Tel: 07837 137032
Email: whowlands65@gmail.com
SURREY
18. Nigel, Ann & Tim Metson, Coverwood (P) Herd, The Old Farmhouse, Coverwood Farm, Peaslake Road, Ewhurst, Cranleigh, Surrey GU6 7NT. Tel: 01306 731101 Email: farm@coverwoodlakes.co.uk
19. B., H. & M. Myers, Boundless (P) Herd, Boundless Farm, Boundless Road, Brook, Nr. Godalming, Surrey GU8 5LF. Tel: 01428 683077.
20. M.J. Burton, Westgate (P) Herd, Stumblehole Farm, Leigh Surrey, RH2 8PY. Tel: 01293 862607
SUSSEX
21. R. Hutchings, Fisher (P) Herd, Fisher Farm, South Mundham, Chichester, West Sussex PO20 1ND. Tel: 01243 262252. Mobile: 07881 944394
22. Nick Wren, Cathedral (P) Herd, Cedars Leggatts Farm, Old Park Lane, Chichester, West Sussex PO18 8AP Tel: 01243 572732 Fax: 01243 576899 Email: Nick@scarterfields.co.uk
23. Michael Clark, Lowesmoor (P) Herd, 4 Hyam Cottages, Bristol Road, Malmesbury, SN16 0RA 07929637573 01666823732 mikeclaklowesmoor@btinternet.com
24. Mr & Mrs M G S Gibson, Stitchcombe (P) Herd, Durnsford Mill House, Mildenhall, Marlborough, SN8 2NG. Tel: 07850 859824. Email: hello@grovefarmstitchcombe.co.uk
25. JR JK & RJ Pike, Bromham (P) Herd, Mrs J Pike, Durlett Farm, Bromham, Chippenham, Wiltshire SN15 2HY. Tel: 01380 850412/ 07891 386484, richardjohnpike@icloud.com
26. R Edwards & E Smith Classic Herd: Westfield, 31 Malmesbury Road, Leigh, Swindon, Wiltshire, SN6 6RH 07772495913 07979496365 premiercattleservices@gmail.com
Nicholas Williams, 3 Trindledown Cottages, North Standen Road, Hungerford, Berkshire, RG17 0QY. Tel: 07977 135624. Email : sehbasecretary@gmail.com www.southofenglandherefords.co.uk
Hereford Breeders’ Association AGM was held on the Isle of Wight in 2022 where the association’s herd results were announced.

The year 2022 got off to a good start for the South of England Hereford Breeders’ Association (SEHBA) with a spring workshop and herd visit hosted by Simon and Gemma Hartwright at Grove Farm, Abingdon, Oxfordshire. Starting with a herd walk around the Spartan herd with herdsman Luke Murphy, members then enjoyed a barbecue lunch followed by a stock judging competition and show preparation workshop with Richard Edwards. The stock judging was kindly judged by Jonny Dymond from Halls Auctioneers. Thanks go to all involved with putting on this enjoyable event.
Last year, saw Nick Williams, Aimee Hewlett and Stephen Foster designed an update of the association website. The new mobile friendly website includes all the details of SEHBA events as well as information on local and national shows,
membership information and updates and links to the SEHBA Instagram and Facebook pages. Visit www.sehba.org.uk.
Members have continued to support the shows with their cattle, many with notable success. Oxfordshire’s SC and GL Hartwright had much success through the season including winning supreme champion at the National Poll Show at Moreton-in-Marsh with Spartan 1 Typhoon. James and Ellen Lake of Borovere Herefords also triumphed with the grand female champion and reserve supreme champion at the National Hereford Show at Tenbury Wells with Pulham Pansy 26th. Congratulations must go to all members showing their cattle and for continuing to fly the flag for the SEHBA.
The SEHBA annual awards presentation evening made a return to the events calendar this year after an enforced absence due to the restrictions of Covid-19. Returning in its traditional slot of the last Saturday in November, nearly 30 members gathered at Gatton Manor near Dorking, Surrey to celebrate Christmas and the award winners of 2022. The association’s 2022 herd competition attracted 20 herd entries, kindly judged by Jim Spiers of Pepperstock Herefords, Luton. Thanks also to Johnathon Williams for his work at both events and selling the raffle tickets.
The SEHBA AGM took place on the Isle of Wight in late September 2022 and was appropriately held at The Cow, Yarmouth. During the meeting a lot of information was discussed and plans for 2023 put forward. The herd competition results were revealed to our members and congratulations go to our category winners. Thanks to all members who entered who certainly made life difficult for judge Jim Spiers of Pepperstock Herefords. Following lunch members visited three herds on the island, making the most of the glorious weather: The Brambles herd of David Thurman, the Crockers and Northwood herd of Paul and Mary Bradley and Whitelane Herefords of Mike and Jenny Morris. Thanks to them all for their help and hospitality in hosting the visits and AGM on the Island. In the evening a fine meal of Stitchcombe Hereford Beef was enjoyed at the Chequers which was delicious.
In May 2022 members learned the sad news that Pam Noel had passed away. Pam had just celebrated 50 years of breeding Herefords, achieving many championships at shows. Pam was a member of the association as well as being show secretary for many years. She was an ardent supporter of the breed and this association and she will be sadly missed.
Every year throws its challenges and 2022, with the extreme heat and drought conditions only showed how well the Hereford breed can acclimatise to different conditions. The Hereford still thrives and they always look a picture no matter what the pastures look like.

Thanks must go to all committee members particularly Nick Williams and Martin Gibson for keeping the association running smoothly, and to Michael Clark and Martin Jenkins who continue to represent the area at council.

(Judge, Jim Spiers, Luton, Bedfordshire)
Overall winner, SC and GL Hartwright, Spartan
Large herd, 1st, SC and GL Hartwright, Spartan; 2nd, M Jenkins, Appleridge; 3rd, Mr and Mrs MGS Gibson, Stitchcombe
Medium herd, 1st, RJ Hutchings, Fisher; 2nd, J Boomaars, Vexour; 3rd, J Neagle, Velmore
Small herd, 1st, D Thurman, Brambles; 2nd, M Clark, Lowesmoor; 3rd, C Baseley, Phantom
Stock bull (Warehead Cup), Solpoll 1 Perfection, SC and GL Hartwright
12-15 month heifer (Hawstonfold Salver), Spartan 1 Duchess SP V134, SC and GL Hartwright
12-15 month old bull (Lincoln Rose Bowl), Fisher 1 Valiant V542, RJ Hutchings
Spring bull calf (The Fern Nichols Tankard), Velmore 1 Hamish, J Neagle
Spring heifer calf (David Trott Tankard), Appleridge 1 Bluebell D160, M Jenkins
Judge’s choice (Cindy Hewlett Trophy), Vexour 1 Paige and Vexour 1 Wilma (sow and calf), J Boomaars
South of England Hereford of the Year 2022, Spartan 1 Typhoon, SC and GL Hartwright
Stockman of the Year, Luke Murphy, Spartan
Young handler (Brodnyx Trophy), Stacey Lake
Services to the association (The Wilson Quaiche), Nick Williams
CHURCHLANDS ESTATE 1 REMITAL SUPERDUTY
As a result of modern breeding, assessment techniques and traditional showing activities, the herd today boasts a string of national show awards. It is owned and founded by Philip English and his mentor and ‘guardian angel’ was Oscar Colburn who of course founded the Polled Hereford Breed. That friendship inspired him to use Oscar Colburn’s genetic guidelines. The genetics have been drawn internationally from Canada, USA, Australia and Denmark. They have pursued ease of calving, high milking volume, weight gain and the herd has produced an overall Polled female champion 2004 and overall male champion in 2006 and 2007.



We have semen available from Churchlands Estate 1 Batavia (overall male champion in 2006 and 2007) and six younger bulls 14 to 24 months immediately available for sale carrying outstanding genetics. For more information, please visit the Hereford Cattle Semen page on our website www.churchlands-herefords.com or call us on 07831 446421. Embryos are also available and can be purchased on a contract basis.


Straight off the back of their highly successful Royal Highland Show, Oxfordshire’s Spartan Herefords and stockman Luke Murphy made the long journey to Royal Norfolk. Their efforts were worthwhile and took three of the top Hereford spots of the day.
Renowned cattleman, Danny Wyllie, was tasked with judging the Herefords at Royal Norfolk Show and was delighted to see so many entries forward.
Spartan 1 Typhoon, bred by SC and GL Hartwright, Abingdon, Oxforshire was Danny’s breed champion, and commented ‘he walked in the ring with presence and style’, adding it was the best Hereford bull he had judged since Normanton 1 Laertes.


Born in February 2020, it won its class at the Great Yorkshire and Shropshire County last year, while it stood breed champion at this year’s Royal Highland and also placed reserve male champion at Royal Lancashire, reserve champion at Stafford and supreme at Shropshire County.
Female champion and reserve breed champion was another win for first time Norfolk Show exhibitor, SC and GL Hartwright, with Spartan 1 Duchess T95, described by Danny as ‘a tremendous heifer, which oozes character’. February 2020-born, this heifer is out of Ruckmans 1 Orange 1332 and by Panmure 1 Henry son Solpoll 1 Perfection and already has a class-win at the Royal Highland as well as the championship at Royal Lancashire.
Reserve male champion was Spartan 1 Voyager SP V138, winner of the youngest bull class of the day. Voyager fought off Sandlow 1 Victor from Simon Jones, to win its class, the judge’s closest decision of the day. March 2021-born, this young bull is out of Panmure 1 Plum K19,
UK226752 600560
Sire: Haven Granville
IL/G53/121
Dam: Laxfield Lady Lynda 14th UK226752 200094
No rain in June, July, August. Doing well on barley straw, dust and water.
UK226752 500692
Sire: Nuelands Juror* CNT/ J16/105
Dam: Laxfield Silver 8th*
UK226752 500118
A promising traditional calf with a bit more scale.


Your satisfaction is our aim. Visitors always welcome.
D.C. Smith and Sons, Banters Barn Farm, Boyton, Woodbridge, Suffolk IP12 3LW Tel: 07971 694912 or 01394 411270
www.butleyherefords.co.uk
Breeding stock usually available from some of the best horned and traditional female lines.
making it a full brother to the supreme champion.
Regular Norfolk Show exhibitors, MJ Ludgate, Thame, Oxfordshire took the reserve female spot, with 2021 Agri Expo champion Rempstone 1 Curly N604, shown by stockman Joe Clark and sired by Solpoll 1 Nobility. Danny again took to the microphone describing it as a ‘powerful heifer with exceptional length which will make a fantastic cow’ and won the largest class of the day made up of 12 heifers.
Rempstone 1 Curly N604 was the judge’s junior champion, with Spartan 1 Duchess SP V134, which was second to Curly in the class following her through to take the reserve spot for the Hartwrights. The whole Spartan team is sired by Solpoll 1 Perfection, champion at the Hereford Cattle Society spring sale in April 2019 and was purchased for the top price of 8,000gns.
The youngest heifer class was won by Sandlow 1 Mines-A-Singlestar, from first-time Norfolk Show exhibitor Simon Jones, who had made the trip from Cheshire. A daughter of Rempstone 1 Mines-A-Double E432, it is out of Sandlow 1 Starburst by SMH King Size 87K.


Spartan Herefords rounded off their fantastic day by winning the pairs class and the group of three.
The Norfolk Special was won by PRJ and LR Vincent with Pulham Pansy 28th, a January 2021-born Pulham Ranger daughter.

The Spartan team had further success on the second day of the show with Typhoon winning the native male beef championship and Spartan 1 Duchess T95 being made reserve native female beef champion.
The Herefords also had success in the beef young handler classes as judge Garrett Behan, Ireland, put the many handlers through their paces. Cara Doggett, the current New Zealand Beef Parader National Champion, who is visiting the UK and was showing for Spartan Herefords, won the very competitive championship.




Cleland 1 Oyster Gem 32nd sold for 3,600gns and also travels to Worcestershire with Nigel Hooper. Out of Titcomb 1 Oyster Gem 3rd, it is by the successful show bull Cleland 1 Jackson.
Cleland 1 Cheerful 7th topped the dispersal sale of Hungerford-based AE Nesbitt Farms at 6,200gns which was incorporated into Halls’ spring Hereford day, selling to Ryan Coates, Newton Harcourt, Leicestershire. This nine year old cow is a daughter of Bromley 1 Midas, a Dorepoll 1 Crown Royal son and out of a home-bred cow. It sold with its fifth calf at-foot, heifer Cleland 1 Cheerful 18th, which is sired by Havenfield 1 Robin Hood. At 5,800gns, Cleland 1 Oyster Gem 51st from AE Nesbitt sold to a top call of 5,800gns to Nigel Hooper, Leigh Sinton, Worcestershire. By Solpoll 1 KitKat, a son of the renowned Panmure 1 Henry, the female sold at three years of age with its first calf Cleland 1 Oyster Gem 56th, which is another daughter of Havenfield 1 Robin Hood.
Going to the same home was Cleland 1 Cheerful 14th, which sold with its first calf Cleland 1 Cheerful 17th for 4,700gns, again to Nigel Hooper. This three year old female is out of a Bromley 1 Midas daughter and by Cleland 1 Nelson which sired both the grand female and male champions of the 2021 National Poll Show.
Five year old cow Cleland 1 Glissade 27th sold with its second calf, Cleland 1 Glissade 29th, for 4,200gns, adding to Nigel Hooper’s purchases of the day. This cow is a daughter of Cleland 1 Luther, the South of England Hereford Breeders’ Association 2018 bull of the year, while its calf is another by Havenfield 1 Robin Hood.
The most senior stock bull in the Cleland dispersal was Havenfield 1 Robin Hood, which sold at 3,200gns to a telephone bidder. As a youngster, Robin Hood stood reserve supreme at the 2018 National Calf Show at Shrewsbury. By Romany 1 Lawbreaker RE L23, it is out of Dendor 1 Ruby 20th.
In the main run of the sale, it was Dendor 1 Voodoo from DE, ED and AL Jones, Caersws, Powys which led the money, and was the day’s top priced bull at 4,400gns. Born in October 2020, it is by Dendor 1 Nairobi, the 2018 National Poll Show supreme champion. Out of Dendor 1 Ruby 9th, it went home with JL Forsey, Broadoak, Dorset.
At 13 months of age Glenvale 1 Fabulous from TG, EI and EN Thorne hit a top call of 2,600gns to A Whitfield, Derrington, Staffordshire. By the breeders’ stock bull Vexour 1 Palmer, it is out of the Thornes’ Angela line, sired by Dendor 1 Ledley.
The gavel went down for 14 month old
Glenvale 1 Fireball at 2,500gns. From TG, EI and EN Thorne, the current national herd of the year title holders it was purchased by DP Jones Agricultural Contracting, Coleshill, Warwickshire. Having travelled south from Northumberland, T and D Harrison’s Moralee 1 Kathryn KS R17, a four year old second calver, sold with its daughter atfoot to Anthony Whitfield for 2,600gns. Its calf is by Moralee 1 Rebel Kicks KS R12, the Hereford champion of Europe 2021. Coley 1 Willow 489, a three year old from Heather Whittaker, Halifax, was knocked down at 2,300gns to Duncan Law, Bassaleg, Newport. By the 2019 bull of the year, Romany 1 Prime Time BL P62, it is out of Grangefell 1 Wyandot A63G, an Ervie L1 Achiever 91163G daughter. It sold with its first calf, the bull calf Coley 1 William which is by Coley 1 Spear, a son of the Canadian sire, Tlell 8N Red Zulu 1Z.
Within the maiden heifer section, Moralee 1 Ishbel RB V11 from T and D Harrison realised 2,000gns, and was also purchased by Anthony Whitfield.
Auctioneers: Halls
May 2022 saw the dispersal of AE Nesbitt Farm’s well-known dispersal herd which saw prices to 6,200gns for a cow and calf.
Dyfed Hereford Breeders’
Secretary: Liz Roderick, The Bank Farm, Scurlage Castle, Scurlage, Reynoldston, Gower, Swansea, SA3 1BA tombankfarm@aol.com
Hereford Cattle Breeders’ Association (West Midlands)
Secretary: Emma Davies, 33 Windmill Lane, Inkberrow, Worcestershire WR7 4HG emmajadedavies@hotmail.co.uk
Midlands and East Anglia Hereford Breeders’ Association
Secretary: Peter Moyes, Lodge Farm, Welford Road, Thornby, Northampton, NN6 8SL petermoyes@btinternet.com
North of England Hereford Breeders’ Association
Secretary: Jackie Cooper, Pollards Farm, Howick Cross Lane, Penwortham, Preston, PR1 0NS nehbasecretary@gmail.com
Northern Ireland Hereford Breeders’ Association


Secretary: Mark Moore, 51 Glassdrummond Road, Aughnacloy, Co Tyrone, N Ireland, BT69 6DE mark-moore@hotmail.co.uk
North Wales HBA/Clwb Henffordd Gogledd Cymru
Secretary: Audrey Morgan, Fardre Farm, St George, Abergele, Conwy, LL22 9RT morganfardre@btconnect.com
Powys Hereford Breeders’ Club
Secretary: Glenn Pritchard, The Sidings, Railway Goods Yard, Station Houses, Tir-Phil, New Tredegar, Caerphilly, NP24 6ES gpritcharf@gmail.com
Scottish Hereford Breeders’ Association
Secretary: Margaret Galbraith, Millmoor Farm, Sandilands, Lanark, ML11 9TW margaret.stewart123@btinternet.com
South of England Hereford Breeders’ Association
Secretary: Nick Williams, 3 Trindledown Cottages, North Standen Road, Hungerford, RG17 0QY sehbasecretary@gmail.com
South Western Hereford Association
Secretary: Angela Kerslake, Nicholashayne Farm, Nicholashayne, Wellington, Somerset, TA21 9QY southwestherefordassoc@gmail.com
Traditional Hereford Breeders’ Club
Secretary: Helen Macleod, Carpenters Farm, Berrow, Malvern, Worcestershire WR13 6JJ helenmac2@btconnect.com
President: Les Gould Tel: 01258 472417
Email: gould121@btinternet.com

Chairman: Gerald Wood Tel: 07721 068181

Email: ameliajwood@aol.com
Secretary: Angela Kerslake, Nicholashayne Farm, Sampford Arundel, Wellington, Somerset TA21 9QY. Tel: 07973 452403, Email: southwestherefordassoc@gmail.com www.herefordssouthwest.com www.facebook.com/southwestherefordassociation


Success was enjoyed by a number of South Western Hereford Breeders’ Association members at summer shows in 2022.


The South Western Hereford Breeders’ Association’s (SWHA) visited the 2021 South West herd competition winners, the Lanscombe herd near Dorchester in the summer of 2022. They started at the Halsey Arms some two miles away from the Mitchell family’s High Henley Farm for a slap-up roast carvery and delicious puddings. After a leisurely drive, 50 members arrived well on time to see a wonderful and well-prepared array of magnificent Hereford cattle including their very impressive stock bull Vexour 1 Phantom.
Christopher Mitchell explained the different groups of cattle in close proximity to the farm yard and presented members with a full documented catalogue of all animals they were able to see.
The afternoon also included a clipping and show preparation demonstration and two stock judging competitions and a guess the weight contest. The tea and cakes afterwards were also greatly appreciated. The SWHA committee would like to thank the Mitchell family for their superb hospitality over the course of the day.
The first day of the show saw heavy rain but this did not deter the many breeders exhibiting that day. Border Souvenir S40 exhibited by FJ, RP and JM Hawke was overall champion with Spartan 1 Polly T122 from Luke Powell in reserve. Anna Pascoe-Old took away many awards with Venen Unique winning bull born in 2021, best exhibitor-bred Hereford and best Cornish-bred Hereford and reserve champion male. Anna then went on to win group of three animals.
One to watch in the future is young Tom Jarvis who won cow or heifer born in or before 2019 with calf at-foot with Valley View 1 Sparkle.
Other successes by SWHA members were Erin Lockett of Gwel An Mor Herefords who won overall beef young handler.
Breed champion Vexour 1 Phantom was photographed prior to his champion native beef animal and reserve interbreed
successes and its photo was published in the next edition of The Guardian.
The South Western Hereford Association won the gold award for the best breed stand and thanks must go to Jackie Hawke for helping man the stand for all three days.

A good turnout of Hereford cattle were seen in the very strong native classes. Chris Lockyer of Lockyer Agri Services presented the red rosette to Valley View 1 Winging’ it owned by Tom Jarvis winning pedigree any other native breed bull calf born in 2022. Moralee 1 Kylie OR264 ventured far to win her any other native heifer class then went on to become reserve overall native calf.
Huge congratulations goes out to the Wood family of Allwood Herefords situated in the heart of South Devon for their success at the National Poll Show where they took female champion and reserve supreme champion with Rempstone 1 Anna Mary N506 and reserve with Pepperstock 1 Leslie V706.
Large herd
(Judge, Chris Mitchell, Dorchester, Dorset)
Herd, 1st, Cato, JD Moorhouse; 2nd, Meadow Duke, S White; 3rd, Spyway, PA and PM Earley
Bull calf, 1st, Cato 1 Washington, JD Moorhouse; 2nd, Hollystone 1 Rider, PR and CA Caunter; 3rd, Meadow Duke 1 Tell, S White
Heifer calf, 1st, Meadow Duke 1 Alice, S White; 2nd, Cato 1 Princess Gem, JD Moorhouse; 3rd, Spyway 1 Ambrosia 14th, PA and PM Earley
Stock bull, 1st, Pepperstock 1 Sampson, S White; 2nd, Dorepoll 1 Transtar, JD Moorhouse; 3rd, Panmure 1 Rocky, PR and CA Caunter
Brood cow, 1st, Cato 1 Helen, JD Moorhouse; 2nd, Spyway 1 Ambrosia 8th, PA and PM Earley; 3rd, S White, Heath House 1 Throch
(Judge, Les Gould, Shaftesbury, Dorset)
Herd, 1st, RA Mitchell, Lanscombe; 2nd, Gwel an Mor, ME Vague; =3rd, A and D Robinson, Velleyhill; =3rd, Jamie Palmer, Rolster Bridge

Bull calf, 1st, Gwel an Mor 1 Warleggan, ME Vague; 2nd, Lanscombe 1 Diamond, RA Mitchell; 3rd, Rolster Bridge 1 Winendine, Jamie Palmer
Heifer calf, 1st, Velleyhill 1 Vivian, A and D Robinson; 2nd, Stockbridge 1 Wada, AE Voss; 3rd Chamberlains 1 Kaitlyn, SC Luxton
Brood cow, 1st, Firbosa 1 Brownie, Jamie Palmer; 2nd, Stockbridge 1 Stardust, AE Voss; 3rd, Lanscombe 1 Queenie, RA Mitchell
Stock bull, 1st, Vexour 1 Phantom, RA Mitchell; 2nd, Shraden 1 Niicosia, SC Luxton; 3rd, Fabb 1 Rory, Jamie Palmer
(Judge, JD Moorhouse, Stogumber, Somerset)
Herd, 1st, EG Mills, Severnvale: 2nd, J Burgess, Clarance; 3rd, JR Williams, Culverhill
Bull calf, 1st, Midford 1 Whistlejacket, W Awan; 2nd, Farmlay Douglas, C and E Layzell; 3rd, Severnvale Rogue, EG Mills
Heifer calf, 1st, Allwood 1 Greta, FJ Wood and sons; 2nd, Baybridge 1 Felicity, LG Gould; 3rd, Culverhill 1 Lavender, JR Williams
Stock bull, 1st, Kinglee 1 The New One, W Awan; 2nd, Somerwood Rondo, EG Mills; 3rd, Baybridge 1 Prince, K Rolls
Brood cow, 1st, Oakleaf Miranda, K Rolls; 2nd, Potkiln 1 Flossie, GMS Farming; 3rd, Richmonds 1 Vivien 7th, RL Jones and sons





At the Royal Bath and West Show, Vexour 1 Phantom from RA Mitchell moved to the fore and was named breed champion and grand male champion before also winning the reserve interbreed champion title.
Following Phantom through the senior bull class all the way to the reserve supreme champion position was Buckenhill 1 Trans Am from M Gray and L Crowther, Bromyard, Herefordshire. A son of Cornriggs 1 Knightrider, it is out of Greenyards 1 Ferdinand daughter, Buckenhill 1 Anxiety 3rd.
Taking the junior native heifer championship was from B Birch, G Brindley and N Griffiths, Staffordshire which also stood grand female champion. Born in February 2021, Miss Allure won supreme champion in the National Pedigree Calf Show held at the English Winter Fair in 2021 and was also



junior champion at Stars of the Future that year. By Dendor 1 Kohinoor, it is a son of Danish-imported SMH Euro 30E and out of Dendor 1 Jennefer 15th, the two times Hereford female of the year which is a daughter of Solpoll 1 Gilbert, the three times UK sire of the year. Reserve female champion was tapped out
as Buckenhill 1 Brownie V329, another from M Gray and L Crowther. Born in November 2020, it is out of Bosa 1 Brownie 1034 and by Buckenhil 1 Samsonite, a Greenyards 1 Nostradamus son.
Lanscombe 1 Cranberry and Lanscombe 1 Crème Brûlée also paired up to win the reserve native interbreed pairs.










Ellen Layzell runs the Farmlay herd of horned Herefords along with her father Colin near Honiton, Devon. In autumn 2022 she spent some time in Germany and learnt about the German beef industry and Hereford herd.
by Ellen LayzellFrom October through to December 2022 I visited Germany and took this opportunity to reach out to the German Livestock Association and the German Hereford Association to gain an insight into their beef industry, and the presence of the Hereford breed.
The German beef industry is slightly larger than the UK, with close to 50,000 farms which together house more than 1 million cattle. More than 40 beef breeds are kept in Germany, including the Hereford.
During the second month, I spent a couple of days in Hannover in Northern Germany attending EuroTier - an event which is known as the largest international trade fair within the livestock sector. Here, I was excited to meet the board of the Federal Association of German Hereford Breeders. I was interested to learn about the growing size of their association, which now consists of 160 members having increased by 15 members alone this year.
There are around 2,000 registered Herefords in the country, most being of poll breeding. There are also 300 herds and 6,000 Herefords in the country which are not registered with the association. Meeting the bull Roost 1 Hans Oluf was another highlight of the event, which is currently the 2022 National Champion Hereford bull.
Coming to the end of my trip, Ulrich and Monika Spechtmeyer kindly welcomed me onto their farm. Located in Western Germany, they have been breeding poll Herefords since 1992 using Danish breeding with bloodlines originating from Canada. Their herd, HSp Herefords, is currently home to 17 cows with offspring, two stock bulls and several yearlings.
Covering 22 hectares (55 acres) and operating an organic farming system, the cattle remain on pasture land allyear-round with the additional access to shelter if desired. Their feeding and
nutritional management consists of high quality meadow grass, and supplemented hay and silage in the winter months. The farm is entirely self-sufficient, making their own fodder. They calve during the spring, with the weaned calves and young stock either kept or sold for breeding. To maintain the quality of the cattle and ensure a high health status, annual blood tests are taken. Twice a year, body condition scoring of breeding cows is also completed, with support from the German Hereford Association, alongside regular weighing of youngstock to ensure growth targets are met.
Learning first-hand about the beef industry in Germany and more importantly the presence of the Hereford breed was a great experience. It is fascinating how the agricultural industry differentiates worldwide, yet the love for the Hereford breed remains the same.
REGISTERED BULLS & FEMALES AVAILABLE AS REQUIRED THROUGHOUT THE YEAR




VISITORS ALWAYS WELCOME
MANY THANKS TO ALL OUR LONGSTANDING & NEW CUSTOMERS
Having won the Royal Cornwall breed championship multiple times over the family’s long history of breeding Hereford cattle, local family Fred, Roland and Jackie Hawke came to the fore once again with Border Souvenir S40 with Warwickshire’s Richard Mann sorting the line ups.
Bred by Stan Quan, Wormbridge, Herefordshire, this 2018-born bull is by Witherstone Archie, which itself is bolstered by generations of Border breeding and was shown by Ifan Davies, stockman for the Border herd.
Standing in the reserve supreme and grand female position was Spartan 1 Polly T122 owned and shown by LD and LL Powell, Penpedaorheol, Mid Glamorgan having already won the 2020-born heifer class. Bred by SC and GL Hartwright, it is by the 8,000gns Solpoll 1 Perfection and out of Ruckmans 1 Polly 1306.
Valley View 1 Sparkle from T Jarvis, Ashreigney, Devon was tapped out as reserve female champion following its success in the senior female class. Out of Moorside 1 Julia, it is by Hoghton View 1 Gold Mine, which goes back to Remitall Patriot 13P.
Taking the male championship was Venen Unique from Anna Pascoe-Old, St Issey, Cornwall. Born in February 2021, it is a Free Town Mascot son, out of Venen Bonny 8, which is also from Free Town breeding. The group of three was also won by Anna Pascoe-Old.
The 2021-born heifer class was led by Lanscombe 1 Cranberry from RA Mitchell, Dorchester, Dorset who won the 2021 South West herd competition. Born in January 2021, it is by stock bull Vexour 1 Phantom, which stood breed champion at the Royal Bath and West just days before.



Bulls
Border Souvenir S40 at 3½ Royal Cornwall Show Breed Champion 2022

Border Souvenir S40
Got size, length and width. Calved 30 heifers to him and hardly touched a calf. Our 16th Royal Cornwall Show Champion. Our first was back in 1969, 53 years ago with Eggbeer Artisan, his daughter Female Champion 1969. Every cattle farmer and breeder said Border Souvenir S40 was the best Hereford ever shown at a Royal Cornwall Show. Our special thanks go to Ifan Davies, former top stockman for Helen & Stan Quan, Border Herd, for coming down and doing a great job showing Border Souvenir S40 for us.
Senior Stud Bull
Rockland Perseus is proving a great Sire for us. Bred by Clive & Paula Bidmead.
Our cattle are not pampered in any way
Most of the cow herd are by Phocle Generator, who has to be one of the best sires used in the breed.
Hustyn Farm, Burlawn, Wadebridge, Cornwall, PL27 7LD
Phone 01208 815834
At Devon County Show Vexour 1 Phantom from RA Mitchell, Dorchester, Dorset was tapped out as breed and grand male champion. By Solpoll 1 Landmark, this March 2017 born bull is out of Baybridge 1 Atlas daughter Romany 1 Mink A84 J22 and it was purchased by the breeder at the 2018 autumn show and sale for 5,000gns.

The bull also won reserve interbreed champion and native interbreed champion. Together with reserve breed champion Spartan 1 Polly T122 from LD and LL Powell, Penpedaorheol, Mid Glamorgan, the two animals went on to be champion interbreed pair.
Reserve champion Polly stood supreme champion at the 2021 Christmas calf show for breeders SC and GL Hartwright, before selling to a top call of 4,000gns to LD and LL Powell in the Designer Genes sale. Sired by the 8,000gns Solpoll 1 Perfection, it is out of Ruckmans 1 Polly 1306.

Reserve male was Lanscombe 1 Carlos, another from RA Mitchell. Home-bred, this February 2021-born son of the supreme champion Phantom.
Porton House 1 Jane 2nd from South
Stirling
Sunday 5 – Monday 6 February
Dungannon Farmers Mart
Tuesday 14 February
Shrewsbury Auction Centre
Saturday 15 April
Dungannon Farmers Mart
Tuesday 18 April
Borderway Mart
Saturday 20 May
Shrewsbury Auction Centre
Saturday 30 September
Stirling
Sunday 16 – Tuesday 18 October
Dungannon Farmers Mart
Tuesday 5 December
Wales’ Paul and Vicky Moyle was selected as reserve female champion. By Dendor 1 Sherlock, it is out of Porton House 1 Jane, a daughter of Panmure 1 Nugget.





A switch to native breeds is fitting a more holistic style of farm management being adopted by Bristol-based beef farmer George Ford.
Running 40 breeding cows, mainly continental-crosses, George, who farms with his wife Meg and parents, Pete and Gill, has moved to use a Hereford sire in the last few years. In a private deal, George purchased Fabb 1 Noak, a bull full of Danish breeding with good EBVs for eye muscle area and intramuscular fat to join his commercial herd.
George’s intention is to cross these first Hereford sired heifers to an AberdeenAngus in order to produce Black Baldies.
He explains: “This is partly driven by a desire to keep a more moderate sized cow and also a preference for easier fleshed cattle with good intramuscular fat as we are now starting to retail our own beef.
“We want to avoid anything with myostatin, which is not present in the Hereford breed. Large backends aren’t of any interest to us, the prime cuts are in the sirloin and that’s the priority.”
Along with the switch in cattle type, the family has embraced a change in grassland management, initially moving to paddock grazing youngstock, before moving to holistic grazing and mob grazing management style of taller grass.
“We’re heavily focusing on soil health through grazing. Grazing taller grass and allowing for a degree of trampling is helping improve soil quality and helping adapt to farming with lower inputs. But he admits, it’s required a significant change in mindset.
George says: “It’s a messier way to farm and you have to accept that as part of the change in system. However, grazing taller grass means there is more to trample which helps build soil quality and is meaning we can extend the grazing period at either end of the grazing season.

George Ford is working towards running a Black Baldy herd at his Bristolbased farm.
“Whereas with standard paddock grazing you’re looking at 21-day rotations, with holistic grazing it can be anything from 30 days to 100 days before cattle are back round on the same ground again,” explains George.
“The aim is to rely less on ryegrass and increase the diversity of species in the sward, it is amazing once you stop using artificial fertiliser what other plant species come through. It does mean that some weeds also thrive more, including docks and while they are unsightly, we are coming to terms with the fact that they are doing some good in fixing phosphorus in the soil.
On a practical note, he says the shift in grazing system is allowing cattle to be grazed both earlier and later in the year, with the housing period now cut down to December to the end of March.
“It’s getting shorter each year, with cows housed in cubicles and calves able to creep forward to a straw yard and weaned in January, ahead of cows calving again in April and May.
“The change in breeding is targeting a lower cow weight, with cows which thrive in a forage-based system and get in-calf every year with minimal intervention and largely goes unnoticed in the herd. Those ‘ghost’ cows which never cause any problems and deliver every year are the ones which leave a profit,” says George.
The aim is to have the herd made up of 100 per cent home-bred, native-bred

cattle within 10 years to help simplify management.


“It is easier to boost profits by reducing costs than increasing outputs,” he says. And in-line with this simpler approach to herd management, George is extending this to the beef sales, choosing to freeze most of the carcase once cut and retail it a little at a time.

“We’re growing beef sales gradually, but I am conscious that we don’t want to move to all-year round calving, so freezing beef when cattle are ready for slaughter means we can maintain supply through the months when we don’t have any ready.
“Those animals we’re not retailing are sold to ABP, with the aim being an R3 carcase with a maximum carcase weight of 400kg for the steers,” he adds.
“Additionally, we farm 550 turkeys and 1,200 pasture-reared chickens, and the turkeys are big fans of the docks, stripping the seeds from the plant,” he says.
The freezing option is something George believes could be extended to the turkey enterprise, particularly with the threat of bird flu increasing later in the year.
“It would also help with spreading the workload and labour availability.”
It is this poultry enterprise and particularly the turkeys which have given George the confidence to start shifting the beef enterprise towards one which delivers higher eating quality.
He says: “Ultimately, we’re looking to retail more of our own meat, both through pop-up events and also by working with local restaurants and through online sales.
“We started with turkeys five years ago and have introduced the chickens off the back of that and now see an opportunity to expand that with the beef too,” adds George.
The family are working with local butcher
Jamie Vowes who cuts the beef to their requirements, with George saying he’s learning a lot about the different cuts as he gets more involved with the retail aspect of the industry.
George says: “We have historically been finishing 4,000 pigs each year, but have recently ceased with that and hope to expand the meat sales side of the business to replace that lost income.
“I firmly believe eating quality will be paramount to that and native breeds, such as Hereford, reared on a forage diet


are the best way to deliver the type of beef that can earn a premium through direct selling.”
Away from the livestock enterprises George is also introducing other new ventures to the farm, with planning permission recently granted for subterranean glamping pods, with work on those due to start in 2023 and George is also looking at offering farm safaris in the summer months to capitalise both on glamping visitors and the farm’s proximity to Bristol.
He says: “These are both diversifications which will complement the farming system we’re moving towards and add value to the farm’s outputs by raising awareness of our meat sales.”
• 40 breeding cows
• Working towards a Black Baldy herd
• 550 turkeys
• 1,200 pasture-reared chickens
• Planning permission for subterranean glamping pods

Genetics have a key role to play in improving the long-term performance of livestock herds. Genetic progress from the maternal side can be slow as females typically only produce one calf per year but in contrast, a single bull of high genetic merit can produce thousands of offspring through artificial insemination, states Emma Stuart of Paragon Vet Group.
Given the equally important role of both males and females in enhancing herd genetics, adopting technologies which maximise offspring numbers from superior dams via conventional embryo flushing (MOET) or in vitro production (IVP) will help accelerate herd genetic progress.
Emma says: “Increasing the longterm productivity, sustainability and profitability of herds can be more readily achieved by selecting for characteristics such as enhanced feed efficiency, fertility, longevity and disease resistance, which can be facilitated by genomic testing.”
Once embryos have been produced, the success of any embryo transfer (ET) programme relies heavily on good stockmanship and management of the recipients.
As a general rule, maiden heifers are preferred as they average a five to 10 per cent better pregnancy rate compared to cows.
Emma continues: “Maiden heifers should be at least 15 months old, cycling regularly and should weigh a minimum of 350kg before ET. However, when transferring embryos from larger beef breeds or embryos sired by a bull with
a poor calving ease index, cows may be preferable.”
Selected females should have no history of reproductive or health problems.
“Cows should have passed peak yield before being synchronised for ET as the stress of lactation will reduce pregnancy rates it is also preferable to use younger animals - 4th calvers or less,” she says.
Purchased recipients should have at least a six week settling period as they will often have an unknown nutritional and reproductive history, explains Emma.
“Allow time for isolation, testing and vaccination programmes which should be discussed with your vet. Diseases such as IBR, BVD, Leptospirosis or
deficiencies of copper and selenium could have a devastating effect on an ET programme.,” she says.
Routine husbandry treatments such as vaccinations, worming and fly repellent should all be completed prior to the commencement of an ET programme reducing any stress factors.
Recipient animals should be in good health and a condition score of ~2.5/5 at transfer, as pregnancies are lower when recipients are either too fat or too thin.
Emma continues: “Ideally, recipients should be segregated and managed as a separate group. Avoid major changes in diet or routine six weeks both pre and post-transfer.
“The aim of the diet is to achieve a moderate rising plane of nutrition. A long fibre-based diet such as hay, big bale silage or straw is best, whilst lush, wet grass should be avoided. A low-protein coarse mix as a concentrate supplement can be fed, while sugar beet pulp can be useful if more energy or fibre is needed. In our experience, recipients managed indoors have five to 10 per cent better pregnancy rates than those managed at grass,” says Emma.
Several trace elements have a major role in reproduction including copper, selenium, manganese, phosphorus and zinc. Some form of supplementation is likely to be of benefit in all ET programmes which should be discussed with your vet.


She says: “Recipients should be fed 100g per day of a good quality powdered mineral for at least six weeks before the planned transfer date. Boluses can also be used and supplemented with free access mineral buckets.
“Finally, to maximise the success of any synchronisation programme and increase pregnancy rates, good heat detection is vital. This can be done by recording the time of onset of standing heat for each recipient and communicating this to the technician.
“If donor cows and semen of high genetic merit have been selected, the resulting calves should have improved characteristics, which will further enhance the productivity and sustainability of the national herd. As an added bonus, these animals should, in turn, be more profitable.”








The annual summer meeting and herd visit of the Traditional Hereford Breeders’ Club arrived at High Trees Farm, near Ware, Hertfordshire on Wednesday 22 June, kindly hosted by the Gibson family. Members enjoyed a productive meeting and fantastic lunch, followed by a tour of the family’s Gibsons herd of Hereford cattle. Established just five years ago and already displaying an impressive consistency within the herd, the herd featured youngstock by Blue Cedar Legend bred by Nigel Darling, along with current stock bull Boresisle Richmond bred by David and Juliet Fenton.
Herd owner and young Hereford breeder William Gibson runs the online butchery
Just William from a newly built unit on the farm, alongside parents Andrew and Vanessa’s arable business. The family’s herd of Traditional Hereford cattle was added to supply the butchery with top-quality beef direct from grass, while keeping a registered herd and aiming to breed stock to satisfy butchers and breeders alike. Thanks go to Andrew
and Vanessa Gibson, their sons Charles and William, and all who helped to organise and run such a superb visit. The opportunity to host the 2023 summer event will be offered in due course, and anyone who would be interested in hosting, either for this year or in the future, would be very welcome to contact the club to register their interest.
The Traditional Hereford breeders’ Association has enjoyed an active year while also collating cow family information.Club chairman Les Cook (left) and treasurer Sarah Cowle Members enojyed the summer herd visit in Hertfordshire Some cow families are becoming increasingly rare
One of the most important duties of the Traditional Hereford Breeders’ Club is to monitor and analyse the frequency and distribution of the remaining descendants of the Traditional Hereford female families, as recorded in the early Hereford herd books.
Club researchers have put together the below table which shows the number of
females, residing in England, Scotland or Wales registered with the Hereford Cattle Society and alive at time of searching, with pedigrees tracing back along the female line to the families shown.
Census data is given for 2018, 2019 and 2022 and reveals there are eight families each with fewer than 20 registered females remaining. There are a further eight families each with between 20 and 100 registered females, and five families with more than 100 and up to 440.
For all breeds, retaining a wide genetic base is useful to enable farmers a greater choice when selecting animals to use in their breeding programme, to make available all of the traits which exist within the breed and to prevent the likelihood of animals becoming too closely related. When it comes to genetic diversity, the Traditional Hereford is in a fortunate position, having once been highly populous, becoming successful in many parts of the world and having stored semen from a large number of bulls across several decades.
Since the re-importation of overseas Hereford genetics into the UK became popular, some of that diversity within the Traditional Hereford breed will have been lost, as farmers began to breed their UK-bred Hereford cows to bulls with overseas genetics. Those original cows would eventually have made their way out of production leaving no progeny to replace them, and as such many of the original female families have only a few descendants remaining, or none at all.
Whie the Hereford stands in a strong position in the marketplace and remains popular with consumers, the Traditional Herefords must continue to develop as a resource, not only to represent this phenotype, but to hold onto the whole cross-section of those valuable characteristics which are important to beef producers and graziers around the world.
Breeders already owning females represented in the above table,
particularly those in categories with the lowest numbers, can help to perpetuate the continued revival of those families by ensuring that females are bred to Traditional bulls and, where possible, take action to ensure their protection against disease.
Bovine TB (bTB) remains a major concern in many areas of the UK, and rare bloodlines represented by animals residing in bTB hotspots are extremely vulnerable to being lost. Breeders in this situation could look at the possibility of moving individual animals to herds in other areas in order to mitigate this risk, and the association is keen to offer help where needed in connecting breeders who might like to work together or to buy and sell. The club is continually working to identify where animals from the rarest families reside, and to make the owners of those animals aware of their importance.
It was discussed at a recent meeting of the club that embryo collection and/ or IVF from the rarest females could be one way to fast-track the regrowth of these bloodlines, and that the club would welcome the participation of any breeder interested in undertaking this work by offering rare females for embryo collection or IVF (particularly as a final consideration prior to culling) or providing recipients and rearing progeny. In addition, the club also continues to work to re-introduce further lines now only in existence overseas and are also looking into the possibility of assessing mitochondrial DNA to distinguish between or within these recognised families.
Most importantly, if any individuals or organisations are interested in what could be done to increase numbers of some of these rare families, they should contact the Traditional Hereford Breeders’ Club to discuss.
Want to know the background and history of the Hereford female families? Visit www. traditionalherefords.org/post/originalpopulation-cow-families.

Carpenters Curly 18th from Helen MacLeod, Worcestershire was selected as supreme, junior and female champion of the Traditional section at Shropshire County Show by judge Sarah Cowle, Quainton, Buckinghamshire. January 2021-born, this heifer is a daughter of stock bull Shefford Monarch, a grandson of Free Town Kendal which sold for 17,000gns in 1976. The Curly line at Carpenters goes back to Llandinabo where it took residence from the Vern herd.

Reserve supreme and reserve female was Carpenters Laura, again from the home of Helen MacLeod’s Carpenters herd. Two years old, this female is another Shefford Monarch daughter and is out of Rhydri Clarabelle Laura, which goes back to the Westwood herd.
Heading up the male championship was Carpenters Monarchist, from the same stable. By Shefford Monarch, it is out of Carpenters Venus 4th, the family of which if traced back, returns to the Penatok herd.
Second placed male on the day was Albany Sailor from FW Cook and son, Fen End, Cambridgeshire. By two home-bred parents, it is by Albany Lincoln and out of Albany Sable which is a daughter of Boresisle Lawrence.
In the pairs, two Carpenters animals went on to win the rare and minority interbreed pair

Despite being on the side of Northamptonshire’s M1 on the urban fringe, Courteenhall Estate has a feeling to it which harks back to yesteryear, with many similar properties having fallen by the wayside.
The estate and house which is made residence by Dr Johnny Wake DL ARAgS, was listed in the Domesday Book and has been owned and occupied by the Wakes since 1672, with the family having been recorded as being in the area since 1200s.
These days, the estate has gone from being a purely arable farming operation to one which has added beef and broiler chicken production with cattle grazing 120 hectares (296 acres) of parkland. The farm is made up of 865ha (2,140ac) in one block, while a further 1,220ha (3,000ac) is also owned in Norfolk. Paul Deacon works as the estate’s livestock manager and has worked at Courteenhall for the last 10 years.
Johnny took over the running of the estate nine years ago from his father, and in this time has seen the business increase its stewardship activities, widen its arable rotation, minimise tillage and use the poultry muck as a replacement for bagged nitrogen.
As part of the new Higher Tier stewardship application, the estate’s parkland is being restored and managed. This saw an opportunity, with the help of the Rare Breeds Survival Trust, to reintroduce the Traditional Herefords that have a rich history on the estate. There are also additional benefits of keeping a docile breed.
Last March, the estate saw the first of these cattle arriving back onto the

Having previously kept Herefords in the 1950s, Northamptonshire’s Courteenhall Estate has again made itself home to the breed, and sticking to its origins, is pursuing a future in Traditional Herefords.
Principally, the foundation females brought-in at Courteenhall in the modern day feature the Julia and Curly families which go back to the Vern herd of Captain de Quincey; the Silvers from Stacey Jones’ Penatok herd; Gaymaids from Arkwright’s Hampton Court herd and the Venus family which traces back to Tudge’s Beauties from Adforton, Herefordshire.
estate. Paul contacted the Traditional Hereford Breeders’ Club, and made contact with Patrick and Esther Lynn of the Hockerwood herd and bought seven females available at the time, varying in age.


Next came the bull, in the form of Albany Lone Ranger, bred by FW Cook and sons of Cambridgeshire and had placed fifth in its class in the 2021 National Hereford Club virtual show, and joining it were four Albany-bred females.
This bull had sired three registered calves at Albany by the age of 18 months, having worked from nine months old, and breeder Les Cook says it lost no condition as a result.
Lone Ranger carries a double cross of Albany’s L family which descends from AP Turner’s Leen herd where it was
known as the Wigmore Grange tribe within Turner’s herd, presumably as the first of these females had originated from Wigmore Grange of John Galliers. Joining the herd next were seven purchases from Helen and Ian MacLeod’s Carpenters herd.
Following this, the inaugural Grass Masters sale run by the Traditional Hereford Breeders’ Association held online in July 2022 and saw the purchase of maiden heifer Carpenters Lavender 2nd. A daughter of renowned
Shefford Monarch bred by Paul Carter, it sold at £1,225.
Now, Courteenhall is home to 26 females which roam the estate’s grassland, and when in front of the main house, form a quintessential English countryside scene.
The estate hopes to increase the herd over the next few years to reach 50 head of cattle. Due to the size of the parkland and pasture, a flock of sheep may also be added to the park. Again, the Rare Breed Survival Trust will be consulted to
The farm is also home to seven separate photo-voltaic arrays to save on electricity, two solar-thermal arrays, four air source heat pumps and 16 ground source heat pump systems. An amount of rainwater harvesting also takes place.
Community is central to the vision for Courteenhall. The team works hard to create bridges by hosting events like Open Farm Sunday, charity fundraisers and the HomeStart Daventry and South Northants and TRUST programmes, which it also sponsors along with local sports teams. Education is an area of major focus, with very close relationships and regular visits from the two neighbouring primary schools.
The estate is also a wedding and events venue with the parkland and hall taking centre stage.
Courteenhall grows broiler chickens and is home to approximately 350,000 birds which employs three team members, selling to Avara at Brackley. Compound feed is bought-in for the birds but they also make use of their own wheat. Courteenhall also has a number of commercial units which house a wide range of businesses from physiotherapists to aggregate suppliers.
establish the best breeds for the land and requirements of the business.

Also in-line with the stewardship scheme, a lot of fences are being replaced and hedges laid, which will allow for the cattle to graze a more expansive area, including those fields
returning to parkland from arable rotations.
With regenerative farming now at the core of the farming policy, the next move, once the cattle numbers are up and the fences are secured, is to adopt a system of mob grazing, which Paul
• 120ha (297ac) parkland
• 140haha (346ac) legume mix
• 416ha (1,030ac) arable cropping –beans and wheat
• 350,000 broiler chickens
• Wedding and events venue
• Renewable energy sources
• Commercial and residential property
explains will operate in one big circle rotating around the main house. The cattle are checked every day and Paul says they needed something that would be outside all year round with the herd out-wintered and not supplementary fed. Cattle take longer to finish on a 100 per cent grass-fed diet, but it is very achievable, he says.
He adds: “They are easy care, with lower inputs and lower output.”
The herd calves all year round and calves are weaned at seven to eight months with bull calves castrated with a ring and disbudded.

The estate employs a team of 21, with some housed in estate properties, including some members who help Paul when it comes to moving cattle and other jobs which require more than one person.

Courteenhall is a founding member of the Tove Valley Cluster Farm Group, which sees local farmers working together to help sustain nature on a landscape scale. The estate has calculated its carbon footprint with conventional calculators and is just completing the first round of measurement using a new system of artificial intelligence and ground truthing with Ecometric.
Beef is to be sold through The Ethical Butcher, a business which carries a great amount of emphasis on traceability.
Paul says: “We are members of Pasture for Life and are working to become certified.”
The Courteenhall herd was originally started by Johnny’s ancestors. Back then, the foundation females carried a lot of Tarrington, Atok and Vern blood.
In 1953 Major Wake bought the joint top price bull, Marlow Attlee, for 400gns at the society’s show and sale at Hereford in April. It was a grandson of the then well-known bull Tarrington Debonair and had stood second that day in a class of 49 entries.
FW Cook and son’s journey from Cambridgeshire was made worthwhile as they won champion Traditional Hereford at the Royal Welsh Spring Festival.


As the Royal Welsh Spring Festival returned to the showground at Llanelwedd, Albany Laramie from FW Cook and son, strode into the champion position concluding the Traditional Hereford class judging, making the long trip from Fen Over, Cambridgeshire worthwhile. Born in February 2020, this young female is by Albany Lincoln and out of Albany Lilypad, a daughter of Boresisle Mentor.
Judging was Herefordshire’s Clive Davies of Westwood Herefords. Clive described the champion senior heifer as ‘long, fleshy, carrying clean lines’.
He placed Caebach Unity Amorous from N and R Johnson, Caerphilly into the reserve supreme and reserve female position. April 2021-born, it is by Caebach Sydney which was reserve male champion on the day. It is out of Rhydri Cashmere Amorous, a daughter of Baytal Jack.
Clive described the reserve supreme as ‘impressive for her strong spine, excellent hind leg shape and breed character’.
Having nipped across the border from Worcestershire, Helen MacLeod was presented the male champion title for home-bred bull Carpenters Morgan.
By stock bull
Shefford Monarchbred by Paul Carter, it is three generations
from Free Town Kendal which sold for 17,000gns in 1976. This two year old bull is out of Carpenters Venus 4th which is by Llandinabo Zest which was born in 1999.
Adding another title to the day’s rewards for breeders N and R Johnson was three year old bull Caebach Sydney. This bull is out of Rhydri Laura which goes back to the Westwood Laura line which itself came from the Shucknall herd many years ago.
Commenting on the stock in front of him, Clive said: “The standard was high, uniform and pleasing. The classes had sound, practical and functional animals. It was good to see cattle of useful

Topping the Grass Masters online sale of Traditional Hereford cattle was Albany Laramie from FW Cook and son, Cambridgeshire, selling for £2,600. The supreme champion from this year’s Royal Welsh Spring Festival, this Albany Lincoln daughter sold in-calf to Willow Grange Louis and moves to Nottingham to join the Lynn family’s Hockerwood herd. Also selling from the Cook’s Albany herd was Albany Prettymaid 30th, another Lincoln daughter with the hammer falling at £2,200 to Louise Thompson-Ball, Yorkshire.

Leading the bull trade was Carpenters Morgan from I and H Macleod at £2,000. Taking male champion at both the Royal Three Counties Show and the Royal Welsh Spring Festival, this bull will be employed as a new herd sire for Jon Francis of Paddock Farm Butchery, Warwickshire and joins females previously bought from the Macleods. From the same stable, Turnant Gaymaid 3rd, a 2018-born cow bred by R Clare, Herefordshire sold for £1,525 with its bull calf-at foot to Janet Tibbenham, Brecon. Following closely behind was two-yearold bull Aeron Leon from J Cockburn, Ceredigion, selling at £1,500. This April 2020-born bull makes a short trip to join Miss E Clarke’s Clarkedale herd, also in Ceredigion to be a new stock bull.
The only lot on offer from Carolyn Redmayne was Gavelock Sarah, another daughter of Albany Lincoln. This yearling heifer joins the sale leader and travels to Hockerwood herd, Nottingham at £1,500. Also joining the Lynn’s herd was Albany Lumen, the first lot in the ring with the virtual hammer falling at £1,475. Lumen is sired by Gavelock Dudley, itself a son of Boresisle Lawrence, a prolific sire of many successful breeding and show cattle.

The final lot to sell was another from the Carpenters herd of I and H MacLeod, Malvern, Worcestershire. Maiden heifer Carpenters Lavender 2nd, a daughter of renowned Shefford Monarch bred by Paul Carter, joins the newly established herd at the Courteenhall Estate, Northampton, at £1,225.

Stirling
Sunday 5 – Monday 6 February
Dungannon Farmers Mart
Tuesday 14 February
Shrewsbury Auction Centre
Saturday 15 April
Dungannon Farmers Mart
Tuesday 18 April
Borderway Mart
Saturday 20 May
Shrewsbury Auction Centre
Saturday 30 September
Stirling
Sunday 16 – Tuesday 18 October
Dungannon Farmers Mart
Tuesday 5 December
Auctioneers: Denis Barrett
Sale manager: Agri Marketing
Averages: 6 females, £1,754; 2 bulls, £1,750
Secretary: Mrs. Audrey Morgan, Fardre Farm, St George, Abergele, Conwy, LL22 9RT Email: morganfardre@btconnect. com
1. GM Graham GAZANNA (P) Groes Faen Bach, Holywell, Flintshire 07789 797639
2. M Lewis SALBRI Salbri, Amlwch, Ynys Mon hereford@salbriherefords.co.uk 01407 710565 07769 653063
3. G & E Mathews CARNEDDAU
1 Tyn y Coed, Gwydyr, Llanrwst eilldh.h@wernvets.co.uk
4. GH Morgan FARDRE (P) Fardre Farm, Abergele, Conwy morganfardre@btconnect.com 01745 833012 07712 861867
5. H, D & CL Owen BODWYN (P) Cefn du lsaf, Gaerwen, Ynys Mon manonangharad@hotmail.com 07796 508322 01248 422692
6. HOGIA BRYN AWEL (P)
3 Meusydd LLydain, Bryniau Hendre Penrhyndeudraeth, Gwynedd, LL48 6EA 01407 720445 07771 538698
Secretary: Mr. Glenn Pritchard, The Sidings, Station Houses, Tir-Phil, New Tredegar NP24 6ES 07903 021680 gpritcharf@gmail.com
7. HJ Cloke LORD HARVEY’S (P) Glenllwyd, Brecon harveysherefords@gmail.com 01874 636674
8. VB Collins KATHLEA (P) The Paddocks, Upper Kathlea, Abergavenny
9. A & G Crow RHYDRI (P) Pantglas Farm, Rudry, Caerphilly gillian@crowmarketing.co.uk
02920 747720
10. A Davies GELLL (P) Gelli Farm, Hirwaun, Aberdare alungwynd@hotmail.com
01685 811705
11. I Davies CREINOG (P) Meity lsaf, Trecastle, Brecon iwandaviesmeity@hotmail.com
01874 638889
12. JH Evans & Son BWLCHLLYN (P) Dollys Farm, Llanidloes evansdollys@pc-q.net 01686 412694
13. DL Gatehouse CAECOTTRELL Cae Cotterall, Llangorse, Brecon brynlygatehouse@yahoo.co.uk 01874 658302
14. FG Goodall GLENROSE (P) Glyntywarach, Babel, Llandovery barrygoodall63@googlemail.com
01550 720649
15. PE Holtrop GLYN (P) Glyn Farm, Painscastle, Builth Wells peterholtrop@btinternet.com
01497 851622
16. PH James CROSSFOOT Crossfoot Farm, Clyro, Herefordshire crossfootherefords@eral.net 01497 820145
17. WS Jones & Son TYN-Y-COED (P) Tyn-y-Coed Farm, Bonvilston, Cardiff hello@tyn-y-coed-lodge.com 01446 781256
18. DE ED & AL Jones DENDOR (P) Gwastadgoed, Caersws, Powys dendorherefords@btinternet.com 01686 688266 07974 416527
19. J Lawrence and sons BRYNSIDE Bryn Farm, Glascoed, Usk, Monmouthshire 07949110201 mathlawrence7@gmail.com
20. C Lewis & P Parfit HIRFYNYDD Rhys-y-pwllau Farm, Seven Sisters, Neath. cerysannlewis@outlook.com 01634 701321
21. JD Phillips ONNEN Nantyronnen, Sennybridge, Brecon 01874 636677
22. L & A Price TYNLLYNE (P) Tynllyne, Llanigon, Hay on Wye tynllyne@outlook.com 01497 847342
23. G Pritchard ABER-LLIA The Sidings, Railway Goods Yard, Station Houses, Tirphhil, New Tredegar, Caerphilly 07903 021680 gpritcharf@gmail.com
24. T Pritchard BERTHLLWYD (P) Springfield, Hirwaun Rd, Hirwaun, Rhondda Cynon Taff gpritcharf@gmail.com 01685 814582
25. G & S Pryce ANROCH (P) 48 Cardiff Rd, Dinas Powys, Vale of Glamorgan pryce48@hotmail.com 02920 515090
26. T Small CAMLAIS (P) 17 Llys Pencrug, Llandeilo, Carmarthen toby.small@breconbeacons.org
27. L Smith BWLLFA (P) Bwllfa Farm, Cwmdare, Aberdare lukeandwilliam@yahoo.co.uk 01685 870990
28. Mrs HC Thomas ROSECOTT (P) No 1 Rose Cottage, Verity Court, Cowbridge, Vale of Glamorgan 07874 919227 helenchristinethomas@hotmail.com
29. KTJ Vater & LJ Garratt VATER C/O JCA Vater & Son, Mill Farm, Abergavenny lindagarratt@brooksplace.wanadoo. co.uk 01873 840562
30. IT Williams SCALDING (P) Scalding, Llyswen, Brecon ivorthomaswilliams@gmail.com 01982 560208
31. TDR Williams WINDYCREEK (P) Plaswarren, Clyro, Herefordshire 01497 851642
Secretary: Mrs. Liz Roderick, Bank Farm, Scurlage Castle, Scurlage, Reynoldston, Gower, SA3 1BA 01792 390389 tombankfarm@aol.com
32. L & L Bowen BOWENDU (P) Tydu Farm Nelson Treharris adam@bowencontracting.co.uk 07973 932773 01443 450314
33. R,J and T Chinn CELYNFACH Hollybush Farm, Mathry, Pembrokeshire 01348 831825 tpchinn@hotmail.co.uk
34. D Gibby SARN (P) Bethesda, Narberth, Pembs dafgibbs8@gmall.com
35 Messrs Griffiths PENRHIWGOCH Penrhiwgoch, Ferryside, Carmarthenshire ferrycabin@aol.com 01267 267044 07807 774336
36. The Hean Castle Estate HEAN (P) The Estate Office, Saundersfoot, Pembs david.burnhill@hean-castle-estate. com 01834 813538 07483 150253
37. RA & AW Howell LUNDY (P) Greenway Cottage, Oxwich Green, Gower, Swansea 01792 390170 angelahowellflowerfairy@hotmail. co.uk
38. EJT James CLEDDAU (P) Quarter Park, Martletwy, Pembs suejames18S@gmail.com 07779 917185
39. A John LAX Lacques Fawr, Llanstephan, Carmarthen anthonyjohnlax@hotmail.co.uk 01267 241244
40. R Morgan SANCLER Pentre Farm, St Clears, Carmarthen 07866 047174
41. N Owens MAIRWEN (P). Yr Hafod, Pontyberem, Llanelli, Carmarthen 07843 055888 nigelowens@wru.wales
42. LD & LL Powell BRYNHEATH (P) Rhos Farm, Penpedaorheol, Mid Glamorgan. rhosplastics@aol.com 07769 219379
43. E Rees TREFOCHLYD (P) Trefochlyd Farm, Croesgoch, Pembs euros@trefochlydpolledherefords. co.uk 07817 995903
44. OEM Jones & EM Roberts CYNIN Penparc Farm, Llangynin, Carmarthenshire elizabethmroberts@outlook.com 01994 231460 07813 902380
45. TDJ Roderick BRANGWYN (P) The Bank Farm, Scurlage Castle, Gower tombankfarm@aol.com 01792 390389
46. DC Smith & Son LAXFIELD Blaenffynnon, Talog, Carmartheshire s.701smith@btinternet.com 01994 484765 07966 053606
47. AJ, AE & MG Thomas PREMIER (P) Clyncemaes Farmhouse, Clarbeston Road, Pembrokeshire premierpolledherefords@gmail.com 07809 622168
48. G Thomas CHURCH VIEW (P) Church View, Mathry, Pembs glynn_thomas@btinternet.com 07811 356145
49. TG, El & EN Thorne STUDDOLPH GLENVALE ASHDALE (P) Studdolph Hall, Milford Haven, Pembs. ionwy.thorne@hotmail.co.uk 01437 890240
50. J Twose BECA (P) Maenhir Farm, Login, Carmarthenshire. josephtwose@hotmail.co.uk 07870 269738
51. R Welch FALCONDALE (P) Bryneinon Fm, Pumsaint, Carmarthenshire. bryneinon@aol.com 01558 650200
The summer of 2022 saw the return of a normal show season, with some healthy competition within the Dyfed Hereford Breeders' Club.
Firstly I feel it’s a privilege to be elected chairman of the Dyfed Hereford Breeders Club. I have been involved with Herefords for quite a number of years, firstly with my uncle’s Kingshall herd then Kilvrough and now our own small Lundy herd.
The first year of my chairmanship was dominated by the Covid pandemic so the club had quite a quiet year although we did manage to hold the herd competition. The year 2022 started on a much better note with things slowly retuning to normal. Most of the shows in our area re-started and exhibitors were glad to be back. It was good to see breeders from the extreme east of our
region taking supreme honours at the Royal Welsh and as such congratulations must go to Paul and Vicky Moyle of Porton House Herefords.
My congratulations must also go to all the breeders in the club’s area that supported the local and national shows and sales throughout the season. Good luck with your cattle in the coming year.
The Dyfed Hereford Breeders' Club AGM was held a bit later in the year than usual,


but the weather couldn’t have been better for their visits to the Brynheath and Bowendu herds in Glamorgan. The Powell family welcomed the club with teas and coffees and plenty of cakes before visitors walked around the Brynheath herd, where they met Spartan 1 Polly T122, which took many show successes this summer. The herd quietly grazed in lovely surroundings.
It was a short drive before another warm welcome awaited the club from the Bowen family. The Bowendu herd
grazed in picturesque surroundings and club members saw numerous past and present show champions.
Members clearly enjoyed the herd visits, but it was soon time for the annual general meeting which the Bowen family provided a great venue for.

It was a very successful day. Thanks must go to the hosts who also took members out for a pub meal to finish up a great day.
Following the year 2022, it is also great to see the local shows back and members out supporting them.
Supreme and male champion, Penrhiwgoch 1 Progress 483T, Messrs Griffiths
Supreme and male champion, Penrhiwgoch 1 Progress 483T, Messrs Griffiths
Female champion, Penrhiwgoch 1DS
Lass 564, Messrs Griffiths
Supreme and male champion, Penrhiwgoch 1 Progress 483T, Messrs Griffiths
Female champion, Penrhiwgoch 1 DS
Lass 564, Messrs Griffiths
Supreme champion, Glenvale 1 Angela 767, TG, EI and EN Thorne
Male champion, Glenvale 1 Goldfinger, TG, EI and EN Thorne
Heifer, 1st, Glenvale 1 Angela 767, Thorne Family; 2nd, Cleddau 1 Dainty Stacey, Eifion James; 3rd, Cleddau 1
Amethyst Lottie 2nd, Eifion James
Bull, 1st, Glenvale 1 Goldfinger, TG, EI and EN Thorne, 2nd, Ashdale 3 George, TG, EI and EN Thorne
Bull calf, 1st, Cleddau 1 James, Eifion James
Supreme champion, Bowendu 1 Isabella Rose, L and L Bowen; reserve, Spartan 1 Polly, T122, LD and LL Powell
Cow and calf, 1st, Bowendu 1 Isabelle Rose, L and L Bowen; 2nd, Brangwyn 1 Kerry Maid and Brangwyn 1 Willow, TDJ Roderick; 3rd, Brangwyn 1 Pearl and Brangwyn 1 Wyndam, TDJ Roderick
Maiden heifer, 1st, Spartan 1 Polly, T122, LD and LL Powell; 2nd, Bowendu 1 Lucy, L and L Bowen; 3rd, Bowendu 1 Jennifer, L and L Bowen
Heifer calf, 1st, Brangwyn 1 Willow, TDJ Roderick
Bull calf, 1st, Brangwyn 1 Wyndham, TDJ Roderick; 2nd, Brangwyn 1 Woolsey, TDJ Roderick
Senior bull, 1st, Porton House 1 Rhydian, LD and LL Bowen; 2nd, Studdolph 1 Attribute, TDJ Roderick
Supreme champion, Sancler Oyster 5th, Rob Morgan; reserve, Cleddau 1 James, Eifion James
Heifer, 1st, Sancler Oyster 5th, Rob Morgan; 2nd, Cleddau 1 Dainty Stacy, Eifion James
Junior heifer, 1st, Cleddau 1 Amethyst Lottie; 2nd, Eifion James; 2nd, Cleddau 1 Miss Milly
Bull calf, 1st, Cleddau 1 James, Eifion James Young handlers, Eifion James
Supreme champion, Glenvale 1 Polly 764, TG, EI and EN Thorne; reserve, Glenvale 1 Angela 767, TG, EI and EN Thorne
Senior male champion, Penrhiwgoch 1 Progress 483T, Messrs Griffiths
Junior champion, Glenvale 1 Fanfare, TG, EI and EN Thorne
Bull born before Jan 2021, 1st, Penrhiwgoch 1 Progress 483T, Messrs Griffiths
Bull after Jan 2021, 1st, Glenvale 1 Fanfare, TG, EI and EN Thorne; 2nd, Beca 1 Viking, Joseph Twose; 3rd, Glenvale 1 Farmer, TG, EI and EN Thorne
Senior heifer, 1st, Glenvale 1 Polly 764, TG, EI and EN Thorne; 2nd, Glenvale 1 Angela 767, TG, EI and EN Thorne
Junior heifer, 1st, Beca 1 Jubilee Vogue, Joseph Twose; 2nd, OEM Jones and EM Roberts; 3rd, Sancler Oyster 5th, Rob Morgan
Heifer calf, 1st, Studdolph 1 Barbie 833, TG, EI and EN Thorne; 2nd, Studdolph 1 Pearl 837, TG, EI and EN Thorne
Show herd of the year, 1st Penrhiwgoch, Messrs Griffiths
Show female of the year, Glenvale 1 Angela 767, TG, EI and EN Thorne
Show Male Of the year, Penrhiwgoch 1 Progress 483T, Messrs Griffiths
After winning the Dyfed Hereford Breeders' Club’s herds competition in 2021, the task of judging the 2022 competition fell to Euros Rees of Trefochlyd Herefords.

He commented: "I knew it would be a daunting job, but it proved to be much more difficult than I thought.
"Our club is full of top-class cattle and choosing between them was incredibly difficult. But I relished the challenge and enjoyed the experience, I was overwhelmed by just how many great herds we have in this part of Wales."
Overall herd winner, Studdolph/ Glenvale/Ashdale
Best new herd, 1st, Mairwen, Nigel Owens; 2nd, Rectory, Peter and Wendy Williams
Large herd, 1st, Studdolph/Glenvale, Thorne Family; 2nd, Hean, Hean Castle Estate

Small herd, 1st, Beca, Joseph Twose; 2nd, Bowendu, L and L Bowen
Best bull calf, 1st, Mairwen 1 Emrys, Nigel Owens; 2nd, Penrhiwgoch 1 DS Progress 631, Griffiths Family
Best heifer calf, 1st, Glenvale 1 Polly 842, TG, EI and EN Thorne; 2nd, Hean 1 Doris 192, Hean Castle Estate
Best cow and calf, 1st, Hean 1 Liberty840 with calf Hean 1 Libert 241, Hean Castle Estate; 2nd, Penrhiwgoch L1 Achiever Ladylike 103 with calf

Penrhiwgoch 1DS Progress632, Griffiths Family
Best stock bull, 1st, Dendor 1 Sugar Ray, Nigel Owens; 2nd, Solpoll 1 Superduty, Hean Castle Estate
Best bull calf, 1st, Beca 1 Woverine, Joseph Twose; 2nd, Bowendu 1 Willie, L & L Bowen
Best female calf, 1st, Bowendu 1 Lottie 3rd, L and L Bowen; 2nd, Cleddau 1 Miss Milly 5th, Eifion James
Best cow and calf, 1st, Sancler Diadem 5th with Sancler Diadem 10th, Rob Morgan; 2nd, Brangwyn 1 Nova with Brangwyn 1 Audi, Roderick Family
Best stock bull, 1st, Solpoll 1 Trailblazer, L and L Bowen; 2nd, Boycefield Samson, Rob Morgan


The Dendor name is one of the most well-known names in pedigree Hereford cattle breeding, both in Wales, and across the UK.
But as a hardy breed with great foraging ability and other priorities on the upland farm, the Dendor herd of pedigree Herefords is run with commerciality and functionality at its core.
Laying the foundations to today’s success were Denis and Doris Jones who started as dairy and pig farmers. Doris had moved from west Wales and lodged at The Graig near Llanfair Caereinion which was home to Herefords and here an interest and affiliation with the breed was sparked.

The iconic red and white breed first made its way to Gwastadgoed, the home farm situated in Llanwnog, Powys, in the early 1960s. Initially breeding under the Gwastad name, Denis and Doris Jones would purchase Hereford cows with bull calves at-foot, with focus put on the quality of the calf rather than the dam as long as it had plenty of milk. The young bulls were then sold on at 12 months of age.
After becoming society members in 1963, success was had with the horned cattle, but it wasn’t until the late 1960s that considerable numbers were built up. In 1974 with favour turning towards the poll strain of the breed and with Denis’ eye on the commercial market, bull Wayland 1 Harrow was purchased and an amalgamation of Denis and Doris’ names was adopted, hence the Dendor name.
Alongside the Herefords, an interest in baby beef was gaining momentum and the family were some of the first
The Dendor herd has been consistently successful in the show ring for a number of decades but at home on the Jones’ upland farm, these cattle have to perform in the family’s commercial system.
to exhibit in the section at Bingley Hall and a dozen cross-bred cattle would be exhibited at the English and Welsh Winter Fairs.

These days, it is Denis and Doris’ son Aled and wife Jen who are the custodians of the Dendor ship, along with their three sons Guto, Twm and Ianto and Aled’s sister Sian. After 30 years of living in this picturesque area of Montgomeryshire, Jen has not lost her thick Australian accent, and having bred poll Herefords at home, she worked for various well-known breeders while travelling the UK as a youngster before settling in Llanwnog and marrying Aled in 1991.
Attracting visitors and buyers from all over the country, Gwastadgoed consists of 142 hectares (350 acres) with some additional rented ground. The farmhouse and yard sit at 200 meters (650ft) with ground running to 365m (1,200ft).
With 40 inches of rain a year and not a great depth of soil, the farm is all down to grass and despite being some of the best genetics within the breed, these cattle have to hold their own and compete against the commercial sheep flock for both grass and their breeders’ time.
It was the late 1980s and early 1990s when the Dendor herd really began to build its reputation, with thanks given to bull Costhorpe 1 Destiny purchased in 1988, bred by Harry Coates, Leicestershire.

Aled explains: “We were doing well but Destiny just lifted the standard of the whole herd. He was a beautiful, big bull and gave our cows terrific amounts of milk. I saw him in November and bought him in the January of 1988 at the society sale at the old Hereford market.”
Being just an hour north from the showground in Llanelwedd, the Royal Welsh Show has long been the Jones’ shop window. They first competed in 1969 where classes were consistently 15 to 20 entries strong and have since only missed the shows of 2001 for foot and mouth, 2010 when Denis judged the native group of three interbreed and these last two Covid years.
Aled says: “Every year at the Royal Welsh we are in the same place in the cattle lines. People know where we can be found and it is a great opportunity to catch up with commercial buyers both new and old, while finding out how our stock has been doing for them. The Winter Fair is the same. People can come by and have chat and a good look at what we have on offer.”
In recent times, Twm and partner Hannah Jones are often seen in the ring, but all three boys play their part in producing and turning out the family’s cattle.
Despite starting by collecting small numbers of females from different breeders in the early days, the Dendor type is now well-established and recognised by many and 50 females now make up the herd. When it comes to females, the family opt for femininity, moderate size and they must have good amounts of milk. At Dendor, plenty of emphasis is also put on length of neck and broadness of muzzle to allow the animal to work as efficiently as possible, being a working grazing animal.
Aled adds: “I like nice dark coloured cattle, with a good coat quality. I think a lot of people forget the coat these days.
Supreme champion: 1995, 2002, 2003, 2005, 2008, 2012
Reserve supreme: 1995, 1996, 1997, 2000, 2014, 2015
"I want a white neck, white crest and white socks.”
The last female to be bought in to the herd was in 2002 from Northern Ireland’s Colin Christie’s Seaconpoll herd, so all dams are home-bred. Each year, eight to 10 females are sold, or more if required. The Designer Genes sale of 2021 staged at Shrewsbury Auction Centre saw the family yield their highest sale price to date where Dendor 1 Ruby 37th sold for 10,200gns to Lyn and Leslie Bowen, Nelson, Glamorgan to join their Bowendu herd.
Despite the success of the Ruby females, and also the Jennefer line in the show ring, Aled says there are no favourite cow families or best performing lines.
“They are all doing a job – they wouldn’t be here if they weren’t,” he comments. Calving takes place in September to October outside, and again in March and April when housed, before being turned out in May with their calves. At present, two home-bred bulls and Pepperstock 1 Trigger purchased from Speirs Farms, Luton are running with females.
Aled says: “We opt for bulls with good locomotion and feet, and I like them to look like a Hereford should. We need weight for age and I will always try and see the mother of a bull or any offspring before I make a purchase.”
With that said, two important bulls at Dendor in recent years, Bakgard 1 Keno and SMH Euro, were purchased from Jens Michael Jensen from photographs
and imported from Denmark, with Aled commenting the UK gene pool can at times be narrow.
Heifers are served at 20 to 21 months with natural service preferred and Aled says they have had very little success with embryo work. Now with a more readily available AI technician and the need to find different genetics, some AI work was carried out in the autumn, with the 2007-born Romany 1 Distiller as the sire of choice.
Aled adds: “We try and get heifers with calves out first on to grass to help them get on and produce plenty of milk with compensatory growth coming into play after being on just silage and straw when inside.”

The family breed their own whitefaced Welsh mules, consisting of a Welsh ewe cross Fronteira, which is a Texel cross Blue Faced Leicester bred by the Ingram family of Logie Durno fame. The Durno, made up of a Charollais cross Texel is then put to these ewes to produce fat lambs selling to Tesco as part of their producer group, being killed at Kepak in Merthyr Tydfil. Mule ewe lambs are put to a Charmoise, with the hope that the resulting lambs will make up for any losses in the main flock.

Mule ewes and ewe lambs lamb inside while the Welsh are brought down to lower ground to lamb.
Calves are creeped at three months of age until they are weaned at eight or nine months, or longer if they are on the hill.
“Whether its calves or lambs, I don’t mind creep feeding them while they are young as it is then that they take the most benefit from what is in front of them,” he says.
It is the sheep which have priority when it comes to grazing, with spring grass utilised by ewes feeding young lambs to meet the early trade and the end of the season’s grass used to flush the ewes. On a farm unable to grow huge amounts of grass due to a lack of soil depth, the Herefords with their easy-doing foraging
The farm is also home to a six bed holiday let, Solitude, which can sleep 14 people and is very popular with those looking for a quiet getaway to this area of mid-Wales.
nature mop up behind the sheep flock. With arable production also unviable, all feed and straw is purchased, with a 16 per cent protein reared blend opted for the Herefords.

Out of all bull calves born, 80 per cent will be sold for breeding, with many heading to the milk fields of west Wales, north Shropshire and into Cheshire. Cattle which don’t make the grade for breeding are killed and packed as boxed beef, producing a carcase of 340 to 350kg.
Jen says: “We don’t advertise our beef, we just have a steady flow of customers who keep coming back to us. They always say how much tastier the Hereford is.”
She adds: “We wouldn’t sell anything for breeding which we wouldn’t be happy to use ourselves. We have a great customer base with a good amount of repeat customers including one person who is now only on his third bull in 30 years.”
Aled and Jen say their best year at the Royal Welsh, and their greatest success in the show ring to date, came in 2018. It is believed the breeders were the first to win the coveted Fitzhugh Pairs Trophy with the Hereford breed and only the second pair in the cup’s history to be exhibited by the same breeder.
“Winning the Fitzhugh was the best show win we have had by a country mile,” says Aled. “Winning the National Poll Show with Dendor 1 Nairobi in 2018 was also
• Dendor 1 Vivian
• Dendor 1 Vernon
• Pepperstock 1 Trigge
• 142 hectares (350 acres) owned grassland, plus some rented
• 50 pedigree Hereford females
• Herd established in 1963
• 800 ewes – both Welsh Mountain and home-bred white-faced Welsh mules
• Ground rising from 200 metres (650ft) to 365m (1,200ft)
• Boxed Hereford Beef scheme
memorable, but the Fitzhugh just stands out for us.”
With three enthusiastic boys at Gwastadgoed, the future looks bright for the continuation of the Dendor poll Hereford name, and with the cost of feed soaring, coupled with a shortage of labour for farms across the country, Aled comments the future for the docile, easy doing Hereford looks equally as promising.


Aled & Jen Jones– 07974416527
Twm Jones– 07896475340
Dendorherefords@btinternet.com
We look forward to the first calves by Vernon and Vivian in 2023.
Sired by Moonshine out of Holly 10th. Moonshine was Supreme Champion and Junior Interbreed Champion at the 2018 Royal Welsh Show. Holly 10th is sired by the 2017 Royal Welsh Champion Keno. She has been an excellent breeder with her 2022 born bull calf, sold to Bonlea Herefords in the Republic of Ireland.


Sired by Nairobi and out of Echo 28th. Nairobi is a son of 'Orkney' out of the 2014 Female of the year 'Molly 41st. 'Nairobi' won the Supreme Championship at the 2018 National Poll Show. Echo 28th is an exceptional daughter of SMH Euro, Echo 28th also bred Triple H stock bull at Allwood Herefords.
Thank you to all purchasers & a massive congratulations to all the exhibitors of Dendor bred stock shown in 2022.
 Dendor 1 Vivian
Dendor 1 Vernon
Dendor 1 Wilson – Sired by Gouldingpoll 1 Moonshine
Senior Male Champion @ Agri Expo 2022
Dendor 1 Anna Mary 44th – Sired by Dendor 1 Trigger
Dendor 1 Vivian
Dendor 1 Vernon
Dendor 1 Wilson – Sired by Gouldingpoll 1 Moonshine
Senior Male Champion @ Agri Expo 2022
Dendor 1 Anna Mary 44th – Sired by Dendor 1 Trigger
Members of the Powys Hereford Breeders’ Club are enjoying time together even more following the pandemic.

Powys Hereford Breeders’ Club activities kicked off in May where they attended the RWAS Spring Festival with the promotional stand. An enjoyable weekend was had by all where new members were gained. The club extends its warmest thanks to those who came along to help out with manning the stand.

Finally after a couple of years of little or no activity due to the pandemic, the club got back to some sort of normality which was a great relief to everyone. It was wonderful to meet up with members and friends new and old and made members realise how important and enjoyable the club get togethers are. Club activities kicked off in June
where two teams were entered into the National Hereford Stockjudging Competition at the Royal Three Counties Show. The teams were made up of Helen MacLeod, Caleb Vater and secretary Glenn Pritchard while the other team
consisted of Luke and Laura Powell and Ieuan Block. Out of the many teams entered, Luke, Laura and Ieuan were placed fourth, which was a fantastic achievement considering it was Ieuan’s first ever competition. Summer shows

were back in full flow and although cattle numbers were slightly down it was great to see members out there parading quality Herefords and showing the breed can compete with and hold their own against any other breed.

This year the annual general meeting, barbecue and herd visit were held on the same day, kindly hosted by the Lawrence family of Brynside Herefords near Usk. With over 50 members in attendance, it was a fantastic day where everyone thoroughly enjoyed lovely cattle, surroundings and food and the Lawrence family must be thanked for all the hard work and hospitality they showed the club.
October brought the annual Sunday lunch and presentation of awards which was again held at Rhosgoch Golf Club. This very well attended event lets the club recognise members who have excelled throughout the year but a special mention must go to
the younger members who are really pushing the club forward.
Tom Pritchard won the YFC Hereford stockjudging competition at the Royal Welsh Show and Emma Jones won the YFC Floral Art Competition. The club is gaining more members annually thanks to the hard work of officers and members alike, with a Facebook page (Powys Hereford Breeders Club) and an email address (powysherefordbreeders@gmail.com ) up and running.

Powys herd of the year winners 2021, Shannon and Matthew Lawrence, Brynside
Powys herd of the year runners-up 2021, Linda Garrett and Kristian Vater

Easts of Brecon has occupied the town’s high street shop for 34 years, and is now run by James East, the sixth generation in a long line of butchers.
With a passion for quality beef, the Hereford takes pride of place in James’ business and on entering the shop, customers are met with an impressive display of meat, the beef being particularly eye-catching, and once you start looking around the shop there seems a common theme. The butchers all wear Hereford ties, the shop is lined with pictures of the red and white cattle and there is a white crest on the red hide which hangs over the staircase leading to the cutting room beneath.
With three supermarkets and two other butchers in the small town, Easts have to do something to make them stand out from the competition, and the level of skill of butchery on show in the shop’s counter cannot be denied. James remarks ‘there are butchers and then those who sell meat’, and this is clear to see which category this business falls into.
The East family set up their butchery legacy in 1910, having originally started out in a shop in the village of Llangorse, some seven miles west of Brecon, but had to leave an unsuitable premises and increase their passing trade. It was the sale of one of the 11 Victoria Crosses awarded following the Battle of Rorke’s Drift of 1879 in the Anglo-Zulu war following the death of family member Robert Jones which raised the funds to initially set up the business.
Having studied at the Royal Agricultural University at Cirencester, James returned to the butchery in 2008. While growing up, James’ father had a small number of store cattle and James says he could see they were quiet and as such, he always wanted to keep the breed himself.
Going back another generation, James recalls that his grandfather Bob would

The passion for the Hereford breed is evident as soon as customers step into Easts of Brecon butchery.
state even ‘if a donkey was crossed with a Hereford, you would still have good beef’.
To keep a steady supply of Hereford Beef into his shop, James purchased stores as well as cows and calves out of Hereford market initially being both registered and pure-bred.

He says: “The beef has a huge following here. We sell two bodies over the counter each week and it gives me a great deal of satisfaction. T-bones are our signature steak, but ribeyes and sirloins are also very popular.
“I have plugged Herefords for years,” he says. “I promote Hereford Beef on Facebook, I always put the kill tags out to show the traceability and also promote it on our shop blackboards.”
A bull was purchased at two years old from RA Bradstock and partners, Tarrington, Herefordshire over Sell My Livestock with James saying he doesn’t have the time to attend sales anymore. Many of James’ cattle are horned which he says wasn’t an intentional move, but rather just the cattle which were available to him at the time.
“I get great satisfaction when someone comes in and says the steak they bought was the best they’d ever had."
James says: “Hereford Beef is very soft, with a very fine grain. Our Hereford Beef is slower grown and so the muscle make-up is different. Any product which is slower grown is better. The beef also benefits from having been fattened on grass.”
The style and cuts available in the shop today are more like the butchery style of his grandfather’s era, remarks James.
“The high street butcher was dying when I came home,” says James. “No one in Brecon would have seen some of the cuts we now provide for years.”


Further to the busy town centre shop, James also runs a sizable wholesale and catering arm to his business, servicing 50 wholesale customers. Here, he is selling 30 carcases worth of lamb, six pigs and 300 chickens. Each week he also buys in vast quantities of rumps and loins of beef for his customers.
Lambs are killed at Neil James’ in Raglan, Monmouthshire and cattle slaughtered
at Maddock Meats in Maesteg, Glamorgan.
James explains that he believes people buy a product based equally on its price, the product itself and the name behind it, and in turn he is trying to bolster all three elements of his marketing mix.
To fulfil the quantity of orders, there are 11 people working out of the shop despite its small size, along with one full time and one part time driver ensuring the wholesale deliveries are made.
Among his own cattle, James opts for a smaller, more Traditional sized carcase and as such keeps smaller cows.
James explains the wholesale and shop business require two different carcases. He says 400kg is ideal for servicing the catering trade but 300kg is really the sort of carcase weight a butchers shop requires.
Calving takes place from May and goes through until July. Cattle are killed at 26 to 29 months and are only supplementary fed in the last month of life.
James comments: “I like to keep things as natural as possible. The cows calve outside and are given as little concentrates as possible. "
James still operates in a traditional manner and has judged the Christmas fatstock market at Brecon twice, while staff member Jules Tunnicliffe judged the pre-sale show in 2021, and on both occasions Herefords have done well.
The business has also bought out of the Winter Fair at Builth.
Meat quality is key to Easts’ operation
• Family trade since 1910
• Sells two Herefords each week in the shop

• Wholesale business servicing 50 customers
• 11 employees
and when it comes to hanging, the forequarter of the animal will be processed within a fortnight, while the rest will hang from four to six weeks.
James believes butchery has become an undervalued and unappreciated skill. He says: “There is a distinct lack of training facilities or education centres for food-based skills unless it is catering. As a result, the standard of workmanship in the butchery industry is often poor.”
With an appreciation for quality meat and the skills required to provide this product, the future of Easts of Brecon looks safe for the next generation in James’ hands, in which Hereford Beef is set to play a major part.



To secure his first farm tenancy, Will McFarland suggests he would happily have travelled to the moon.
But, as good fortune would have it, he was spared that journey through space to milk cows in a lunar landscape when he was offered that opportunity in Pembrokeshire.
The 89 hectares (220 acres) coastal farm and a grazing agreement for 809ha (2,000ac) on a nearby military firing range have been his passport to farming in his own right.
His wife, Sophie, a clinical psychologist, shares his passion for a county renowned and envied for its grassbased farming systems.
“I will live and die in Pembrokeshire,’’ she declares.
Will came to farming with but a distant link to the industry. His ancestors had farmed in Northern Ireland but his grandfather left the family farm at the onset of the Second World War, thereby severing that immediate link to agriculture.
He grew up in an urban environment in Stourbridge but that innate desire to farm had filtered down through the generations with Will studying agriculture at Harper Adams University before starting his career in the industry working in multiple places across the UK and New Zealand.
“I picked up several fantastic mentors in previous bosses along the way,’’ he says.
Will was involved in a contract dairy farming enterprise in Powys when the tenancy at Court Farm, Castlemartin, became available.

Having previously being involved in short term agreements, the opportunity to acquire a 20 year tenancy provided the

When dairy farmer Will McFarland introduced beef sweeper bulls after building up sufficient cow number with black and white sires, the Hereford was his breed of choice.
stability he needed to invest and build up his own business.
“It was quite a big change, especially the financing of it, but I would have done anything to be in the position we are in today,’’ he says.
The grassland farm came with a 24-unit swingover parlour but with little in the way of housing.
What it is blessed with is mostly free draining and fertile soil so establishing a fully outdoor spring-calving system with the herd and the yearling heifers grazing on the Castlemartin Firing Range during the dry period is the route Will and Sophie have taken.
“Because of the grazing conditions on the range it can be difficult to achieve growth rates there all of the time but the extra land has opened our minds to ideas with different stock groups and whether it becomes an outlet for beef production in the future,’’ he explains.
Geofencing grazing collars are currently being trialled on 162ha (400ac) of that land. Both the military and Will are keen to utilise this technology to achieve conservation objectives on the ranges, through establishing optimum conditions for ground nesting birds and protecting rare flora and fauna.
“They have the potential to be a great management tool,’’ he says.
A grazing crop of kale is also grown as feed for the yearling heifers and fodder beet for the dairy cows which consists of a herd of 420 Friesian-crosses.
Cow numbers have increased since the move to Court Farm in 2019, by inseminating with dairy sires and sweeping up with Friesian bulls.
“It was dairy all the way as building up numbers was a priority,’’ Will explains.
In 2022, with the herd size at the target he had set, it was time for a change of policy and a switch to a beef breed.
Will considered many options but it was the Hereford that ticked all the boxes on his list of priorities which began with temperament and calving ease.
“Stock bulls are the biggest risk on a dairy farm and, after having Friesian bulls, above all I wanted an animal with a good temperament,’’ says Will. Calving ease was a very important requirement too, he adds.
“I aim to keep everything as simple as possible and calving ease feeds into
that, especially so for the calves that are being produced at the tail-end of the calving season because the cow must be able to recover as quickly as possible before we start breeding again.
“You have got to have easy calving animals on small dairy cows and we think that the Hereford will give us that.’’
Foot health in the bulls is another priority as the furthest paddock from the milking parlour is two kilometers.
“They have to walk quite a distance but they performed really well on feet and legs in their first breeding season, much better than the Friesians ever did,’’ says Will.
He also saw a significant benefit in producing calves with a very distinct white face.
“Having a calf that is identifiable as a beef calf is important in our system, unlike for example an Angus-cross which can be confused with a Jersey-cross at birth.
“The Hereford stamps its progeny well. You will always be able to pick out a Hereford cross calf.’’

Will had a ready market for those calves too with a buyer who wanted Herefordcrosses adding to his choice of sire.
With the Hereford fulfilling all the principal requirements he wanted from a bull, he bought seven 20-monthold poll bulls in May 2022 from the Thornysure herd at Shipston-on-Stour, Warwickshire.
Heifers are served at 15 months to calve at two years old and breeding got underway on 28 April with one round of AI using dairy genetics followed by a

cycle of beef AI before turning the bulls in with the herd for six weeks.
Will reports an exceptional year for fertility with a submission rate of 93 per cent in the first three weeks and a nonreturn rate of 68 per cent to first service. The empty rate was 7 per cent.
“For us, because we dry everything off in one go, days in milk are the biggest driver of profit for us,’’ he says.
With no infrastructure to produce winter milk and with easy access to the military range, there are limited benefits to investing in housing, resulting in a very defined milking season.
Fertility and a tight calving block are therefore Will’s key performance indicators.
“They just drive the whole system,’’ he says. “A tight calving pattern ensures we achieve high days in milk while maximising grass utilisation.’’
The grazing system is run to traditional extensive grazing principles. The primary aim is to produce as much milk as possible from grass in the grazing season and to outwinter on deferred grazing or forage crops.

Since Will took on the tenancy he has invested significantly in three main areas – in cow tracks and an automatic footbath to promote foot health, in fencing and soil fertility for grazing management, and in gaining labour efficiencies through automatic cluster removal and geofence collars.
During the grazing season he aims for entry grazing covers of 2,700kgDM/ha, grazing down to a residual of 1,500kg.
The summer drought impacted on grass availability in 2022 so the herd was buffer-fed silage at grass to extend the grazing round.
“We don’t have buildings as our ‘get out of jail card’ so we need to make sure we have sufficient covers for the winter, to not leave ourselves short of grass, by decisions we make earlier in the year,’’ says Will.
Three cuts of clamp silage are made. There are no dedicated silage fields and surpluses in the paddocks are cut while around 250 bales of silage are also made, to provide fibre to balance energy and protein in the winter grazing crops. Will shares the farm workload with full-timer, Aaron Maddison, who he describes as his ‘indispensable second in command’, and the previous tenant, Stephen Alderman, who enjoys maintaining his link with farming by helping out when needed. Sophie is also on-hand to help at weekends and when she has time off from work.
While half the herd calved in the first 12 days in the 2022 calving season and the entire herd in 12 weeks, the target has been to reduce that to nine weeks in 2023.
Every beef calf is kept for eight weeks and then sold to private buyers to be reared on.
• Replacement rate: 20%
• Annual average milk yield per cow: 4,800 litres
• Rolling somatic cell count: 190,000 cells/ml
• 4.5% butterfat and 3.8% protein
Calves receive four litres of colostrum as soon as possible after birth and are then fed transition milk for the first four days before being reared on whole milk until they are weaned and sold.
The replacements are reared on at grass. In the first few months they get supplementary feed at pasture but in 2022, beet pulp was trialled and the calves performed well.
As the herd moves closer to drying off, a 10-in-7 milking system replaces the normal twice a day pattern.
“We had tried once a day milking but we found we lost too much milk yield so we introduced 10-in-7 for the first-time last year from the start of October and it worked really well, the milk loss was negligible,’’ Will explains.
“It helps the cows to maintain their condition in the run-up to calving and, with fewer milkings, there is less stress on foot health too.”


Only having been members since 2016, this new herd has been gaining momentum on the show scene in recent times, with this heifer already winning reserve champion at the Royal Three Counties this year as well as reserve champion at North Somerset. Born in March 2021 out of foundation cow Dendor 1 Lilac Wine 28th, the champion is a daughter of Panmure 1 Nugget which also has had success at Builth, standing senior and reserve male champion at Royal Welsh Show in 2019. From here, this heifer will head to Burwarton and the National Poll Show.
On the Thursday of the show, the heifer also teamed up with Harveybros 1 VaVa-Voom and Sky High 1 Miss Allure to stand reserve in the group of three interbreed.
Standing in reserve in both the supreme and female championship was Moralee 1 Pippa KS S11 from Tom and Di Harrison, Mickley, Northumberland having won the senior cow class with five month old bull calf Moralee 1 Wynne SO270 atfoot, sired by Auckvale 1 Standout 1891S. April 2019-born, Pippa is another by the prolific SMH King Size 87K which was the 2019 sire of the year and out of Coley 1 Pippa 356 which stood breed champion at the Royal Highland in 2017, a daughter of Australian sire Days Calibre G74. Not a
stranger to the show ring, it was reserve champion at Devon County last year and reserve champion at the Royal Highland Showcase. It went on to stand senior female champion at the 2021 National Poll Show, mirroring the position of its dam Coley 1 Pippa 356 in 2018.

Male champion was found in the form of Buckenhill 1 Trans Am from Matthew Gray and Louise Crowther who had crossed the border from Bromyard, Herefordshire and started the day by winning the senior male class. January 2020-born and a Cornriggs 1 Knight Rider son, it is out of the Anxiety line at Buckenhill and has already received senior male champion at the Royal Three Counties Show and reserve male champion at the Royal Bath and West.


Junior male and reserve male champion was selected as Harveybros 1 Va-VaVoom from George and Sophie Harvey who had not yet returned to their Balfron home following the Great Yorkshire. Winning the spring 2021 bull class, this March-born bull is by Normanton 1 Laertes which stood interbreed champion on the same ground six years earlier. Out of Harveybros 1 Crocus E2, the only female line at the Harvey’s stable, it goes back to Panmure’s Crocus family and stood reserve supreme while at Harrogate.
The junior bull class was headed up by OEM Jones and EM Roberts, Llangynin, Carmarthenshire with the home-bred Cynin Diezel which also went on to be named reserve junior bull. Although well used to showing sheep at Builth, this was the relatively new breeders first time out in the Hereford ring. Born in June 2021, Diezel is a son of Dyfed herd competition reserve junior bull champion Llangynin Scooby which was bred and purchased from the late Meirion Jones, the family’s next door neighbour and good friend. Meirion always wanted to show Herefords at the Royal Welsh and so the Cynin herd carried out his wish. Its dam is one of the breeders’ best cows, Llangynin Lindy Loo, and carries blood from horned herds such as Free Town, Spinney and Church Preen.
As Matthew moved into the females, the classes got bigger. The January to August 2020 heifer class was led by the May-born Glenvale 1 Polly 764 from TG, EI and EN Thorne. Placed second in its
class at the 2021 National Poll Show, it is by stock bull Vexour 1 Palmer and out of Glenvale 1 Poly 617 which won the senior female class at last year’s Poll Show and Pembrokeshire County.
Spartan 1 Polly T122 from LD and LL Powell, Penpedaorheol, Mid Glamorgan took the red ticket in the September to December 2020 heifer class. After heading up the 2021 Christmas calf show for breeders SC and GL Hartwright, this heifer went through the ring to a top call of 4,000gns to LD and LL Powell. Sired by the 8,000gns Solpoll 1 Perfection, it is out of Ruckmans 1 Polly 1306 and stood reserve breed champion at Devon County and at the Royal Cornwall earlier this summer.
The junior heifer class was another won by Paul and Vicky Moyle with Porton House 1 Jane 2nd. May 2021-born, it is by Dendor 1 Sherlock and goes back to Ashley Moor’s Amethyst female line. It also took the junior heifer class at the Royal Three Counties this year.

The group of three was also won by OEM Jones and EM Roberts with Cynin Governess 4th, Cynin Victory and Cynin Diezel. These breeders will be out at Haverfordwest Show and the National Hereford Show.
Great success was had in the young handlers section for young members of the Hereford breed. In the interbreed young handlers pair, Classic Herefords’ Ollie Garnett-Smith and Cara Doggett who is from New Zealand took the reserve champion title out of 11 teams.
Shraden Herefords’ Melissa Roberts judged the individual handler competition, where in the junior class of 16 years of age or under, Freddie Cloke of Lord Harvey’s Herefords placed sixth in a strong class.

The 17 years and above class saw international visitor Cara Doggett and Elan Thomas take to the ring. Elan placed third while Cara took first place before being entered into the championship where Melissa challenged the competitors by removing their show sticks, concluding in Cara winning overall champion young handler, having also recently taken the same accolade at the Royal Norfolk.

Every year Wales Federation of Young Farmers Clubs runs a breeding stockjudging competition for both beef and sheep and concludes with the winners from the 12 counties competing at the Royal Welsh Show.
This year Hereford Cattle Society was pleased Wales YFC’s competitions’ committee chose the Hereford breed for members to focus on.


In the run up to county rallies across Wales, many society members were called upon to train the nation’s youngsters as well as to judge county rounds of the competition.
On the Tuesday of the Royal Welsh, Non
Thorne of Studdolph Herefords, Mannon Lewis of the Salbri herd, Helen O'Kane of Keadyview and George Morgan of Fardre Herefords were ‘master judges’. After an afternoon of competition, the results were announced on the YFC stage with the under 16 section won by Jane Davies of Ceredigion and under 18 section led by Ynyr Roberts of Eryri. The under 21 category was won by Brecknock’s Ffion Havard while team mate and Brecon market auctioneer Tom Pritchard won the under 28 section. As a team, Brecknock YFC were named as gaining the highest points. The four age category winners were presented with Hereford merchandise from the society.
Ffion Havard from Brecknock YFC said: “Having the opportunity to represent Brecknock in what was once the county’s most dominant beef breed was indeed a privilege. Numerically, the white face cattle still dominate beef production worldwide, noted for their docility, climatic versatility, easy fleshing and above all eating quality.
“Placing the breed which sustained several generations of my ancestors was a unique experience, not to mention the thrill of winning the under 21 section and more importantly contributing to the team’s overall victory. Diolch CFFI Cymru am y cyfle.”
By Laxfield Wilberforce ex Laxfield Silk 58th By Laxfield Jubilee ex Laxfield Countess 3rdThe above two calves are typical of the type of cattle we have strived to breed for the last 50 years. Their pedigrees include great sires and female lines from the past and present day.
BY AI – LAXFIELD JEFFERSON, BOYCEFIELDMany thanks to all our customers - visitors always welcome. Well-bred, hardy cattle of the true Hereford type from long established bloodlines usually for sale. Entire herd is homebred.


After a period of reduced activity due to the pandemic, the year 2022 saw UK Hereford Youth bounce back even stronger with a packed year of activity.
As with many social groups the pandemic had a prolonged impact on UK Hereford Youth's gatherings. Workshops were postponed, agricultural shows were cancelled and face-to-face meetings re-scheduled. But it did not take UK Hereford Youth long to get back into the swing of things making 2022 one of the best years yet.
The first event in the calendar was the long awaited national workshop in April. This was kindly hosted by Paul and Vicky Moyle of Porton House Herefords, Newport, South Wales. Over 30 young members were in attendance and it was great to see some new and old faces plus visitors from Ireland. All members were split into ability and age categories with seniors and intermediates being put through their paces on commercial stock judging and showring etiquette. Health plan templates were distributed and they were set the task of completing this, discussing the potential disease risks, biosecurity, and overall farm management.
Newcomers and juniors were taught throughout the day how to clip and prepare an animal for the showring providing valuable experience which they all enjoyed. The trainers also taught them how to tie a halter with the safety knot and had a go at releasing the animal
and leading it around the makeshift showring.
Tyndale Vets came with an animal’s reproductive tract, allowing everyone to view the breeding components of a cow and were informed on artificial insemination and embryo work. It made a very interesting session.
Paul and Vicky made everyone feel welcome supplying endless amounts of tea and biscuits, a hog roast lunch and a leisurely farm walk for participants, parents, and all attendees. Once the day’s proceedings were over several of the young breeders met in the evening for a meal to discuss their day.
Lyn, Leslie and Adam Bowen from Bowendu Herefords took the reins for day two and treated attendees all to a comprehensive herd walk. Following that, the young breeders were put
through their paces and were asked to stock judge a selection of young bulls, dry cows, and yearling heifers. Trevor Andrews from Northern Ireland’s Mountview Herefords was the master judge and led a healthy discussion on his placings giving everyone a sound view on cattle judging.
Once again, the event was finished off with a super lunch.
The summer shows offer numerous opportunities with young handler classes to compete in. The Royal Three Counties saw seven young Hereford members going head-to-head in the ring, with Sid Shaw taking first place in the under eights. Tia Moyle then took first in the nine to 12 year category and Mia Shaw was fourth. Ollie Garnett-Smith was
awarded first in the senior section with Cara Doggett third. Ollie then went on to take overall champion young handler. The Royal Welsh had an exceptional representation for the Hereford breed with two teams entered in the interbreed young handlers. One team was made up of Ethan Brook and Catherine Nicholas, and the other by Ollie Garnett-Smith and Cara Doggett who took the overall reserve slot. There were many also competing in the individual competitions with Cara taking the overall championship.
Lots of competitors were present at both the National Hereford and National Poll Shows, with countless young handlers fiercely fighting it out for the top spots. It is always great to watch all the determination and drive exhibited to win those trophies.
Shows are not always about competing but for judging too. Three of our members were asked to judge shows up and down the country. Maddie Clarke flew across to Tullamore, Ireland judging the young handlers’ competitions. Will Awan travelled to Halifax Show judging both the Dexter and Hereford classes and Ollie Garnett-Smith cast his
watchful eye at Bedwellty Show on the Hereford entries and overall interbreed. Congratulations goes out to them, representing the breed in a professional and skilful manner.
The Bonanza Ball was the first of its kind and was organised to raise money for charity, highlight the breed to the wider beef industry and celebrate the youth programme. Planning started back in December 2021 but with Coley Herefords kindly donating a heifer to be raffled, tickets first went on sale in June 2022. Breeders and anyone wanting to win a heifer from this award winning herd were encouraged to purchase a ticket, with the winning number being drawn on the evening of the ball.

Dunbia were the main sponsor of the evening, as they have a long and proud history of supporting young and aspiring talent in the industry. It was great to welcome Dunbia representatives to celebrate with us. Many other Hereford breeders played an important part by sponsoring tables, providing raffle and auction prizes.
In all, 111 guests were in attendance and were treated to an evening of excellent British food, served across
three courses, a super raffle and exciting charity auction, finished off by dancing into the night. A total of £10,832.95 was raised and the money will be split three ways to Leukaemia UK, Farm Safety Foundation and the UKHY travel bursary fund. This was an amazing amount of money and UKHY thanks everyone who participated in some way and Hereford Cattle Society for supporting the event.
There are currently nearly 100 members within UKHY, many of whom are either helping on Hereford herds or are breeders in their own right producing calves to be shown or sold on for breeding purposes.
The year of 2022 has demonstrated that the breed is in safe hands with older members moving on and new ones coming in to learn about the breed. Our workshops offer opportunities of learning and engagement, and summer shows allow members to network and build on existing relationships.
There are many exciting projects planned for the upcoming year so please do follow UK Hereford Youth’s progress on Facebook.

BEDFORDSHIRE
1 Jim Speirs, (P) ‘Pepperstock’ Pepsal End Farm, Pepperstock, Luton, Bed. LU1 4LH. 07979463480 Email: speirs77@btinternet.com
BUCKINGHAMSHIRE
2 D. & A. Briggs, ‘Blackwell’ (P), Blackwell Farm, Latimer, Chesham, Bucks HP5 1 TN. Tel: 01494 762190/07970492785. Email: farm@davidbriggs.com
3 Sarah Cowle ‘High Hedges’ 15, Station Road, Quainton, Aylesbury, Bucks HP22 4BW. Tel: 01296658310/07770666887. www.high-hedges-quainton.co.uk Email: high-hedges-quainton@outlook.com
CAMBRIDGESHIRE
4 F.W. Cook & Son. ‘Albany’ Albany Farm, Fen End, Over, Cambridgeshire. CB24 5NE. 07818632353 / 07771333303. info@albanyfarm.com www.albanyfarm.com
5 Daniel Fabb & Helen Parr, ‘The Fabb Herd’ Wilsons Orchard Farm, Fenside Road, Warboys, Cambs PE28 2TY. Tel: 07584035080. Email: helen@fabbherd.com. Web: www.fabbherd.com
6 Karen Froud ‘Oldwest’, 13 Hill Row, Haddenham, Ely, Cambs CB6 3TQ. Tel:07787576798. Email: p_kfroud@hotmail.com.
DERBYSHIRE
7 D. J. Deaville, ‘Alderville’ (P) Model Home Farm, New Road, Alderwasley, Belper, Derbyshire, DE56 2SQ. Mob: 07999527108. Email: alderville@w3z.co.uk
8 D.D. Rowley & Partners, ‘Hollowseal’ (P), Hollows Farm, Sandy Lane, Netherseal, Swadlincote, Derbyshire, DE12 8BU. Tel: 01827 373293/07724743611. Email; carol@ hollowsealherefords.co.uk Web: hollowsealherefords.co.uk
9 Lower Hurst Farm ‘Lower Hurst’, Lower Hurst Farm, Hartington, Nr Buxton, Derbyshire, SK17 0HJ. Tel: 0129884900.
Email: sam.walton@lowerhurstfarm.co.uk. Web: www.lowerhurstfarm.co.uk
10 Anthony & Carol Walker, ‘Humblebee Grange’, Humblebee Grange Farm, Hulland Ward, Derbyshire. DE6 3ES. Tel: 07896 173292.
Email: carolwalker1967@gmail.com
11 Mrs. L. Jackson, ‘Sparkwood’ Woodrow Farm, Wigginton, Tring, Herts HP23 6HT. Tel: 01442 823005. Email: lesleyjackson1@hotmail.co.uk
Web: www.sparkwoodherefords.co.uk
LEICESTERSHIRE
12 P. Cobley, ‘Kinglee’ (P), Stanton Farm, Broughton Road, Stoney Stanton, Leicestershire, LE9 4JA. Tel: 07738 110102.
Email: Pete.Cobley@Cobleytransport.co.uk
13 TD. & WT Livesey, ‘Normanton’ (P), Manor Farm, The Hollow, Normanton Le Heath, Leics LE67 2TJ. Tel: 01530 264683/07710386329.
Email: tlivesey@liveseybros.co.uk
14 Newtoncroft Farms Ltd, ‘Newtoncroft’ Croft Farm, Newton Harcourt, Leicester, LE8 9FH. Tel: 01162 259387 Mob: 07990 686854.
Email: ncf450@btinternet.com. Web: www.newtoncroftfarms.co.uk
15 CE & JM Todd ‘Hatton Lodge’ (P), Hatton Lodge, Dalby Road, Nether Broughton, Melton Mowbray, Leicestershire. LE14 3EX. Tel: 01664 822305
Email: candj.todd@btconnect.com
16 SA & VJ Elwess, ‘Elwess’ (H) Manor Farm, Common Lane, Heapham, Gainsborough, Lincs DN21 5XB. Tel: 01427 838208. Simon: 07825446321. Victoria: 07764740540. Email: simon@elwess.com. victoria_elwess@hotmail.com. Web: www.elwessherefords.co.uk.
NORFOLK
17 Chris Blaxell, ‘Bittern Herefords’ White Lodge Farm, Southrepps Road, Antingham, North Walsham, Norfolk NR28 0NW. Tel: 07768 171979. Email: chris@bitternherefords.co.uk.
18 Robert Fowell. ‘Bure Valley’ Orchard Farm, The Common, Itteringham, Norwich, Norfolk. NR11 7AP. 01263587285 / 07947126053.
Email: rafowell@afiweb.net
19 Philip & Laura Vincent, ‘Pulham’ (H & P). White House Farm, Coles Common, Pulham Market, Diss, Norfolk IP21 4XT. Tel: 01379 676906 Philip 07771697866, Laura 07767838208. Web: www.pulhamherefords.co.uk. Email: philiprjvincent@hotmail.com / laura363@btinternet.com
20 Jonathan Wells & Partner, ‘Wellhart Poll Herefords’, Lethbridge House, Rogers Farm, Norwich Road, Costessey, Norwich, NR5 0LB. Tel: 07703126768. Email: leisafreeman2@gmail.com.
NORTHAMPTONSHIRE
21 Thornby Farms - Miss AE. Barlow, ‘Thornby’ (P), Thornby House, Thornby, Northampton, NN6 8SJ. Tel: 01604740295. Email: thornbyfarms@btinternet. com Peter Moyes - 07767 353205. Email: petermoyes@btinternet.com
22 RG Westaway & Son ‘Clipston’, Grasslands Farm, Clipston, Market Harborough, Leicestershire. LE16 9RY Tel. 01858 525385 / 07793472626. Email:rose.westaway@btinternet.com
NOTTINGHAMSHIRE
23 JW & R Johnson, ‘Real’ (P), 110 Bridle Road, Burton Joyce, Nottingham, NG14 5FP. Tel: 01159 313184 Web: www.Realpollherefords.co.uk. Email: realpollherefords@hotmail.com.
RUTLAND
24 JWE & SL Bevin, ‘Shorne Hill’, ‘Shipley Hill’, Shorne Hill, Ridlington Road, Braunston, Oakham, Rutland, LE15 8DB. Tel: 07860819554/07711616944
Email: louise.bevin@hotmail.co.uk
SUFFOLK
25 Owen Smith Farming, ‘Clement’ (H). Briar Cottage, School Lane, Bromeswell, Woodbridge, Suffolk IP12 2PX. Tel: 01394460408 and 07885 594143.
Email: owensmithfarming@live.com.
WARWICKSHIRE
26 Monica Brown, ‘Happy Herefords’, Herberts Farm, Saddledon Street, Tysoe, Warwickshire CV35 0SH. Tel: 07770770976.
Email: info@happyherefords.co.uk.
27 Nick & Lucy Holdsworth, ‘Pebworth’ (P) Little Meadows Farm, Pebworth, Stratford-upon-Avon, Warwickshire CV37 8XE. Tel: 07894074041
Email: nlholdsworth99@gmail.com
28 D.P. Jones Ag. Cont, ‘Maxstoke’ (P), Mill Farm, Fillongley Road, Maxstoke, Coleshill, Warwickshire B46 2QA. Tel: 01675462183/07854258111.
Email: mill-farm@btconnect.com.
29 Mike & Caroline Shaw, ‘Thornysure Herefords’ Wharf Farm, Darlingscote Road, Ilmington, Nr Shipston-on-Stour, Warwickshire CV36 4JA. Tel: 01608682556 / 07968486823. Email: thornysure@gmail.com.
Hon. Secretary: Peter Moyes, Lodge Farm, Welford Road, Thornby, Northampton NN6 8SL. Tel: 07767 353205
Email:petermoyes@btinternet.com www.meahba.co.uk
After two years of activities almost completely lost by the effects of covid, during 2022 the Midlands and East Anglia Hereford Breeders’ Association were able to get back to a full year of events.
The highlight of the association’s year and the first opportunity members had to meet since the complete lifting of the Covid restrictions was the annual stockjudging evening. The association had managed to keep this competition alive in 2020 and 2021 by holding a virtual event. This had been wellsupported by members, in fact, more than normal attended the live event. Thanks must go to the Normanton and Fabb herd for taking the photographs for the previous two years.
However, in May 2022, the evening event was again able to take place, with a record number of members and guests taking part. On the night, 36 competed in the judging with many more enjoying the farm walk and splendid supper afterwards.
Our host was Pete Cobley, Kinglee Herefords, who must be thanked sincerely for such an enjoyable time, and not forgetting Steve Edwards and Emma Dexter for preparing the cattle. Will Awan was the master judge, who carried out
the task very efficiently, and gave an excellent summary for his placings in each class.
Emma Dexter was again the winner for the second time in three years, with Richard Mann in second and Joe Clark placing third.

The experience gained from this evening again proved its benefit when our teams had a clean sweep in the National Stockjudging Competition at the Royal Three Counties Show, with members taking the top three positions and Ryan Coates, James Ludgate and Joe Clark making up the winning team. Congratulations go to all members who took part.
Members look forward to a great evening in 2023 with Pete Cobley again inviting members to Kinglee.
All the summer shows in the area took place, with the exception of Rutland, which had no Hereford classes, and Leicestershire, who failed to hold a show. It was great to get back to showing and the association was grateful to all those who entered the shows. While there was some disappointment with entries and numbers forward, this was a trend across cattle classes in all areas of the country. The association urges all members, including those who have shown for many years, and new breeders, to support the 2023 show season, or the breed risks joining the any other breed sections.
The Norfolk Show was again the best supported in the region, not just by associations members, but

by many breeders from other areas. Congratulations must go to Messrs Hartwright, Spartan Herefords on taking the breed champion with Spartan 1 Typhoon; what a season they have had. The association was again able to have a stand within the showground, which attracts not only farmers interested to learn more about our breed, but the general public, especially children. Members penned a Hereford cow and calf on the stand, for which they thank Phil and Laura Vincent, Pulham Herefords. Clive Bidmead, ably assisted by Adrian Yardy provided the refreshments, in the absence of Alan and Joy Pittam, previous association secretary and his wife. Thanks go to Sarah Cowle for helping on the stand for the two days, Paul Sneyd for attending, and the Hereford Cattle Society for providing the stand.
After the day’s showing was finished, many members and friends congregated on the stand for refreshments. Clive Bidmead’s butcher, Tony Perkins, had slow cooked Hereford brisket, served in a bread roll with a barbecue sauce. They were delicious, so much in fact, 80 were served. Together with a beer, kindly supplied by Pulham Herefords, it was a great gathering after a long day.
The herd competition was held during the last week of July, when judge Simon Bradley Farmer and Tina Russell, Shorthorn Breeders from Oxfordshire visited 21 members’ farms. At the request of members, the judging was completed in one week, quite a task, with many miles covered from Luton to Lincoln, and Norwich to Shipston-onStour.
The association would like to thank Simon and Tina for giving up their time to judge the competition and Simon for attending the AGM, presenting the trophies, and his very complimentary comments on all the herds visited.

On giving an appraisal of his judging, Simon said: “The improvement in the growth and condition of the young stock after weaning is most marked.”
This is a very similar comment to the 2021 judge who said: “Are breeders paying enough attention to the milking potential of their cows?”
A very interesting addition to this year’s competition was the daily report of progress on Facebook which the association thanks Tina for.
Best herd, (J G Holland Cup), PRJ and LR Vincent, Pulham
Small herd, 1st, Karen Froud, Oldwest; 2nd, Beth Vincent, Beckhall; 3rd, CE and JM Todd, Hatton Lodge
Medium herd, 1st, Peter Cobley, Kinglee; 2nd, DD Rowley and partners, Hollowseal; 3rd, M Ludgate, Rempstone
Large herd, 1st, PRJ and LR Vincent, Pulham; 2nd, TD and WT Livesey, Normanton; 3rd, Monica Brown, Happy Bull calf (Geoffrey Lewis Cup), PRJ and LR Vincent, Pulham Wedding Crasher
Heifer calf (Chadshunt Cup), TD and WT Livesey, Normanton 1 Buttercup 5th Heifer under two years (Michael Church Plate), Beth Vincent, Beckhall Princess Bella
Cow suckling a calf (MEAHBA Cup), David Deaville, Alderville 1 Dione
Stock bull (Mardleybury Cup), DD Rowley and partners, Cleland 1 Potter Bull under 30 months (Pulham Trophy), TD and WT Livesey, Normanton 1 Vindicator
Judge’s choice (Alvian Cup), TD and WT Livesey, Normanton group of yearling bulls
Individual animal gaining most points (Paul Sapsed Cup), joint 1st, PRJ and LR Vincent, Pulham Pansy 28th and K Froud, Oldwest 1 Carol Singer T5
Animal with most points from a herd of less than 20 cows (Austin Manning Cup), K Froud, Oldwest 1 Carol Singer T5
Champion young handler (High Hedges Cup), joint 1st, Joshua Matthews and Beth Vincent
The final event of the year, the association AGM, was held by kind invitation at the herd of Simon and Victoria Elwess, Gainsborough and was first time for many years the AGM had been held in Lincolnshire.
The 2023 committee was elected as




Michael Church as president, Ryan Coates as chairman, Jimmy Speirs as vice-chairman and Peter Moyes as secretary. The rest of the committee remains the same, except for the addition of Mike Shaw and resignation of Martin Coates.
Mike Church stood down as chairman after 33 years. He was warmly thanked by members, and presented with many
gifts in recognition for all that he has done for the association and the breed over many years.
After a very tasty beef lunch, on a lovely sunny afternoon members visited the Elwess herd. The cattle looked in excellent condition, grazing on almost bare land, showing off the qualities of the Hereford breed. Members thanked them for organising the meeting venue,



and providing tea and cakes before they departed.
The association was saddened to hear of the passing of breed stalwart, Peter Dowlman, who passed away in October. Peter was an active member of the association and breeder of Hereford cattle for many years and his knowledge and experience will be sadly missed.

-







Members of the HiHealth Herdcare Scheme Many thanks to all our customers in the past year.
Progeny available from our 4 stock bulls...





THERE’S NO STOCK LIKE PEPPERSTOCK







Fred Klein who died peacefully eight days before his 97th birthday was born on a family farm in Johannisdorf in Transylvania. He was the youngest of seven children having five brothers and one sister and had a very happy childhood.
His teenage years were not so fortunate. Two of his brothers were killed at Stalingrad and were never found. Fred was conscripted into the German army, he set out with the idea that he would become a good soldier but soured by his experiences he later refused promotion. He became involved in the siege of Leningrad. The number of casualties in that conflict alone demonstrates how lucky he was to survive. He had a number of narrow escapes from deadly situations during the retreat of Leningrad, the most poignant when his friend Jensen was shot and killed after his second attempt to wake an exhausted Fred. He was lucky to get on the last but one boat out of Riga. The boat behind was hit and sunk. Fred could only watch as hundreds of soldiers drowned. This left its mark on him for decades.
Arriving in Germany, he soon surrendered to the Americans. He definitely did not want to fall into the hands of the Russians. After some months in prisoner of war camps, he came to England as a prisoner of war. Sent to work on farms, he eventually found his way to The Vern as part of a team of hay makers. Although only there for a few days, his capacity for work and his willing attitude attracted the attention of Captain de Quincey who offered him a full time job on his release as a prisoner of war. When the Captain asked for his POW number, Fred replied unlucky 13. Maybe its lucky for me,
answered the Captain. Prophetic words.
A huge blessing in Fred’s life was meeting Edeltrud, his wife of 57 years. Throughout their long and happy marriage she gave Fred unstinting support and objective advice and they formed a loving and enduring partnership. By the time of Captain de Quincey’s death in 1965, Fred had become the Captain’s right-hand-man as far as the cattle were concerned and he was able to say, ‘I loved the man and regarded him as the father I had lost’.
Such was Fred’s renown as a stockman, that he was offered eight jobs here and overseas but in the end decided to remain at The Vern with the new owners and became herd manager. In his will the Captain left Fred, the pick of two of that year’s maiden heifers. From these animals, he bred the bulls Kleine Atlantic exported to New Zealand and Kleine Baron, sold for £12,000 to Lord Portman for his Wilmaston herd.
The tremendous success of the Vern dispersal sale in October 1966 was in no small measure due to the efforts of Fred

and his team. Fred has vowed he would do the best for the Captain even though he was gone.
The sale still ranks as one of the greatest ever cattle sales. For the next seven years, Fred remained at The Vern with the same owners. When they sold in 1973, he took up farming on his own account at Rowley Farm, Leominster. Being a neighbour of Esmond Bulmer of cider fame, he was well-placed to observe a demonstration of a recently invented apple tree shaking machine. An idea came to Fred that he could purchase a machine and start an apple tree shaking business in the many orchards of Herefordshire. The machine cost £7,500 but prior to this he had been left £10,000 in the will of Barbara Turner, another of those good people. He retired from the apple shaking business in 2015, aged 90 and handed it over to his son Christopher. When Fred arrived in England as a prisoner of war, he had few clothes, no money and could barely speak the language. Through his own efforts, he became a man of substance while retaining his wonderful sense of humour which served him so well throughout his long life. Although he had the ability to bring the past vividly to life, his reminisces were never the bleatings of an old man wishing to live in the past.
Another great blessing of Fred’s life was that he was completely compos mentis until the end. Eldetrud pre-deceased him in 2013. He is survived by daughter Martina and two sons Christopher and Anthony, six grand children and five great grandchildren.
One might say Fred has come full circle in his nearly 100 years. His extraordinary life was the subject of a book Fortunes, Buffets and Rewards, published towards the end of his life.
Pam was born on 28 February 1933 in Buckinghamshire. During the war, Pam was evacuated to stay with relatives in the countryside at a place called Shurlock Row. Her love of animals started at an early age with the family’s pet cats and dogs. By the age of 15, she was a trained dancer and acrobat and rode elephants in Tom Arnold’s Circus in Haringey, performing most of her routines on a baby elephant called Sally.
In 1954, Pam married her first husband John Noel in Harlington, near Hayes, Middlesex. John taught her to shoot and fly fish and they travelled all over the country fishing and shot with different syndicates, one of which would meet in Shurlock Row. She was a tenacious fisherman and a crack shot. John and Pam moved to Stonecroft Farm in Burnham and started breeding, training and working golden retrievers under their prefix Duckflight. They exported trained dogs all over the world, and they both insisted the dogs had to work as well as show. Consequently, they won many championships in the field and show ring including at Crufts, where they lifted the gold trophy in 1967 and 1969.
Ever looking for a new challenge, they started a boarding kennels. The dogs went home looking so well. Their owners started asking what food had been fed in the kennels, providing the perfect opportunity for them to start a home delivery service. This proved so successful it escalated into a wholesale pet food company with a fleet of lorries and vans.
In 1971 at the Three Counties Shows, Pam saw the grand parade of Hereford cattle and fell in love with them quickly, deciding they were to be the next great adventure. After talking with Jack Grange of Frilsham Herefords near Newbury, she purchased two in-calf heifers and Sarabande Herefords was born.

Robert joined the dog food firm in 1975, and also fell in love with the Herefords. It wasn’t long before the cattle out grew
Burnham so in 1978 they moved to Long Meadow in Shurlock Row – what goes around, comes around.
The herd grew. In the early 1980s Pam was sent a photograph of a bull from a friend in Ireland. Pam was so impressed she ordered some semen and he turned out to be one of the most influential bulls of the breed at the time, namely Standard Lad 93J. Pam bred the first two calves from him in England. One male Sarabande James who held the record 400 day weight at the time and Sarabande Rose 12 which was female and reserve supreme champion at the National Hereford Show. Sadly in 1987, John passed away and Pam tenacious as she was in everything decide stoically to carry on going from strength-to-strength with the help of Robert and other friends.
The show successes continued with many championships year after year at all the
shows across the south of England, and also at the Royal Show and the National Hereford Show in Tenbury Wells, including three interbreed beef recorded classes at the Royal and four at the South of England Show. She won the Canadian Rose Bowel out-right at the Royal Show after winning it three times with different home-bred females. She considered this one of her greatest achievements as none of the larger herds had managed it. She won the South of England Hereford of the Year competition 26 times out of 30 between 1980 and 2010. She also served on the SEHBA committee for many years and judged cattle at shows all over the country. In 2010 after 40 years as director of the pet food company, Pam aged 77 finally stepped down for her retirement with Robert, their cattle and dogs. Pam thoroughly enjoyed her Herefords for 51 years, her final thoughts going back to her circus days were, the show must go on.
Peter was born in 1932 at Spilsby in Lincolnshire. His father was a farm bailiff but soon moved his family onto Hawksworth in Nottinghamshire. After his schooling here Peter took work on a local pig farm. It was at this time that he and wife Ivy met. Following their marriage, they moved on to a nearby outfit that kept Aberdeen Angus cattle and from here to West Tisted in Hampshire with the same breed. Peter began to develop his showman skills as in a close geographical region was the famed Wych Cross herd, where the well-known George Rugg was herdsman.
A couple of times each year, cattle were forwarded to the Perth bull sales. Transport was via the railways and these epic trips led to great camaraderie among the stock handlers. Through such expeditions and at the shows Peter met up with Alistair Rettie bringing out stock for Osmonds of Grimsby the well-known veterinary medicine company, and Sandy Beaton based with Glanelan Herefords near Norwich. The threesome became close allies, and all were mentored by Albert Rettie, the master practitioner.
The Dowlman family were on the move again spending some time on the Rothchilds’ Estate in Buckinghamshire but with a growing young son, Paul, a better family home was required. There was a job vacancy at Kelling Pine in Norfolk working with Angus and Herefords. As time went on, success came with the cattle and they remained there until the stock were dispersed in July 1967.
Animals were dispersed far and wide with some to Sir George Harriman of Knowle, Warwickshire who was establishing a herd which was to be the Dowlman family’s next project. Sir George had been chair and managing director of the British Motor Corporation (BMC). Foot and
mouth disease took hold in the north Midlands area in the late autumn of 1967. Several Hereford herds were lost and great damage was done to the British cattle industry. Through BMC’s Canadian division, the champion Hereford at Calgary was purchased for a then record price of $10,000 (£4,000).
George died in the spring of 1973 but Lady Harriman, with Peter’s guidance continued with the farm until the decision was made to wind things down during 1975.

The pedigree cattle scene was changing in many ways and at this time Peter was seriously considering taking a different career path. However, there was a fairly recently established herd in northern Northamptonshire that was looking out for some help. Dick and Gwen Adams were ambitious commercial livestock farmers and were establishing their Welford herd. Success came, more investment was made and Peter’s tally of achievement grew, including preparing and parading both male and female champions at the English Royal.
National Show champions and winners were coming thick and fast. This Welford team were well suited, worked hard, had
high expectations and got results. There was only one real difference: following an event, Dick and Gwen would spend quiet time holding a postmortem of the proceedings whereas Peter would prefer an all-night party, but the next day the cattle came first.
Peter enjoyed his retirement and was much involved with the show scene, particularly the Birmingham event held at Stafford since 1973 and became a council member. In 2014 he moved to Herefordshire to be near to son Paul, Sarah and the family. He was proud of their achievements, with Paul tending Hereford and Aberdeen Angus cattle at Llandinabo along with his four grandchildren followed by the arrival of great-grandchildren.
Peter passed on 12 October 2022, when his busy life came to its end. He was a talented operator, certainly one of the last of the old-school that revelled in the glorious livestock days of the fifties and sixes. He was a strong believer that animals should be known by their names and not just numbers, and that work should be carried out with show animals to the extent that a show stick was not required: he never used one.
Towards the end of January 2022 the Hereford breed lost one of its most dedicated quiet achievers.
Melanie Williams was born Melanie Pascoe on 8 September 1952. She was raised in a farming family that was predominately dairy. John and Melanie were married on the 25 March 1972. Melanie did not move far once married, just across the valley to the next door farm, where her and John set-up AnHay, which was part of John’s family farm. Melanie gave birth to their only child, their son, known by everyone as AJ in November 1973. The couple became members of the Hereford Cattle Society in 1977, and that has been a major part of both their lives ever since. AJ met his partner Polly in 1993, and granddaughters Shanon Maya, born in 2001, and Bryony, born in 2005, were Melanie’s pride and joy.
The Anhay herd was developed using genetic choices from all parts of the UK. Special regard was given to type, conformation and construction and it was no wonder that success was achieved. A friendly bond was created with Colin Clarke of Badlingham Herefords fame with plenty of conversation, comparisons and decision-making taking place. Undoubtedly one of the most celebrated stock bulls ever used in the South West was Badlingham Broad Lad, sired by Standard Lad 93J from Badlingham Blossom 17th by Wenlock Grandee. This bull not only sired top-class progeny at Anhay but also won numerous awards successfully representing the white-faced breed in interbreed competitions. In later life Broad Lad joined the poll Hereford herd of Jack Henry, continued his valuable contribution and was then subsequently used by many other breeders.
Broad Lad was soon followed with Ongutein Jerry, a Generator son from a Daffodil cow built up with strong Badlingham breeding. Subsequently further well-chosen bulls were used including a goodly number of welldeveloped home-bred animals. Over the years this gave John and Melanie an excellent supply of breeding females to offer interested parties together with sound sire choices mainly to the vibrant dairy sector of the South West.
The Williams’ farming also involved a dairy herd that for such a long time has been run as an organic enterprise with sheep farming also. As well as the farms near to St Martins, the family also run cattle on The Lizard so undoubtedly the UK’s most southern grazing herd of Herefords. John and Melanie also developed and for some time ran a busy bull hire business with John dealing with negotiation and transport
and Melanie maintaining the ever increasing administration of affairs. The couple were also great travellers, usually with caravan in tow. Whether a field day, sale or show they would be spotted anywhere around the country where Herefords roamed and were great supporters of so much of the breed’s activity. Conversely, Hereford cattle visitors to Anhay were very well received as were all guests with Melanie having that special approach to a welcome and especially so with regards to the holiday accommodation that was run alongside the farming for many years.
John, AJ, Polly and the family continue with their busy farming activities including the Anhay Hereford herd, but Melanie’s contribution of kindness, support and dedication will be held in their memories and with those of everyone else that met her.

In 1943, Harold Hatt was born at Weybrook Farm in Sherborne St John, Hampshire, a busy arable and dairy farm, the hub of the local community and the place he was to call home all his life. The middle child of three, with a sister either side, he had great success at mischief making - a personality trait that remained true to the end of his life, often sharing his enduring sense of fun with his grandchildren.
He had a very keen interest in stockmanship from an early age and a passion for bloodlines and pedigrees which quickly brought success in the show ring with pedigree British Friesians. This he continued to develop with the Weybrook prefix being etched into many a piece of silverware and bulls and females with the name Weybrook being highly sought after in the dairy world.
By the mid-1990s the urban sprawl was putting pressure on the dairy and with both sadness and dignified pragmatism Harold took the farm in a new direction which enabled him to set up charitable ventures to benefit many elderly and vulnerable people as well as taking on the challenge of a pedigree beef suckler herd that would maintain and sustain the farm he loved. Ahead of his time, he planted trees and hedges, set up low input farming systems and wanted to find cattle that would fit in with his farming ethos supporting wildlife and the natural environment.
The dispersal of the Weybrook dairy herd and the letting go of carefully planned bloodlines was a massive wrench that he turned into a new opportunity. After trialling a few Aberdeen Angus, Simmental and Herefords, he firmly fell in love with the docile, reliable, versatile, whitefaced Hereford and never turned back. Unafraid of the challenge and using his
keen eye for quality cattle, he set about finding correct animals with a quiet temperament to form the beginnings of a new poll Hereford herd and tried to get his head around trimming and leading cattle a little differently out in the show ring, which he soon learnt to great effect.
It wasn’t long before he found success in showing Weybrook poll Herefords at the Royal Show and other shows across the south of England with the stash of rosettes soon mounting up alongside requests for him to judge cattle and livestock in general.

Perhaps even more enduring than his gathering of prizes was the integrity
with which he conducted his farming and cattle breeding business. Many have commented on his honesty in business and his genuine care and interest in people. He was a gentleman. It is with great sadness that the Hatt family come to terms with the sudden passing of a much loved husband, father and grandfather, and the huge void his passing leaves both on the farm and further afield. The certainty of his Christian faith and the hope this brings through trusting in Jesus is a great comfort and the care and support received from the farming community as well as from within the Hereford Cattle Society has been greatly appreciated.
Robert James Webb was born on the estate of Croft Castle, in north Herefordshire in 1928. His parents, Percy and Elizabeth also had two other sons and a daughter. When Bob, as he was universally known, was four, they moved across the Shropshire border towards Ludlow. They soon made Court Farm, Ashford Carbonell their home. Bob was educated at the local school but he didn’t much like it, instead preferring life about the farm. In fact, it could be said that his greatest ‘achievements’ at school was having his name entered into the punishment book.
Angela was brought-up in the neighbouring parish, on the other bank of the River Teme. They were married in Ashford Bowdler Church in 1957. Percy and Bob were dedicated stockmen. They had long been involved with Ryeland sheep. The 1950s was a very successful period, for instance, taking top awards at the English Royal Shows. The Ashford and Teme Flocks are major players today and Bob is credited with being instigator for the development of the Coloured Ryeland breed.
Their Hereford cattle breeding wasn’t long established but they would always keep a Hereford bull for use in their small dairy herd. They commenced the Ashford herd in 1942 using the top bloodlines of the day, a project that lasted until the late 1970s. Animals were regularly shown and also sold at the Hereford sales.
As well as farming, Bob carried out many livestock haulage tasks which included work for locally based Hereford breeder, HC ‘Benny’ Dent at Woodhampton, Little Hereford. He was one of the greatest historians of the breed and ran the Perton herd. Many tasks for Benny would include trips to The Vern where Bob would look, listen but join-in on the banter.

Even in his later years he was always youthful in his mind. Busily thinking, engaged in what was happening and interested in all developments. He had that element of fun and mischievousness about him, harking back to his prankster days at school.
Bob was regularly used as a judge and many will have benefited from his opinions. A nudge here, a nod there, breeders taking on an animal that he had spotted and with sound results. He was a master feeder of livestock. Never complicated or elaborate, infact, basic but his adage, ‘a little bit and often’ and very often in this case, always brought results.
In 2005, Bob and Angela reformed the Ashford Hereford herd based on Westwood bloodlines and had great success, particularly at the autumn and winter calf shows achieving notable wins. Their last outing was to the 2013 autumn Hereford sale where the impressive Ashford Whisky took first prize and sold
to the Chase herd. During these times Bob and Angela were regular attendees of events, especially those organised by the Hereford Cattle Breeders’ Association, Bob, wearing his black eye patch.
As well his vision issues, he was quite profoundly deaf which made conversation a bit of a shouting match, but his ever-attentive mind missed nothing. During his final years and with mobility problems, many sheep had come into the house for inspection by the flock-master, a recent purchase or some being prepared for show.
Bob died in mid-January 2022, Angela having past some years previously. With great support from all of his family, two sons, two daughters and the five livestock-appreciating grandchildren, and many close friends, Bob happily lived out his final years. He will be much missed by many people over a wide area but this character of the livestock world has certainly made his mark.






















Following in the footsteps of Moralee 1 Rebel Kicks KS R12, Spartan 1 Typhoon was named Champion of Europe in 2022 by a panel of international judges.
Spartan 1 Typhoon from SC and GL Hartwright, Abingdon, Oxfordshire took the Champion of Europe title in 2022, making it the second consecutive win for UK poll bulls in this competition.
Having won several interbreeds around the UK this summer with stockman Luke Murphy on the halter, Typhoon was also named UK bull of the year, while its sire Solpoll 1 Perfection picked up UK sire of the year.

The competition is run by PJ Budler, Texas and is judged by an international panel which this year consisted of Santiago Bordaberry Herran of Uruguay, Erica Halliday of Australia, Gérard Ernst of Luxembourg and USA’s Brandon Callis.
Since winning the competition, Typhoon was purchased by Speirs Farms, Luton for a record poll bull price of 16,000gns.
The year 2022 saw Umgola 1 Lawman from S Baxter, Armagh move over the border to JJ and C Farrell, Trillick-aTemple, Co Longford, Eire to join their Trillick herd. A son of Solpoll 1 Lawman, it is out of a home-bred female.
Corcreevy Margare from N Hudson, Co Fermanagh took the same journey. By Irish sire Newland Joey, it is out of a home-bred Parkhill Pompeii and was purchased by J Clancy, Killeen, Dromahair, Co Leitrim.
The Lewis bicentenary sale saw a number of animals travel to the Republic of Ireland. Haven Thrush 75th bred by EL Lewis and son was purchased by Kieran Power, Garrnoe, Co Tipperary while Haven Louisa 96th travelled to join the herd of H Thompson, Ballyraggan, Co Carlow. Haven Dowager 196th went to Newtown, Co Louth to join the herd of E and J McKiernan.
Glenvale 1 Fanfare from current national herd of the year winners TG, EI and EN Thorne, Pembrokeshire was released to Matthew Goulding, Kilmore, Co Kerry to join his Gouldingpoll herd having been purchased out of the autumn show and sale at Shrewsbury Auction Centre.
Dendor 1 Wyatt Earp from Powysbased DE, ED and AL Jones also moved across the Irish Sea after purchase from Alannah Cooke, Thurles, Co Tipperary.
In terms of semen exports, 117 straws of Solpoll 1 Spike semen bred by J and W McMordie held by Genus sold to Viking Genetics in Finland. Sold by Genus, 30 straws of Solpoll 1 Spike were also exported to Belgium.
Selling to John Steinsvik, Norway, were 10 straws of Chater Valley Chance, a miniature Hereford bull bred by M and L Gough. Also heading to Norway were 10 straws of Chater Valley Chai, another miniature bred by M and L Gough. Semen from Margarita Sensation, a Traditional Hereford bred by R Hodson Walker was exported to PD and HM Hall,
Cotmore Herefords, Australia. Semen of Margarita Sebastian was sold by Mr and Mrs D Fenton to the same buyer.
From Graceland 1 Silas bred by R and J Irvine, 250 straws of semen was sold by AI Services NI to Eurogene AI Services, Co Tipperry. From Cogent’s Netherhall 1 Mind Set, 200 straws were sold by Cogent to the same buyer.


World Hereford Council – secretary general - Larry Feeney
Email: worldherefordcouncil@gmail.com
American Hereford Association
Jack Ward, Executive Vice President
Box 014059, 1501 Wyandotte, Kansas City, Missouri, 64108-1222, USA
Phone: 1-816-842-3757
Fax: 1-816-842-6931
www.hereford.org/
Email: aha@hereford.org
Asociacion Argentina Criadores de Hereford
Manuel Obarrio 2948, C1425CQB - Buenos Aires, Argentina
Mr. Augustin Arroyo, General Manager
Phone: 54-11-4802-1019
Fax: 54-11-4802-1019
Email: info@hereford.org.ar
www.hereford.org.ar
Herefords Australia Ltd.
Lisa Sharp
General Manager
Locked Bag 7, Armidale NSW 2350, Australia
16 Uralla Road, Armidale NSW 2350
Australia
Phone: 02 6772 1399
Mobile: 0447 949 650
Fax: 02 6772 1615
www.herefordsaustralia.com.au
Email: lsharp@herefordsaustralia.com.au
Canadian Hereford Association
Mr. Stephen Scott, Executive Director
5160 Skyline Way N.E., Calgary, Alberta, T2E
6V1, Canada
Phone: 1-403-275-2662
Fax: 1-403-295-1333
www.hereford.ca
Email: stephen@hereford.ca
Danish Hereford Association
President, Knud Erichsen
Skibstedgaard
0045 40196310
www.hereford.dk
Email: skibstedgaard@skibstedgaard.dk
Animal Breeders Association of Estonia
General Manager: Tanel Bulitko
Hereford Director: Mr. Aigar Suurmaa
79005, Rapla County, Estonia
Phone: 372-4873-181
Fax: 372-4890-680
Hereford Director: Mr. Aigar Suurmaa
Phone: 372-742-1575
Fax: 372-742-2879
Finnish Hereford Association
Chairman:Kai Pastell
Innilantie 113, 37500 Lempaala, Finland
www.hereford.fi
Email: hereford@hereford.fi
German Hereford Association
c/o Carsten Schmit
Neuer Kamp 38, 30900 Wedemark, Germany
Fax: 49-5130-925023
www.hereford-germany.de
Email: info@hereford-deutschland.de
Dutch Hereford Association
Henk Kuipers
Horstingerend 7, 7843 TE Erm, The Netherlands
Tel. 0591-564135
www.hereford.nl
Email: henkensonjakuipers@kpnplanet.nl
Hungarian Hereford Association
Dr. Istvan Marton, General Manager
H-7400 Kaposvar, Denesmajor 2, Hungary
Phone: 36-82-3-16-610
Fax: 36-82-510-046
www.mhagte.hu, www.hereford.hu
E-mail: hereford@t-online.hu; info@mhagte. hu
Irish Hereford Breed Society
Ms. Louise Callan, Acting Secretary Harbour Street, Mullingar, Co. Westmeath, Ireland
Phone: 353-44-48855
Fax: 00-353-44-48949
www.irishhereford.com
Email: irishhereford@gmail.com Kazakhstan Hereford Association
Kenesary 40, Street
Business center “7th Continent” office 1206, 1205. 12 Floor 010000, Nur-Sultan city, Kazakhstan Phone: +7 7172 279 002, +7 7172 279 996, +7 771 532 002. www.herefords.kz
Email: info@herefords.kz, director@herefords.kz New Zealand Hereford Association Inc.
Mrs Posy Moody, General Manager
Hereford House, Box 503, Feilding, New Zealand
Phone: +64 6323 4484
www.herefords.co.nz
Email: manager@herefords.co.nz
Norway Hereford Association
Mr. Inge G. Kristoffersen, President Storhamargata 44, 2317 Hamar, Norway
Phone: +47 915 45 613
www.hereford.no
Email: post@hereford.no
Email: inge.g.k@online.no
The Norwegian Breeding Association
Storhamargata 44, 2317 Hamar, Norway
Director: Halvor Nordli
Phone: +47 952 90 855
Fax: +47 62 53 82 41
Email: tyr@tyr.no
Paraguay Hereford Association
Oficina de Registro Genealogico de la Asociación Rural del Paraguay
Ing. Carlos Pedretti, Ruta Transchaco Km. 14 ½ Mariano Roque Alonso, Asunción, Paraguay Phone: 011-595-21-754412
E-mail: secretaria@orzarp.org.py
South African Hereford Breeders Society
Contact: Liezel Grobler
P.O. Box 20165, Willows, BFN 9320, South Africa
Phone: 051 410 0958
Fax: 086 218 8246
www.hereford.co.za
E-mail: liezel@studbook.co.za
Promotions: Lizette Vermaak
Phone: 082 412 2868
Email: herefords@vodamail.co.za
Swedish Hereford Association
Magnus Johansson, Chariman
Hollstorp Hagalund, 355 91 Växjö, Sweden
Phone: +46 470 749 461 or +46 768 303 600 www.hereford.nu
Email: magnus.johansson@hereford.nu
Swiss Hereford Association
Walter Faessler, President Interessengemeinschaft
Schweizer Herefordzuechter, c/o Walter Faessler, Barenegg, 9633 Baechli-Hemberg
Switzerland
www.swisshereford.ch
Email: barenegg.hereford@bluewin.ch
Mr Paul Sneyd, Director of Operations
Hereford House, 3 Offa Street
Hereford, HR1 2LL U.K
Phone: +44 1 432 272 057
Fax: +44 1 432 377 529
www.herefordcattle.org
Email: postroom@herefordcattle.org
Sociedad Criadores de Hereford del Uruguay
Dr. Alejandro Costa Irigoyen, President
Mercedes 855 Esc 605
CP 11.100, Montevideo, Uruguay
Phone/fax 0059 2908 7579 - 2901 0437
www.hereford.org.uy
Email: info@hereford.org.uy
Luciano Augusto Sperotto Terra, President
Av. General Osório 1094
Caixa Postal 483, Bage - RS - Brasil
Phone: 55 (xx)(53) 3312 8726
Fax: 55 (0xx53) 3242 1332
www.hereford.com.br
www.braford.com.br
Email: hereford@braford.com.br
Asociacion de Criadores de Hereford de Chile
Fernando Schuck R, President
Casilla (P.O. Box) 703, Osono, Chile
Phone: 56-64-234388
Fax: 56-64-238408
E-mail: fschuck@surnetlibre.cl
Czech Republic Hereford Association
Czech Beef Cattle Association
KAMIL MALÁT, CEO
Těšnov 17, 110 00 Praha 1, Czech Republic
Phone: +420 221 812 865
GSM: +420 724 007 860
email: info@cschms.cz
Association Hereford France
Pascal Bastien, President
10 rue de la fontaine, 57170 BAGNEUX, France
Phone: +33 615177610 Pascal Bastien
Email: pascal.bastien@orange.fr
www.hereford-france.com
Hokkaido Beef Cattle Club
c/o Yuji Ikeda - Shintoku Animal Husbandry Experiment Station
Tokiwa 5-46, Shintoku-cho
Hokkaido, T088 2313, Japan
Phone: 1566-4-5321
Fax: 1566-4-6151
Mexican Hereford Association
Octavio Bermudez, President
Bosque de Yuriria 2701-2, Fracc. Sicomoros
Chihuahua, Chih. 31260, Mexico
Phone: 52-410-7493
POLSKI ZWIĄZEK HODOWCÓW
I Producentów Bydła Mięsnego
(Polish Association of Beef Cattle
Breeders and Producers)
ul. Rakowiecka 32, 02 - 532 Warszawa
Poland
NIP 527-20-04-291
Phone: (+48 22) 849-19-10
Fax: (+48 22) 849-32-32
www.bydlo.com.pl
E-mail : bydlo@bydlo.com.pl
Herd Book Society of Zambia
Hereford Breed Section
Mrs. Joan Holmes, General Manager
P.O. Box 50146, Lusaka 15101, Zambia
Phone/Fax: 260-1-251149
Zimbabwe Hereford Society
Mr. Phil Rogers, Chairman
P.O. Box FM80, Famona, Bulawayo, Zimbabwe
Phone: 263-09-229-588
Fax: 263-09-74839
Email: herefordzw@hotmail.com

In many countries with high levels of sun light, cattle can suffer with squamous cell carcinoma (CCEO) of the bovine eye which can lead to significant economical losses.


CCEO is a pathology that affects elderly animals, older than five years, as well as different breeds. Its appearance is related to the absence of pigmentation
around the eye and direct exposure to ultraviolet radiation. Some authors also point out genetic factors as well as associations with papilloma virus. It is the most frequent neoplasm in cattle, being a cause of discarding, economic losses and implications for animal welfare, since self-trauma is an effect of discomfort in response to pain. Treatment of this condition is highly dependent on the location of the tumour and the degree of invasion of the underlying tissue.
As a result of this, the technical staff of the Argentine Hereford Breeders' Association carries out continuous studies. In the year 2022, the ocular pigmentation of more than 11 animals of both sexes belonging to 230 Hereford breeders in 14 provinces of the country
were evaluated. It was decided to use the Uruguayan Pigmentation Table, in order to unify the method of measurement.
The study yields encouraging data for the breed. Of the bulls selected, 62 per cent of the bulls under the selected programmes of the Argentine Association has a 100 per cent pigmentation, which added to those with 75 and 50 per cent give a total of 89 per cent of animals with significant protection to avoid CCEO.
In the case of females, 70 per cent have both eyes with full pigmentation while 13 per cent have 50 per cent pigmentation. The Argentine Hereford Breeders' Association continues to work to improve the breed to ensure it is the best option in the meat market
The Canadian Hereford Association released its new strategic marketing plan titled ‘Better Your Beef’. This plan will be the guiding document for the association over the next several years and identifies six priority areas for the association and breeders to focus their efforts.
These include:
1. Empower breeders to commit to a coherent and consistent strategy.
2. Be a maternal ingredient for a productive crossbreeding programme.
3. Affirm Hereford as the most costefficient breed.
4. Improve Hereford’s influence producing a quality carcase.
5. Dispel the image of Hereford as yesterday’s breed.
6. Connect as a breed of choice for upcoming generations of cattle producers.
The Better Your Beef strategic marketing plan will serve to position the Canadian Hereford Association as a leader in the beef industry and Hereford and Hereford-cross cattle as a vital part of the production chain. The Hereford breed is known in Canada for its maternal attributes and ability to thrive under adverse conditions.
The Canadian Hereford Association recruitment committee selected Michael Latimer as the new executive director in August 2022. Michael will work closely with the CHA board of directors in implementing the Better Your Beef marketing plan and operating the association. Michael has experience in the seedstock sector through his involvement in Remitall Cattle Company, Canadian Beef Breeds Council and other leading beef breed associations in Canada. Through these organisations Michael has experience in operational management, primary production, government relations and board governance.
Agricultural events have resumed normal operations with little or no Covid restrictions remaining across Canada. This year the Royal Agricultural Winter Fair celebrated its 100th anniversary and hosted the National Hereford Show. Canadian Western Agribition hosted 128 international guests representing 13 countries. This marks a substantial increase from 2021 and similar to the last pre-pandemic show in 2019.
The Canadian Junior Hereford Association hosted its annual Bonanza 2022 junior show in Lindsay, Ontario. The show was hosted in person as most pandemic related restrictions were removed prior to the event and was successful by all accounts. Bonanza 2023 will be hosted in the Province of


Prince Edward Island on 25-29 July in conjunction with the CHA annual meeting.
Pure-bred cattle sales remained strong for all breeds of cattle throughout 2022. Commercial feeder and fat cattle welcomed a strong market that trended higher than in 2021 for most of the year. Among other factors, the strong market is due to increased consumer demand across Canada and internationally for Canadian beef and genetics. Inflationary pressures from the global economy, weather related events and geopolitical conflicts have created added pressure on the beef supply chain which have led to increased input costs for producers and agri-food companies.
The Dutch Hereford Association has had a good year. After two years with a slight decline in the number of members, 2022 has been better. The year however started with uncertainty due to the government’s phosphate reduction plan which poses problems for both dairy and beef producers.
Due to the abolishment of milk quotas, milk production had increased so much, and the phosphate leaching with it, that the European Union immediately fined the Netherlands.
The Netherlands has been given exemption which allows our farmers to use a little more phosphate than most other EU countries. If this exemption was to be withdrawn it would mean that nearly half a million cattle would have to be slaughtered.
The EU realised the increase in phosphate was not actually due to beef cattle numbers as these had not increased. The cattle that had increased in numbers were the dairy cattle and phosphate is mainly used on dairy farms. It was a relief for the cattle industry in the Netherlands that the plan was not put into action. It would have meant that farmers who increased the size of their herds would be given sky high fines and the hobby farmers would see their dreams go up in smoke.
However, this plan for the regulation of phosphate was in fact to be put into action 1 January 2023 and farmers can buy and sell quotas for phosphate. The beef industry will not be affected, other than due to the fact that the government can’t see in their records which animals up to two years of age are beef and which are dairy but the Beef Association is working with the government to solve this problem.
The Dutch Association has arranged several activities throughout the year, all of which have been well visited. In the spring we held a course in linear scoring, led by our studbook inspector, Adri Van Gent. There were 20 participants which meant the course was fully booked. Everyone went away with a good understanding of linear scoring. Hopefully the same course will be arranged in 2023.
Family Kreun arranged a day full of activities with lots of Herefords to be seen and 50 members took part. The day ended with a delicious barbecue with Hereford Beef butchered on farm by Wouter Kreun.
The greatest highlight of 2022 was no doubt the National Show in Dalfsen. Never before have so many Herefords been shown in the country with 75 in total on display. It wasn’t an easy task for judge Robin Irvine from Northern Ireland
to pick out a winner. The weather gods were not on our side but despite the weather, both exhibitors and spectators were pleased with the day and the lovely cattle on display.
Male champion, Moeskaer Rico (by Harvie Dan Ricochet 167U P x E MC Aberdeen Lani U820) exhibited by Be Warmelts from Amen.
Female champion, Horstinge Jindera (CCR 59G Stamina ET 199S x Horstinge Hester exhibited by Henk Kuipers and Sonja Oost from Achterste Erm.
The Dutch Breeders' Association, CVR, has decided to import more semen. After a recommendation by the association 100 straws of Nordbaek Kenan and 150 straws of Bakkely Kristian have been purchased from Denmark. The association hopes these bulls can have a positive effect on Dutch Herefords.

Falling cattle numbers in Denmark have further encouraged the Danish Hereford Association to nurture their youth members.
Because of Covid-19, all Danish cattle shows were cancelled in 2020 and 2021. Many beef breeders, not least many Hereford breeders were thrilled when the ban was lifted before the 2022 show season.
The National Show lasted three days in early July. The show had exhibitors from 17 different beef breeds with the most entries being Limousin, followed by Hereford, Charolais, Simmental, and Blonde d’Aquitaine.
The Hereford Show was supported by 20 exhibitors and was down one third compared to 2019. There were 43 Hereford entries which was down 30 per cent compared to 2019. However, the association was pleased to welcome five newly established breeders who entered the show ring leading Herefords for the very first time.
James Graham, Richmount poll Herefords, Northern Ireland was invited to judge and is an experienced judge who did an excellent job to the satisfaction of the association and exhibitors and ably gave his reasons.
James emphasised feet and legs, locomotion, and a good balance between the animal’s front and rear end.
The association is fortunate to have a good number of very talented and successful breeders. However, in 2022 one breeder achieved something unique.
For three consecutive National Shows breeder, Bent Sørensen, Rosenkaer poll Herefords, had the supreme champion animal with three different home-bred animals awarded by three different judges, all from overseas. That record will probably not be beaten soon.

Among the entries listed in the catalogue, 36 per cent had a British sire and 23 per cent had a British sire and a British maternal grandsire. In addition, 31 per cent had a Canadian sire and 27 per cent had a Canadian sire and a Canadian maternal grandsire.
No doubt, Danish Hereford breeders know where to identify top genetics and they know how to take advantage from combining them with genes in their national herd.
Lately, several Danish bred top-quality animals have been exported to the UK, the homeland of the Hereford breed which they consider to be like exporting sand to the Sahara.
The Danish Association used to have an annual Agromek exhibition with a great number of international visitors. Now Agromek is held every second year. Agromek 2022 in early December had 40,000 visitors of which 10 per cent were international guests.
At this year’s show, 13 breeds were represented of which the Hereford had 26 entries with some particularly high quality heifers.
An experienced Danish breeder, Mikkel Christiansen, supported by fellowbreeder Heine Slyk Søe, judged the Hereford show. Mikkel emphasised locomotion, muscularity and style.
Nordbaek Herefords had a particularly good show and breeders Jytte and Henning have won five championships or reserve championships. Furthermore, they won the interbreed championship for herd groups of three or more. Also, they had the interbreed bull championship. All Hereford exhibitors and other members of the association present shared their delight and pride.
SMH Sexy Duchess, a 20 month old heifer, was superior supreme champion and carries international genetics being a result of a successful embryo import from the UK. Out of a Dorepoll cow, Sexy Duchess is by Canadian CCR 57G Stamina ET.
In recent years there has been a fall in the number of beef cattle in Denmark. Since 2018 Hereford numbers have dropped by four per cent. Breeds such as Simmental, Charolais, and Limousin have fallen 20 to 25 per cent. Highland cattle’s popularity has stayed the


Most Danish beef breed associations, including the Hereford, see falling number of members. New members and breeders are essential for the associations and breeds to survive.
In Denmark an association for youngsters taking an interest in the Hereford breed was formed in 2009 –Hereford Youth. It has its own board of directors and is financially supported by the main Hereford association. The purpose was, and is, to attract young people and maintain their interest in Herefords. Hopefully, some of them will be future Hereford breeders and willing to take organisational responsibility.
Today Hereford Youth has 49 members, aged three to 30 years old. Every year a Hereford Youth Show is organised at one of the main cattle shows, with an international judge. In 2022 nine youngsters exhibited 25 Herefords,
same while Angus and Dexter numbers have increased by 10 per cent in the country.
However, the Galloway breed has seen the greatest increase with a 25 per cent
judged by Mr and Mrs Moisander from Finland.
Realising the importance of supporting and encouraging youngsters to remain in the Hereford business, the
increase over the period in question. Smaller sized breeds are becoming very popular for nature conservation which may benefit certain breeders in Denmark.
constitution of the Danish Hereford Cattle Association was changed in 2021. Following this, the board of directors of the main Hereford association is now made up by six members, one of which is appointed by Hereford Youth.
The year 2022 has been a busy year for the Finnish Hereford Association.

In June a junior camp was held for juniors aged 7 to 18. This year the camp was more popular than ever, and saw the highest number of juniors in attendance since the first camp in 2013. During the camp the juniors worked with six heifers learning animal handling skills, junior handler show rules and lots of other things about Herefords and cattle shows.
At the end of June, the association held their National Show in the city of St Michel (Mikkeli), Southern Savonia.
We had a total of 13 animals attending the show along with two junior handler classes and a showmanship class, all judged by Miranda and Christel Lysell from Sweden.

The male champion was APH InStyle bred by Hannele and Juha Moisander, while female champion and National Champion was Luoteen Triteia from Marja Luomajärvi.
These champions also attended the Champion of the World and Miss World online competitions as the Finnish representatives but without success this year.
During autumn fall 2022 the association representatives took part in the Nordic Cattle Genetic Evaluation workshop where breeding goals for Herefords in Nordic countries were discussed. The workshop was held in Copenhagen on 22 September.
The year 2023 will be a huge step in Finnish beef cattle breeding as we
are getting the first genomic breeding values for beef cattle in March 2023. Over 4,000 Hereford animals have been genotyped this far in this genomic project where these genomic breeding values are developed, and breeders are very excited to see the results of their hard work. So far, the breeders have gathered genomic information about the animals genetic defects and poll genes from genotyping.
Last winter hypotrichosis was added to the genomic chip so all the genotyped Herefords automatically get the animal’s hypotrichosis result. Breeders are also getting results for MD. The target in Finland is to get as much information as possible by sending only one tissue sample for genotyping and to increase the number of pedigree verified animals.
A well supported youth camp was among some of the country’s successes in 2022.Male champion, APH InStyle National and female champion, Luoteen Triteia
The year 2022 started in February with the beef bull sales in various areas in Germany, where Herefords averaged €2,450.
At the National Beef Cattle sale in April for heifers, six Herefords were forward and averaged €3,017. The top-seller was the 2020 born heifer HKL Kada, a daughter of the Danish bull Olymbrio, bred by Roland Klüber and sold for the price of €4,000.
On the second weekend in July 2022, our National Show took place at the ‘tarmstedter ausstellung’, where 20 cattle from across Germany attended at our show, as part of the National Beef

Cattle show in Lower Saxony. The cattle were judged in a heifer class, cow class and the bull-class. Judge was Clemens Braschos form Masterrind.
The win in the bull class went to the 10 year old bull Hans Oluf from the farm of Monika and Ulrich Spechtmeyer. After 2016 and 2020, this was the third time, this bull achieved the champion title. No other Hereford bull has achieved this before in Germany. The second place went to the bull Tuesday from the farm of Jutta Wiegand and Jürgen Schubart.
In the cow class the win went to the cow RZW Brigid from the farm of Jutta Wiegand and Jürgen Schubart. The second place went to the cow Kalinka from the farm of Carsten Rust
In the heifer class the win went to the heifer Minetta from Martina Eickhorst and the second place went to Hsp Resi from Christopher Wallbaum.
The weekend of 26 to 28 August saw the annual breeder meeting. This year’s host was Alexander Schmidt who farms near Lüneburg. Alexander Schmidt sells his own beef under the trademark ‘Heiderinder’. Around 60 members attended the meeting and had a beautiful weekend with a lot of information about how to sell beef direct to the consumer. The weekend finished with the AGM.
From 15 to 18 November the Eurotier took place in Hannover. The German Hereford Association attended this exhibition with a stand and it was a success. Many conversations were had about the breed and there were some inquiries for cattle and semen. There were also visitors from foreign countries like Mexico, UK, Ireland and Kazakhstan.
The first Herefords were brought to Kazakhstan in 1930 for pedigree transformation and improvement of local livestock.

The growth of the breed is really pleasing, because 10 years ago, in 2010, there were only 2,500 Herefords in the country. Today there are 105,000 registered animals in Kazakhstan. Over the years, about 30,000 heads have been imported, the rest are home-bred in Kazakhstan. Most of the livestock was imported from the following countries; Canada, USA, Australia, Russia and from European countries.
Today, 139 farms are members of the Republican Chamber of the Hereford breed. The breed is represented in most regions of Kazakhstan and both small and large farms are involved in the breed with the number of livestock among members of the Chamber varying from 75 to 3,000 head.
Herefords have won the great love of farmers in different parts of the world, becoming one of the most numerous and widespread meat breeds of cattle on the planet. A special position and color make these animals aristocrats among meat breeds. Apart from Antartica, they are bred on all continents and are at home in the UK, in EU countries, in Canada, the USA, Mexico, Australia and New Zealand, Brazil, Argentina, Uruguay, South Africa, Russia (Siberia, Far East, Southeast) and Central Asia. The Hereford breed is also widely represented in Kazakhstan. Today, the Hereford is one of the three most common breeds in Estonia.
Kazakhstan is located in the center of the Eurasian continent and ranks ninth in the world in terms of area being 2.725 million km².
The terrain of Kazakhstan is also diverse.
Within the territory, 63 per cent is occupied by steppes, 25 per cent is desert and semi-desert while 10 per cent are mountains. Forest-steppes predominate in the north of the republic and occupy 2 per cent of the country’s area. Furthermore, 23 per cent of the country’s territory is suitable for agriculture (forest-steppe and cold steppe) with 70 per cent occupied by nomadic livestock systems. The length of the country from west to east is 2,900 km, from south to north 1,600 km.
As you can see, most of Kazakhstan is occupied by steppes, or plains, and it is in such conditions that farmers breed ecofriendly cattle, including the Hereford breed, which has perfectly adapted to the territory of Kazakhstan.
Farmers are waiting for you in Kazakhstan, both as guests and as partners.
The 40th anniversary of the Norwegian Hereford Association was marked one weekend at the beginning of November in connection with the annual meeting. Here, members noted how well the association had pulled through two years of pandemic and limited physical meeting places.
The members are loyal and have kept in touch online and the board has remained active. This summer the association was finally able to arrange a summer gathering, and in September the old tradition of an annual show or ‘Dyrskuen’ in the south of Norway was resumed.
The 40 year anniversary has been an occasion to reflect on the history of the Norwegian Hereford Association. From the very beginning at the end of the 1970s through to the 1980s, limited Hereford animals were imported into Norway. Herefords were primarily imported from Denmark and Sweden, but also from England.
The number of Hereford cows grew from a few hundred in 1982 to the present day population of 14,300 across 1,340 herds. Herefords have become a large and viable breed in Norway with a share of 14 percent of the national suckler herd. Two of the bulls which left significant traces in the Norwegian breed came from England in 1983. Orari 1 Swaledale bred by GR and RH Peacock, N Yorkshire and later Grimsby 1 Fenby Town from Chapman and Frearson, Grimsby were imported to Skjatvet farm. Halstein Flesland led the work with Herefords at Skjatvet farm for 40 years and was a well-known man for many in the
international Hereford community, though today the farm no longer keeps Herefords or any other livestock.
In the spring of 2022, there was great excitement associated with the bull test at Staur and the result of the ET bulls in testing. Two out of four ET bulls were qualified, including 71135 Mæringsdalen Roar JR sired by USA NJW 135U10Y Hometown made the best score, qualifying along with71134 R PP Blueprint – ONE from Rønn sired by USA Boyd 31z Blueprint6153. Both bulls had several semen collections and Norway envisage a possible export.
The annual bull auction at Staur, Herefords achieved an average price of €5,800 with the highest price achieved for 71134 PP Blueprint – ET by Rønn, pricing at €8,300.
In the coming year, the Hereford association will work specifically on collecting performance data on birth weight, 200 and 365-day weight. Registrations together with an increased number of pedigree registrations will
strengthen the Norwegian Hereford breeding.

The Hereford picture of the year is an annual photo competition by the Norwegian Hereford Association. The winning picture of 2022 shows Herefords on Fuglestad farm belonging to the Fuglestad family in Nordland county. The photograph is by farmer’s daughter, Susanne Fuglestad.


Like every society, 2022 continued to be a challenging year for NZ Herefords. Planned events were once again postponed with the coast-to-coast herd tour rescheduled for March 2023. The herd tour organising committee did not expect to be involved for three years and have their fingers crossed that 2023 will be ‘third time lucky’.
The youth development weekend was also postponed however the society did hold a very successful leadership day where a dozen of 18 to 30 year old members were invited to attend a communication session, where they sat a psychometric test, gaining a great insight
to their personal strengths and from that they learnt the importance of tailoring their communication skills. The society plans to continue to work with these future leaders in the coming years, as the board has identified its responsibility to educate its future leaders.
Although the National Sale, and breed dinner were sadly cancelled, the autumn private bull sales being one month later, did go ahead. There was a tie at the top of the leader board for the highest priced Hereford bull sold with Matariki Herefords, located at Kaikoura and Okawa Herefords, also in the South Island at Mt Somers both selling sires for $47,000.
The yearling spring top price went to Mahuta Herefords, South Auckland at $14,000 for Mahuta Routeburn 1059 selling to Craigmore Herefords, Hamilton. Routeburn 1059 is a son of Mahuta Ocean 8073, a bull which has performed exceptionally well in the recent Beef and Lamb Genetics Dairy Beef Progeny test and has a well-balanced EBV profile with low birthweight and high growth. A great line of yearling bulls which were attractive to both dairy and beef farmers meant a full clearance was achieved on 58 bulls sold to average $4,540 which is a record average for a Hereford spring yearling bull sale in the country.

The year 2022 saw some continued disruption for NZ Herefords. Despite this, bull sales remained strong.Matariki Nautical Gray Pannett judged the UK’s autumn show and sale
It has continued to be a challenging year for beef breeders with the NZ government further implementing environmental targets to be met. However Herefords have proven they are structurally suited to rugged country and with the ability to mature between 400 days and 600 days, there is confidence in the members that they can efficiently meet the future market demands, encouraged by the use of SNP DNA results enabling better selection decisions at an earlier stage of their breeding programme.
One of this year’s highlights for general manager Posy Moody and president Gray Pannett was to attend the European Conference in France and then the Hereford Cattle Society autumn show and sale in Shrewsbury and society dinner. While there is less showing in NZ in comparison to UK, both Gray and Posy found the type of Herefords similar to those currently being bred in their own country. Gray was particularly impressed with the strong line-up of heifers and said during the presentation of prizes he would ‘willingly use anyone of them at his Limehills stud in NZ’.

Posy says: “Robyn, Gray and I were extremely well hosted by Paul and Laura but we particularly want to give Mark Roberts a big thank you for putting up with the three of us for so long.”

Dedicated efforts by Hereford breeders in the United States over time have positioned the breed enviably as commercial cow-calf producers seek to incorporate more heterosis through complimentary crossbreeding.
“In my 20 years of serving the American Hereford Association (AHA), the enthusiasm of our membership has never been higher, nor the interest from the commercial industry more intense,” says Jack Ward, AHA executive vice-president.
“Hereford momentum in the United States is building and should continue to build given the historic opportunity at hand.”
The historic opportunity has to do with two primary drivers.
First, more commercial producers are recognising that making the national cow herd increasingly straight-bred Angus came at the cost of reduced production efficiency and the associated economics.
Based on various data, commercial cow herd performance has remained static or declined during the past two decades when it comes to key revenue metrics like reproductive efficiency, weaning weights and weaning weights per cow exposed. While the increased carcase quality that came with more use of Angus genetics was necessary to bolster consumer beef demand, more producers are recognising
the need to maintain carcase quality while shoring up production efficiency.
The second part of the historic Hereford opportunity has to do with raw numbers.
When 2023 begins, there will likely be approximately 3 per cent fewer beef cows year-over-year in the US inventory at about 29.2 million head. That would be 2.5 million fewer cows than the most recent peak of 31.7 million in 2019. While economics are partly to blame, widespread, persistent drought has been the primary impetus of national beef cow liquidation.
When the current drought ends, supply fundamentals suggest enough economic incentive for cow-calf producers to build back by at least 2.5 million cows and the bulls necessary to breed them.
“Considering narrow profit margins, even as depleted cattle supplies drive cattle prices higher, increased use of heterosis is the logical solution,” Jack says. “More than logical, you can easily argue it’s necessary for economic sustainability.”
Experience across decades and reams of research document the advantages of direct and maternal heterosis.
Inherent genetic advantages make Hereford the most powerful crossbreeding component. In fact, the vision of AHA’s new five-year strategic plan is to establish Hereford genetics as the essential component of the US beef cow herd.

Past AHA research projects demonstrated the economic value associated with direct and maternal heterosis in Hereford-sired, F1 Black Baldy females, compared to straightbred black Angus peers.
“Documented advantages include fertility (pregnancy rate), pounds of calf weaned per cow exposed, feedlot feed efficiency and cost of gain, cow feed efficiency (pasture) and net return per calf,” according to Shane Bedwell, AHA chief operating officer and director of breed improvement.
Plus, Hereford are the least related of the Bos Taurus breeds, according to the US meat Animal Research Center. That means Hereford come with added cross-breeding punch.
AHA continues to document the advantages.
As an example, a multi-year research
When the current drought ends, commercial producers will likely need to expand the nation’s cow herd by at least 2.5 million head.Pressure on US cattle and beef currently comes from concerns about climate change
project at Oklahoma State University documented that Hereford-sired Black Baldy females consume about two pounds less moderate-quality pasture forage per day, while carrying more body condition, when compared to straightbred black Angus peers. That equates to about one acre less forage per year.

Shane also points to AHA’s current multi-year research project with the University of Illinois, which carries previous knowledge about maternal heterosis a step further. The project compares Hereford-sired, Black Baldy cows to straight-bred black Angus peers for economically relevant traits such as conception rate, calving rate and pounds of calf weaned per cow exposed. But the project also measures individual cow feed intake prior to breeding and during lactation to establish maintenance energy requirements. Additionally, steer progeny of cows in the project will be fed and finished, providing a comprehensive assessment of values and efficiencies from conception through to slaughter.
Ultimately, the project goal is to develop a global economic model to quantify direct and maternal heterosis advantages of the Hereford-sired, F1 Baldy female.
Hereford’s efficiency advantages magnify the breed’s opportunity when
it comes to environmental sustainability and social license.
“Sustainability is not a nice-to-have anymore; it’s a need-to-have,” says Kim Stackhouse-Lawson, PhD, director of Colorado State University’s (CSU), a research collaborative developing sustainable solutions for agriculture.
“Yes, producers have been here for generations, but today we have to say, ‘we’ve been here for generations and here’s how we continue to improve and continue to care.’ The proof points in today’s society are expected, whether that’s fair or not.”
Kim explains most of the pressure on US cattle and beef currently comes from concerns about climate change, specifically the level of greenhouse gas produced by the industry.
“We know cattle are natural up-cyclers. We also know how much more efficient US beef production has become over time in terms of producing more beef with fewer cows on less land.
"The American cattle producer is the most efficient in the world,” Jack says “But we also know the global population is expected to grow by almost 2 billion by 2050. So, how do we become more efficient and how do we, from a genetic standpoint, affect overall sustainability?”
The AHA launched a collaborative research project with CSU and AgNext during fiscal year 2022 to find answers.
Specifically, the research aims to enhance the understanding of the genetic differences in seedstock relative to enteric methane production — a byproduct of rumen fermentation — and nitrogen excretion. Both contribute to greenhouse gas (GHG) emissions and the carbon footprint of cattle.
“Documenting the relationship between traits associated with efficiency — Hereford advantages — and GHG emissions is the logical next step for the breed and the industry,” Jack says.
Shane explains the project leverages decades of AHA research and member data, including individual feed intake records collected through the National Reference Sire Program (NRSP) since 2010. It uses the unbiased reporting and added prediction accuracy stemming from AHA’s Whole Herd Total Performance Records (TPR™), which was established in 2001.
“Because of leadership foresight and breeder commitment to progress, the Hereford breed is poised to represent the entire beef industry as leaders in the sustainability arena,” according to Shane.
Expected outcomes of the multi-year project include characterisation of Hereford’s sustainability advantages associated with absolute production of methane and nitrogen, as well as selection tools enabling producers to select for less GHG emissions.
All of these opportunities build on expanded Hereford market share in recent years, based on AHA memberships, registrations, inventory in the TPR program and transfers of registered Hereford bulls to commercial cow-calf producers.
The average price paid in 2021 for Hereford bulls reported by AHA was $5,745. That was $1,079 more (+23%) than the average price five years earlier. Keep in mind, the 2021 bull price average accounts for 6,280 bulls, one of the largest volumes ever reported by AHA. These prices and volume will likely be similar when 2022 annual data is available.

Hereford breeders in the United States are also strongly positioned to expand market share because of AHA’s longterm focus on providing Hereford youth with the opportunity to learn more about the cattle and beef industries as they develop leadership skills. The
Stirling
Sunday 5 – Monday 6 February
Dungannon Farmers Mart
Tuesday 14 February
Shrewsbury Auction Centre
Saturday 15 April
Dungannon Farmers Mart
Tuesday 18 April
Borderway Mart
Saturday 20 May
Shrewsbury Auction Centre
Saturday 30 September
Stirling
Sunday 16 – Tuesday 18 October
National Junior Hereford Association (NJHA) is widely regarded as offering more opportunity than any other junior breed organisation in the nation.
Consider that the Hereford Youth Foundation of America — funded by Hereford breeders — awards nearly $200,000 in scholarships each year. Another example is growing participation in the Fed Steer Shootout, which gives Hereford juniors a chance to learn about the cattle feeding and beef packing sectors, while feeding their own cattle at a commercial feedlot — HRC Feedyards in Scott City, Kansas. — to see how their genetics perform. As well, depending on the year, the NJHA hosts the largest or second largest junior heifer show in the world.
“We’re proud of NJHA and the breeder support behind the organisation and its activities,” Jack explains.
“While those efforts continue, our AHA board of directors is also focused on expanding opportunities for young breeders, those who leave the ranks of NJHA and are just beginning their professional careers.”
Currently, AHA is designing a leadership programme for that specific segment of the organisation’s membership.
International Hereford friends will have a chance to see and hear more about Hereford in United States during the World Hereford Conference. It is scheduled for 23-26 Oct 2025 in Kansas City, Missouri with exciting pre-conference and postconference tour options.
“Hereford breeders in the United States are commonly recognised for their family spirit. If you have anything to do with Hereford, you’re part of the family,” Jack says.
“I’ve discovered the same thing is true of Hereford breeders across the world, who have extended such amazing hospitality to our staff and members over time. We’re looking forward to sharing that same kind of hospitality with those attending the 2025 World Hereford Conference.”
AFTER THE ONE-TWO PUNCH OF PI REMOVAL AND BIOSECURITY, YOU’LL WANT TO KEEP YOUR GUARD UP AGAINST BVD. A DISEASE WITH AN IMPACT OF OVER £40 PER COW PER YEAR 1 . SPEAK TO YOUR VET ABOUT HOW THE UK’S MARKET LEADING BVD VACCINE 2 PROVIDES 12 MONTHS’ PROVEN PROTECTION AGAINST BOTH BVD TYPE 1 AND 2, WITH JUST ONE JAB 3 When used as part of a comprehensive approach to BVD including culling of PIs and biosecurity.
AFTER THE ONE-TWO PUNCH OF PI REMOVAL AND BIOSECURITY, YOU’LL WANT TO KEEP YOUR GUARD UP AGAINST BVD. A DISEASE WITH AN IMPACT OF OVER £40 PER COW PER YEAR 1 . SPEAK TO YOUR VET ABOUT HOW THE UK’S MARKET LEADING BVD VACCINE 2 PROVIDES 12 MONTHS’ PROVEN PROTECTION AGAINST BOTH BVD TYPE 1 AND 2, WITH JUST ONE JAB 3 . When used as part of a comprehensive approach to BVD including culling of PIs and biosecurity.


WIRRUNA PEACE
SIRE: WIRRUNA LEDGER
DAM: WIRRUNA OYSTER GIRL L334
MAWARRA HUGO P190 (H)
SIRE: YARRAM UNIQUE F181
DAM: MAWARRA MINERVA 1009
WIRRUNA LENNON L102
SIRE: ALLENDALE ANZAC E114
DAM: WIRRUNA MADAM H55
MAWARRA SHOWTIME P277 (PP)
SIRE: OAK DOWNS LAWLOIT L75
DAM: MAWARRA MISS TITANIA 054
NETHERHALL 1 MATTY S098
SIRE: WIRRUNA MATTY M288
DAM: WIRRUNA VICTORIA G7
For more information on our Hereford range, call: FREEPHONE: 0800 783 7258
SKY HIGH 1 TAKE A CHANCE (P)
SIRE: REMITALL SUPER DUTY 42S
DAM: DENDOR 1 JENNIFER 15TH
